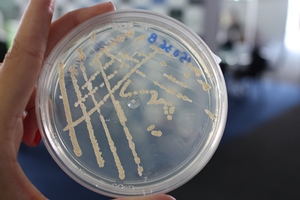

-
Você está aqui:
- Página Principal

- Comunicação

- Banco de Notícias

- Macroalga e probiótico para produção de tilápia são destaques do IP na Agrishow
Macroalga e probiótico para produção de tilápia são destaques do IP na Agrishow
IP apresenta tecnologia para obtenção de estimulante agrícola a partir de macroalga marinha na Agrishow
Segundo dados da FAO (Organização das Nações Unidas para Alimentação e Agricultura), o mercado mundial de plantas aquáticas movimentou US$ 11,4 bilhões em 2016, com uma produção total de 30,1 milhões de toneladas. De olho na importância econômica desse mercado, o Instituto de Pesca (IP-APTA), da Secretaria de Agricultura e Abastecimento do Estado de São Paulo, desenvolve desde 1995 estudos com a macroalga marinha Kappaphycus alvarezii, que apresenta potencial de aplicação em diversos segmentos da indústria, como o de biofertilizantes, biocombustíveis, cosméticos, rações, dentre outros.
Os resultados preliminares do projeto de pesquisa intitulado “Desenvolvimento ordenado e potencial da produção da macroalga Kappaphycus alvarezii no Estado de São Paulo para a extração do biofertilizante”, realizado pelo Instituto de Pesca em parceria com a Faculdade de Engenharia Agrícola (Fepagri), da Universidade Estadual de Campinas (Unicamp), serão apresentados ao público entre os dias 30 de abril e 4 de maio durante a Agrishow 2018.
De acordo com a pesquisadora do IP Valéria Cress Gelli, que coordena o projeto, os resultados obtidos demonstraram que o extrato da macroalga K. alvarezii pode ser considerado um estimulante agrícola e sua eficiência já foi comprovada também em diversos estudos.
“Os testes preliminares que realizamos na Feagri/Unicamp demonstraram que o extrato da macroalga K. alvarezii em uma concentração de 2% resultou em um aumento de produtividade de aproximadamente 25% na cultura da alface quando comparado aos biofertilizantes comerciais. Novos testes devem ser realizados, porém a eficiência deste extrato tem sido estudada mundialmente com sucesso em outras culturas, como, por exemplo, a da soja, pimentão, milho, cana, trigo”, diz a pesquisadora.
Outro ponto positivo da utilização da macroalga para esse fim é que o produto é biodegradável e previne doenças nas lavouras, principalmente as causadas por fungos e bactérias, conta Valéria.
“Nos últimos anos, o mercado de alimentos orgânicos tem crescido, mas a produtividade por área ainda é um entrave. Neste sentido, o estimulante agrícola extraído da macroalga K. alvarezii poderia ser uma alternativa utilizada para aumentar a produtividade sem comprometer a certificação dos produtos”, explica.
sse projeto também tem o objetivo de desenvolver de forma sustentada, ordenada e responsável o cultivo de algas, ou algicultura, no litoral norte de São Paulo, a fim de que se torne uma alternativa de trabalho e renda para as comunidades litorâneas, em particular aquelas relacionadas à produção aquícola familiar e/ou artesanal.
“Nos estudos de viabilidade econômica realizados, concluímos que a produção do extrato da macroalga, de forma artesanal, passa a ser rentável a partir de áreas de cultivo de 2.000 m² de lâmina d’água. Além destes estudos de eficiência econômica, estamos também realizando pesquisas com o uso de geotecnologias para o ordenamento espacial da atividade em todo o litoral norte de São Paulo, com o objetivo de colaborar nas políticas públicas da maricultura paulista”, conta Jansle Vieira Rocha, professor e pesquisador da Faculdade de Engenharia Agrícola da Unicamp.
Biocombustível
m outra frente de estudo, a utilização da macroalga Kappaphycus alvarezii como biocombustível também demonstrou ser viável. A tecnologia inédita para a obtenção de um hidrolisado de glicose por meio do processamento industrial de macroalgas marinhas foi desenvolvida pela Universidade Estadual Paulista “Júlio de Mesquita Filho” (Unesp) em co-titularidade com o Instituto de Pesca (IP-APTA).
A nova tecnologia proporciona uma taxa de conversão da glucana em glicose de 100%, o que permite a redução de uma etapa para a produção de biocombustível. Para se ter uma ideia, a taxa de conversão da cana-de-açúcar é de apenas 20%. Por isso, o hidrolisado de glicose se configura como uma alternativa tecnológica com menor impacto ambiental para a produção de combustíveis.
Probiótico para tilápia desenvolvido pelo Instituto de Pesca será apresentado durante a Agrishow 2018
Com produção estimada 357 mil toneladas em 2017, a tilápia é atualmente o peixe mais cultivado no Brasil. Tendo em vista sua importância econômica para a aquicultura brasileira e a necessidade de aumento de produtividade das fazendas aquícolas, pesquisadores do Instituto de Pesca (IP-APTA), da Secretaria de Agricultura e Abastecimento do Estado de São Paulo, estão em fase final de desenvolvimento de um probiótico específico para tilápias. A tecnologia será apresentada para o público durante a Agrishow 2018.
De acordo com Danielle de Carla Dias, pesquisadora que integra a equipe do IP, foram selecionadas quatro cepas de bactérias com potencial probiótico, que estão sendo produzidas em industrialmente para realizar os experimentos in vivo. Ela destaca que nos testes realizados em laboratório, esses probióticos inibiram in vitro as três principais bactérias patogênicas que ocorrem na tilapicultura brasileira – Aeromonas hydrophila, Francisella noatunensis subespécie orientalis e Streptococcus agalactiae.
“Até o final do mês de agosto de 2018, teremos os resultados dos testes com os peixes para solicitar o registro dessas bactérias probióticas junto ao Ministério de Agricultura, Pecuária e Abastecimento (MAPA), regularizando sua utilização em tilapicultura”, afirma Danielle, que participa do Programa Jovens Pesquisadores em Centros Emergentes da Fundação de Amparo à Pesquisa do Estado de São Paulo (Fapesp).
Aumento de produtividade
Os probióticos são micro-organismos vivos que, se administrados em quantidades adequadas, trazem benefício à saúde do animal que os hospeda. “Esses micro-organismos têm capacidade de se instalar e proliferar no trato intestinal do animal, trazendo benefícios como, por exemplo, aumento de ganho de peso, redução de colonização de organismos causadores de infecções, maior taxa de fertilização e produção de ovos, dentre outros”, explica a pesquisadora Por isso, o desenvolvimento desse tipo de produto se torna um aliado importante para os produtores que trabalham com sistemas de cultivo intensivo, onde o risco de doenças é maior e pode comprometer todo o estoque de peixes.
Para selecionar a bactéria mais adequada para o desenvolvimento do probiótico, os pesquisadores do IP visitaram e coletaram material em 24 pisciculturas dos Estados de São Paulo, Paraná, Bahia e Pernambuco. “Esse trabalho de coleta durou cerca de um ano. No campo, nós fizemos a raspagem da pele da tilápia para coleta de muco e retiramos também uma amostra de seu intestino, onde estão concentradas em maior quantidade as bactérias probióticas. Feito isso, nós congelamos esse material, que foi conservado em meios de cultura adequados para o transporte de bactérias até o laboratório para realizarmos as análises de seleção”, detalha o pesquisador do IP, Carlos Ishikawa, que também participa da pesquisa.
A coleta de material biológico em diferentes regiões é fundamental para a pesquisa. De acordo com o pesquisador do IP, Leonardo Tachibana, há variações nas características das bactérias dependendo das condições ambientais, como o clima e a qualidade da água. “Por isso, é tão importante esse trabalho de coleta em vários pontos. Isso nos dá uma diversidade de material para selecionarmos o probiótico mais adequado”, conta Tachibana.
Para o secretário de Agricultura e Abastecimento do estado de São Paulo, Francisco Jardim, o desenvolvimento do probiótico para tilápia pelo Instituto de Pesca será importante para o fortalecimento setor produtivo da aquicultura, pois trará ganhos de produtividade às fazendas aquícolas que cultivam este peixe, cumprindo os propósitos delineados pelo governador Márcio França.
Textos: Leonardo Chagas – Assessor de Imprensa – IP
Contato durante a Agrishow:
Fernanda Domiciano – Assessora de Imprensa APTA
(19) 99269-9138 (com Whatsapp) | (19) 99745-9837 | fdomiciano@sp.gov.br
Notícias por Ano
- ► 2026 (10)
- ► Janeiro (10)
- • Instituto de Pesca estabelece banco de germoplasma de tilápia no Brasil
- • Agro paulista fecha 2025 com superávit de US$23 bilhões
- • Geraldo Melo Filho é o novo secretário de Agricultura e Abastecimento do Estado de São Paulo
- • Instituto de Pesca avalia viabilidade econômica da pesca recreativa e propõe alternativas sustentáveis
- • Ital prevê realizar 37 cursos, seminários, workshop, conferência e congresso em 2026
- • Programa de Pós-Graduação do IAC cria disciplina inédita sobre Propriedade Intelectual e Inovação na Agricultura Tropical e Subtropical
- • Instituto de Economia Agrícola lamenta falecimento de dois ex-pesquisadores
- • Pesquisador do Ital deixa legado na área de ciência e tecnologia de alimentos
- • IAC se despede do pesquisador conhecido por ser o pai do Feijão Carioca
- • Instituto de Pesca reafirma sua missão para 2026
- ► Janeiro (10)
- ► 2025 (214)
- ► Dezembro (17)
- • Nota de pesar: Instituto de Tecnologia de Alimentos lamenta o falecimento de Paulo Tavares, pesquisador com duas décadas de dedicação à instituição
- • Governo de SP convoca 37 novos pesquisadores científicos para escolha de vagas
- • Instituto de Pesca lança campanha para preservação das áreas de maricultura em Ubatuba
- • Censo rural fortalece cidadania indígena e proteção ambiental no Vale do Ribeira
- • O Instituto Agronômico (IAC) homenageia personalidades com a medalha "Mérito Científico D. Pedro II"
- • “O bê-á-bá da Aquicultura” reúne especialistas na Apta Regional de Pindamonhangaba
- • Centro de Pecuária Sustentável do Instituto de Zootecnia será inaugurado em São José do Rio Preto, no dia 19
- • Dia do Engenheiro de Pesca: homenagem destaca trajetória de pesquisadora do Instituto de Pesca
- • Pesquisador do Instituto Biológico participa da descoberta de novo gênero de nematoide no Brasil
- • Pindamonhangaba vai receber o 2° Encontro da Rede Sociobiodiversidade SP
- • Férias chegaram! Confira programação imperdível no Planeta Inseto
- • Superávit do agro paulista chega a US$ 21 bilhões no acumulado do ano
- • IZ desenvolve sistema inovador para mensuração de metano e avaliação da fermentação ruminal
- • Instituto de Pesca recebe delegação do Governo do Estado de Selangor, Malásia
- • São Paulo anuncia chamamento de 37 novos pesquisadores do agro, primeira contratação em 20 anos
- • Apta e Instituto de Pesca recebem visita de cônsules do Uruguai e Paraguai
- • IAC comemora 138 anos e bicentenário do nascimento de D. Pedro II com lançamento de 13 cultivares
- ► Novembro (25)
- • Dia Mundial da Aquicultura: o papel do Instituto de Pesca no desenvolvimento sustentável da atividade
- • Coordenadora do Instituto Biológico é escolhida como uma das “rainhas pioneiras” do estudo das formigas no Brasil
- • Estudo do Instituto de Pesca destaca impactos da crise climática em comunidades tradicionais
- • AptaHub renova gestão e amplia rede: rumo ao agro do amanhã
- • IAC apresenta duas novas variedades de cana-de-açúcar
- • Instituto de Pesca destaca a importância do Dia Mundial da Pesca e da Luta pela Pesca Artesanal
- • Projetos da Apta são destaque no maior evento científico de aquicultura do país
- • Governo de SP premia os 50 melhores cafés do Estado no 24.º Concurso Estadual de Qualidade do Café
- • IAC celebra os 138 anos de sua criação e o bicentenário de seu criador
- • IAC lança página especial com pesquisas e programas voltada à COP30
- • Estudo do Instituto de Pesca investiga crescimento muscular de linhagens de trutas arco-íris
- • Tecnologia desenvolvida no IZ para aumento do rendimento de queijo já está presente na produção comercial
- • Instituto Biológico celebra 98 anos de excelência científica e legado à pesquisa agropecuária paulista
- • Curso do IAC-Apta destaca oportunidades e inovações no mercado de óleos essenciais
- • Núcleo de Pesquisas Pescado para Saúde participa da COP 30
- • Agro paulista registra superávit de US$ 19 bilhões no acumulado do ano
- • Impulsionada pelo AptaHub, startup parceira da Apta Regional é premiada com projeto que treina abelhas para polinizar café
- • Apta Regional investe em capacitação da equipe com curso sobre Inteligência Artificial
- • Novo e-book do Instituto de Pesca revela retratos da pesca artesanal na Baixada Santista
- • Apta Regional marca presença na COP30 com foco em agricultura sustentável e bioeconomia
- • AptaHub destaca papel da inovação no enfrentamento dos desafios ambientais em evento pré-COP
- • Instituto de Pesca participa do Summit SP+Verde, evento preparatório para a COP 30
- • Sem mares saudáveis, não há futuro sustentável, alertam pesquisadores no Summit Agenda SP+Verde
- • Tradição e Inovação: Alcachofra paulista floresce como destaque nacional
- • Instituto de Zootecnia sedia XXXV Treinamento em métodos de diagnóstico e controle da brucelose e tuberculose animal
- ► Outubro (27)
- • Período de Defeso da Piracema começa em 1º de novembro no Estado de São Paulo
- • IAC tem dois reconhecimentos, sendo um da FAO
- • Comer Com Ciência lança site ampliando ações de comunicação do Ital com a sociedade
- • Prêmio Apta Semeador do Futuro 2025 homenageia pesquisa paulista
- • Instituto de Pesca levará inovação e conhecimento para a Seafood Show Latin America 2025
- • Nova Alta Paulista conquista Indicação Geográfica paulista com apoio da Secretaria de Agricultura do Estado de São Paulo
- • Iniciativas de segurança alimentar são premiadas na edição 2025 do Prêmio Josué de Castro
- • Ital recebe o público neste sábado (18) com exposição, interações e visita guiada
- • São Paulo aprova modernização da carreira de pesquisador científico
- • Agro paulista registra superávit de US$16,8 bi nas exportações
- • Apta Portas Abertas 2025: Instituto de Economia Agrícola mostra ao público a importância dos dados para a ciência no agro
- • IZ contribui para o desempenho da pecuária no Brasil e no mundo
- • Alunas da Pós-graduação do Instituto de Zootecnia são premiadas em congresso internacional
- • Apta Portas Abertas 2025: atividades do Instituto Biológico acontecem em São Paulo, Votuporanga e Campinas
- • Pesquisa do Instituto de Pesca busca alternativas naturais para melhorar a nutrição de tilápias
- • Na irrigação, monitoramento é tão necessário quanto a água
- • Campos experimentais e laboratórios da Apta Regional ao alcance da sociedade com a 4ª edição do “Apta Portas Abertas”
- • Segunda florada do ano colore o cafezal do Instituto Biológico e atrai polinizadores
- • IAC participa do Apta Portas Abertas nos dias 17 e 18 de outubro
- • Criação de Laboratório para produção de embriões in vitro do IZ deve acelerar pesquisas na área de reprodução de bovinos
- • Instituto de Pesca abrirá as portas ao público com programação científica, lazer e gastronomia
- • Ital oferece oito vagas para mestrado stricto sensu em Ciência e Tecnologia de Alimentos
- • Apta Portas Abertas 2025
- • Instituto de Pesca aponta benefícios da macroalga Kappaphycus alvarezii no crescimento de manjericão e menta
- • Enriquecimento ambiental pode melhorar a saúde e o bem-estar de bezerras leiteiras, aponta pesquisa do IZ
- • Estado de São Paulo intensifica vigilância contra praga em palmeiras
- • Em sua 4ª edição, Apta Portas Abertas aproxima a população da ciência aplicada ao agro
- ► Setembro (18)
- • Fapesp aprova quatro centros de pesquisa liderados pela Apta
- • Semana de Alimentação: sabor, saúde e ciência serão destaque de evento da SAA
- • Apta vai à Índia para fortalecer cooperação em pesquisa agropecuária
- • Boletim do Instituto de Pesca ingressa na Coleção SciELO
- • Sanidade Animal – Defesa Agropecuária, Apta Regional e Câmaras Setoriais promovem I Seminário sobre Javali
- • Secretaria de Agricultura de SP realiza homologação de 37 novos pesquisadores científicos
- • Pesquisador do IP participa de encontro nacional sobre petrechos de pesca
- • Instituto de Zootecnia lança nova tecnologia no 1º encontro de Bubalinocultura do IZ
- • Referência em Melhoramento Genético das Raças Nelore e Caracu, Instituto de Zootecnia recebe Prêmio Criadores de Eficiência durante a Expogenética 2025
- • IG do mel do Vale do Paraíba: conquista que une produtores, pesquisa e qualidade
- • Festa Tem Peixe na Vila, do Instituto de Pesca, repete sucesso na capital paulista
- • Pesquisadora do IAC recebe prêmio da União Europeia por invenção
- • Apta Regional mostra o protagonismo da pesquisa agropecuária na “AGRO SEM LIMITES 2025”
- • Tem Peixe na Vila: Apta Regional leva ao evento pesquisas com rã-touro
- • Semana do Pescado 2025 chega à 22ª edição com ações em todo o país, incluindo a Festa Tem Peixe na Vila
- • Workshop sobre plantas medicinais e agricultura familiar recebeu participantes de 40 munícipios para debater políticas públicas
- • Instituto Biológico certifica soro fetal bovino, insumo habilitado para exportação à União Econômica Euroasiática
- • Pesquisadora do Ital é premiada por tecnologia que permite redução de gordura saturada em alimentos
- ► Agosto (13)
- • Apta, Embrapa e Pecege assinam parceria para Corredor Agro SP na Semana da Agricultura Digital
- • Instituto de Pesca apresenta novidades da 3ª edição da Festa Tem Peixe na Vila em encontro com a imprensa
- • Anticorpos monoclonais: da medicina à agricultura tropical
- • Seguro agrícola paramétrico será tema de debate em seminário do Instituto de Economia Agrícola
- • Aquicultura sustentável contribui para a diminuição do impacto das mudanças climáticas
- • Balança Comercial do Agro Paulista registra superávit de US$ 12,81 bilhões no acumulado de sete meses
- • MUSEU DE PESCA SEGUE ATIVO EM AÇÕES DE REVITALIZAÇÃO
- • Congresso Brasileiro de Fruticultura exalta legado de referência nacional no setor
- • FAO e OMS destacam sucesso do Brasil na prevenção e redução de micotoxinas em milho
- • FAO e OMS destacam sucesso do Brasil na prevenção e redução de micotoxinas em milho
- • FAO e OMS destacam sucesso do Brasil na prevenção e redução de micotoxinas em milho
- • Tem Peixe na Vila, a Festa do Pescado de São Paulo, chega à 3ª edição
- • Da lavoura ao copo: lúpulo de SP ganha espaço na produção artesanal
- ► Julho (12)
- • Premiação nacional inédita de molhos de pimenta recebe inscrições até 9 de setembro
- • Governo de SP avança em parceria com a iniciativa privada para qualificar mão de obra rural
- • Secretaria de Agricultura participa da abertura da 6ª edição da Batatec
- • Núcleo de Pesquisas Pescado para Saúde lança livro com orientações práticas para uma alimentação saudável com pescado
- • IAC expõe nova variedade de batata-doce durante a 6ª Feira Tecnológica da Batata-doce – Batatec
- • I Simpósio Brasileiro de Olivicultura discute desafios e inovação no cultivo de oliveiras em condições subtropicais
- • Estudo do Instituto de Pesca revela que baixas temperaturas aumentam risco de infecção viral em alevinos de tilápia
- • Agro paulista tem superávit de US$ 10,45 bilhões no primeiro semestre de 2025
- • Instituto de Zootecnia: 120 anos de dedicação à produção animal
- • Camarão no inverno: uma alternativa saudável e nutritiva para o cardápio
- • Metodologia desenvolvida no IZ promete aumentar rendimento de queijo muçarela
- • Mestrando do Instituto de Pesca estuda aspectos fisiológicos e potencial de transmissão viral em tilápias
- ► Junho (20)
- • Instituto Agronômico completa 138 anos com produtos inéditos
- • Festa Junina: Dois dias de festa no Instituto Biológico
- • Instituto de Pesca orienta manejo de espécies durante o inverno
- • CCD Circula: Pesquisa paulista impulsiona economia circular
- • Parceria entre Aptahub e Inova Prudente fortalece inovação no agro paulista
- • Instituto de Zootecnia leva pesquisa e inovação para Feicorte 2025
- • Museu de Pesca de Santos é contemplado com projeto de modernização museográfica pelo ProAC
- • Consumo de responsável de pescado foi tema de debate em seminário do Instituto de Economia Agrícola
- • Diretor-geral do IAC recebe duas homenagens na mesma semana
- • IAC firma parceria com a Orplana
- • Inovação, conhecimento e conexões: Apta traz a pesquisa no agro para a Campinas Innovation Week 2025
- • Agro Paulista tem superávit de US$8,54 bilhões nas exportações, apesar de tarifaço americano e gripe aviária
- • JBS e Ital inauguram centro de inovação em colágeno pioneiro no mundo
- • Instituto de Pesca firma parceria com a UFRPE dedicada ao tema dos petrechos de pesca
- • Parceria entre Agricultura e Segurança Pública fortalece policiamento com doação de cavalos
- • Ital interage com setor de produtos naturais e consumidores na capital paulista
- • Projeto Petrechos de Pesca: conservação e sustentabilidade para a proteção dos oceanos
- • Brasil fortalece laços internacionais para reduzir emissões de metano na pecuária
- • Com apoio da Secretaria de Agricultura, 50ª Expocitros destaca força da citricultura paulista
- • Apta Regional exibe inovações que impulsionam o agronegócio paulista no GAFFFF 2025
- ► Maio (20)
- • Instituto de Pesca leva conhecimento técnico e inovação para a Aquishow Brasil 2025
- • Pesquisa com participação do Instituto de Pesca contribui com a gestão de reservatórios paulistas
- • Xenotransplante: Instituto de Zootecnia apresenta pesquisa na Câmara de Piracicaba
- • Agro Summit 2025: IAC expõe tecnologias nas áreas de Inteligência Artificial, segurança do trabalho e irrigação
- • Mestrado em Ciência e Tecnologia de Alimentos do Ital recebe inscrições até 16 de junho
- • Hortitec 2025: IAC expõe recentes tecnologias nas áreas de horticultura e sanidade
- • Ital oferece pós-doc dedicado a reciclagem de plásticos pós-consumo
- • Valor da Produção Agropecuária paulista em 2024 será tema de debate em seminário do Instituto de Economia Agrícola
- • IZ celebra dia do Zootecnista, profissional essencial para a produção animal
- • Agro paulista registra superávit de US$ 6,72 bilhões com bom desempenho da carne bovina, suco de laranja e café
- • Novo livro trilíngue do Ital sobre urucum explora suas atividades fitoterápicas
- • IAC avalia crescimento de mudas de Paineira Rosa adubadas com composto orgânico e inoculante biológico
- • Produtor terá acesso gratuito a dados agrometeorológicos
- • Instituto Agronômico difunde uso de plantas aromáticas e medicinais
- • Parceria com criadores impulsiona produção e qualidade do rebanho de búfalos em São Paulo
- • Teste de Eficiência Alimentar de Bovinos e Ovinos
- • Ferramentas eficazes no uso racional da água na agricultura irrigada
- • Apta Regional leva técnicas agroecológicas e inovações à cadeia produtiva da mandioca e arroz
- • Ital, em parceria com a Cati, destaca ciência e inovação alimentar
- • Instituto Biológico apresenta inovações em sanidade e controle biológico na avicultura durante a Agrishow 2025
- ► Abril (19)
- • Agrishow 2025: IEA apresenta soluções e tecnologias para impulsionar a economia agrícola
- • Agrishow 2025: IAC lança batata-doce alaranjada biofortificada
- • Público da Agrishow 2025 poderá conhecer diferenças das funções de adjuvantes e sua importância
- • Instituto de Pesca apresenta inovações que impulsionam a aquicultura
- • Agrishow 2025: Caravana Giro do Leite, do IZ, promove melhoria na cadeia produtiva
- • Nova cultivar IAC de feijão carioca, o IAC 2560 Nelore, será apresentada na Agrishow 2025
- • Agrishow 2025: Conheça todas as atrações que a Apta leva para a Feira
- • Instituto de Pesca sedia 5ª edição do Fly Fishing Festival em São Paulo
- • Área do Instituto de Zootecnia, em Nova Odessa (SP), servirá de abrigo para animais abandonados
- • Ital inaugura laboratório dedicado a micro-ondas e plasma não térmico
- • Instituto de Pesca leva ciência e sabor à Santa Feira do Peixe na CEAGESP
- • Conheça os Penacos: peixes saborosos e de valor acessível para a Semana Santa
- • Comer Com Ciência completa um ano incentivando escolhas alimentares conscientes no Instagram
- • São Paulo lidera exportações do agro e fecha primeiro trimestre com superávit de US$ 4,9 bilhões
- • Pesquisa do IZ contribui para recuperação de pastagens degradadas e produção de silagens no período da seca
- • Manejo ecológico da propriedade agrícola será tema de debate em seminário do Instituto de Economia Agrícola
- • Estudo do IP contribui para a conservação de espécies e sustentabilidade da pesca
- • Pesquisa do IAC mostra que monitoramento climático contribui para a previsão e controle de pragas no milho
- • Dia da Saúde e Nutrição: Secretaria de Agricultura de SP destaca papel da ciência e da tecnologia para alimentação equilibrada
- ► Março (19)
- • Pesquisa do IP avalia peixes do reservatório de Três Irmãos e aponta desafios à conservação
- • Apta mostra resultados de pesquisa durante a Fruit Attraction SP
- • Inovação feminina na ciência é destaque em roda de conversa sobre sustentabilidade e mudanças climáticas
- • Ital capacita setor de carnes e produtos cárneos a determinar prazos de validade
- • Mestrando do IP avalia técnicas inovadoras para criação de tilápias
- • Dia da Aquicultura: Secretaria de Agricultura de SP aposta em pesquisa e inovação para desenvolver setor
- • IAC sedia campeonato brasileiro de preparo de cafés especiais filtrados
- • Pesquisa avalia viabilidade econômica do cultivo de soja precoce em solo arenoso
- • Agro Paulista registra superávit de US$ 3,01 bilhões, apesar de queda nas exportações no primeiro bimestre de 2025
- • Ital e Unicamp oferecem duas bolsas de pós-doc em Ciência e Tecnologia de Alimentos
- • Startups aceleradas pelo AptaHub levam inovação a evento de DeepTechs em Paris
- • Mudança de uso da terra impacta no carbono do solo
- • Apta participa da Delegação Brasileira de Deeptechs em Paris para fortalecer parcerias internacionais
- • Tour de Soja: Apta Regional de Brotas traz ao produtor atualizações tecnológicas para cultura
- • Diretora-geral do Ital receberá prêmio conhecido como o Oscar do agronegócio
- • “Ponto de encontro para o conhecimento”: Bibliotecas históricas dos institutos de pesquisa da Apta são patrimônio do agro
- • São Paulo é líder nacional em startups voltadas ao agronegócio
- • Sensoriamento remoto na estimativa de produtividade da cana-de-açúcar será tema de debate em seminário do Instituto de Economia Agrícola
- • Instituto Biológico destaca inovações em vacinas no Encontro de Biotecnologia da Unicamp
- ► Fevereiro (16)
- • Instituto de Pesca sedia Encontro do Comitê Gestor sobre Prevenção e Combate a Queimadas de São José do Rio Preto
- • Instituto de Pesca orienta sobre alimentação com pescado no Carnaval
- • Pesquisador do Ital assume cargo no Conselho Federal de Engenharia e Agronomia
- • Apta divulga classificação do concurso para pesquisadores científicos
- • Instituto de Pesca busca tornar viável a produção de camarões longe do mar
- • Vale do Paraíba - Dia de Campo apresentará aos produtores de leite novos cultivares de milho e evolução dos resultados de produtividade
- • Agronegócio paulista registra superávit em janeiro, mas desempenho é inferior ao ano passado
- • Agronegócio paulista registra superávit em janeiro, mas desempenho é inferior ao ano passado
- • Projeto premiado do Instituto Biológico revoluciona diagnóstico de doenças virais em aves
- • Dia de campo da Apta Regional de Andradina destaca inovações em cultivo de soja, milho e sorgo
- • Instituto de Zootecnia pesquisa nutrição livre de antibióticos para suínos
- • Instituto de Pesca investiga vírus ISKNV, que afeta sanidade de peixes e causa prejuízos à piscicultura
- • Institutos de pesquisas ligados à Secretaria de Agricultura de SP apoiam jovens cientistas
- • Pesquisas revelam alta satisfação com serviços e eventos do Ital
- • Ministério da Agricultura apresenta projeto de inovação para coordenaria da Agência Paulista de Tecnologia dos Agronegócios
- • Estudo de aluna do Instituto de Pesca revela os benefícios do perifíton na produção sustentável de peixes e hortaliças
- ► Janeiro (8)
- • Parceria entre Brasil e França visa a introdução de Tecnologias Queijeiras em São Paulo
- • Secretaria de Agricultura de SP na 18ª Coopershow leva destaques em inovação e sustentabilidade para produtores rurais
- • Capes define novos procedimentos de avaliação de artigos científicos
- • Ital promove encontro, conferência internacional, dois seminários e 36 cursos em 2025
- • Agro Paulista lidera a pauta de exportação nacional em 2024 e registra superávit 5,8% maior em comparação ao ano anterior
- • Novo sistema do Ital disponibiliza a clientes relatórios e avaliações de serviços
- • Secretaria de Agricultura e Abastecimento de SP atinge metas e servidores são reconhecidos
- • Ital impulsiona novas bebidas não alcoólicas saudáveis e funcionais
- ► Dezembro (17)
- ► 2024 (219)
- ► Dezembro (18)
- • Pesquisas do Instituto de Pesca revelam potencial gastronômico da CMS de peixe
- • Renata Branco, pesquisadora científica do IZ-Apta, é reconhecida como uma das zootecnistas mais influentes do agronegócio em 2024
- • Inédito concurso nacional de geleias artesanais e tradicionais recebe inscrições até 23 de fevereiro
- • Instituto de Pesca é a única instituição no Brasil a cultivar gametófitos da macroalga Kappaphycus alvarezii
- • Niágara Rosada: Apta Regional apresenta pesquisas sobre videira para estudantes de universidade
- • Projeto Petrechos de Pesca coleta mais de 1 tonelada de redes de pesca para reciclagem
- • Prêmio Apta Semeador do Futuro 2024: reconhecendo destaques da Pesquisa e do Agronegócio
- • Pesquisadora do IAC é nomeada para ocupar a cadeira 77 da Associação Brasileira de Ciência Agronômica (ABCA)
- • 1º CONCURSO ESTADUAL: Secretaria de Agricultura divulga lista com as melhores cachaças paulistas
- • Núcleo de Pesquisa Pescado para Saúde revela perfil de consumo do pescado paulista
- • Secretaria de Agricultura de SP assina parceria para promover setores de vinho e cachaça
- • Dr. Edison Barbieri é reconhecido como um dos pesquisadores mais influentes do mundo
- • IAC disponibiliza quatro novos Boletins Técnicos sobre um porta-enxerto e três variedades de café mais recentes
- • Maior produtor nacional, São Paulo premia as melhores cachaças paulistas
- • Apta Regional de Ubatuba e Unesp estabelecem cooperação de pesquisa, desenvolvimento e inovação para agricultura familiar no Litoral Norte de SP
- • Apta Regional de Andradina realizará fórum para intensificar a produção de frutas com uso de tecnologias sustentáveis
- • Núcleo de Pesquisa Pescado para Saúde lança o concurso de receitas “Festas com Sabor de Pescado”
- • Área do Instituto de Zootecnia em Nova Odessa será utilizada para equoterapia
- ► Novembro (21)
- • Apta Regional impulsiona o desenvolvimento da cadeia produtiva do Jatobá
- • Secretaria de Agricultura premia os melhores grãos no Concurso “Qualidade do Café de SP”
- • Feicorte: Instituto de Zootecnia de SP apresenta pesquisas de melhoramento genético bovino em Presidente Prudente
- • IAC desenvolve estudo sobre novos clones de seringueira em parceria com Michelin/Cirad e Apabor
- • Adriana Verdi concorre ao Prêmio Mulheres do Turismo Paulista
- • Mestrando do Instituto de Pesca desenvolve estudo inovador sobre crescimento muscular de truta arco-íris
- • Feicorte - Planejamento para terminação da carçaca é apresentado por pesquisador da Secretaria de Agricultura de SP
- • Instituto de Pesca celebra 60 anos de sua unidade em Campos do Jordão
- • Instituto de Pesca apoia o Dia Mundial da Pesca e da Luta pela Pesca Artesanal
- • Impulsione sua Carreira: Bolsas de Pós-Doutorado em Biologia Celular, Molecular e Biotecnologia oferecidas pelo Instituto Biológico
- • Publicações do Instituto de Pesca: conhecimento ao alcance de todos
- • Países se mobilizam para construir uma estrutura global para segurança do trabalhador em aplicação de agroquímicos
- • Instituto de Zootecnia recebe visita da Fealq
- • Agro Paulista registra alta de 11,2% nas exportações e se mantém como líder nacional
- • Expedição Bééé Brasil visita IZ
- • Começa a etapa de provas do Concurso Estadual “Qualidade do Café de São Paulo”
- • Riscos e perigos em carnes e bem-estar animal estão entre temas discutidos em seminário on-line do Ital
- • Com experiência adquirida no Instituto de Pesca, pesquisador se destaca na Suécia
- • Referência para o agro, Instituto de Economia Agrícola de São Paulo comemora 82 anos
- • Instituto Biológico comemora 97 anos de excelência em pesquisas e inovações em prol do agro de SP
- • Revista liderada pelo Ital repercute pesquisas de pasta de chocolate com pouca gordura saturada e cerveja obtida por processo alternativo
- ► Outubro (23)
- • APTA PORTAS ABERTAS: Abertura dá a largada para jornada de difusão das pesquisas que impulsionam o agronegócio
- • Pesquisadores do IZ das áreas de pastagem e de nutrição animal se qualificam no exterior
- • Apta Regional de Marília analisa indicadores econômicos de cultivares de café arábica
- • Parceria entre CATI e IAC impulsiona a produção de batata de origem nacional na região de Botucatu
- • Instituto de Pesca promete trazer inovação e conhecimento para o Seafood Show Latin America 2024
- • Comer Com Ciência incentiva decisões alimentares mais coerentes e conscientes
- • AptaHub participa do Agro Innovation Week no Fórum Usinas do Futuro
- • Dia Nacional da Pecuária: Secretaria de Agricultura de SP contribui com ações para alavancar o setor
- • Pesquisador do IAC toma posse na quinta Cátedra “Luiz de Queiroz”
- • Secretaria de Agricultura de SP estuda investimentos em estações meteorológicas no Estado
- • No Dia da Pecuária, IZ destaca sua contribuição para a atividade
- • Live do IZ discute importância da ingestão de leite para o desenvolvimento de crianças e adolescentes
- • São Paulo lidera exportação agropecuária do Brasil em 2024
- • Secretaria de Agricultura participa da 67ª Semana “Luiz de Queiroz”, da Esalq/USP
- • Assinatura de contrato favorece acesso aos medicamentos fitoterápicos em rede pública
- • Institutos de pesquisa da APTA abrem as portas na Semana da Ciência
- • Pesquisadores das áreas de melhoramento genético e de biotecnologia do IZ aprimoram qualificação com estágios no exterior
- • Pesquisadores do Instituto de Pesca expandem colaborações nos EUA
- • Pesquisa do IZ sobre controle de mastite em vacas leiteiras é premiada em congresso
- • Apta apresenta trabalho dos institutos de pesquisa para diretores do Centro Alemão de Ciência e Inovação
- • Secretaria de Agricultura destaca o Dia Internacional do Café com os trabalhos da pesquisa científica e extensão rural
- • Dia Mundial do Turismo: Com o Programa Rotas Rurais, visitantes chegam as atrações do agro no interior paulista
- • APTA PORTAS ABERTAS 2024 - Confira a Programação
- ► Setembro (14)
- • Pesquisa do IAC registra pela 1ª vez transmissão da bactéria causadora da escaldadura das folhas da cana por um inseto vetor
- • Em evento realizado no IZ, especialistas esclarecem dúvidas sobre o controle do carrapato estrela, capivaras e febre maculosa
- • Sustentabilidade para a agropecuária brasileira será tema de debate em seminário do Instituto de Economia Agrícola
- • Dia da Banana: Secretaria de Agricultura de SP aposta no melhoramento genético e em medidas fitossanitárias
- • IAC-Apta participa da Agrotech Expo 2024 com variedades em batata, batata-doce e grãos
- • A Cachaça: bebida brasileira e sua evolução na terra da cana
- • "Tem Peixe na Vila" é sucesso de público
- • DIA DA CACHAÇA: Melhores de SP serão anunciadas no Primeiro Concurso Estadual em dezembro
- • Ital abre processo seletivo para mestrado em Ciência e Tecnologia de Alimentos
- • APTA e Instituto de Economia Agrícola sediaram divulgação do PAM 2023 pelo IBGE
- • IZ sedia o XXXII Treinamento em métodos de diagnóstico e controle de brucelose e tuberculose animal
- • Núcleo Regional de Pesquisa do IAC em Mococa mostra estudos de cana-de-açúcar para coordenadoria da APTA
- • Apta participa do 2º Fórum Brasileiro de Deep Techs
- • Núcleo Regional de Pesquisa do Litoral Sul recebe coordenadoria da Apta
- ► Agosto (5)
- • Coordenadoria da APTA visita núcleos de pesquisas do IAC em Capão Bonito e Itararé
- • Governo de SP inaugura novo espaço de inovação para o agro na capital paulista
- • Em sua segunda edição, Festa Tem Peixe na Vila vai aproximar o público do universo do pescado
- • Moringa pode ser ótima alternativa de forragem alimentar para ruminantes na seca
- • Prêmio “Victória Rossetti” é concedido a bolsista Pibic do IB
- ► Julho (21)
- • Herbário IAC completa 89 anos de existência com novidades
- • No Dia do Produtor Rural, conheça algumas iniciativas da Apta em prol de quem traz alimento para a população
- • Recursos dos Futuros Planos Safra serão tema de debate em seminário do Instituto de Economia Agrícola
- • Instituto de Pesca divulga novos estudos sobre macroalga com amplas utilidades no setor produtivo
- • APTA de Presidente Prudente mostra pesquisa de melhoramento genético de batata-doce para coordenadoria
- • Na Batatec 2024, produtores e consumidores têm a oportunidade de conhecer novas variedades da Apta
- • Coordenadoria da Apta visita Núcleo Regional de Pesquisa de Jaú "Hélio de Moraes" do IAC
- • Unidade de pesquisa avícola do Instituto Biológico recebe coordenadoria da Apta
- • Instituto de Zootecnia celebra 119 anos em evento com grande participação da população
- • Coordenadoria da Agência Paulista de Tecnologia dos Agronegócios visita APTA Regional de Bauru
- • Pós em Ação! Estudo de aluna do Instituto de Pesca revela impactos do desastre de Brumadinho na Aquicultura e Pesca
- • Superávit do Agro Paulista cresce 9,4% no primeiro semestre de 2024 comparado ao ano passado
- • Apta leva cultivares melhoradas e palestras científicas para as festas do Bunkyo e do Gengibre
- • Instituto de Zootecnia comemora 119 anos de pesquisa e inovação na agropecuária
- • Dia mundial do chocolate é celebrado pelas instituições da Secretaria de Agricultura com resultados técnico-científicos
- • Ital sediará centro de inovação em colágenos pioneiro no mundo
- • Instituto de Pesca da APTA apresenta no Senado Federal projetos para pesquisa da Kappaphycus alvarezii
- • Dia Nacional da Ciência: maior agência estadual de pesquisa agropecuária do Brasil, Apta mostra que o conhecimento se constrói a muitas mãos
- • Produtores de Orgânicos de Assis e Região buscam capacitação em sistemas agroflorestais na Apta Regional
- • SAA presente na cerimônia de lançamento do Plano Safra 24/25 e Plano Safra da Agricultura Familiar
- • Produtores artesanais se preparam para o Arraiá da Vila, no Instituto Biológico
- ► Junho (24)
- • IAC comemora 137 anos com a casa cheia
- • Ital inicia parceria com PUC-Campinas para formar novos engenheiros de alimentos
- • Pós em Ação!: mestrando do Instituto de Pesca desenvolve pesquisa sobre sanidade na piscicultura
- • Instituto de Zootecnia organiza evento técnico sobre produção de mini cabras, sensação no universo pet
- • IAC completa 137 anos com nova patente de método inovador para retardar o amadurecimento de frutos
- • Secretaria de Agricultura de SP anuncia novas medidas para retomada da produção de borracha natural no estado
- • Secretaria de Agricultura prestigia homenagem do governo francês ao presidente da FAPESP
- • Secretaria de Agricultura paulista participa com cogumelos da Apta Regional do prêmio Melhores da Gastronomia 2024
- • Dia Internacional das Engenheiras: Mesmo minoria no setor, mulheres são referências para gerações futuras
- • IZ oferece curso sobre Melhoramento Genético
- • Especialista do Instituto Biológico é eleito presidente da maior associação mundial voltada à saúde de bovinos
- • Curso do IZ ensina a técnica de PCR quantitativa
- • Secretaria de Agricultura marca presença na HORTITEC 2024 com pesquisa, assistência técnica e defesa voltadas ao setor hortícola
- • Instituto de Pesca lança série "Pós em Ação!"
- • Superávit do Agronegócio Paulista impulsiona Balança Comercial do Estado nos cinco primeiros meses
- • Núcleo de Pesquisa Pescado para Saúde participa do Conexidades 2024
- • Parceria em pesquisa entre Ital e instituto alemão Fraunhofer IVV completa 10 anos
- • Institutos de pesquisa da Apta participam da Campinas Innovation Week, trazendo debates sobre agricultura, alimentos, ambiente e novas tecnologias
- • Conexidades: Secretaria de Agricultura de SP apresenta ações e assina convênios com municípios em São Sebastião
- • Expocitros: SP libera linha de crédito para produtores de laranja atingidos pelo Greening
- • Evento internacional sediado no Ital aborda desafios e possibilidades da inovação em alimentos
- • Instituto de Pesca celebra o Junho Verde
- • Dia Mundial do Leite: Pesquisadores da Secretaria de Agricultura atuam em prol do setor leiteiro em todo o Estado de São Paulo
- • Ital recebe inscrições para 25ª edição do Curso de Industrialização do Palmito em Conserva
- ► Maio (21)
- • Apta participa do Conexidades 2024 com Núcleo de Pesquisa Pescado para Saúde e Programa Rotas Rurais
- • Aquishow 2024: Instituto de Pesca conquista vários prêmios
- • Secretaria de Agricultura de SP inaugura sexta unidade do AptaHub
- • Censo Agropecuário e a abordagem de gênero das estatísticas rurais serão debatidos pelo Instituto de Economia Agrícola
- • IZ promove treinamento em métodos de diagnóstico e controle de brucelose e tuberculose, doenças graves que acometem o gado
- • No Dia Nacional do Café, Secretaria de Agricultura anuncia nova edição do concurso para eleger os melhores grãos do Estado
- • Com café em alta, SP abre as portas do maior cafezal urbano do mundo
- • Instituto Biológico (IB-Apta), na capital paulista, abre suas portas para o lançamento do Concurso Estadual “Qualidade do Café de São Paulo”
- • Dia Internacional da Biodiversidade: pesquisas da Apta lembram que, sem preservação ambiental, não há alimento
- • Instituto de Pesca no Aquishow 2024: inovação e ações estratégicas para aquicultura
- • Agro Paulista registra superávit de US$7,51 bilhões, aumento de 21,7% comparado ao primeiro quadrimestre do ano passado
- • DIA DAS MÃES: Secretaria de Agricultura parabeniza mulheres que dedicam suas vidas profissionais ao agro
- • Dia do Zootecnista: referência em SP e no Brasil, IZ segue impulsionando o conhecimento na área
- • Pesquisador da Apta concorre a prêmio brasileiro de Aquicultura
- • Pesca Marinha e Estuarina em São Paulo será debatida pelo Instituto de Economia Agrícola
- • Apta Regional pesquisa uso inédito da macaúba em sistemas integrados de produção
- • Responsável por 22,3% dos empregos na fabricação de sorvetes e gelatos do Brasil, SP estimula evolução do setor
- • IZ recebe visita de pesquisadores que discutem a produção de suínos doadores de órgãos para transplante
- • AGRISHOW 2024: APTA Regional pesquisa nova variedade de banana prata encontrada no Vale do Ribeira
- • AGRISHOW 2024: Variedades de cana-de-açúcar do IAC-Apta são expostas na maior feira da América Latina
- • Secretaria de Agricultura de SP expõe na Agrishow 2024
- ► Abril (26)
- • APTA se reúne a entidades parceiras em evento do Corredor Agro SP, durante a Agrishow 2024
- • Apta presente na abertura da 29° Agrishow
- • Conheça a Comissão de Ética de Uso de Animais do Instituto de Pesca
- • Apta prestigia lançamento da Rota do Queijo Artesanal pela Emater do Distrito Federal
- • Secretaria de Agricultura de São Paulo marca presença na solenidade dos 51 Anos da Embrapa
- • Ital recebe inscrições para mestrado em Ciência e Tecnologia de Alimentos
- • Dia Mundial do Livro: em parceria com a filha, pesquisador do Instituto Biológico cria obra para ensinar às crianças a importância dos nematoides
- • APTA Regional abre inscrições para o Programa de bolsas de Iniciação Científica vinculadas a projetos de pesquisa
- • Ital sedia congresso latino-americano de sorvetes focado em resiliência, competitividade e sustentabilidade do setor
- • Secretaria de Agricultura de SP avalia instalação de biodigestor no Instituto Biológico
- • Dia Nacional da Conservação do Solo: IZ destaca importante pesquisa sobre o tema
- • Centro de pesquisa liderado pelo Ital oferece pós-doc em Ciência, Tecnologia e Engenharia de Alimentos na USP
- • DIA MUNDIAL DO CAFÉ: São Paulo é berço do maior cafezal urbano do mundo
- • Programa do Instituto de Pesca busca transformar resíduos em biofertilizantes para agricultura
- • IZ realiza cursos voltados a bovinocultura leiteira
- • Balança Comercial do Agro Paulista registra alta de 23,4% no primeiro trimestre de 2024
- • Instituto de Pesca celebra aniversário de 55 anos
- • Secretaria de Agricultura lança Programa Cacau SP no Vale do Ribeira
- • Santos ganha unidade do AptaHub, espaço para fomentar a inovação na área da pesca
- • LÍDER NACIONAL: Produção paulista de abacate cresce mais de 8,5% em 2023
- • Apta Regional realiza Dia de Campo voltado à produção leiteira no Vale do Paraíba
- • CACHAÇA.SP: Inscrições para o 1º Concurso Estadual da bebida terminam em um mês
- • Cooperação entre Secretaria de Agricultura de SP e instituto alemão Fraunhofer fortalece inovação em alimentos, recursos biológicos e embalagem
- • Instituto de Pesca orienta sobre o consumo de pescado durante dias de altas temperaturas no país
- • Voltado a produtores e técnicos, evento irá abordar o tema “silagem no Noroeste Paulista”
- • Ital disponibiliza anais de inédito congresso internacional de queijos
- ► Março (29)
- • Pesquisa do Instituto de Pesca avalia complemento alimentar para piscicultura de pequeno porte
- • Pioneiro, Boletim do Instituto de Pesca está entre periódicos de alto impacto
- • Instituto de Pesca produz a primeira linhagem clonal de truta arco-íris no Brasil
- • Palestrantes renomados abrilhantaram a 9° edição do Curso do IZ sobre carne ovina
- • Instituto de Pesca e Marinha do Brasil unidos pela aprendizagem
- • Dia Mundial da Água: Pesquisas do IZ contribuem para economia do recurso nos sistemas de produção animal
- • 90% da água usada na irrigação retorna ao ambiente pela transpiração das plantas
- • Núcleo de Pesquisa Pescado para Saúde inicia etapa experimental para produzir tilápia mais nutritiva
- • Museu inovador e tecnológico do agro é apresentado na Secretaria de Agricultura de SP
- • Núcleo de pesquisa liderado pelo Ital seleciona bolsista de pós-doc na Unicamp
- • IZ realiza capacitação voltada à técnica de PCR Convencional
- • “PRÊMIO APTA SEMEADOR DO FUTURO” homenageia servidores e personalidades de destaque no agro em 2023
- • Balança Comercial: São Paulo lidera entre os principais estados exportadores do agro
- • Secretaria de Agricultura de SP estuda termo de cooperação com empresa internacional de sementes vegetais
- • Reforma tributária e alimentação saudável serão debatidos pelo Instituto de Economia Agrícola
- • III Festa do Cacau no Instituto Biológico acontece em 23 e 24 de março!
- • Instituto de Zootecnia passa a oferecer exame que diagnostica parasitas no sangue de cães
- • Instituto Biológico realiza aula inaugural da pós-graduação: momento único de inspiração e conexão
- • Secretaria de Agricultura inaugura AptaHub em Ribeirão Preto
- • Avanços Científicos na Saúde Pública: Colaboração entre Instituto Biológico e Prefeitura de São José dos Campos tem êxito no controle do carrapato-estrela
- • Instituto de Pesca é palco da reunião da Câmara Setorial de Produção, Extrativismo e Indústria de Pescados
- • AptaHub inaugura polo de inovação no agro em Ribeirão Preto
- • Pós-Graduação IAC passa a integrar Programa de Mentoria Universitária Bayer
- • Instituto de Pesca sediará reunião da Câmara Setorial de Produção, Extrativismo e Indústria de Pescados
- • Com azeites premiados, olivicultura paulista é reconhecida internacionalmente
- • Inscrições abertas para o LXIII curso de habilitação para emissão de CFO/CFOC
- • Lançado em São Paulo Anuário Peixe BR da Piscicultura 2024
- • Curso do IZ sobre carne ovina chega a sua 9° edição; inscreva-se!
- • Instituto de Pesca publica estudos sobre novas linhagens de macroalga com amplas aplicações industriais e para o agro
- ► Fevereiro (14)
- • Termina em 28/02 o período de defeso da piracema
- • Institutos de pesquisa da Apta expõem na Coplacampo tecnologias e serviços ao produtor
- • Governo de São Paulo participa da abertura da Coplacampo em Piracicaba
- • Treinamento realizado no Instituto de Zootecnia capacita médicos veterinários para o diagnóstico de importantes doenças na bovinocultura
- • Ital amplia pesquisa e desenvolvimento de materiais de embalagem de produtos diversos
- • Saúde, segurança e inovação na produção de queijos serão abordados em congresso internacional inédito no Ital
- • Lançamento do Programa Propaga SP: investimento de mais de R$ 4 milhões do Governo de SP impulsiona produção de mudas da CATI, com sustentabilidade econômica e redução de plásticos na natureza
- • Satisfação de clientes do Ital supera 95,5% por três anos consecutivos
- • Plantio de amendoim direto na palha reduz custo de produção em até 20% e erosão do solo em 90%
- • Instituto de Pesca orienta pescadores para obter licença de pesca
- • Balança Comercial do agro de SP atinge superavit de US$ 1,73 bi em janeiro, 20% superior ao registrado no ano passado
- • DIA DO FEIJÃO: Variedade carioca tem origem paulista e é o preferido do brasileiro
- • Instituto de Pesca indica melhores pescados para foliões
- • SAA ITINERANTE: Profissionais da Apta, Cati e CDA fazem atendimento a lideranças do agro no Vale do Paraíba
- ► Janeiro (3)
- ► Dezembro (18)
- ► 2023 (281)
- ► Dezembro (21)
- • Agronegócio de São Paulo registra superávit de US$ 20,65 bi
- • CCD de Sanidade em Piscicultura apresenta ações e resultados de pesquisas
- • Agricultor familiar, de Santo Antonio da Alegria, produz o melhor café fermentado de SP e já levou dois prêmios
- • Ital recebe homenagem inédita em sessão solene do Crea-SP
- • SP+Orgânicos: Secretaria de Agricultura apresenta pesquisas e projetos para o desenvolvimento da agroecologia
- • Pleapo: Secretaria de Agricultura assina Plano de Incentivo para Orgânicos e Agroecológicos
- • Concurso Cachaça.SP: resgate cultural da bebida foca na sustentabilidade da cadeia da cachaça paulista
- • Aos 60 anos, Ital lança livro histórico em que destaca sua atuação na última década
- • Secretaria de Agricultura reúne produtores rurais para lançar o 1º Concurso Estadual da Cachaça Paulista
- • Instituto de Pesca atua na reparação de danos causados pelo desastre em Mariana (MG)
- • Instituto de Pesca: Núcleo de Pesquisa estuda consumo de pescado no Estado de São Paulo
- • Sanidade Animal - Câmara Setorial de Ovinos e Caprinos se reúne e retoma pauta sobre cadastramento de rebanho
- • Pesquisa revela o consumo de café no Brasil nos períodos pré, durante e pós-pandemia
- • Prédio do Instituto Biológico e sede da Secretaria de Agricultura podem ser restaurados
- • Secretaria de Agricultura de São Paulo inaugura auditório na Apta em Pariquera-Açu
- • Estudantes visitam Ital no Apta Portas Abertas
- • Campos experimentais e laboratórios da Apta Regional recebem a visita da sociedade na 2ª edição “Apta Portas Abertas”
- • “Apta Portas Abertas”: Ações de pesquisa e de tecnologia realizadas pelo Instituto de Zootecnia são apresentadas em evento
- • Secretaria de Agricultura participa, na Apta Regional de Pariquera-Açú, de inauguração e abertura da 2ª edição “Apta portas Abertas”
- • Governo do Estado premia melhores cafés especiais de SP e inaugura espaços de inovação do agro
- • Secretaria de Agricultura inaugura duas unidades da AptaHub e homenageia Alysson Paolinelli
- ► Novembro (16)
- • Ecossistema de inovação de São Paulo ganhará 6 novos espaços para o desenvolvimento de startups com foco no agro
- • Estratégias para fomentar o ecossistema da inovação é tema de reunião na Secretaria de Agricultura de SP
- • IAC e CATI realizam o 15º Seminário de Agregação de Valor em Horticultura
- • Instituto de Pesca recebe visita de pesquisadores da Itaipu Binacional
- • IAC lança porta-enxerto de café multirresistente a nematoides
- • Concurso do Café de SP encerra fase de degustação com quase o dobro de inscritos
- • Secretaria de Agricultura apresenta projeto de desenvolvimento do agro paulista em encontro sobre economia ecológica no Pará
- • Pioneiro em dados para o agro, Instituto de Economia Agrícola comemora 81 anos de história
- • Nascimento de Jumentinhos: APTA Regional celebra crescimento do principal núcleo de preservação de Jumento Nacional no Brasil
- • Instituto de Zootecnia realiza Curso sobre Manejo de Vacas Secas
- • Instituto de Zootecnia fecha parceria inédita que prevê a criação de suínos para transplantes
- • Setor em expansão: produção de pescados no Brasil cresceu 25% em 2022
- • Setor em expansão: produção de pescados no Brasil cresceu 25% em 2022
- • Instituto Biológico comemora 96 anos
- • IAC tem suas análises de fertilizantes orgânicos e calcário certificadas pelo Inmetro
- • Secretaria de Agricultura de SP destaca papel da tecnologia para garantir o futuro da alimentação
- ► Outubro (24)
- • Instituto de Pesca orienta sobre início do Defeso da Piracema, em 1º de novembro
- • Instituto de Pesca mostra a importância da pesquisa no cenário do agronegócio do pescado
- • Duas cientistas do Instituto Agronômico estão entre as 100 mulheres doutoras do agro
- • Simpósio Brasileiro de Óleos Essenciais 2023 visa fortalecer os diferentes elos da cadeia produtiva
- • Instituto da Apta é reconhecido internacionalmente com pesquisa em sanidade vegetal
- • IZ realiza Curso Teórico-Prático sobre o Método Famacha© no Controle da Verminose em Ovinos
- • AptaHub abre inscrições para Programa de Residência para impulsionar deeptechs do agro paulista
- • Com Portas Abertas, Institutos de pesquisa da APTA recebem população para mostrar a ciência do agro paulista
- • Secretaria de Agricultura inaugura centro de pesquisa, desenvolvimento e inovação que visa ser referência em ecossistema de alimentos
- • Instituto de Pesca orienta pescadores para obter licença pelo PesqBrasil
- • Semana do arroz e feijão, o par perfeito da alimentação do paulista
- • Tropical Food Innovation Lab chega para impulsionar a inovação na indústria de alimentos na América Latina
- • Delegação do Governo do DF visita instituições e agroindústrias de SP visando criar rota do queijo
- • IZ comemora Dia do Ovo com pesquisas e serviços que contribuem para melhor qualidade do alimento e bem-estar animal
- • Na semana Luiz de Queiroz, Secretaria de Agricultura e Abastecimento transfere gabinete para Piracicaba
- • Pesquisa realizada no IZ aponta técnicas que promovem sequestro de carbono em pastagens
- • Economia circular, sustentabilidade e logística reversa são foco de bolsa de pós-doutorado oferecida pelo Ital
- • Apta Regional difunde as vantagens do uso de enxertia de arábica em cafeeiros de canéfora, na TecnoCafé 2023
- • Polinização guiada estudo da Apta Regional e startup treinam abelhas para aumento de produção cafeeira
- • Calor excessivo afeta produção de hortaliças, pescados e reprodução animal
- • II Workshop de Carne de Qualidade do IZ abordará avanços tecnológicos e práticas de sucesso no setor
- • Núcleo de Pesquisa Pescado para Saúde comemora um ano
- • Ital abre inscrições para mestrado em Ciência e Tecnologia de Alimentos durante o mês de outubro
- • Com crescimento expressivo em SP, piscicultura brasileira comemora aumento nas exportações
- ► Setembro (26)
- • Instituto de Pesca participa do Fórum de Aquicultura 4.0
- • Secretaria de Agricultura lança NeuTroPec em São José do Rio Preto
- • Apta Regional coordena Simpósio de produção de mudas de alta qualidade
- • Instituto de Zootecnia lançará Centro de Ciência para Neutralidade Climática da Pecuária de Corte na 60ª Expo Rio Preto 2023
- • Governo de São Paulo apresenta ações para transição energética à delegação norte-americana
- • Com o objetivo de combater o Greening em SP, encontro reúne representantes da citricultura e técnicos da Secretaria
- • Evento no Instituto Biológico marca início da Primavera e reúne moradores do bairro e população em busca de conhecimento científico e diversão
- • Jovens do Projeto do Futuro de Catanduva vivenciam um dia de campo na área de mudas e sementes da Apta Regional
- • Secretaria de Agricultura cria Câmara Setorial do Queijo Artesanal e cadeia produtiva elege primeiro presidente
- • Bolsa de pós-doutorado oferecida pelo Ital visa pesquisar sustentabilidade e avaliação de ciclo de vida
- • Líder nacional, São Paulo produz 26% da banana do país
- • Apta Regional e IB fazem intercâmbio científico em sistemas agroflorestais
- • Núcleo de pesquisa de ingredientes liderado pelo Ital oferece bolsa de doutorado na USP de São Carlos
- • Instituto de Pesca no Aquaculture Europe 2023
- • Oportunidades de Estágio Curricular no Instituto de Pesca
- • Oportunidades de Estágio Curricular no Instituto de Pesca
- • Superávit no agro paulista totaliza US$ 14,4 bilhões no acumulado de 2023
- • ESPECIAL: Câmara Setorial do Amendoim atua com visão empresarial para fortalecer o agronegócio
- • Pesquisa e difusão tecnológica agrega valor à cadeia produtiva da cachaça
- • Estado de São Paulo é responsável por 90% da produção nacional de amendoim
- • Cadeia produtiva do agro paulista comemora o Dia Nacional da Cachaça
- • Pecuária sustentável no Estado de São Paulo é tema de reunião na Secretaria de Agricultura
- • Instituto de Pesca contribui para o desenvolvimento do pré-sal da Bacia de Santos
- • 17ª edição do Congresso Interinstitucional de Iniciação Científica (CIIC) premia bolsistas dos Institutos da APTA
- • Secretaria de Agricultura de SP e ESALQ-USP estudam cooperação técnica para desenvolvimento rural sustentável
- • Fim de semana voltado ao pescado no Instituto de Pesca atrai moradores da Vila Mariana, em São Paulo
- ► Agosto (34)
- • Rede social voltada ao agro comemora dezessete anos e conecta o Brasil com o mundo
- • Centro de Pesquisa do IZ contribui para formação de alunos de escola técnica
- • No aniversário de 60 anos, Ital lança site dedicado a alimentos industrializados e anuncia novos investimentos da Fapesp
- • Pesquisas do IAC apontam oito razões para plantar amendoim direto na palha
- • Apta Regional, Cati e Itesp realizam 1º Fórum de Fruticultura para assentados rurais
- • 17º Congresso Interinstitucional de Iniciação Científica CIIC 2023
- • Secretaria de Agricultura celebra o dia da avicultura com ações que promovem a sanidade e a produtividade do setor
- • Primeira edição da festa Tem Peixe na Vila apresenta atrações temáticas imperdíveis!
- • Integração Lavoura-Pecuária é tema de reunião na Secretaria de Agricultura com representantes do ILPF
- • SP expande produtividade da cana-de-açúcar com tecnologia, pesquisa e clima favorável
- • Ital lança estudo Brasil Food Safety Trends 2030 em seminário dedicado a segurança de alimentos
- • Instituto de Pesca disponibilizará tecnologias de ponta ao 1º Parque Aquícola lançado no interior paulista
- • Exportações do agro em São Paulo crescem 5,4% e atingem US$ 15,15 bilhões em julho de 2023
- • Instituto de Zootecnia apresenta resultados de pesquisa em Reprodução de Bovinos de Corte em evento nacional
- • Quantidade de isoflavonas em diferentes cultivares de soja poderá influenciar nichos de mercado
- • Instituto Biológico abre suas portas para a Festa do Chocolate com o Programa Cacau SP
- • Instituto de Zootecnia leva patrimônio genético em bovinos de corte para a ExpoGenética 2023
- • Projeto de reforma poderá viabilizar abertura do Aquário Água Branca em São Paulo
- • Seminário do Ital discutirá desafios e tendências em governança e gestão da segurança dos alimentos
- • Instituto de Pesca lança a festa Tem Peixe na Vila
- • Instituto de Pesca entrega obras de reforma do Núcleo Regional de Pesquisa do Litoral Norte
- • Borracha Natural Tratativas para cooperação técnica avançam em encontro entre Secretaria de Agricultura e CONAB
- • Pesquisador do IAC é homenageado pela FAPESP
- • Saída de produtores e redução de rebanho no mercado de leite preocupam pesquisadora do IEA
- • Rotas Rurais ganha prêmio de excelência no Gov Summit 2023
- • Produtividade na Agricultura Brasileira é o tema do Ciclo de Seminários IEA desta semana
- • Já estão abertas as inscrições para o curso de habilitação para emissão de CFO
- • APTA Regional abre inscrições para seu programa de Bolsas de Iniciação Científica
- • Visita ao Centro de Cana IAC-APTA
- • Coordenador da APTA participa de importante encontro voltado aos Citros de Mesa, no Centro de Citricultura do IAC
- • IEA lança site para cálculo de custo de produção rural
- • Pesquisadora da APTA Regional participa de debate da cadeia produtiva de plantas medicinais na agricultura familiar com ministros em Brasília
- • Centro de Pesquisa do IB em Campinas recebe visita de estudantes japoneses
- • APTA participa de reunião na Superintendência da Pesca e Aquicultura, na capital paulista
- ► Julho (31)
- • Pesquisa indica que 93% dos produtos de amendoim industrializados não têm corantes e 87% não possuem conservantes
- • Instituto de Zootecnia é premiado pela Sociedade Brasileira de Melhoramento Animal
- • Câmara Setorial e Secretaria de Agricultura traçam estratégias para fortalecer o setor de pescado
- • Agricultores de SP aumentam produção de cacau visando chocolate com maior valor agregado
- • Cafezal do Instituto Biológico é tema de reportagem de TV árabe
- • Instituto de Pesca participa do I Encontro Paulista de Limnologia
- • Expocitros Tech MAPA Conecta recebe inscrições até 15 de agosto
- • Ital recebe inscrições até segunda-feira (31) para bolsa pós-doc dedicada a proteínas vegetais
- • Dia do Suinocultor: ações da Secretaria de Agricultura e Abastecimento de SP contribuem para uma cadeia tecnificada e economicamente forte
- • Preços Agropecuários caem 2,31% em junho de 2023, confirmando viés de baixa pela sexta semana consecutiva
- • Secretaria de Agricultura pleiteia aprovação de fungo para eliminar carrapato-estrela em grandes áreas públicas
- • IAC recebe o 12.º Prêmio VISÃO AGRO CENTRO-SUL 2023
- • Perspectivas para o setor sucroenergético e plantio mecanizado norteiam 4ª Reunião do Grupo Fitotécnico de Cana IAC
- • APTA abre concurso público para contratar 37 pesquisadores científicos
- • Bolsa de pós-doc de pesquisa liderada pelo Ital recebe inscrições até quinta-feira (20)
- • Instituto de Pesca apresenta ao Ministério da Pesca e Aquicultura projeto para aumentar consumo de pescado
- • Mercado Futuro: valorização do real e aumento da produção podem dificultar a vida dos cafeicultores brasileiros
- • Aniversário do Centro de Engenharia e Automação do IAC
- • IZ completa 118 anos de pesquisas: impulsionando o desenvolvimento sustentável e o bem-estar animal
- • Agronegócios em São Paulo registram superávit de US$ 10 bilhões no primeiro semestre de 2023
- • Ações do Instituto de Pesca para a valorização da qualidade do pescado visam o desenvolvimento sustentável da cadeia produtiva
- • População de Campinas conhece ações da Secretaria de Agricultura de SP em evento dos 249 anos da cidade
- • Instituto Agronômico recebe a mais importante homenagem nas áreas científica e tecnológica no Brasil, a Medalha Nacional do Mérito Científico
- • Secretaria assina acordo de cooperação técnica do Programa Solo + Fértil
- • Previsão de Safra IEA divulga resultado do segundo levantamento
- • IAC firma parceria inédita com a Prefeitura de Tapiraí para o fortalecimento da produção de gengibre e a agricultura familiar
- • Secretaria de Agricultura participa de exposição de Ciência, Tecnologia e Inovação em celebração aos 249 anos de Campinas
- • Dia Nacional da Ciência e do Pesquisador Científico: Institutos de Pesquisa paulistas são, há mais de um século, “fonte viva do progresso” para o agro
- • Acompanhado do coordenador da APTA, secretário de Agricultura apresenta ações da Pasta para delegação de autoridades da Suíça
- • Boletim do Instituto de Pesca está no Top 10 das publicações de reconhecimento internacional
- • 26º Festival das Cerejeiras Bunkyos celebra tradições e cultura japonesa
- ► Junho (27)
- • Secretaria de Agricultura inicia tratativas para Instalação do primeiro Parque Aquícola Estadual em São Paulo
- • Coordenador da APTA recebe ex-ministro para discutir sistema de pesquisas
- • Viva os profissionais da pesca!
- • Agronegócio paulista registra US$ 8 bilhões de superávit em cinco meses
- • APTA Regional apresenta pesquisa de Genômica de Populações em Árvores Brasileiras na Havard University
- • IAC apresenta inovações de impacto para o agro durante a 28ª Hortitec
- • Instituto de Pesca apoia Gastronomia Sustentável
- • Instituto Biológico inaugura nova sede do Laboratório Regional de Pesquisa em Araçatuba
- • IAC comemora 136 anos com resultados inéditos na pesquisa
- • Preços Agropecuários caem 1,31% em maio de 2023, aponta IEA
- • Agrônomos da Secretaria de Agricultura de SP são premiados na cerimônia da Deusa Ceres
- • Nota de Esclarecimento: PL N° 614/2018
- • Secretaria de Agricultura e Abastecimento do Estado de São Paulo e Vale assinam convênio inédito para estudo e propagação de plantas raras de Minas Gerais
- • Publicação do Ital aponta que bebidas à base de plantas comercializadas no país são seguras, nutritivas e, em sua maioria, contêm baixos níveis de sódio e gorduras saturadas
- • Pesquisadora do IZ dá dica importante de dieta de baixo custo para alimentar ovinos no período da seca
- • Planeta Inseto é uma boa opção de lazer para as férias escolares
- • Pesquisas e inovações da APTA Regional em horticultura sustentável estarão na Hortitec 2023
- • Secretaria da Agricultura participa de discussões sobre Bionergia na Fapesp
- • Estudantes e professores colocam a “mão na massa” em atividades do Instituto de Pesca
- • Atendendo a demanda do setor, Ital realiza curso inédito sobre shelf life de carnes
- • Vice-diretora do Ital é escolhida pesquisadora do ano em evento internacional de Inovação em alimentos
- • Ital sedia evento de importância mundial voltado à inovação em alimentos
- • Agroecologia favorece a produção de alimentos sustentáveis
- • Amendoim se destaca na segunda prévia da safra 22/23 e consolida Estado como maior produtor
- • Instituto de Pesca premiou startups que inovaram na cadeia do pescado
- • IZ destaca no Dia Mundial do Leite as análises para certificação do leite A2
- • Instituto Biológico realiza nova edição do Curso de Controle Microbiano de Insetos
- ► Maio (28)
- • IEA promove seminário para debater insegurança alimentar, agricultura familiar e agroecologia
- • Secretário de Agricultura participa da abertura da Expocitros em Cordeirópolis
- • Exportações de agronegócios em São Paulo crescem 4,3% em 2023 e registram superávit de US$ 6 bi
- • Rotas Rurais gera negócio e potencializa o turismo rural
- • 16ª edição do Sabor da Colheita atrai público recorde
- • Pesquisa da Secretaria de Agricultura demonstra a importância do Leite A2
- • Ital abre processo seletivo para mestrado em Ciência e Tecnologia de Alimentos
- • Planos de exploração do cultivo e manejo das algas marinhas são apresentados à Secretaria
- • Pescado cultivado ganha força no interior do estado de SP com a Aquishow Brasil
- • Maior cafezal urbano do mundo leva história e educação ambiental à população
- • Reúso e reciclagem de embalagem é foco de bolsa de pós-doutorado oferecida pelo Ital
- • APTA Regional de Pindamonhangaba apresentará, na Aquishow Brasil 2023, pesquisas com rã-touro como bioindicador de poluição ambiental
- • No Dia Nacional do Café, Secretaria de Agricultura enfatiza ações e tecnologias voltadas à bebida mais apreciada pelos brasileiros
- • APTA Regional realiza I Encontro Regional de Restauração Florestal do Noroeste Paulista
- • Pesquisadores do Instituto Biológico debatem soluções para doença que preocupa produtores de atemoia
- • Levar conectividade ao campo é tema de reunião na Secretaria de Agricultura
- • Mercado de Carbono é o tema do Ciclo de seminários do IEA desta semana
- • Estratégias e governança para a economia circular é foco de bolsa de pós-doutorado de centro de pesquisa liderado pelo Ital
- • No dia do Zootecnista, pesquisadores e extensionista da Secretaria de Agricultura destacam a relevância da profissão para o Agro
- • Especial Dia das Mães: do campo ao laboratório
- • Saudabilidade, rotulagem nutricional e resíduos de alimentos são temas de fórum coordenado pelo Ital na Apas Show
- • Zootecnia de Precisão é tema de curso oferecido pelo IZ em Ribeirão Preto
- • Com Laboratório Móvel de Análise da Qualidade do Leite, IZ marca presença no Torneio Leiteiro da 88ª ExpoZebu
- • “Virada de chave”, diz produtor de cana sobre parceria com Instituto Agronômico
- • Demonstração de excelência do Instituto Biológico (IB) em controle biológico é destaque na Agrishow
- • Com participação da APTA, evento do Conexão.f abordou relação entre pesquisa e gastronomia, na Agrishow
- • Produtos da cadeia de cogumelos são destaque na Agrishow
- • APTA se destaca em eventos sobre ambientes e ecossistemas de Inovação na Agrishow 2023
- ► Abril (16)
- • Trajetória da APTA na inovação no agro será abordada em evento na Agrishow 2023
- • IZ comemora Dia do Boi com pesquisas que geram carne de melhor qualidade, com menor custo e que produzem menos impacto ambiental
- • Centro de pesquisa liderado pelo Ital oferece bolsa de pós-doutorado em gestão e inovação para a economia circular
- • Agrishow 2023 - APTA coordena instituições de pesquisa do agro paulista
- • Ministério da Agricultura aprova o uso de fitossanitário desenvolvido pelo IB
- • Bem-estar de bezerras leiteiras será tema de webinar oferecido pelo IZ
- • Ital amplia PD&I com foco em redução de danos em embalagem para transporte e distribuição
- • Coordenador da APTA recebe representantes comerciais do Líbano
- • Treinamentos oferecidos pelo IZ aprimoram conhecimentos na área de Bubalinocultura
- • Programa Rotas Rurais é referência para Estado de São Paulo
- • Secretaria de Agricultura celebra os 54 anos do Instituto de Pesca
- • Governo de São Paulo e Secretaria de Agricultura prestigiam lançamento do Centro de Ciência para o Desenvolvimento de Agricultura Digital
- • 100 dias de gestão: Governo de SP coloca o produtor rural no mapa do Estado
- • Cheirinho de café no ar? É o Sabor da Colheita chegando
- • Em evento no México, pesquisador do IZ apresenta pesquisas voltadas à uma ovinocultura mais sustentável
- • Público aprimorou conhecimentos técnicos no curso do IZ de processamento e comercialização da carne de ovinos
- ► Março (29)
- • Apta Regional inaugura laboratório de Pós-colheita e agregação de valor à pesquisa e ao produtor
- • IZ realizará curso de inseminação artificial de bubalinos
- • Seminário de Bubalinocultura do IZ abordará maior produtividade para atividade
- • IZ participa de evento voltado à produção de Leite A2
- • Festa do Cacau, no Instituto Biológico, recebe mais de 3 mil visitantes
- • Estudo revela que 98,1% dos chocolates industrializados não têm conservantes e 95,2% não possuem corantes
- • IZ recebe reunião da Comissão de Sementes e Mudas de São Paulo
- • Pesquisas da Apta Regional contribuem para melhor gestão dos recursos hídricos
- • I Festa do Cacau no Instituto Biológico de São Paulo
- • Instituições de Pesquisa e Extensão da Secretaria de Agricultura difundem tecnologias para valorização florestal
- • Curso no IZ aborda aspectos tecnológicos, processamento e comercialização da carne de ovinos
- • Agricultura paulista apresenta resultados expressivos com relação ao ano de 2022
- • Pesquisa do IZ sobre qualidade de ovos é premiada em Congresso da área
- • Pesquisa do Ital contribui para redução da pegada de carbono na cadeia produtiva do cacau
- • Pesquisas contribuem para reduzir efeitos das mudanças climáticas com sustentabilidade e fontes de suprimentos para as plantas
- • Análise do clima e seus efeitos - mitigação dos problemas das alterações climáticas nas práticas do setor agropecuário
- • Pesquisa promove a sustentabilidade dos agronegócios com a agricultura de precisão e regenerativa em Sistemas Integrados
- • Pesquisas do IZ contribuem para a redução da emissão de metano com a pecuária sustentável
- • Todo ser vivo precisa de cuidados. Como está a saúde das árvores da sua cidade?
- • Associação Brasileira de Citros de Mesa inaugura nova sede no Centro de Citricultura Sylvio Moreira
- • Secretaria de Agricultura participa de encontro da Embrapa sobre Hub de inovação em conceito Farm Lab
- • Dia do Campo em Manduri promove Leguminosas de Verão e ILPF
- • Exportação de animais vivos: o Brasil tem muito espaço para ampliar suas vendas e o Instituto Biológico pode ajudar
- • Secretaria estuda parcerias para estimular o cultivo da cevada cervejeira
- • IB organiza evento público para comemorar o Dia do Cacau
- • Secretaria de Agricultura reforça protagonismo feminino no Agro
- • IZ realiza webinar sobre controle seletivo do carrapato do boi
- • IZ moderniza Centro de Pesquisa dedicado à pecuária de corte
- • IB esclarece dúvidas sobre o mal da vaca louca
- ► Fevereiro (22)
- • Termina o período de defeso de piracema
- • Secretaria recebe demandas do setor de aquicultura e piscicultura
- • Embrapa apresenta projeto inédito de corredor de inovação tecnológica à Secretaria de Agricultura
- • Melhorias em infraestrutura garantem o incremento das pesquisas do IZ
- • Instituto de Zootencia realiza Dia de campo voltado ao uso de biofertizantes na produção agrícola
- • Instituto Biológico recebe visita do Secretário de Agricultura e Abastecimento
- • Otimização de recursos e ganhos em sistemas de produção animal
- • Felipe Camargo é o novo diretor-geral do Instituto de Economia Agrícola
- • Dia de Campo aproxima pesquisa do produtor de leite do Vale do Paraíba
- • Comunicado Rotas Rurais
- • Ital, Biopark e Fundação Araucária se unem para fortalecer pesquisa alimentar
- • Instituto de Pesca colabora com pesquisas para identificação e monitoramento de marlim-azul
- • Pesquisas do IAC e da APTA Regional auxiliam na redução de prejuízos causados por pragas no amendoim
- • Dia de campo apresentará resultados preliminares de pesquisas científicas para produtores de leite do Vale do Paraíba
- • Instituto de Pesca oferece capacitação a estudantes
- • Embrapa apresenta sistema de tecnologia agropecuária para o Estado de SP
- • Mapa amplia prazo de validade de Imunobiológicos produzidos pelo IB
- • Syngenta oferece apoio ao Programa Solo + Fértil
- • Museu do Instituto de Pesca vai navegar no metaverso
- • Ital oferece 47 eventos abrangendo processamento, segurança e qualidade de alimentos e embalagem
- • Instituto de Economia Agrícola e Fundação Instituto de Pesquisas Econômicas têm encontro promovido pela Secretaria de Agricultura
- • Revista Científica do Instituto de Pesca sobe de nível no Qualis
- ► Janeiro (7)
- • APTA apresenta projeto do novo Ecossistema de Inovação
- • Instituto de Pesca cotribui para o fortalecimento da tilapicultura paulista
- • Preço recebido pela Agropecuária Paulista fecha 2022 positivo em 6,63%
- • Dia de visita coloca trabalhos desenvolvidos pela pesquisa, extensão rural e defesa agropecuária sob holofotes
- • Antonio Junqueira reforça compromisso de diálogo com todos os setores da cadeia produtiva
- • Abertas as inscrições para bolsa de treinamento técnico no Ital
- • Antonio Julio Junqueira de Queiroz toma posse como secretário de Agricultura e Abastecimento do Estado São Paulo
- ► Dezembro (21)
- ► 2022 (164)
- ► Dezembro (4)
- • Secretário de Agricultura e Abastecimento do Estado de São Paulo realiza entregas de maquinários agrícolas no Centro de Cana do IAC, em Ribeirão Preto
- • Secretário de Agricultura participa de assinatura de protocolo de intenções que traz novas possibilidades à pesquisa do agro paulista
- • Instituto de Pesca oferece treinamento à Marinha do Brasil
- • Secretário de Agricultura e Abastecimento participa de cerimônia de inauguração dos novos laboratórios do Instituto de Pesca
- ► Novembro (20)
- • APTA Regional lança Rede Agroecológica Regional, voltada a fomentar agricultura de base ecológica
- • Governador Rodrigo Garcia e secretário de Agricultura autorizam abertura de concurso para pesquisador científico nos Institutos de Pesquisa do agro paulista
- • Inovação e tecnologia: APTA de Portas Abertas mostra à sociedade como a ciência atua no agronegócio
- • Em 21 de novembro é comemorado o Dia Mundial da Pesca!
- • Secretário de Agricultura e Abastecimento visita institutos no último dia do projeto "APTA Portas Abertas"
- • Instituto de Economia Agrícola promove roda de conversa sobre sociobiodiversidade
- • Secretário de Agricultura e Abastecimento do Estado de São Paulo realiza abertura do APTA Portas Abertas no Instituto Biológico
- • APTA de Portas Abertas aproxima a ciência da sociedade paulista
- • 131 anos da Secretaria de Agricultura e Abastecimento do Estado de São Paulo
- • Balança Comercial paulista: Agro tem superávit de US$15,32 bilhões de janeiro a setembro de 2022
- • Secretário de Agricultura participa da comemoração dos 95 anos do Instituto Biológico
- • Secretário de Agricultura e Abastecimento do Estado participa das festividades de 80 anos do Instituto de Economia Agrícola
- • Secretaria de Agricultura e Abastecimento do Estado de São Paulo realiza Agrifutura Talks
- • Instituto Agronômico de Campinas: um instituto “Sangue Azul”, mas de feitos e resultados democráticos
- • Secretário de Agricultura de SP integra painel sobre sustentabilidade no agro durante Inova Trade Show
- • Referência em dados econômicos e estatísticos no agro, Instituto de Economia Agrícola comemora 80 anos de existência
- • Instituto Biológico completa 95 anos
- • Institutos de Pesquisa da APTA participam do Inova Trade Show 2022
- • A partir de 2023 APTA contará com ecossistema próprio de inovação voltado a criar soluções e impulsionar agro paulista
- • Inicia hoje, 1º de novembro, o defeso da piracema
- ► Outubro (1)
- ► Agosto (3)
- • Secretário de Agricultura e Abastecimento do Estado de São Paulo participa da inauguração de novos laboratórios do Instituto Biológico de São Paulo
- • Secretário Francisco Matturro participa da abertura da 3ª edição do BeefDay e da reunião da Câmara Setorial da Pecuária
- • Secretaria de Agricultura de SP capacita profissionais para garantir a sanidade dos produtos vegetais paulistas
- ► Julho (9)
- • Secretaria de Agricultura e Abastecimento do Estado de São Paulo realiza reunião com presidente e representante da Câmara Setorial da Borracha Natural
- • Secretário de Agricultura preside reunião da Câmara Intersecretarial de Segurança Alimentar e Nutricional de SP, no Ital
- • Ao comemorar 117 anos, IZ inaugura novas unidades de apoio à pesquisa em Nova Odessa
- • Secretário de Agricultura Francisco Matturro participa do Fórum Pecuária Brasil 2022
- • APTA Regional de Colina realiza terceira edição do BeefDay – Ciência à favor do campo
- • Instituto de Pesca e sindicatos realizam workshop para pescadores(as)
- • Representante do Instituto de Inovação Israelense realiza série de visitas pelas Unidades da APTA de olho em parcerias de pesquisa para o agro
- • Período Eleitoral
- • Período Eleitoral
- ► Junho (27)
- • Período Eleitoral
- • Instituto de Pesca lança Projeto Valoriza Pesca
- • IAC celebra 135 anos de pesquisa para o agro nacional
- • Período Eleitoral
- • IAC participa de ação do SENAR e CropLife para treinamento de instrutores no modo correto de aplicação de defensivos
- • IAC completa 135 anos com lançamento de cultivar inédita no mundo
- • Ostras: pesquisas do IP ajudam a conhecer um pouco mais sobre esse molusco tão apreciado na gastronomia
- • Benefícios aos animais, produtores e consumidores: terapias alternativas na produção e qualidade do leite são estudadas no IZ
- • Dietas alternativas de alta energia para cordeiros e borregos em terminação é tema de curso do IZ
- • ITAL lança hub de conteúdo: Indústria de Alimentos 2030
- • Começa o inverno, melhor época para se produzir truta
- • IZ está com inscrições abertas para o Programa de Bolsas de Iniciação Científica
- • Festa Junina com doação de alimentos é muito melhor
- • IZ realiza webinar sobre terapias alternativas para melhoria da produção e qualidade do leite
- • Hub de conteúdo do Ital reúne ações da indústria para saudabilidade de alimentos e sustentabilidade do sistema alimentar
- • Secretaria de Agricultura e Abastecimento de SP apresenta ações durante a 27ª Hortitec
- • Curso de Controle Microbiano de Insetos reúne 51 participantes
- • Seminário no IAC sobre cadeia produtiva de queijo marca encerramento de visita de delegação francesa ligada ao setor a São Paulo
- • Laboratórios do IZ e ITAL recebem a delegação francesa para cooperação técnica na área do leite
- • Institutos de Pesquisa da APTA irão compor Centros de Ciência para o Desenvolvimento em parceria com a iniciativa privada
- • Sanidade do rebanho foi o tema do treinamento realizado pelo Prosaf em Guaratinguetá
- • Instituto de Pesca participa do Projeto Ciência na Prática
- • IAC dá início aos principais eventos da citricultura da América Latina
- • IZ realiza venda de ovinos da raça Santa Inês
- • APTA realiza Dia de Campo voltado à mandioca de indústria no Oeste Paulista
- • Agro Paulista cresce em exportações e superávit aumenta 33,7% nos primeiros quatro meses de 2022
- • IZ destaca o Dia Mundial do Leite com tecnologias para produção leiteira paulista e nacional
- ► Maio (20)
- • Rotulagem nutricional de 210 bolos industrializados são avaliadas em estudo do Ital
- • Levantamento inicial mostra sinais positivos para as safras agrícolas referente à produção de 2021/22
- • Startup instalada no ITAL contribui com PD&I de alimentos e bebidas mais nutritivos, funcionais e tecnológicos
- • Iniciativa para aproximar startups e investidores será lançada durante Semana de Citricultura
- • Evento em Campinas celebra os 50 anos de Unidade Laboratorial que alçou a outro patamar o controle biológico no Brasil
- • Na Aquishow, SAA apresenta novas tecnologias, linha de crédito e orientações ao setor de pesca e aquicultura
- • Sabor da Colheita: população poderá colher cafés do maior cafezal urbano do mundo
- • Laboratório de reprodução animal do IZ recebe visita de especialistas em criopreservação de sêmen bovino
- • Laboratório de Controle Biológico completa 50 anos
- • A espera acabou! O Sabor da Colheita será no dia 21 de maio
- • IAC e APTA Regional realizam evento para debater a cadeia produtiva da olivicultura
- • Levantamento das propriedades rurais realizado pelo IEA traça cenário abrangente do agro paulista
- • Cultivo consorciado de café com macadâmia é 215% mais produtivo e 3,2 vezes mais rentável do que sistema tradicional
- • Na FEIBANANA 2022, APTA Regional apresenta pesquisas que podem dobrar produtividade da fruta no Vale do Ribeira
- • IZ atua no desenvolvimento de pesquisas em diferentes sistemas de produção avícola
- • Comitiva da Coréia do Sul visita o Instituto Biológico
- • Agro paulista tem saldo positivo de US$ 3,90 bilhões no primeiro trimestre de 2022
- • IAC realiza o II Workshop Urban Farming
- • IZ participa de evento para discutir a neutralidade climática na pecuária
- • Os aspectos agronômicos e regulatórios de óleos essenciais em medicamentos serão abordados pelo IAC em webinar
- ► Abril (24)
- • Novo sistema de vibração do Ital otimiza avaliação de desempenho de embalagem e produtos
- • IZ levará para Agrishow laboratório móvel para análise de qualidade do leite
- • Tecnologias para aquicultura estarão presentes na Agrishow 2022
- • Agrishow 2022: Pesquisas do IZ selecionam reprodutores e matrizes de bovinos e ovinos com mesmo desempenho animal com menor consumo de alimentos
- • Agrishow 2022: IZ apresenta primeiro sistema de produção animal que integra piscicultura de recirculação e aquaponia à pecuária
- • Novidades sustentáveis na Agrishow 2022
- • IAC e APTA Regional expõem pela primeira vez plantas aromáticas na Agrishow
- • IAC apresenta sua primeira cultivar de feijão Mungo Verde na Agrishow; confira outros lançamentos
- • Secretaria de Agricultura e Abastecimento de SP terá na Agrishow complexo de inovação e sustentabilidade da pesquisa à gastronomia
- • 3ª Expolimão / 22º Dia do Limão Tahiti tem público de 550 pessoas em Pindorama
- • Valoriza Pesca: projeto do IP visa conhecer e fomentar o desenvolvimento da comunidade pesqueira da Baixada Santista
- • IAC e prefeitura de Louveira firmaram parcerias
- • Em evento no IAC, governador de SP e secretário de Agricultura entregam laboratório de pesquisa e anunciam ações à população de Campinas e região
- • APTA completa 21 anos de coordenação da pesquisa agropecuária em São Paulo
- • Consumo e benefícios do pescado vão além da Semana Santa e Páscoa
- • Planeta Inseto: nova proposta expográfica amplia conteúdo educativo para Fundamental II e valoriza a acessibilidade na comemoração de seus 12 anos
- • Ital oferece bolsa de pós-doutorado focada em elementos inorgânicos em alimentos
- • Dia Nacional da Conservação do Solo é comemorado com evento reunindo pesquisadores e técnicos da Secretaria de Agricultura e Abastecimento
- • IAC anuncia investimento no Centro de Frutas e apresenta projetos inovadores para uva e caqui nesta terça, 12
- • Ital oferece três dias de workshop gratuito focado em tendências em alimentos e perspectivas para 2030
- • Investimentos da Secretaria de Agricultura de SP na APTA Regional impulsionam pesquisas em produção sustentável
- • APTA Regional e Unesp formam parceria em Pesquisa e Tecnologia
- • Investimentos da SAA revitalizam e modernizam áreas de pesquisas do IZ
- • Ital e Unicamp obtêm patente de processo que prolonga a qualidade visual do chocolate
- ► Março (32)
- • Museu de Pesca em Santos será revitalizado
- • A cada real investido nas unidades de pesquisa da APTA, R$ 16,23 são revertidos para a sociedade
- • Cidade de São Paulo receberá complexo científico e cultural a céu aberto sobre o agronegócio
- • Rede Morangos do Brasil será lançada nesta terça, 29
- • Investimentos na infraestrutura do IAC refletem em agilidade e eficiência das pesquisas
- • Secretário da Agricultura realiza visita técnica ao Núcleo de Pesquisa e Desenvolvimento Regional de São Roque
- • Cacau: setor em alta encontra no Ital oportunidades de inovação aliada à saudabilidade e à sustentabilidade
- • Pesquisador da APTA Regional de Colina é condecorado por contribuições à pecuária bovina paulista e brasileira
- • Ital desenvolve metodologias para obter ingredientes saudáveis a partir de óleos com ômegas
- • Secretário da Agricultura abre 1° Fórum da Cachaça SP em Piracicaba
- • IAC realiza 7° Curso Prático de Extração de Óleos Essenciais
- • Secretaria de Agricultura e Abastecimento coordena curso que habilita profissionais para emissão de CFO/CFOC
- • Laboratório do Ital exclusivo para teste de desafio é o primeiro do setor público no Brasil
- • Em São José dos Campos, Governo de SP lança Agropolo Vale em evento marcado por entregas e inaugurações da Secretaria de Agricultura e Abastecimento
- • Dia Mundial da Água: Secretaria de Agricultura de SP desenvolve diversos projetos de pesquisa e extensão rural sobre o uso da água no agro
- • Governo do Estado investe R$ 7,5 milhões no Instituto Biológico em 2021
- • IP é uma das instituições beneficiadas com os recursos destinados pelo governo estadual
- • Dados do IAC mostram que cresce o número de laboratórios de solos que oferecem mais opções ao setor
- • II Seminário da Agricultura Familiar na Alta Paulista: Diversificação e Novas Alternativas de Cultivos será realizado neste 17 de março
- • Parceria entre IZ e criador de Angus auxilia na identificação de genes relacionados à resistência à babesiose bovina
- • Prédio do Instituto Biológico, símbolo da art decó na cidade de São Paulo, será restaurado
- • Autorizo para criação de ambientes de inovação no agro e inauguração de laboratórios são destaque na abertura do AgriFutura
- • AgriFutura premia inovações tecnológicas para o agronegócio
- • São Paulo foi responsável por 55% das admissões com carteira assinada no agro brasileiro em 2021
- • Secretaria de Agricultura de SP convoca candidatos de último concurso para preenchimento de 213 vagas de trabalho
- • Com R$ 6,8 mi do Governo de SP, Ital amplia capacidade de P&D em ingredientes, alimentos e embalagem
- • Revista Pesquisa & Tecnologia, da APTA Regional, homenageia autores de trabalhos mais acessados
- • Secretário de Agricultura de SP visita o Núcleo Regional de Pesquisa de Pirassununga
- • IZ realiza estudos com terapia de células-tronco em búfalas
- • Farinha de folha de mandioca biofortificada com 50 vezes mais ferro vegetal que a tradicional: este é o resultado de pesquisa do IAC e Unicamp
- • IZ realiza venda de 142 bovinos das raças Nelore e Caracu
- • Com recursos recordes, Institutos de Pesquisa da Secretaria de Agricultura realizam 118 obras de modernização em 2021
- ► Fevereiro (16)
- • Agronegócio paulista cresce 20,3% em janeiro de 2022
- • Período defeso nos rios de São Paulo termina no dia 28
- • Cresce interesse por determinação de prazo de validade de alimentos e Ital inaugura sala climatizada dedicada à área
- • Programa Aplique Bem do IAC recebe do MAPA Prêmio em Boas Práticas
- • Noroeste paulista se destaca na aquicultura nacional
- • Ampliação de laboratório do Ital dedicado à microencapsulação será foco de webinar gratuito
- • Ital e IAC propõem embalagem à base de papel para morangos
- • São José do Rio Preto (SP) sedia feira de negócios e conhecimento de aquicultura nacional
- • Instituto de Zootecnia comprova aumento da produtividade de vacas leiteiras que recebem carinho
- • Pesquisadores do IAC e da APTA Regional realizam o 13º Encontro de Produtores e Dia de Campo de Amendoim
- • Pesquisador do Instituto de Pesca é um dos mais relevantes do mundo, de acordo com ranking da Stanford University
- • Ital recebe inscrições para bolsa de pós-doutorado na área de metalografia aplicada a embalagem
- • Ital atinge recorde de satisfação de clientes do setor produtivo em 2021
- • Pesquisa estuda o efeito do estresse térmico em bovinos de corte, fator limitante para produção de carne de alta qualidade
- • Ital oferece bolsa de pós-doutorado em Ciência e Tecnologia de Alimentos
- • Pesquisadores do IB e professor colaborador da Esalq participam de livro internacional de vírus em plantas ornamentais
- ► Janeiro (8)
- • Preços agropecuários fecham 2021 com alta de 40,63%, com grande influência dos produtos vegetais
- • Nova tecnologia extrai RNA de sangue bovino com extrema qualidade e menor custo
- • IB amplia em 31% produção de imunobiológicos e atualiza portfólio para atender demanda do setor produtivo
- • IAC lança o livro Compostagem para fins Agrícolas
- • Exportações do agro paulista aumentam 9,5% em 2021
- • IAC lança boletim sobre os fundamentos da aplicação de herbicidas em cana-de-açúcar
- • Pesquisador da APTA Regional recebe Prêmio Ambientalista Regional por suas contribuições à gestão e proteção dos recursos hídricos
- • Cálculos Preliminares indicam Valor da Produção Agropecuária em São Paulo 26,6% maior em 2021
- ► Dezembro (4)
- ► 2021 (360)
- ► Dezembro (24)
- • Secretaria de Agricultura de SP encerra o ano com diversos programas efetivados e orçamento recorde em 2021
- • Extensionistas da CATI Regional Guaratinguetá participam de Dia de Campo sobre qualidade do leite
- • Ital prevê realizar 59 eventos em 2022 com retomada de capacitações presenciais
- • Período chuvoso deve aumentar a proliferação de pragas importantes para a canavicultura
- • IAC participa de projeto de educação ambiental em Americana
- • Laboratório do Ital amplia capacidade de pesquisa e desenvolvimento de bactérias láticas e probióticas
- • Projeto orientado por pesquisador da APTA Regional de Colina é selecionado entre os dez melhores no Desafio da Pecuária Responsável
- • A partir de problemas sanitários observados em campo, IB e APTA Regional realizarão treinamentos com produtores de leite do Vale do Paraíba
- • AgriFutura 2022 é lançado pela Secretaria de Agricultura de SP
- • Parceria entre Instituto de Pesca e Instituto de Zootecnia busca produção de iscas vivas em sistema de aquaponia, que alia aquicultura e cultivo de hortaliças
- • Repositório institucional do IB chega a marca de mil documentos científicos armazenados
- • Vinho Agroecológico é apresentado em São Roque
- • Ital contribui no desenvolvimento da metodologia para avaliação sensorial de café solúvel
- • Em grande evento do setor, Secretário de Agricultura assina Protocolo voltado a pesquisas em ovinocultura no Estado
- • APTA realiza eventos com startups para discutir sucessão familiar
- • Balança comercial: agro paulista tem superávit de US$ 12,15 bilhões nos dez primeiros meses de 2021
- • IAC inaugura área de pesquisa de extração de óleos essenciais, faz curso e lança livro sobre o tema
- • Instituto de Pesca apresenta ração sustentável para peixes carnívoros
- • Capim Aruana do IZ se mostra excelente opção de forrageira para sistemas integrados de produção agropecuária
- • Com 49 anos de Secretaria de Agricultura de SP, Luis Madi trouxe avanços para o setor de alimentos e embalagem
- • Cascas de manga são transformadas em ingrediente funcional com tecnologia desenvolvida pelo Ital
- • IAC lança seis cultivares de feijão e quatro de mandioca
- • Grande evento em Campinas festeja os 130 anos da Secretaria de Agricultura e Abastecimento do Estado de São Paulo
- • Secretário de Agricultura e Abastecimento de SP visita unidade do IB em Campinas
- ► Novembro (26)
- • Planeta Inseto reabre suas portas a partir de 30 de novembro
- • IEA completa 79 anos e celebra a data com premiação de trabalhos científicos
- • IB responde dúvidas sobre fungos na agricultura em evento online
- • IZ entrega ao setor produtivo resultados de prova de eficiência alimentar de ovinos
- • IEA premia melhores autores de trabalhos científicos
- • Ital inova em tecnologia de ingrediente bioativo e amplia pesquisas em processamento térmico
- • Novas variedades de cana IAC são liberadas ao setor nesta terça, 23
- • Instituto de Pesca trabalha alinhado às iniciativas do Ano Internacional da Pesca e Aquicultura Artesanais
- • IAC lança cultivar de uva fina para vinho branco
- • Secretário de Agricultura visita o Instituto Biológico e participa da celebração de seus 94 anos
- • IZ e APTA Regional oferecem capacitação online em sistemas integrados de produção agropecuária e recuperação de áreas com pastagens degradadas
- • Instituto Biológico comemora 94 anos em evento aberto a população
- • Secretaria de Agricultura de SP completa 130 anos em novembro e resgata a história de suas instituições de pesquisa
- • Pesca artesanal e industrial em SP gerou receita de R$ 60 milhões no segundo semestre de 2020
- • Plataforma Biotecnológica de Ingredientes Saudáveis oferece bolsas de pós-doutorado no interior de SP
- • XVI Seminário Nacional de Milho Safrinha marca três décadas desse cultivo com tecnologia
- • Ital recebe propostas para implantar ambiente de inovação e planta-piloto multiusuário focados em tecnologia de alimentos
- • IZ realiza teste de desempenho e eficiência alimentar de 77 touros da raça Canchim de 12 criatórios brasileiros
- • IZ finaliza Prova de Ganho de Peso e disponibiliza ao setor bovinos de corte provados
- • Inscrições para mestrado em Ciência e Tecnologia de Alimentos do Ital se encerram em 15 de novembro
- • Qualidade do leite é tema de próximo treinamento do Prosaf no Vale do Paraíba
- • IAC participa de evento sobre novas normas para produção de mudas de café no Estado
- • Instituto de Economia Agrícola completa 79 anos levando informação socioeconômica de qualidade para o agro e o país
- • Pesquisa do Instituto de Pesca com produção de lambaris para isca-viva é publicada em revista de referência na área de aquicultura
- • Pesquisadores do IAC participaram da live “Para qual direção caminha a produção da cana-de-açúcar no Brasil?”
- • IZ disponibiliza dez orientações para pequenos e médios produtores melhorarem qualidade do leite
- ► Outubro (29)
- • Secretaria de Agricultura e Abastecimento de SP realiza primeiro concurso de café canéfora de São Paulo
- • Evento do Instituto de Economia Agrícola discute comercialização no entreposto da Ceagesp em São Paulo
- • Pesca de espécies de peixes nativas está proibida a partir de 1º de novembro em SP
- • Incêndios queimam produtividade nos canaviais e recursos do produtor
- • Agro paulista cresce 13,1% nos primeiros nove meses do ano
- • Secretaria de Agricultura e Universidade Estatal Amazônica do Equador assinam protocolo de intenções para o desenvolvimento do agronegócio
- • Nematoides são microscópicos, mas causam prejuízo de R$ 35 bi por ano ao agro brasileiro
- • Tecnologias da Secretaria de Agricultura de SP para a cultura da seringueira serão discutidas em live em 27 de outubro
- • Estudo do Ital mostra que massas industrializadas são produzidas com as mesmas matérias-primas usadas em fabricação caseira ou artesanal
- • IB amplia diagnósticos acreditados com padrão internacional
- • Você conhece o Museu de Pesca da Secretaria de Agricultura e Abastecimento de São Paulo?
- • Dia Nacional da Alimentação na Escola: Secretaria de Agricultura de SP promove ações para auxiliar práticas saudáveis em escolas públicas
- • IB e Guarda Municipal de Campinas estreitam relacionamento para maior segurança de Centro de pesquisa do Instituto
- • Diretora do Ital está na lista da Forbes das 100 mulheres mais poderosas do campo
- • Seminário do IEA visa contribuir para a construção da sustentabilidade na reserva da biosfera do cinturão verde paulista
- • Versáteis e de importância ecológica, palmeiras nativas são objeto de estudo na APTA Regional de Piracicaba
- • Tecnologias para lidar com mudanças climáticas e aproveitar melhor a água no agro durante evento online Terças do Agro
- • Siriris nas lâmpadas? Pesquisador do Instituto Biológico explica o que fazer
- • IAC lança as primeiras variedades de batata coloridas do Brasil
- • Agro paulista tem saldo positivo nos oito primeiros meses do ano, com elevação de 12,2% nas exportações
- • Dia Nacional da Pecuária: pesquisas da Secretaria de Agricultura garantem mais produtividade, melhor qualidade da carne e menos impacto no ambiente
- • Ital aprimora atuação em ciência e qualidade dos alimentos com quatro novos laboratórios
- • Instituto de Pesca organiza evento que discutirá estratégias para inclusão do pescado na alimentação escolar
- • IAC apresenta três novas variedades de cana
- • IZ realiza evento online focado no manejo de pastagens em sistemas integrados de produção agropecuária
- • Webinar Ciência e Qualidade dos Alimentos apresenta novos laboratórios e linhas de pesquisa do Ital
- • Programa de Pós-Graduação do Ital abre inscrições para mestrado em Ciência e Tecnologia de Alimentos
- • Pesquisa mostra alterações no consumo do café causadas pela pandemia
- • Semana de Ciência e Tecnologia: Veja a programação dos Institutos de Pesquisa da Secretaria de Agricultura de SP
- ► Setembro (33)
- • Anvisa credencia Ital para realizar análises fiscais e de monitoramento de alimentos e embalagens
- • APTA Regional de Adamantina debate pesca no Rio Paraná
- • Bactérias em plantas e animais de interesse econômico são tema de próximo webinar do IB
- • Com o vice-governador, Secretário de Agricultura de SP assina Rotas Rurais e autoriza o compartilhamento da Casa de Agricultura de Boituva
- • Em Presidente Prudente, Secretário de Agricultura assina Rotas Rurais com 21 municípios da região e participa da abertura do “Retoma SP”
- • Secretário de Agricultura de São Paulo assina convênio do Rotas Rurais em Tatuí
- • Em Tietê, vice-governador e Secretário de Agricultura assinam convênio do Programa Rotas Rurais e realizam entregas do PAA Cesta Verde
- • Secretário de Agricultura e secretário-executivo visitam Unidade de Pesquisa e Desenvolvimento de Brotas
- • Secretário de Agricultura visita fazenda de coleta e armazenamento de sêmen de touros, que mantém parceria com o Instituto de Zootecnia
- • Cultivo de tomate orgânico será tema de treinamento do Instituto Biológico
- • Museu de Pesca se prepara para reabertura
- • Monitoramento realizado pelo Instituto de Pesca fornece subsídios para mudanças na legislação pesqueira em SP
- • Após acelerar nove startups, TechStart Food Innovation recebe inscrições até domingo para segundo ciclo
- • Em Bauru, Secretário de Agricultura visita o Polo Regional da APTA, o EDR e o EDA
- • Convênio do Programa Rotas Rurais é assinado na cidade de Bauru
- • Barra Bonita recebe vice-governador e secretário de Agricultura para assinatura do Rotas Rurais e entregas do PAA Cesta-Verde
- • Vice-governador e Secretário de Agricultura assinam convênio do Rotas Rurais em Jaú
- • Bocaina firma convênio com o Programa Rotas Rurais
- • PODCAST DA SÉRIE “A CRISE HÍDRICA”, EPISÓDIO 2!
- • Secretário de Agricultura visita o Polo Regional Extremo Oeste da APTA, em Andradina
- • Síndrome de Haff ou Doença da urina preta
- • Webinar gratuito do Ital aborda novos ingredientes, proteínas vegetais e aproveitamento integral e plantio da macaúba
- • Bolsistas dos Institutos de Pesquisa da APTA recebem o Prêmio “Futuro Cientista” do CIIC 2021
- • IAC abre inscrição para mestrado na Pós-Graduação em Agricultura Tropical e Subtropical
- • Instituto de Pesca participa de revitalização do Córrego do Sapateiro na Vila Mariana
- • Tecnologias IB de bioinsumos trazem benefício econômico de R$ 398,5 milhões anuais para agro brasileiro
- • Leilão Virtual de Reprodutores e Matrizes linhagem IZ
- • Trutas podem gerar descendentes mais adaptados às mudanças climáticas, sugere estudo do Instituto de Pesca
- • Balança comercial: Agro paulista cresce 11,9% nos sete primeiros meses de 2021
- • Dia do Biólogo: Avanços científicos e tecnológicos contam com biólogos na pesquisa agropecuária
- • Evento online do IEA discute tributação do agro na atualidade
- • Da conserva tradicional a sopa e patê: versatilidade do palmito é explorada pelo Ital
- • Pesquisadores da APTA Regional orientam para prevenção de incêndios em seringais
- ► Agosto (38)
- • Os ganhos e as formas de manejo de micronutrientes em cana são tema de Workshop do IAC
- • Bolsistas dos Institutos de Pesquisas da APTA apresentarão resultados de projetos no 15° Congresso Interinstitucional de Iniciação Científica
- • Secretário de Agricultura assina convênio do Rotas Rurais em Presidente Venceslau
- • Mirante do Paranapanema recebe entregas do PAA Cesta Verde e convênio com o Rotas Rurais
- • Em Teodoro Sampaio, Secretário de Agricultura assina convênio do Rotas Rurais e participa de inauguração de novo prédio de ETEC
- • Rotas Rurais também chega à cidade de Palmital
- • Ingredientes e nutrientes de 90 hambúrgueres industrializados são analisados em novo estudo do Ital
- • ITAL comemora 58 anos de existência com ações estratégicas de pesquisa e valorização do setor de alimentos
- • IZ comemora o dia da avicultura com importantes pesquisas na área
- • Secretário de Agricultura conhece novas variedade de batata do IAC na Unidade de Pesquisa e Desenvolvimento de Mococa
- • Instituto de Pesca lança pôsteres para divulgar números da atividade pesqueira em São Paulo
- • Pioneiro em P&D de drageados, Ital é referência para fabricantes de versões doces e salgadas
- • Pesquisadores da APTA de Colina são homenageados por contribuições para setor de confinamento em gado de corte
- • IZ desenvolve nova metodologia para análise da babesiose bovina
- • IB realiza evento online para responder dúvidas do público sobre vírus em animais e plantas
- • APTA Regional orienta sobre cuidados com seringais após geadas
- • Terças do Agro: Secretaria de Agricultura de SP realiza evento online sobre sanidade vegetal
- • Pesquisas da APTA Regional de Piracicaba ressaltam relevância do silício na adubação da cana-de-açúcar
- • Previsão de safa: Estado de SP deve aumentar em 2,06% produção de culturas anuais
- • APTA Regional de Pindamonhangaba realiza evento sobre horta medicinal
- • No Dia do Estagiário, APTA ressalta relevância da relação entre estudantes e Instituições de Pesquisa
- • IAC constata que aplicação de nanopartículas liberadoras de óxido nítrico contribui para recuperar plantas em condição de seca
- • IZ lança Sumário de Touros e Matrizes Nelore e Participa da 14ª Expogenética
- • Webinar comemorativo do Ital abordará segurança de alimentos com lançamento de plataforma de serviços tecnológicos especializados
- • Instituto de Pesca trabalha para incluir o pescado na Alimentação Escolar
- • Cadeia produtiva de gado de corte conhece tecnologia da APTA para produção de novilhas precoces
- • Aluna de doutorado do IB recebe prêmio oferecido pela Sociedade Brasileira de Entomologia
- • Preços agropecuários sobem 9,16% em julho, informa IEA
- • IAC obtém patente de invenção de máquina de poda e pré-poda da videira
- • Tradicional curso de embalagens plásticas do Ital recebe inscrições para edição on-line e ao vivo
- • Ital e IP realizam curso on-line sobre produtos de pescado à base de CMS com chef Dário Costa na programação
- • Instituto de Pesca orienta piscicultores a cuidado com os peixes no inverno
- • IZ entrega ao setor produtivo tecnologia inédita para detecção de fraudes em produtos lácteos
- • Estão abertas inscrições para os principais eventos de cogumelo do Brasil
- • Unidade de Pesquisa e Desenvolvimento de Tietê da APTA Regional recebe secretário de Agricultura
- • Centro Avançado de Pesquisa Marinho do Instituto de Pesca recebe equipe da Secretaria de Agricultura
- • Secretário Itamar Borges visita o Centro de Engenharia e Automação do IAC
- • Centro de Frutas do Instituto Agronômico (IAC) recebe o secretário de Agricultura
- ► Julho (33)
- • Instituto Agronômico alerta sobre geada nos dias 29 e 30 de julho
- • Estado confirma parceria com empresa para nova biotecnologia de cultura da soja
- • Governo de SP anuncia investimento recorde em pesquisa agropecuária
- • IZ realiza webinar para mostrar como a pecuária pode ser mais sustentável
- • Instituto Biológico lança série de webinars interativos
- • Dia da Agricultura Familiar: Institutos de Pesquisa de SP estão ao lado do pequeno produtor na melhoria da produtividade e gestão das propriedades
- • Projeto internacional com participação do Instituto de Pesca apresenta resultados sobre sustentabilidade na pesca de arrasto do camarão
- • Dia do Suinocultor: confira ações de Institutos de Pesquisa paulistas para o setor
- • Em Campos do Jordão, Secretário de Agricultura visita unidade do Instituto de Pesca que desenvolve pesquisas com trutas
- • Agronegócio: aumentos das exportações do Complexo Sucroalcooleiro, Carnes e Sucos, garantem alta de 13,5% no superávit
- • IAC apresenta as principais pesquisas do setor citrícola na 42ª Semana da Citricultura, 46ª Expocitros e 52º Dia do Citricultor
- • Sanidade animal, fator chave para abertura e manutenção de mercados, será discutida na live Terças do Agro
- • Secretário de Agricultura realiza a abertura do Webinar Comemorativo dos 116 anos do Instituto de Zootecnia
- • Pesquisas do Instituto de Pesca com tubarões e raias em cativeiro trazem mais conhecimento sobre as espécies e contribuem para preservação
- • 116 anos: IZ contribui na evolução da pecuária com sustentabilidade nos sistemas de produção
- • Pela primeira vez no Brasil, pesquisador do IB realiza sequenciamento do genoma completo do vírus da laringotraqueíte infecciosa das galinhas (VLTI)
- • Pesquisa da APTA Regional de Pindamonhangaba aposta na adoção de práticas integrativas em propriedades rurais para conciliar produção e preservação
- • Pesquisador do IZ detalha como superar a falta de alimento aos animais na estiagem
- • Pesquisadores de citros e solos do IAC são agraciados com o prêmio Yara Boa Colheita Experts
- • Dia Mundial da Pizza: 56 pizzas comercializadas no varejo têm valor nutricional analisado pelo Ital
- • Secretaria de Agricultura e Abastecimento de SP e Esalq/USP assinam protocolo de intenções para o desenvolvimento do agro paulista
- • Preços Agropecuários sobem 3,23% em junho, informa IEA
- • APTA Regional de Piracicaba recebe o Secretário Itamar Borges
- • Ital lança estudo que analisa 180 sorvetes industrializados com foco na alimentação, nutrição e bem-estar
- • Ciclo de Seminários IEA discute o Plano Agrícola e Pecuário
- • Prefeito de Ribeirão Preto conhece as instalações da Usina Verde de Compostagem do Instituto Agronômico (IAC) em Campinas
- • Cura de produtos cárneos com compostos vegetais é tema de webinar gratuito oferecido pelo Ital
- • Secretário de Agricultura e Presidente da Alesp visitam o Centro de Seringueira e Sistemas Agroflorestais do IAC, em Votuporanga
- • APTA Regional Pindorama recebe secretário de Agricultura de São Paulo
- • Em Ribeirão Preto, Secretário de Agricultura confere os resultados do Centro de Cana do IAC e encontra prefeito Duarte Nogueira
- • Com a presença do prefeito de São José do Rio Preto, Secretário de Agricultura de SP assina nova resolução para produção de mudas de seringueira
- • Uso da tuberculina bovina é uma grande estratégia de prevenção da tuberculose em bovinos
- • Secretaria de Agricultura e Abastecimento de SP realiza curso para habilitar engenheiros agrônomos para certificação fitossanitária
- ► Junho (37)
- • Atualização em sistema de monitoramento pesqueiro reduz em dois meses a disponibilização de informações da atividade em São Paulo
- • 134 anos do IAC são celebrados com resultados e parceria
- • Rações formuladas pelo IP para produção de tilápia podem reduzir em R$ 30 mil os custos de piscicultor de Zacarias
- • Balança Comercial do Agronegócio: vendas do Complexo Sucroalcooleiro mantêm trajetória de alta
- • Na Fazenda Santa Elisa do IAC-APTA, Secretário de Agricultura conhece a Usina Verde de Compostagem e centros de pesquisa do instituto
- • Diretoria do Ital apresenta instalações do Instituto para o Secretário de Agricultura de SP
- • Secretário de Agricultura visita o Laboratório de Análise Química de Fertilizantes e de Resíduos do IAC
- • IAC celebra 134 anos com novas tecnologias
- • Considerada uma tecnologia disruptiva, Carne Mecanicamente Separada de pescado une melhor aproveitamento e promoção da alimentação saudável
- • Instituto de Economia Agrícola tem novo diretor-geral; conheça as perspectivas para a nova gestão
- • APTA Regional de Assis recebe visita do Secretário de Agricultura de SP
- • IAC e APTA Regional de Presidente Prudente lançam seis cultivares de batata-doce
- • Secretário de Agricultura de SP conhece a APTA Regional de Presidente Prudente
- • Ital contribui com Federação Internacional do Leite para integrar e desenvolver o setor lácteo nacional
- • Pesquisador do Instituto Biológico participa da criação de método mais rápido e eficaz para análise de resíduos em alimentos
- • Pesquisa é prioridade para a Secretaria de Agricultura
- • Leite: alimento de alto valor nutricional está sempre no foco das pesquisas do IZ
- • Bragantia: Revista Científica do IAC completa 80 anos
- • Itamar Borges conhece unidade de pesquisa em fitotecnia e melhoramento genético de cereais e citros da Secretaria
- • Em Registro, secretário Itamar Borges conhece trabalho de pesquisa com bubalinocultura
- • Órgãos de pesquisa da Agricultura de SP destacam potencial do Brasil no mercado de proteína vegetal
- • Previsão de Safra: cana e laranja sofrem pequenas oscilações, café está na fase de bienalidade negativa, aponta IEA
- • Secretário de Agricultura e Abastecimento do Estado de São Paulo visita a APTA Regional de Pariquera-Açu
- • Previsão de Safra: IEA divulga os resultados para as culturas perenes e semiperenes
- • Pacote tecnológico da APTA Regional para o setor de amendoim reduz em até 80% danos causados pelo percevejo-preto
- • Previsão de Safra: IEA aponta boas perspectivas de produção e produtividade para os grãos em 2021
- • Unidades de pesquisa da APTA de São José do Rio Preto e Cordeirópolis são visitadas por secretário de Agricultura de SP
- • IAC faz em formato digital a 42ª Semana da Citricultura, a 46ª Expocitros e o 51º Dia do Citricultor
- • Secretário de Agricultura e Abastecimento participa de reunião sobre o Núcleo de Pesquisa Orientada aos Problemas no Estado de São Paulo
- • Itamar Borges conhece laboratórios de ponta do Instituto Biológico
- • Secretaria de Agricultura de SP realiza webinar Pescado é Saúde, trazendo muita informação sobre o alimento que vem das águas
- • Ital oferece bolsa de pós-doutorado em Biotecnologia com foco em bactérias láticas
- • IZ está com nova diretoria geral, com posse de Itamar Borges como Secretário Estadual de Agricultura e Abastecimento de SP
- • Secretário de Agricultura de SP conhece unidades de pesquisa da APTA em Colina, Sertãozinho e Descalvado
- • Milho safrinha sofre com o período de seca
- • Instituto Agronômico tem novo diretor-geral
- • Sergio Tutui é o novo coordenador da APTA
- ► Maio (24)
- • Secretaria de Agricultura e Abastecimento de SP ensina receita prática com ingredientes do agro paulista
- • 500 mil doses de tuberculina passam a ser distribuídas para todo o Brasil nesta segunda-feira
- • Com atuação de destaque no universo profissional, ex-alunos da pós-graduação do Instituto de Pesca exaltam qualidade da formação recebida
- • Agronegócio: exportações do Complexo Sucroalcooleiro crescem 37,4% entre janeiro e abril de 2021 e aumentam superávit
- • IB disponibiliza ao setor agro frascos de produto para diagnosticar brucelose com menos doses
- • Secretaria de Agricultura entrega tecnologia para produção de novilhas em tempo 40% mais rápido
- • Secretaria de Agricultura e Abastecimento disponibiliza cavalos para o policiamento do Estado de São Paulo
- • Você sabia que cada “cabelo” fertilizado da espiga de milho forma um grão? Sim! A “boneca de milho” guarda informações interessantes
- • Instituto de Zootecnia realiza pesquisas de milho consorciado com plantas forrageiras
- • No Dia Nacional do Café, Secretaria de Agricultura de SP faz live com as tecnologias paulistas para o setor cafeeiro
- • Carrapatos podem trazer danos à saúde de cavalos e potros e prejuízo ao produtor rural
- • Secretaria de Agricultura e Abastecimento de SP ensina a fazer carpaccio de cogumelo
- • Pesquisador do IB discute tecnologias sustentáveis na agricultura em festival mundial de divulgação científica
- • Governo de São Paulo lança aplicativo para cadastro de endereço de produtores rurais
- • No Dia Internacional dos Museus, público poderá assistir lives com visitação ao vivo ao Planeta Inseto e Museu de Pesca
- • Aceitação do pescado certificado é tema de pesquisa de mercado desenvolvida pelo Instituto de Pesca em Votuporanga
- • Opção sustentável para obtenção de insumos para a indústria, macaúba é tema de webinar gratuito no dia 26
- • Dia do Zootecnista: profissional atende do produtor ao consumidor final ao oferecer tecnologias que geram segurança alimentar
- • Você sabia? São necessários cerca de 12 anos para o desenvolvimento de uma nova variedade de cana; entenda o processo
- • Itu é a primeira cidade do Brasil a ter endereços digitais em 100% do território
- • Análises de equipamentos multiusuários do Ital possibilitam melhoria de qualidade de alimentos e embalagens
- • Joaninhas são eficientes no controle de pulgões em hortaliças
- • IAC coordena Rede Morangos do Brasil para o desenvolvimento tecnológico da cultura
- • Pesquisa inédita identifica três variedades de acerola para cultivo na Alta Paulista
- ► Abril (31)
- • Saúde das abelhas é pesquisada em Laboratório da Secretaria de Agricultura e Abastecimento de SP
- • Técnicos da Secretaria de Agricultura de SP orientam como suplementar a alimentação do gado durante a estiagem
- • Pesquisas do IZ mostram as vantagens da dinâmica de sistemas aplicada ao comportamento de Bovinos
- • Curso do Ital ensina a fabricar iogurtes, leites fermentados e bebidas lácteas fermentadas
- • Balança Comercial: exportações do agro paulista sobem 7,5% e fecham o trimestre com US$ 3,87 bilhões
- • Secretaria de Agricultura de SP desenvolve variedade de batata-doce de polpa alaranjada e com produtividade duas vezes superior à média nacional
- • Ciclo de Seminários IEA aborda os desafios na produção e comercialização de orgânicos
- • Secretaria de Agricultura e Abastecimento de SP lança novo episódio de série para cozinhar em casa
- • Biotecnologias produtivas e reprodutivas do IZ colaboram na bubalinocultura brasileira
- • Secretário de Agricultura e prefeito de Campinas visitam a Usina Verde de Compostagem nesta quinta, 22
- • VPA 2020: Cana, Carne Bovina e Soja mantêm as primeiras posições
- • Ital levanta pontos críticos de contaminação por micotoxinas em café, amendoim e cana-de-açúcar para prevenir e reduzir riscos
- • Previsão de Safra: boas perspectivas para os grãos, cana e laranja permanecem estáveis
- • Instituto de Pesca estuda Sistemas de Recirculação de Água, considerados a forma mais ecológica de produzir peixes em nível comercial
- • Dia Nacional de Conservação do Solo: Secretaria de Agricultura de SP atua com medidas de proteção e melhorias
- • IB identifica resposta imunológica diferente da toxoplasmose em cepas do protozoário do Brasil e da Europa
- • IAC comemora Dia Nacional de Conservação do Solo com evento online
- • Bioeconomia será o tema da próxima edição do Ciclo de Seminários IEA
- • Institutos da Secretaria de Agricultura de SP disponibilizarão 50 soluções tecnológicas ao agro em 2021
- • IZ venderá bubalinos machos e fêmeas
- • Secretaria de Agricultura e Abastecimento de SP lança segundo episódio de série para cozinhar em casa
- • Patentes de SP viabilizam reduzir e até eliminar uso de aditivos em grãos, cereais e farinhas por micro-ondas e plasma
- • Secretaria de Agricultura de SP realiza leilões para venda de 404 bovinos
- • Instituto de Pesca faz 52 anos
- • Bovinos Nelore e Guzerá do IZ estarão à venda
- • IAC apresenta nova variedade de lima ácida Tahiti, a IAC 10, e dois novos porta-enxertos
- • Pesquisa paulista explica como a produtividade de cana varia no mesmo tipo de solo
- • Moscas-das-frutas é tema de manual técnico produzido por pesquisadores do IB
- • Carne de cordeiro, uma ancestralidade à moda brasileira, explica pesquisador do IZ
- • Você consome pescado? Pesquisadoras do Instituto de Pesca explicam porque devemos incluí-los na alimentação e elucidam alguns mitos
- • Instituto Biológico atesta sanidade das galinhas produtoras de ovos controlados usados pelo Butantan
- ► Março (36)
- • Tecnologia da Secretaria de Agricultura e Abastecimento de SP aumenta em 20% o ganho de peso de peixes panga
- • Bienal e internacional, conferência do Ital com a Tappi dedicada a embalagens plásticas flexíveis será on-line pela primeira vez
- • Balança Comercial: 35% das exportações paulistas vêm do campo
- • Qualidade da água para ingestão é foco do Ital em atividades relacionadas a galões retornáveis e aproveitamento de vapor
- • Cafeicultores de Garça pedem registro de indicação geográfica da região como produtora de cafés de alta qualidade
- • Online: 12ª edição do Dia de Campo de Amendoim aborda principais inovações
- • Secretaria de Agricultura e Abastecimento de SP lança série de vídeos com receitas fáceis para fazer em casa
- • Consumo de Peixes Não-convencionais une sabor, nutrição e fortalecimento da pesca regional
- • Instituto de Pesca apoia divulgação de evento do Dia dos Bivalves da Água Doce da América do Sul
- • Pesquisa paulista avalia ponto ótimo de maturação de azeitonas para obter o melhor azeite
- • Secretaria de Agricultura e Abastecimento disponibiliza publicação com “Levantamento das Unidades de Piscicultura no Estado de São Paulo”
- • Dia do Cacau: Ital pesquisa contaminação e qualidade do fruto e seus derivados, além de desenvolver novos produtos
- • Live comemorará os 80 anos da revista científica “Boletim da Indústria animal” do IZ
- • Contratos bancários do agronegócio serão analisados no Ciclo de Seminários IEA
- • Instituto de Zootecnia venderá bovinos Santa Gertrudis
- • Dia Mundial da Água: pesquisas da Secretaria de Agricultura buscam preservar e garantir a qualidade do recurso no decorrer de toda cadeia produtiva
- • Nova tecnologia da Secretaria de Agricultura de SP traz ganhos econômicos para produtores de camarão e lambari
- • IZ abre inscrição para 2ª Prova de Eficiência e Performance Boi com Bula® para obter Super Touros, em parceria com a BrasilcomZ
- • Pressionados pela atividade pesqueira, tubarões e raias são tema de livro com participação de pesquisadores do Instituto de Pesca
- • Secretaria de Agricultura e Abastecimento de SP destaca iniciativas em atenção às mudanças climáticas
- • Saiba o que são e como evitar a ocorrência de traças em alimentos, livros e roupas
- • Preços convidativos e demanda aquecida transformaram a soja no grão mais cultivado em solo paulista
- • Charque, jerked beef e carne de sol são abordados em curso inédito do Ital, que tem chef Rodrigo Oliveira na programação
- • Instituto de Pesca se une a órgão federal para incentivar aquicultores paulistas a preencherem Relatório Anual de Produção
- • Cônsul geral da Índia visita unidades de pesquisa da Secretaria de Agricultura e Abastecimento de SP
- • Secretaria de Agricultura desenvolve estudos para melhorar fertilidade e reduzir a temperatura de solo dos pomares de acerola
- • Formigas podem causar problemas nas cidades e no campo; conheça esses insetos
- • Instituto de Zootecnia tem inscrição para bolsa Fapesp para Pós-doc em Genômica
- • Pesquisa da Secretaria de Agricultura de SP faz levantamento sobre mercado de filé de tilápia em São José do Rio Preto
- • Ciclo de Seminários IEA discute a importância dos índices de preço para balizar o mercado
- • Mulheres ocupam 52% dos cargos em instituições de pesquisa da Secretaria de Agricultura e são maioria entre diretores e pesquisadores
- • IAC lança Boletim Agrometeorológico para regiões cafeeiras paulistas
- • Brocas podem atacar objetos de madeira, livros, árvores e acervo de museus; saiba o que fazer
- • Cursos, seminários e conferência internacional on-line integram calendário de eventos 2021 do Ital
- • Secretaria de Agricultura desenvolve pesquisas para selecionar pitayas adaptadas para o cultivo em São Paulo
- • Exportações do agro sobem 3,8% e já representam mais de 37% das vendas externas do Estado
- ► Fevereiro (23)
- • Período de defeso vai até 28 de fevereiro em São Paulo e toda Bacia do Rio Paraná
- • Consórcio de leguminosa e gramínea resulta em aumento de ganho de peso de bovinos e mitigação de gases de efeito estufa
- • IAC desenvolve método de classificação por imagens digitais para evitar perdas em frutas de caroço
- • Tem caruncho no meu arroz! Pesquisador do IB dá dicas sobre o que fazer
- • Pesquisas da Secretaria de Agricultura de SP transformaram produção e comercialização da mandioca de mesa
- • Será que minha árvore tem cupins?
- • IAC usa sensoriamento remoto para avaliar estado hídrico da cana
- • Levantamento realizado Secretaria de Agricultura de SP traz os dados finais para cana, laranja e outras importantes culturas
- • Conservação da biodiversidade, geração de renda e segurança alimentar são foco de pesquisa liderada pela APTA
- • Guia do Ital sobre embalagens para a indústria farmacêutica abrange materiais e requisitos de qualidade
- • Capacitação sobre mosca dos estábulos reúne cerca de 90 técnicos e pesquisadores da Secretaria de Agricultura
- • Instituto de Pesca desenvolve método mais barato de criação de lambari para isca viva
- • Previsão de Safra: soja e amendoim mantêm tendência de aumento de área e produção na safra 2020/21
- • Mulheres ocupam maioria dos cargos de direção dos Institutos de pesquisa da Secretaria de Agricultura de SP
- • Perdas de produtos hortifrutigranjeiros: onde ocorrem e quais os principais motivos?
- • IB tem inscrição aberta para bolsa de Jovem Pesquisador na área de bioinformática aplicada
- • Altas temperaturas e chuvas faz proliferação de mosquitos aumentar
- • Instituto de Pesca participa de pesquisa internacional inédita que mapeou pesca em manguezais no mundo
- • Secretaria de Agricultura comemora 80 anos da publicação científica “Boletim da Indústria Animal” do IZ
- • Secretaria de Agricultura inicia pesquisas com pecuária de precisão na área de nutrição de gado de corte
- • Principais fungicidas usados no controle de doença em tangerinas perdem eficácia em todo o Estado de São Paulo
- • Secretaria de Agricultura viabiliza cultivo de uva para produção de vinhos finos nas condições paulistas
- • Produção paulista de milho: variedade e alta produtividade
- ► Janeiro (26)
- • Agronegócio: Balança Comercial Paulista fecha 2020 com superávit de US$ 13,10 bi
- • Boletim do Instituto de Pesca comemora 50 anos e apresenta novas conquistas
- • Programa de Pós-Graduação em Aquicultura e Pesca comemora a formação de seu 200º aluno de Mestrado
- • Pós-Graduação do IB forma Mestres e Doutores preparados para resolver os problemas de sanidade do agro
- • Secretaria de Agricultura lança série com dez podcasts sobre suas pesquisas com controle biológico
- • De Recife a Campinas em busca de tecnologia do Instituto Agronômico
- • 467 anos de São Paulo: Cidade contribui para o desenvolvimento sustentável do agro paulista
- • Secretaria de Agricultura de SP viabiliza produção orgânica de uva em São Roque
- • Cafés especiais proporcionam inúmeras experiências sensoriais aos consumidores
- • Carrapato do bovino: é preciso estar atento a vários fatores para um controle efetivo do parasita no rebanho leiteiro
- • Água de reuso diminui a pegada hídrica na suinocultura, apontam pesquisas do IZ
- • Pesquisadores e extensionistas da Secretaria de Agricultura de SP participam de obra sobre reserva do Cinturão Verde da capital paulista
- • Secretaria de Agricultura de SP desenvolve pesquisa inédita com trutas de coloração azul-prateada e amarela
- • Visitação Virtual do Museu de Pesca é opção instrutiva e divertida para as férias
- • Pesquisa da APTA Regional mostra impacto da pandemia no setor de hortaliças e frutas na região de Marília
- • Instituto Biológico, da Secretaria de Agricultura, aumentou em 20% sua produção de antígenos para diagnóstico de brucelose e tuberculose em animais
- • Pesquisador do IAC recebe prêmio internacional por pesquisa com aplicação de bactérias benéficas em mudas de cana
- • Ital lança livro trilíngue sobre urucum que contempla 30 anos de pesquisa junto à cadeia produtiva
- • Secretaria de Agricultura divulga a estimativa preliminar do VPA 2020
- • Modernização de estrutura e expertise do Ital permitem valorizar fruticultura e olericultura dentro e fora de SP
- • Lichia: quem ainda não provou tem até o final de janeiro para apreciar a fruta
- • Peixes vivem em poças de água temporárias? Conheça o killifish
- • Transplantadora de MPB adequada ao sistema MEIOSI é novo desdobramento do Sistema de Mudas Pré-Brotadas do IAC
- • Fomento ao consumo de pescado para alimentação mais saudável é tema de proposta inédita aprovada pela FAPESP
- • Agronegócio: Balança Comercial Paulista tem superávit de US$ 12 bi
- • FAPESP, empresas e governo investem R$ 34,8 milhões no IAC para alcançar resultados inéditos nas culturas de citros, café e cana-de-açúcar
- ► Dezembro (24)
- ► 2020 (335)
- ► Dezembro (26)
- • É tempo de uva Niágara!
- • Secretarias de Agricultura e Desenvolvimento Econômico vão oferecer cursos de inglês online e gratuito para produtores paulistas
- • Instituto Biológico treina técnicos da Prefeitura de São José dos Campos na identificação de carrapatos
- • Plataforma Biotecnológica de Ingredientes Saudáveis liderada pelo Ital é aprovada pela Fapesp
- • Profissionais da Secretaria de Agricultura participam da elaboração de Guia para vacinação contra brucelose
- • IAC atualiza o sistema de Mudas Pré-Brotadas de cana e o torna mais sustentável
- • Secretaria de Agricultura e Abastecimento de SP possui variedade de sorgo específica para produção de vassoura caipira
- • Dez anos do Planeta Inseto: conheça sete curiosidades encontradas no único zoológico de insetos do Brasil
- • Secretaria de Agricultura e Abastecimento fará vigilância epidemiológica de morcegos em São Paulo
- • No Vale do Ribeira, Secretaria de Agricultura desenvolve pesquisa para verificar a real necessidade da reforma dos bananais
- • Secretaria de Agricultura e Abastecimento disponibiliza 68 bovinos do IZ para venda
- • Secretaria de Agricultura participa de Fórum Internacional voltado à inovação no agro
- • Ital oferece bolsa jovem pesquisador em Contaminação de Alimentos por Embalagens
- • Secretaria de Agricultura e Abastecimento de SP pesquisa produção de palmito para ampliar opções no mercado
- • Aquecimento do mercado de exportação da soja no mundo demanda investimento em pesquisas e infraestrutura
- • Estudante da Pós-graduação do Instituto de Pesca alcança 2º lugar na 1ª Maratona Digital de Aquicultura
- • Pesquisador da Secretaria de Agricultura e Abastecimento de SP participa de evento internacional sobre tubarões
- • Biocarrapaticida desenvolvido pelo Instituto Biológico é utilizado no controle de carrapato-estrela em São José dos Campos
- • Evento Mesa Regeneração conecta conhecimentos da pesquisa científica, produção agrícola e alta gastronomia
- • V Encontro de Boas Práticas na Pecuária Leiteira é resultado da parceria entre pesquisa e extensão da Secretaria de Agricultura e Abastecimento
- • Instituto de Zootecnia vende ovinos machos e fêmeas
- • Controle de parasitos em peixes exige manejo adequado, orienta pesquisador do Instituto de Pesca
- • Dia Mundial do Solo: Secretaria de Agricultura e Abastecimento de SP atua em várias frentes de preservação e conscientização
- • Quais as recomendações para viabilizar os canaviais transgressivos?
- • Seminário online reúne institutos de pesquisa de SP e startups na busca de inovações para o agro
- • Melancia: saúde e frescor em cada fatia!
- ► Novembro (33)
- • Produção de limão é símbolo de orgulho ao Estado de SP, principal produtor do Brasil
- • Pesquisa estuda viabilidade do cultivo de melancia em áreas de renovação de canavial
- • Produção orgânica é tema de curso proferido por pesquisador da Secretaria de Agricultura e Abastecimento de SP
- • Embalagem autônoma inteligente para cadeia fria de sistemas de saúde é foco de projeto interinstitucional aprovado pela Finep
- • Boletim do Instituto de Pesca, voltado à pesquisa em Pesca, Aquicultura e Limnologia, é publicado com novas regras e artigos
- • Fungos do bem: Secretaria de Agricultura de SP pesquisa Trichoderma, usados para controlar doenças na agricultura
- • Público poderá fazer uma visitação virtual e ao vivo no Planeta Inseto
- • Secretaria de Agricultura capacita 250 pessoas em segurança dos alimentos na região de Bauru
- • Sementes de feijão da Secretaria de Agricultura e Abastecimento de SP começam a ser vendidas para cultivo da safra 2021
- • Sanasa inicia obra em unidade do IB para implantação da rede de esgoto das regiões de Gramado II e Santa Marcelina
- • Profissionais da Secretaria de Agricultura e Abastecimento participam de evento online sobre transição agroecológica
- • Secretaria de Agricultura e Abastecimento de SP promove treinamento de startups para atuar no setor dos agronegócios
- • Evento de iniciação científica da Secretaria de Agricultura e Abastecimento de SP tem apresentação de 90 trabalhos
- • Café: produto que é paixão dos brasileiros e movimenta a economia tem na capital paulista um cantinho especial
- • Livro multidisciplinar “Probióticos e Prebióticos: Inovações e Desafios” será lançado em simpósio do Ital com o IFRJ
- • IAC obtém patente para gene promotor isolado de plantas de café
- • Com 55% de área preservada, setor de papel e celulose mostra eficiência ao aliar produção e sustentabilidade
- • Instituto de Pesca participa de descoberta inédita no mundo
- • Programa Cana IAC desenvolve Indicador de Investimentos em Ações de Prevenção e Combate de Incêndios em Canaviais
- • Cadeia produtiva de papel e celulose é tema da live desta 4ª (11/11) do "Caminhos do Agro SP"
- • Palestra da Secretaria de Agricultura e Abastecimento de SP abordará as Boas Práticas na publicação científica
- • Com forte presença na mesa dos lares e do food service, requeijão cremoso é foco de curso on-line do Ital
- • Instituto Biológico comemora 93 anos com resultados capazes de mudar a realidade dos produtores paulistas
- • Trabalho do IB ajuda a mudar a realidade de pequenos produtores de leite do Vale Histórico do Rio Paraíba
- • IZ recebe troféu “Expogenética 2020” pelo desempenho em melhoramento genético de bovinos
- • IEA completa 78 anos de contribuição para a transparência do mercado agrícola e sucesso dos produtores rurais
- • Agronegócio: superávit da Balança Comercial Paulista sobe 22% e fecha em US$ 9,61 bilhões
- • Secretaria de Agricultura de SP mantém maior acervo de fungos e oomicetos do Brasil na área de doenças dos citros
- • Plantas também ficam doentes; saiba o que fazer
- • Seis questões que podem te fazer incluir mais peixes na alimentação
- • Roçadeira ecológica em conjunto com consórcio de braquiária ruziziensis amplia a produtividade de Tahiti em 30%
- • Defeso da piracema tem início em 1º de novembro em SP: estoque de pescado deve ser informado
- • Exigência do consumidor e abertura de novos mercados desafiam a citricultura brasileira
- ► Outubro (36)
- • Webinar do Ital aborda microencapsulação para produzir ingredientes substitutos de gorduras trans e de outros insumos em alimentos
- • Líderes globais da UPL visitam IB e conhecem pesquisas em controle biológico
- • Secretaria de Agricultura e Abastecimento de SP faz recomendações para manejo do vírus vira-cabeça que afeta alface e tomate
- • Pesquisadores da Secretaria de Agricultura de SP integram programação do Inova Trade Show 2020
- • Ciclo de Seminários IEA analisa os efeitos da reforma tributária sobre o Agronegócio
- • Citricultura é o tema desta semana do "Caminhos do Agro SP"
- • Secretaria de Agricultura e Abastecimento do Estado de SP promove Concurso de Qualidade do Café do Circuito das Águas Paulistas
- • Pesquisadora do Instituto Biológico contribui com nova edição de livro sobre doenças das aves
- • Produção diversificada de hortaliças garante renda ao produtor rural e nutrição ao consumidor
- • Pandemia acelera processos de certificação e coloca Brasil à frente no fornecimento de alimentos seguros para o mundo
- • Ital oferece bolsa de pós-doutorado em Ciência de Alimentos com foco em metabólitos fúngicos
- • Pesquisa com participação da Secretaria de Agricultura é reconhecida por revista científica referência na área animal
- • Dez anos de acreditação pelo Inmetro: O que isso tem a ver com qualidade e lavouras
- • Dia Nacional da Alimentação Escolar: Secretaria de Agricultura e Abastecimento de SP destaca ações para promover saúde de crianças e adolescentes
- • Interessados na Pós-Graduação do IAC podem se inscrever até 22 de novembro para seleção de mestrado
- • Resíduo do tratamento de esgoto de Piracicaba poderá se tornar fertilizante orgânico para agricultura
- • Uso de resíduos agroindustriais para alimentos e aplicações técnicas é tema de webinar gratuito do Ital com Fraunhofer IVV
- • Yes, nós temos Banana!
- • Dezoito trabalhos de iniciação científica de bolsistas ligados à Secretaria de Agricultura são reconhecidos em congresso
- • Institutos da Secretaria de Agricultura e Abastecimento de SP integram semanas de Ciência, Tecnologia e Inovação
- • Dia Mundial da Alimentação: Secretaria de Agricultura contribui para a segurança alimentar no Estado
- • Secretaria de Agricultura e Abastecimento de SP faz diagnóstico inédito das pesquisas desenvolvidas em seus Institutos
- • Princípios da Ciência e Tecnologia de Carnes são abordados em capacitação on-line inédita do Ital
- • Pesquisadora da APTA é nova Consultora Técnica da Câmara Setorial da Cadeia Produtiva da Borracha Natural do MAPA
- • Ciclo de Seminários discute o uso tributário dos valores de terra do IEA
- • Pesquisador do IZ usa simulador de soluções climáticas globais online para engajar agentes rurais no planejamento estratégico da pecuária sustentável
- • Qualidade do ovo, bem-estar animal e saúde das aves são foco das pesquisas da Secretaria de Agricultura e Abastecimento de SP
- • Dia do Engenheiro Agrônomo: Secretaria de Agricultura conta trajetória de profissionais da Pasta e mostra a importância da profissão
- • Dia das Crianças: visite de forma virtual as exposições Planeta Inseto e Museu de Pesca
- • Pesquisa traça perfil de pescadores artesanais na Baixada Santista
- • Pesquisadores do IB e do IAC estudam o uso de drones na aplicação de fungos para o controle dos carrapatos estrela e do boi
- • Pesquisa da Secretaria de Agricultura de SP mostra que uso de probióticos na alimentação de tilápias melhora desempenho da vacinação
- • Secretaria de Agricultura convida interessados em participar do processo seletivo para as 16 CRSANS e para o Consea-SP
- • Representante da FAO apresenta situação e perspectivas da pesca no mundo
- • Morango: produtores ávidos por inovação desenvolvem a fruta altamente nutritiva e com consumo expressivo
- • Presença da cigarrinha-do-arroz em SP deixa produtores atentos
- ► Setembro (41)
- • Bolsistas do PIBIC-CNPq dos Institutos de Pesquisas da Secretaria de Agricultura e Abastecimento apresentarão resultados de pesquisas no Congresso Interinstitucional de Iniciação Científica 2020
- • Bolsistas de Institutos de Pesquisa da Secretaria de Agricultura de SP apresentam trabalhos de iniciação científica em Congresso
- • IB dobra prazo de validade de produto para diagnóstico de tuberculose em bovinos
- • Mais de 200 profissionais da Secretaria de Agricultura de São Paulo participam de treinamento em doenças de animais aquáticos
- • Ciclo de Seminários IEA analisa a Recuperação Judicial no Agronegócio
- • Estudantes de iniciação científica podem inscrever resumos para participar de congresso no Instituto Biológico
- • Covid-19 e embalagem: Ital aponta reflexos da pandemia em questões de sustentabilidade e tendências no mercado
- • IAC produz cerca de 500 toneladas de sementes genéticas por ano
- • Seringueira: fungo selecionado pelo IB para controle do percevejo de renda pode reduzir em 60% os custos com aplicação de defensivos
- • Agronegócio paulista: saldo da Balança Comercial supera US$ 8 bi
- • Acordo do Ital com a BioinFood permite instalação da startup em órgão da Secretaria de Agricultura e Abastecimento de SP
- • Covid-19 e embalagem: pesquisador do Ital esclarece sobre possibilidades de contaminação através dos materiais
- • Diretor do IAC toma posse como membro titular da Academia Brasileira de Ciências nesta quarta, 23
- • Inverno de 2020 apresentou maior ocorrência de dias com umidade relativa do ar abaixo de 20%
- • Previsão de Safra: com aumento de área, produção e produtividade, Soja e Amendoim são os destaques do levantamento
- • Previsão de Safra: tomate e borracha apresentam aumento de produção
- • Trabalhos da Secretaria de Agricultura e Abastecimento de SP garantem segurança das lavouras brasileiras
- • Curso exclusivo do Ital dedicado a embalagem para transporte e distribuição é oferecido pela primeira vez no formato on-line
- • IZ divulga resultado da seleção de bolsista Fapesp para Pós-doc em microbiologia
- • Ital divulga edital do Processo Seletivo 2021 para mestrado em Ciência e Tecnologia de Alimentos
- • Cana-de-açúcar: pesquisa inovadora do IB busca o controle biológico do bicudo, principal praga da cultura
- • Biofortificação: IAC aumenta em 16 vezes o teor de zinco nas folhas de alface
- • 6ª Semana Tecnológica Cereal Chocotec terá capacitações em produtos de panificação e confeitaria
- • Secretaria de Agricultura e Abastecimento promove seminário online sobre a altimetria no contexto da avaliação de impactos em PD&I
- • Leilão com a melhor genética de Reprodutores e Matrizes IZ arrecada mais de R$ 1 milhão
- • Pesquisa da Secretaria de Agricultura analisa fatores que influem na sustentabilidade do setor de pesca
- • Investimento em pesquisa é um alicerce para a rentabilidade do agronegócio
- • Público poderá visitar de forma virtual o único zoológico de insetos do Brasil
- • Comemoração dos 51 anos do Centro de Engenharia e Automação do IAC destaca o impacto das pesquisas
- • Flores: uso de controle biológico proposto pelo IB pode reduzir em 70% a aplicação de acaricidas
- • Dia do Médico Veterinário: Profissional garante a sanidade e a qualidade da produção agropecuária paulista
- • Secretaria de Agricultura e Abastecimento debate a Cédula de Produto Rural e traz explicações ao produtor
- • Agronegócio: superávit da Balança Comercial Paulista é de US$ 7,07 bi
- • Café bate recorde com produção 39,7% maior que a de 2019, cana e laranja mantêm estabilidade
- • Covid-19: contaminação através de embalagens é tema de webinar gratuito do Instituto de Tecnologia de Alimentos
- • Dia do Biólogo: Secretaria de Agricultura de SP mostra a atuação desse profissional fundamental para o setor dos agronegócios
- • Principal blog sobre agricultura é liderado por bióloga que atua no Centro de Citricultura do IAC
- • Instituto da Secretaria de Agricultura e Abastecimento contribui com pesquisa da Embrapa para inativar coronavírus
- • Banana: fungo selecionado pelo IB controla broca-da-banana, principal praga da cultura
- • Levantamento do IAC mostra que micronutrientes balanceados beneficiam a produtividade e a qualidade dos citros
- • No aniversário de 57 anos, Instituto de Tecnologia de Alimentos destaca maior integração e responsabilidade social
- ► Agosto (25)
- • Reprodutores e Matrizes linhagem IZ serão comercializados em leilão virtual
- • Ciclo de Seminários IEA discute a CPR digital à luz da Nova Lei do Agro
- • Centro de Engenharia e Automação do IAC comemora 51 anos com evento online no dia 1/9
- • Dia da Avicultura: ações da Secretaria de Agricultura contribuem com o setor e ajudam na garantia da qualidade
- • Pastagens: fungo selecionado pelo IB para controle biológico da cigarrinha-das-pastagens é usado em dois milhões de hectares
- • Gostoso e nutritivo, o amendoim traz muito retorno à agricultura paulista
- • IZ debate Desenvolvimento Rural na Largada Brasileira para o 9º Fórum Mundial da Água
- • Instituto Biológico passa a oferecer diagnóstico de anemia infecciosa equina
- • Secretaria de Agricultura e Abastecimento de São Paulo apresenta nova organização da programação de pesquisa a servidores
- • Morango: Ácaro predador selecionado pelo IB pode eliminar uso de produtos químicos para controle do ácaro-rajado
- • Melhoramento genético e eficiência alimentar são foco no IZ na 13ª ExpoGenética 360º
- • Para produzir “boi padrão China” é necessário adoção de tecnologias
- • Semana de ovinos IZ abordará temas da pesquisa ao campo
- • Cogumelos são nutritivos e deliciosos: conheça dez curiosidades dos fungos
- • Sorgo IAC Santa Elisa é excelente opção para baixar o custo da alimentação na pecuária
- • Citros: IB desenvolve pesquisas para controle biológico de inseto transmissor do greening
- • Viabilidade do cultivo da banana-da-terra em São Paulo é pesquisada pela Secretaria de Agricultura e Abastecimento
- • Cultivares de feijão IAC estão em dez estados brasileiros
- • Morango está em plena safra em São Paulo
- • Instituto Biológico completa um mês de diagnóstico para Covid-19 em Policiais Militares
- • Colheita mecanizada da cana-de-açúcar atinge 95,3% das áreas produtivas na safra 2018/19
- • Secretaria de Agricultura pesquisa criação de camarão e auxilia aquicultores a se estabelecerem na atividade
- • Custo da alimentação em casa sobe quase 4% no 1º semestre, afirmam pesquisadores
- • Tratamento de efluentes da suinocultura tem menor custo e alto valor agregado à produção
- • Festival do Pescado e Frutos do mar é aberto ao público na Ceagesp
- ► Julho (25)
- • Projeto da Secretaria de Agricultura colabora com procedimentos relacionados à proteção de espécies aquáticas ameaçadas de extinção
- • Preços Agropecuários fecham o mês de junho em alta de 3,09%
- • Secretaria de Agricultura desenvolve pesquisa para melhorar rentabilidade do cafeicultor na região de Garça, no Centro Oeste paulista
- • Dia do Agricultor: 6 inovações da Secretaria de Agricultura e Abastecimento para facilitar as atividades deste profissional
- • Proteínas vegetais são tema de último webinar gratuito do Ital sobre ingredientes saudáveis para alimentos e bebidas
- • Resultados das pesquisas do Instituto Biológico estão mais acessíveis ao cidadão
- • Aprenda a degustar azeite em casa e saiba como evitar a compra de produtos fraudados
- • Canavicultor pode antecipar em quatro anos a adoção de uma nova variedade de cana
- • Mesmo durante a pandemia, superávit do agronegócio cresce 20% e ajuda a equilibrar as contas paulistas
- • Com unidade dedicada a segurança e qualidade de carnes e produtos cárneos, Ital lista as principais mudanças regulatórias
- • Instituto de Pesca realiza pesquisas em biotecnologia que pode viabilizar produção de salmão no Brasil
- • Secretaria de Agricultura reúne representantes da pesquisa, indústria e produção rural na comemoração dos 115 anos do IZ
- • Fruta-do-conde, atemoia, cherimoia: quem é quem?
- • Previsões de Safra: grãos em alta, cana se recupera e café tem à frente céu de brigadeiro
- • IZ comemora 115 anos levando à mesa do consumidor o que há de melhor em tecnologia de produção animal transferida ao produtor rural
- • Pesquisas da Secretaria de Agricultura e Abastecimento contribuem para salvar espécies de peixes ameaçadas
- • Instituto Agronômico faz recomendações para citricultores no inverno
- • Equipamento permite compostagem acelerada de resíduos orgânicos e utilização de compostos como fertilizante
- • Proteínas doces e fibras alimentares são abordadas por especialistas do Ital, da USP e da Unesp em webinar gratuito
- • Laboratório do Instituto Biológico inicia diagnóstico para Covid-19
- • ITAL é parceiro de programa de aceleração para negócios e projetos voltados para ingredientes, alimentos, bebidas e embalagens
- • Secretaria de Agricultura e Abastecimento participa de roda de conversa sobre comercialização da pesca artesanal
- • Livro mais atualizado sobre pragas e doenças da batata está disponível para download gratuito
- • Doce de leite é opção atraente de agregação de valor do leite especialmente para pequenos produtores
- • Produtos Juninos do Agro SP: Estado é referência em pesquisa científica com mandioca
- ► Junho (27)
- • Secretaria de Agricultura e Abastecimento de SP contribui para o monitoramento dos recursos pesqueiros
- • Instituto Agronômico alerta mercado sobre uso indevido de formulações que estariam sendo produzidas com NAC
- • Webinar gratuito aborda potencial dos extratos fenólicos como ingredientes saudáveis para alimentos e bebidas
- • Pesquisa da Secretaria de Agricultura mostra condições de trabalho das pescadoras na baixada santista
- • IAC faz 133 anos com resultado inédito em citros
- • IAC completa 133 anos e é homenageado pelo setor dos agronegócios e pela ciência nacional
- • Governo, academia e iniciativa privada iniciam trabalho integrado para inovar o agro paulista
- • Produtos Juninos do Agro SP: Batata-doce está presente nos tradicionais quitutes caipiras e na alimentação saudável das famílias
- • Secretaria de Agricultura e Abastecimento lança visitação virtual ao Museu de Pesca
- • Secretaria de Agricultura e Abastecimento mantém programa de inovação e transferência de tecnologia em controle biológico
- • Semana da Citricultura e Expocitros são transferidas para maio de 2021
- • Produtos juninos do agro SP: Quentão e doces juninos têm em comum a cana, principal produto da agropecuária paulista
- • Secretaria de Agricultura e Abastecimento desenvolve vacinas para peixes
- • Novo porta-enxerto de café IAC resistente a nematoides está em fase final da pesquisa
- • Água será tema de live realizada pela Secretaria de Agricultura e Abastecimento de São Paulo
- • Parceria do Ital com Unicamp e USP resulta em série de webinars sobre ingredientes saudáveis para alimentos e bebidas
- • Agro paulista também está presente no Dia dos Namorados
- • Produtos Juninos do Agro SP: Tecnologia garante variedades de milho de alta qualidade no Estado
- • Secretaria de Agricultura e Abastecimento pesquisa o mexilhão-dourado, espécie invasora que pode trazer prejuízos à piscicultura
- • Apreciadores de laranja, tangerina e limão podem parabenizar o citricultor
- • Laboratório da Secretaria de Agricultura e Abastecimento é credenciado para fazer novas análises voltadas à sanidade avícola
- • Dia Mundial do Meio Ambiente: Secretaria de Agricultura e Abastecimento promove ações para a produção agropecuária sustentável
- • São Paulo produz 90% do amendoim brasileiro e abriga parte importante dos demais elos da cadeia produtiva
- • Horta em casa ou no apartamento: uma boa adaptação às poucas visitas ao mercado
- • Secretaria de Agricultura e Abastecimento de São Paulo oferece bolsa de pós-doutorado em Ciência e Tecnologia de Alimentos
- • Período de defeso do camarão se encerrou em 31 de maio
- • Dia Mundial do Leite: São Paulo busca melhorar a qualidade e agregar valor ao produto
- ► Maio (26)
- • Saiba como evitar a presença de lesmas e caracóis no quintal ou horta
- • Secretarias estaduais criam grupo de trabalho para elaboração de Planos de Ordenamento Pesqueiro
- • Pesquisadores destacam as características das unidades de produção de coco no Estado de São Paulo
- • Trabalhos com café da Secretaria de Agricultura e Abastecimento de São Paulo trazem impactos positivos para toda a cadeia de produção
- • Dia Nacional do Café: confira 10 curiosidades da bebida que é preferência nacional
- • Pesquisadora do IB é a editora de preprints da área de Ciências Agrárias na SciELO
- • No Dia Mundial das Abelhas, Secretaria de Agricultura apresenta suas ações relacionadas à conservação
- • Secretaria de Agricultura e Abastecimento apoia campanha para estimular o consumo de etanol
- • Aquicultura no inverno: cuidados necessários com os peixes
- • Estado de São Paulo está em plena safra de citros
- • 500 dias de Governo: Secretaria de Agricultura e Abastecimento de SP foca em gestão moderna com estratégias assertivas
- • Pesquisas continuam nas unidades da Secretaria de Agricultura, que realizam colheitas de soja, milho e amendoim
- • Instituto de Zootecnia tem inscrição para bolsa Fapesp para Pós-doc em microbiologia
- • Comunicado oficial – Adiamento da Semana da Citricultura
- • Pesquisadores da Secretaria de Agricultura integram centro de pesquisa inovador da área de canavicultura no Brasil
- • Secretaria de Agricultura marca o dia do zootecnista com a importância das pesquisas do IZ na agropecuária
- • Pesquisa aponta aumento de preparo de alimentos em casa e preocupação com higiene e limpeza do foodservice
- • Pesquisa aponta sustentabilidade com reciclagem e balanço de nutrientes em sistema de produção agropecuária
- • Coronavírus bovino (BCov) é diferente do vírus da Covid-19
- • Pescado é opção saborosa e econômica para preparar no Dia das Mães
- • APTA apoia a Marcha Virtual pela Ciência
- • Regulamentação de produtos alimentícios integrais é tema de consulta pública da Anvisa
- • Parceria entre Secretaria de Agricultura e Abastecimento e Secretaria da Segurança Pública permite a criação de cavalos e incrementa as atividades de policiamento em São Paulo
- • Secretaria de Agricultura apresenta sucesso das pesquisas com algas marinhas
- • Desenvolvimento de vacina para uso humano e veterinário possuem características similares
- • Métodos de processamento de alimentos permitem maior conservação e disponibilidade durante o ano todo
- ► Abril (28)
- • Aprenda a reaproveitar sementes e raízes para plantar horta em casa
- • Conheça as espécies de pescado mais cultivadas e capturadas em SP
- • Produtores e indústria de borracha natural têm novo índice de preços de importação
- • China se mantém como principal parceira comercial do Agro Paulista
- • Truta salmonada: estimulo à pesquisa, ao mercado e à gastronomia
- • Aprenda a produzir frutas em apartamentos
- • Secretaria de Agricultura mostra impactos da pandemia em dez produtos agropecuários paulista
- • Agronegócio se mobiliza na luta contra o novo coronavírus
- • Instrução Normativa do MAPA beneficia atividades de Aquariofilia
- • Dia da Terra: Secretaria de Agricultura e Abastecimento incentiva consumo consciente aliado à produção sustentável
- • Secretaria de Agricultura e Abastecimento de SP esclarece dúvidas sobre qualidade e bom preparo do café
- • Laboratório da Secretaria de Agricultura passa a adotar técnica mais precisa e moderna para diagnóstico de mormo
- • Secretaria de Agricultura dobra a produção de diagnóstico de brucelose e tuberculose em bovinos no primeiro trimestre de 2020
- • Dia Nacional da Conservação do Solo: Secretaria de Agricultura e Abastecimento desenvolve trabalhos voltados à proteção desse precioso recurso
- • Produtores devem redobrar cuidados para a colheita do café
- • Programa de Pós-graduação do ITAL, da Secretaria de Agricultura, realiza sua primeira defesa totalmente on line
- • Laboratório de pesquisa do Governo Paulista tem novo método de identificação de fraude de leite bovino em derivados e leite de búfalas
- • Secretaria de Agricultura apresenta novos projetos do Instituto de Pesca
- • Páscoa: qualidade do chocolate exige cuidados da produção ao consumo
- • Coronavírus que atingem aves são diferentes da Covid-19 e não são transmitidos para os humanos
- • Secretaria de Agricultura dá dicas de pescado e receita para a Páscoa
- • Plantas também ficam em quarentena: isolamento é necessário para que não haja entrada de patógenos exóticos no Brasil
- • Número de publicações científicas aumenta durante a pandemia
- • Secretaria de Agricultura disponibiliza e-book com dicas de como montar aquário com garrafa pet
- • Cogumelos são gostosos e saudáveis: conheça livro da Secretaria de Agricultura e prepare pratos nutritivos
- • Secretaria de Agricultura dá dicas de como evitar a presença de pragas em alimentos secos armazenados em casa
- • Laboratório da Secretaria de Agricultura de São Paulo fará testes para a Covid-19
- • Pescadores e aquicultores poderão receber auxílio federal
- ► Março (32)
- • Cartilha do Museu do Instituto de Pesca ajuda a distrair as crianças durante isolamento
- • Maior produtor de laranja e exportador de suco de laranja do mundo, SP deve manter setor ativo para atender demanda pela fruta rica em vitamina C
- • Elos da cadeia produtiva de cogumelos executam ações coordenadas para evitar perda da produção e mercado
- • Comer em casa: Instituto de Pesca dá dica de receita para fazer durante a quarentena
- • Secretaria de Agricultura e Abastecimento monitora e apoia cadeia do pescado em tempos de Covid-19
- • Pesquisas continuam firme no Instituto da Secretaria de Agricultura com nascimento de 12 bezerros
- • Secretaria de Agricultura e Abastecimento esclarece que coronavírus que acomete suínos é diferente do Covid-19
- • Secretaria de Agricultura faz adequações para manter atividades do Instituto Agronômico na quarentena
- • Programa de Monitoramento da Atividade Pesqueira Marinha no Estado de São Paulo é temporariamente suspenso
- • Secretaria de Agricultura e Abastecimento toma medidas de prevenção e mantém desenvolvimento de pesquisas e prestação de serviços para o setor de produção
- • Secretaria de Agricultura e Abastecimento de SP esclarece que pescado não tem relação com Coronavirus
- • IB esclarece: Não há registro de Luiz Augusto Vassoler como servidor do Instituto, mas sim como estagiário
- • Dia Mundial da Água: Secretaria de Agricultura mantém Centro de pesquisa voltado aos recursos hídricos
- • Secretaria de Agricultura e Abastecimento de São Paulo destaca ações no Dia Mundial da Agricultura
- • Dia Nacional da Aquicultura: atividade gera desenvolvimento econômico e alimentos de qualidade
- • Ital oferece bolsas de pós-doutorado em microbiologia e biologia molecular e em aproveitamento de subprodutos da indústria de frutas e hortaliças
- • Secretaria de Agricultura e Abastecimento recebe jornalistas e influencers do agro de 11 Estados brasileiros
- • Eventos são suspensos por tempo indeterminado
- • Museus e bibliotecas da Secretaria de Agricultura são fechados por 30 dias
- • Secretaria de Agricultura e Abastecimento cria comitê para monitorar o Covid-19
- • Secretaria de Agricultura e Abastecimento cria comitê para monitorar o Covid-19
- • Secretaria de Agricultura e Abastecimento cria comitê para monitorar o Covid-19
- • Secretaria de Agricultura e Abastecimento cria comitê para monitorar o Covid-19 e garantir a continuidade dos serviços essenciais (4)
- • Profissionais e pesquisadores participam da 36º Reunião Anual do Ensaio de Proficiência IAC
- • Tecnologias paulistas podem contribuir para desenvolver a cadeia de produção de macadâmia
- • Secretaria de Agricultura em parceria com "BrasilcomZ" abre inscrição para 1ª Prova de Eficiência e Performance Boi com Bula® para obter Super Touros
- • Instituto de Pesca sediará em São José do Rio Preto a Aquishow, maior feira de aquicultura da América Latina
- • Defeso do camarão: Instituto de Pesca é presença importante na reunião com pescadores
- • Competência feminina impacta desenvolvimento científico e o agronegócio
- • Bagres resgatados no Aeroclube de São Paulo estão em exposição no Aquário do Instituto de Pesca
- • Museu do Instituto de Pesca sedia exposição do Navio de Pesquisa ORION
- • Presidente da Embrapa ministrará aula magna na Pós-Graduação do Instituto Biológico
- ► Fevereiro (13)
- • Período de defeso para a bacia do rio Paraná termina em 28 de fevereiro
- • Instituto de Pesca melhora a qualidade da água dos lagos do Parque da Água Branca
- • Secretaria de Agricultura e Abastecimento transfere técnicas de manejo para o cultivo de figo e goiaba
- • Desempenho de cultivares de soja e de milho para as condições da Alta Paulista será apresentado em evento da Secretaria
- • Secretaria de Agricultura e Abastecimento de SP é pioneira em pesquisas com produção de moluscos marinhos no Brasil
- • Produção de leite de búfalas é difundida por pesquisadores da SAA na Caravana Família Nação Agro
- • Balanço IZ: compromisso com a sustentabilidade e a inovação na Produção Animal
- • Instituto de Pesca, da Secretaria de Agricultura, resgata e cuida de bagres encontrados na capital após enchentes
- • Secretaria de Agricultura divulga edital para vaga de professor na Pós-graduação do Instituto de Zootecnia
- • Mulheres ocupam mais de 50% dos cargos de pesquisadores científicos na Secretaria de Agricultura de São Paulo
- • Produção de amendoim será discutida em Pindorama, em evento realizado pela Secretaria de Agricultura de São Paulo
- • Pesquisa da Secretaria de Agricultura revela que o uso de vegetais como adubo verde é uma ótima opção para cultivo de tomate orgânico
- • Aquário do Instituto de Pesca apresenta nomes das rãs-touro escolhidos pelos visitantes em concurso
- ► Janeiro (23)
- • Conheça a importância de se alimentar com pescado
- • Secretaria de Agricultura coordena pesquisa que busca fomentar a conexão de fragmentos da Mata Atlântica no Vale do Paraíba
- • Secretaria de Agricultura habilitará profissionais na emissão de documentos para comércio de produtos agrícolas
- • Metodologia IZ para identificar alelo A1 em leite A2 é publicada em revista internacional
- • Agronegócio: China foi o principal destino das exportações paulistas em 2019
- • Secretaria de Agricultura realiza, no Vale do Paraíba, treinamento sobre controle biológico de brocas da bananeira
- • Secretaria de Agricultura reúne 150 produtores, técnicos e estudantes para discutir produção de amendoim no Oeste paulista
- • Aniversário de São Paulo: Cafezal urbano e zoológico de insetos fazem parte das atrações da cidade
- • Calendário de eventos 2020 do Ital prevê 44 atividades
- • Novos equipamentos, bolsas, infraestrutura e iniciativas modernizam Ital
- • Secretaria de Agricultura realiza evento para discutir genética e tecnologia do amendoim para o Oeste paulista
- • Parceria IZ e CRV Lagoa capacitou 80 pessoas em inseminação artificial de bovinos
- • Coopershow: APTA apresenta tecnologias para produção de milho safrinha, soja, mandioca e uva a produtores rurais
- • IAC, da Secretaria de Agricultura de SP, orienta sobre os benefícios da irrigação na cana-de-açúcar
- • Governo do Estado de SP anuncia edital de parceria em inovação tecnológica e pesquisa com bezerros leiteiros
- • Nome de Victória Rossetti é usado para batizar novo porta-enxerto de citros da Embrapa
- • Conheça os legumes com preço mais em conta em janeiro
- • Público poderá escolher o nome de cinco rãs-touro do Aquário do Instituto de Pesca
- • Pesquisa inédita do IAC, da Secretaria de Agricultura de SP, usa imagens aéreas para estimar erosão do solo em lavouras
- • É tempo de se planejar e ganhar dinheiro na pecuária
- • Conheça algumas dicas e evite a ocorrência de pragas urbanas durante o verão
- • Pesquisa da Secretaria de Agricultura e Abastecimento de São Paulo é premiada em Congresso realizado em Maceió
- • Ital oferece bolsa de pós-doutorado em Processos Térmicos de Alimentos
- ► Dezembro (26)
- ► 2019 (266)
- ► Dezembro (18)
- • Recorde na liberação de doses marca uma nova fase na produção de imunobiológicos do IB
- • IB recebe grupo de indianos interessados em conhecer seus trabalhos em diagnósticos na área animal
- • Rãs-touro: conheça os pets do Aquário do Instituto de Pesca
- • Diretor do IAC é eleito membro titular da Academia Brasileira de Ciências
- • Agro paulista dá sabor e nutrientes às festas de fim de ano
- • Pesquisa IZ em bem-estar animal na produção de bovinos é premiada em conferência internacional
- • Instituto de Pesca recebe alunos do curso internacional sobre planejamento espacial marinho
- • Novos investimentos devem triplicar produção de antígenos usados no diagnóstico de brucelose e tuberculose em animais
- • Maior cafezal urbano do País recebe visitantes
- • Livro que conta com pesquisadores da Secretaria de Agricultura de São Paulo fica na terceira colocação no Prêmio ABEU 2019
- • Aquário do Instituto de Pesca está mais iluminado neste Natal
- • O Papai Noel pode trazer presentes, mas foi a ciência quem trouxe as frutas natalinas para os vários meses do ano
- • Secretaria de Agricultura promove Workshop sobre a macadâmia e reúne produtores de vários estados brasileiros
- • “Pra onde tenha sol, é pra lá que eu vou”
- • Governo de SP firma parceria inédita com o Google para mapear digitalmente propriedades e estradas rurais do Estado
- • Secretaria de Agricultura e Abastecimento realizará workshop para impulsionar a produção paulista de macadâmia
- • Produtores franceses visitam a sede do Instituto Biológico
- • Representantes de instituições que promovem o pensamento científico visitam o Instituto Biológico, da Secretaria de Agricultura
- ► Novembro (21)
- • Secretaria de Agricultura realiza evento técnico sobre controle de escorpiões
- • Secretaria de Agricultura desenvolve pesquisa para disponibilizar alimentos seguros em restaurante popular de Bauru
- • Sustentabilidade em produtos de panificação, confeitos e chocolates é foco de evento inédito do ITAL, da Secretaria de Agricultura de SP
- • Experiência na gestão e governança no Museu de Pesca será apresentada durante Encontro Paulista de Museus Itinerante
- • IAC participa do II Encontro Técnico de Viticultura e Enologia
- • Secretaria de Agricultura disponibiliza publicação do IZ sobre toxicologia, resíduos e alternativas no controle de carrapatos
- • Pesquisas IZ com búfalos tornam a Secretaria de Agricultura referência internacional
- • Delegação chinesa conhece infraestrutura e serviços de instituto de pesquisa da Secretaria de Agricultura
- • Pesquisador da Secretaria de Agricultura recebe Prêmio Excelência ASBRAM por suas contribuições à cadeia de gado de corte
- • Empresa indiana busca na Secretaria de Agricultura conhecimento em transferência de embriões de búfalas
- • Centro de Cana do IAC recebe o Prêmio LIDE Agronegócios 2019
- • Pesquisadora da Secretaria de Agricultura e Abastecimento integra júri do Prêmio Grandes Cases de Embalagem
- • Secretaria de Agricultura e Abastecimento desenvolve produto natural à base de óleos essenciais para auxiliar no combate a carrapatos em bovinos
- • Secretaria de Agricultura oferece curso à distância sobre criação de camarões pitu
- • Secretaria de Agricultura e Abastecimento quer ampliar produção paulista de leite A2
- • Instituto de Economia Agrícola comemora 77 anos de fundação
- • IEA discute a relevância das informações econômicas para o desenvolvimento do Agro
- • Defeso da piracema já começou no Estado de São Paulo
- • Instituto Agronômico alerta mercado de produtos agrícolas
- • Projeto da Secretaria de Agricultura combate pesca fantasma e reinsere o resíduo na cadeia produtiva
- • Workshop Qualidade da Carne IZ está com inscrições abertas
- ► Outubro (28)
- • Secretaria de Agricultura expõe tecnologias transformadoras no InovaCampinas Trade Show
- • Pesquisadores da Secretaria de Agricultura debatem o futuro da alimentação durante ‘Mesa São Paulo’
- • Ital, da Secretaria de Agricultura de SP, recebe estudantes na Semana Municipal de Ciência, Tecnologia e Inovação
- • Pesquisadoras da Secretaria de Agricultura são homenageadas pelo Dia do Médico Veterinário na Câmara Municipal de São Paulo
- • Pesquisa paulista marca presença no lançamento do programa Vale do Futuro
- • Semana Parasitológica do IZ debaterá o controle seletivo de carrapatos e vermes em bovinos e ovinos
- • Pesquisadores e alunos do IZ são treinados para utilizar equipamentos importantes para os Sistemas Integrados de Produção Agropecuária da SAA
- • Semana de C&T: Quem sabe o que é rizóbio põe o dedo aqui!
- • Curso da Secretaria de Agricultura ensina a produzir cosméticos naturais em casa
- • Secretaria de Agricultura abre portas de seus Institutos durante Semana Nacional de Ciência e Tecnologia
- • IAC registra oito cultivares de plantas em 2018
- • Secretaria de Agricultura comemora Dia do Ovo com degustação de variadas receitas e palestras no IZ
- • Ações da Secretaria de Agricultura e Abastecimento garantem novas tecnologias, sanidade e qualidade na atividade pecuária
- • Alcachofra e vinho são destaques na Expo São Roque
- • Pesquisadora da Secretaria de Agricultura e Abastecimento é nova representante da área de Ciências Agrárias no SciELO Brasil
- • Preços Agropecuários acumulam alta de 0,43% em setembro
- • Secretaria de Agricultura, USP e Unesp assinam protocolo de intenções para desenvolvimento de projetos em conjunto
- • Criadores de ovinos receberão treinamento em controle de verminoses, principal problema sanitário da atividade
- • No Dia das Crianças será possível experimentar pratos preparados com insetos em São Paulo
- • Cadeia produtiva de aves e ovos traça estratégias de inovação com profissionais da Secretaria de Agricultura e Abastecimento
- • Secretaria de Agricultura dá dicas para consumidores evitarem a compra de azeites fraudados
- • Mestrado em Ciência e Tecnologia de Alimentos do Ital está com inscrições abertas
- • Secretaria de Agricultura ensinará produtores do Litoral Norte a prepararem receitas apenas com alimentos orgânicos
- • Secretaria de Agricultura e Abastecimento abre inscrições para Mestrado IZ 2020
- • Dia Nacional da Abelha: Secretaria de Agricultura e Abastecimento realiza ações de apoio à apicultura e meliponicultura
- • Congresso ibero-americano inédito discute potencialidade de peptídeos bioativos em alimentos funcionais
- • Pesquisas da SAA disponibilizarão tecnologia IZ com menor impacto ambiental para produção de suínos
- • Prêmio Abre da Embalagem Brasileira contou com pesquisadores da Secretaria de Agricultura e Abastecimento no Conselho de Jurados
- ► Setembro (16)
- • Secretaria de Agricultura e Abastecimento oferece duas bolsas de pós-doutorado em Ciência e Tecnologia de Alimentos
- • Museu de Pesca estimula interação e aprendizado com o uso de tecnologia QR CODE
- • Preços Agropecuários registram alta pela quarta semana seguida
- • Agro é fundamental para equilibrar a Balança Comercial Paulista
- • Workshops das cadeias de produção do agronegócio da SAA visam à inovação do setor produtivo
- • Secretaria de Agricultura sedia, no Instituto Biológico, o Festival Verdejando
- • Secretaria de Agricultura e Abastecimento usa a ciência no combate à febre maculosa, doença transmitida pelo carrapato-estrela
- • Secretaria de Agricultura e Abastecimento venderá 28 animais ovinos do IZ
- • Cultivo de macroalga é alternativa de renda para pescadores artesanais do litoral norte de São Paulo, revela pesquisa da Secretaria de Agricultura
- • Secretaria de Agricultura debate inovação e desenvolvimento regional na Expo Prudente 2019
- • Cepas para controle biológico selecionadas pela Secretaria de Agricultura são usadas por 90% das empresas brasileiras
- • Secretaria de Agricultura lança Sumários de Touros e Matrizes Guzerá e Touros Caracu
- • Público da ExpoVerde 2019 poderá conhecer único zoológico de insetos do Brasil
- • Secretaria de Agricultura realiza debate e aula-show sobre Peixes Não Convencionais na Semana do Pescado
- • Estado de São Paulo é o maior produtor de cogumelos do País, importante alternativa de geração de renda aos agricultores
- • Dia do Biólogo: Profissional pesquisa soluções ao produtor com menor impacto ao meio ambiente
- ► Agosto (28)
- • Secretaria de Agricultura promove curso de segurança alimentar e qualidade do pescado, em Santos
- • Dia da Avicultura: Secretaria de Agricultura e Abastecimento garante a sanidade das aves
- • Secretaria de Agricultura e UNICAMP patenteiam o resultado de pesquisa de óleo essencial que combate cáries
- • Institutos de pesquisa da Secretaria de Agricultura e Abastecimento analisam suas atividades em 18 cadeias de produção agropecuária
- • Café melhora performance e ajuda a equilibrar o saldo da Balança Comercial Paulista
- • IAC estuda nova variedade de laranja "vermelha precoce"
- • Secretaria de Agricultura recebe comitiva Internacional para conhecer pesquisas dos sistemas integrados de produção agropecuária do IZ
- • Preços agropecuários iniciam agosto em queda
- • Secretaria de Agricultura e Abastecimento realizará curso para ensinar a produzir cachaça de alambique de qualidade
- • Secretaria de Agricultura coordena estudo inédito para verificar a viabilidade de dispositivo obrigatório na pesca de camarão
- • Seminário “Ecossistema de Startups Inovadores do Agronegócio” é realizado no IAC de 22 a 23 de agosto
- • Secretaria de Agricultura lançará “Sumário de Touros e Matrizes Nelore IZ” na ExpoGenética 2019
- • Secretaria de Agricultura realiza em Colina leilão para venda de 17 cavalos e jumentos
- • Secretaria de Agricultura realiza venda de PANC em Pindamonhangaba
- • Secretaria de Agricultura debate "clean label" e rotulagem na 23ª Food Ingredients South America
- • Granja Bandeirantes visita laboratório de análises de qualidade de ovos da Secretaria de Agricultura e Abastecimento
- • Secretaria de Agricultura realizará dia de campo no IZ sobre alimentação de ovinos na seca
- • Estudantes de iniciação científica são premiados em Seminário do Instituto de Pesca
- • Alunos de Pós Graduação do Instituto de Pesca participam de Aula Magna sobre a importância do cientista para a sociedade
- • 16 bolsistas dos Institutos de Pesquisa da SAA são premiados no 13º Congresso Interinstitucional de Iniciação Científica
- • 13ª edição do Congresso Interinstitucional de Iniciação Científica premia seis bolsistas IAC
- • Secretaria de Agricultura fará treinamento em sanidade do café para produtores de Franca
- • Estudantes apresentam trabalhos científicos em Seminário no Instituto de Pesca, da Secretaria de Agricultura e Abastecimento
- • Ciclo de Seminários IEA discute a produção de hortaliças nas últimas três décadas
- • Prêmio Norman Borlaug de Sustentabilidade 2019 vai para pesquisador do Instituto Agronômico
- • Mito ou verdade? Secretaria de Agricultura esclarece dúvidas na produção de frutas
- • Exportações paulistas auxiliam a manter culinária tradicional da China
- • Secretaria de Agricultura alerta produtores sobre cuidados para possível geada no final de semana
- ► Julho (26)
- • Especialista da Secretaria de Agricultura e Abastecimento realiza palestra na TecnoCarne
- • Volta às aulas: período coincide com colheita de hortaliças que rendem refeições saudáveis
- • Curso da Secretaria em Campinas ensinará a fabricar balas de goma
- • Secretaria de Agricultura e Abastecimento disponibiliza 140 bovinos do IZ para venda
- • Bolsistas de instituições de pesquisa da RMC apresentarão trabalhos científicos na área da agropecuária no IAC
- • Como é o cotidiano de trabalho dos insetos no único jardim zoológico do tipo no Brasil
- • Assim como o Timão e o Pumba você também pode comer insetos
- • Besouro do filme O Rei Leão pode ser visitado em museu da Secretaria
- • Secretaria habilita sobre novos requisitos para exportação de citros à Comunidade Europeia
- • Secretaria de Agricultura e Abastecimento desenvolve pesquisas para amenizar preocupações dos produtores rurais
- • Secretaria de Agricultura e Abastecimento oferece bolsa de pós-doutorado na área de Biotecnologia
- • Bastos é disparado o principal produtor de ovos paulista: são 5 bilhões por ano
- • Secretaria de Agricultura promove, em Santos, curso de criação de camarão marinho utilizando sistema de bioflocos
- • IZ completa 114 anos em comemoração que lembra tradição centenária, aliada à modernidade de suas pesquisas
- • Secretaria de Agricultura e Abastecimento inaugura novo Laboratório de Forragicultura, nos 114 anos do Instituto de Zootecnia
- • IAC inaugura laboratórios de ponta para auferir qualidade de vestimentas e luvas protetivas agrícolas
- • Dia do Pecuarista: Secretaria de Agricultura e Abastecimento atua para fomentar o setor
- • Recém-lançado, AgroHub Campinas conta com parceria do Ital
- • Pesquisadores da Secretaria de Agricultura apresentam trabalhos sobre controle de parasitos em Congresso nos EUA
- • São Paulo é o maior produtor de flores do Brasil
- • Inscrições abertas para congresso de iniciação científica da Secretaria com foco em tecnologia no agro
- • Programa de Pós-Graduação do Ital oferece bolsa de pós-doutorado
- • Secretaria de Agricultura de São Paulo desenvolve sistemas de produção de alimentos com menor impacto ambiental
- • A cada real investido, pesquisas da Secretaria devolvem R$ 12,20 para a sociedade
- • Incentivo do Governo para parcerias abre as portas para novas iniciativas
- • Secretaria de Agricultura pesquisa óleos essenciais e hidrolatos para serem usados na produção agropecuária, indústria e gastronomia
- ► Junho (24)
- • IAC completa 132 anos e celebra novas conquistas
- • IAC desenvolve método inédito para avaliar resíduos de agroquímicos em vestimentas do trabalhador rural
- • Parceria entre IAC e Natura resulta em perfumes inéditos no mundo
- • Sistema de Mudas Pré-Brotadas desenvolvido pelo IAC conquista marca registrada
- • Você sabia que é possível cultivar acerola, amora, goiaba, pitanga e jabuticaba até em apartamentos?
- • Mesmo em queda, saldo da balança comercial do agronegócio contribui para equilibrar as contas paulistas
- • Instituto Agronômico marca presença nas festas juninas com as suas cultivares
- • Secretaria promove encontro sobre saúde do rebanho leiteiro e produção de queijo artesanal
- • Preços Agropecuários apresentam queda pela 6ª semana consecutiva
- • Estado de São Paulo incentiva o desenvolvimento de projetos inovadores de pesquisa em nutrição e genômica animal
- • Pesquisa de novas tecnologias busca a redução de custos de produção do bicho-da-seda
- • Secretaria de Agricultura e Abastecimento recebe as apresentações das 20 equipes após treinamento de startups da Rede NIT-APTA
- • Previsão de Safra: condições climáticas afetam a produção de grãos e cana, laranja se recupera
- • Secretaria de Agricultura e Abastecimento promove seminário sobre plano agrícola e pecuário
- • Preços Agropecuários recuam 1,76% no fechamento do mês de maio
- • Secretaria de Agricultura desenvolve pão de queijo sem ovo e com menor potencial alergênico
- • Pesquisa para desenvolver batata-doce mais produtiva é apresentada pela Secretaria de Agricultura e Abastecimento de São Paulo
- • Expansão da produção nacional de azeite é tema de encontro em São Paulo
- • Secretaria de Agricultura e Abastecimento de São Paulo participa do “Oscar da Gastronomia Brasileira” e expõe qualidade da pesquisa agrícola paulista
- • Secretaria de Agricultura e Abastecimento busca a integração da pesquisa agropecuária com a preservação ambiental
- • Secretaria de Agricultura media debate sobre sustentabilidade em feira internacional de tecnologia de alimentos
- • Secretaria de Agricultura cuida do planeta de forma sustentável
- • Começam nesta segunda, 3, a 41ª Semana de Citricultura, a 45ª Expocitros e o 50º Dia do Citricultor
- • Secretaria de Agricultura e Abastecimento oferece Bolsa Jovem Pesquisador
- ► Maio (22)
- • Preços agrícolas mantém trajetória de queda
- • Dia Mundial do Meio Ambiente: Secretaria realiza palestra sobre a preservação das águas
- • Secretaria de Agricultura e Abastecimento amplia integração entre seus institutos para maior qualidade em seus laboratórios
- • Tecnologias e inovação em sorvetes serão abordadas em painel mediado pelo Ital durante conferência internacional do setor
- • Conheça dez ações da Secretaria de Agricultura e Abastecimento do Estado para comemorar o Dia Nacional do Café
- • Secretaria abre as portas do maior cafezal urbano do mundo para a população vivenciar a colheita do café
- • Preços agropecuários caem 0,43% na primeira semana de maio
- • Pesquisas da Secretaria de Agricultura se destacam no Prêmio Inovação Aquícola
- • Ciclo de Seminários IEA aborda as políticas públicas de crédito do Feap/Banagro
- • Preços Agropecuários recuam em abril com a entrada do outono
- • Agronegócio: União Europeia volta a ser o principal destino das vendas externas paulistas
- • VPA do Estado de São Paulo em 2018 tem crescimento em soja, café e milho
- • Novo aparelho orienta atividade de pulverização por meio de comandos de voz, fotos e vídeos
- • Olímpia inaugura biofábrica de fungos entomopatogênicos com assessoria do Instituto Biológico
- • Secretaria de Agricultura e Abastecimento estuda uso de madeira de seringais na produção de biomassa
- • Agricultura urbana é tema de workshop no IAC
- • Secretaria de Agricultura e Abastecimento de São Paulo debate os desafios da comercialização da carne na Agrishow 2019
- • Ital marca presença na Apas Show 2019 com palestra para autoridades e representantes do setor
- • Tradicional na Agrishow, cerimônia Deusa Ceres homenageia engenheiros agrônomos paulistas
- • Agrishow 2019: Público do estande da Secretaria de Agricultura aprova café robusta paulista
- • Agrishow 2019: confira oito tecnologias da APTA para melhorar renda do produtor rural
- • Agronegócio: saldo da balança comercial paulista fecha primeiro trimestre de 2019 em US$ 1,95 bilhão
- ► Abril (31)
- • Agrishow: Secretaria de Agricultura divulga os resultados do LUPA, o censo agro paulista
- • Agrishow: Pesquisadora do IAC será homenageada com a medalha “Fernando Costa”
- • Agrishow: Pesquisa, tecnologia, inovação e extensão rural em café são destaques da Secretaria de Agricultura
- • IAC expõe cultivares de café na Agrishow
- • Centro do IAC em Jundiaí faz 50 anos na posição de referência mundial em estudos sobre aplicações de defensivos agrícolas
- • Instituto Agronômico expõe na Agrishow modernas variedades de cana
- • IAC e Trimble firmam termo de cooperação técnica
- • IAC lança novo híbrido de milho para canjica e ração
- • Comandos de voz, fotos e vídeos orientam na lavoura ao trabalhador aplicador de defensivos agrícolas
- • Agrishow 2019: APTA estuda novas matérias primas para técnica chinesa de cultivo de cogumelos
- • Agrishow 2019: Centro do IAC referência mundial sobre defensivos agrícolas apresentará seus projetos
- • Dia do Boi: Ações da Secretaria focam na qualidade e sanidade da carne
- • Agrishow 2019: APTA apresentará pesquisas para produção de café robusta em São Paulo
- • IAC apresenta sua primeira cultivar de amendoim para o mercado de orgânicos
- • Ital abordará qualidade da bebida de café na Agrishow
- • Agrishow 2019: IAC lança a 50ª cultivar do feijão Carioca
- • Dia da Terra: Secretaria conserva biodiversidade, fomentando projetos sustentáveis
- • Agrishow 2019: Produção de café sem nematoides será abordada pelo Instituto Biológico na Feira
- • Instituto de Tecnologia de Alimentos oferece duas oportunidades para doutores com experiência em pesquisa
- • Programa de Treinamento de Startups da Rede NIT-APTA/SAA busca transformar tecnologias promissoras em novos negócios
- • Agrishow 2019: APTA ensinará técnica que viabiliza produção de maracujá em áreas contaminadas com a morte prematura
- • IZ treina produtores de cordeiros para agregar valor a carne e melhorar a produção
- • IZ transfere tecnologia com aula prática para alunos da Unesp
- • Agrishow 2019: Secretaria apresentará tecnologia que usa a natureza para produzir alimentos sem defensivos agrícolas
- • Dia Nacional da Conservação do Solo: Secretaria analisa, fiscaliza e preserva o solo paulista
- • Preços Agropecuários mantêm trajetória de alta, aponta IEA
- • Secretário de Agricultura visita IB, em Campinas, e conhece pesquisas relacionadas à sanidade vegetal
- • APTA disponibiliza tecnologias e transfere conhecimentos para evitar gosto de barro em pescado
- • Instituto de Pesca completa 50 anos de olho no futuro
- • Habilitação de engenheiros agrônomos para atuarem com certificação fitossanitária é tema de curso no Instituto Biológico, em Campinas
- • Seguindo uma demanda mundial, São Paulo anuncia parceria para desenvolver projetos de canudos biodegradáveis e novos tipos de leites
- ► Março (11)
- • Pesquisa no IAC avaliou adubação nitrogenada em plantas jovens de cafeeiro
- • Secretaria habilitará profissionais para emissão de certificado que garante comercialização agrícola
- • Para Ital, embalagem e engenharia de alimentos, aliadas a políticas públicas e educação, são fundamentais na redução do desperdício
- • Secretaria de Agricultura promove encontro sobre Estatísticas Agropecuárias
- • 22 de março - Secretaria de Agricultura e Abastecimento celebra o Dia Mundial da Água com projetos em prol da agricultura paulista sustentável
- • IEA divulga a estimativa da Produção Animal do Estado de São Paulo, em 2018
- • Dia do Mel - 17 de março: Secretaria de Agricultura e Abastecimento comemora a data e incentiva a produção
- • Dia do Consumidor: Secretaria de Agricultura e Abastecimento oferece serviços e tecnologias para melhorar a vida do cidadão
- • IAC realiza Seminário de Turismo Gastronômico em Capão Bonito
- • IP abre processo seletivo para mestrado em aquicultura e pesca entre os dias 18 e 22 de março
- • Museu do IP celebra o Dia da Mulher com exposição temática
- ► Fevereiro (22)
- • A mobilização do setor alimentício na promoção do consumo responsável será tema de seminário gratuito coordenado pelo Instituto de Tecnologia de Alimentos
- • IZ recebe a visita de pesquisadores dos EUA
- • Cotação do Feijão dispara no Mercado Atacadista de São Paulo, aponta levantamento do IEA
- • Prazo para submissão de trabalhos na XIII Recip é prorrogado até 1º de março
- • IEA tem nova diretora
- • Gestão eficiente é a chave para melhorar rentabilidade com a cultura da Seringueira, afirma IEA
- • IB aponta ocorrência de neosporose e toxoplasmose em bovinos de leite de pequenas propriedades de Araçatuba
- • Pós-graduação do Instituto Biológico inicia turma 2019 com Aula Magna sobre a Amazônia
- • Preços agropecuários caem 0,88% em janeiro, aponta IEA
- • Instituto Agronômico e Instituto Biológico alertam sobre alta incidência da ferrugem no café
- • IP adquire equipamento que permitirá novas análises de água
- • Pesquisadora da APTA dá dicas para quem quer fazer um jardim de PANC em casa
- • Previsão de Safra: Produção de grãos deve superar sete milhões de toneladas, volume ligeiramente superior a 2018, aponta IEA
- • IAC transfere conhecimento em plantio do amendoim em palhada da cana
- • Pesquisador do IB ensina o que fazer para se livrar dos ratos e quais cuidados tomar
- • Laboratórios do Brasil e do exterior se reúnem no IAC nesta terça, 12
- • Instituto de Zootecnia tem nova diretoria geral
- • Nova tecnologia de produção de tilápias será apresentada pelo IP no VI Workshop de Piscicultura do Noroeste Paulista
- • Guia de Sanidade Vegetal é uma verdadeira enciclopédia grátis sobre pragas e doenças. Acesse!
- • Apostila grátis orienta sobre manejo para evitar prejuízos com as formigas-cortadeiras no campo e na cidade
- • Nematoides parasitos da alface são tema de apostila do Prosaf. Baixe grátis!
- • Pesquisa da APTA que avalia cultivares de soja em Itapetininga será apresentada durante Copla Soja
- ► Janeiro (19)
- • IAC lança quarta edição do Programa +Cana de transferência do sistema MPB
- • Atum deve ser congelado antes de ser consumido cru
- • APTA e cinco Institutos de pesquisa têm novos diretores
- • Eloísa Garcia é nomeada diretora geral do ITAL
- • IAC tem novo diretor-geral
- • Infestação de carunchos e traças nos alimentos em casa? Pesquisador do IB ensina a combater
- • IB habilita estudantes para preparação correta de lâminas histológicas para diagnóstico de doenças em animais
- • APTA apresenta tecnologias para melhorar produção e renda no campo durante a Coopershow
- • Agronegócio: Balança Comercial Paulista registra superávit de US$ 11,49 bilhões, aponta IEA
- • Mercado Atacadista: IEA explica as movimentações de preços em dezembro e do acumulado dos últimos 12 meses
- • Planeta Inseto destrói mitos e ensina verdade sobre o temido mosquito da dengue. Confira!
- • Projeto da APTA avalia cultivares de soja para interior paulista
- • Tecnologias da APTA são adotadas em todos os estados brasileiros
- • Preços agropecuários sobem 12,78% em 2018, informa IEA
- • Laboratório de Produção de Imunobiológicos do IB traça atuação para 2019 e promete facilitar a vida do pecuarista
- • Prosaf: Apostila grátis orienta sobre controle biológico no combate a pragas e doenças em folhosas
- • IB assina convênio com quatro universidades para receber estagiários em suas pesquisas
- • IAC abre inscrição para o curso Master Gestão em Fitossanidade
- • Primeiro app da Secretaria de Agricultura foi desenvolvido pelo IEA
- ► Dezembro (18)
- ► 2018 (227)
- ► Dezembro (32)
- • Pesquisadora da APTA é Destaque Rural Feminino em premiação no Rio Grande do Sul
- • Curso requisitado para exportar alimentos aos EUA ocorrerá em junho no ITAL
- • ITAL promoverá 54 eventos de capacitação e atualização em 2019
- • APTA aumenta em 16% quantidade de análises laboratoriais realizadas em 2018
- • Museu do Instituto Biológico reabre ampliando a conscientização ambiental para todas as idades
- • Mercado atacadista: IEA detecta aumento do preço das carnes em função das festas de fim de ano
- • Curso de shelf-life do ITAL tem duas edições em 2018
- • Agronegócio: Preços agropecuários sobem 0,11% em novembro
- • Agronegócio: Cana e café seguram o saldo da Balança Comercial Paulista
- • Assinatura de acordo permite avanço na criação de endereços na zona rural
- • Software desenvolvido pela APTA e pela Embrapa auxilia na implementação de boas práticas de manejo e na gestão ambiental da produção de tilápia
- • Pesquisador espanhol conhece trabalhos da APTA em conservação ambiental e recuperação de solo degradado
- • Livro traz informações inéditas sobre o relacionamento de pesquisadores com a imprensa
- • Pesquisador do IB dá dicas para prevenção e controle de escorpiões
- • IP inaugura Unidade de Beneficiamento de Pescado nesta terça-feira, 18 de dezembro
- • Prosaf encerra 2018 ensinando agricultores familiares sobre controle biológico com ácaros e fungos
- • Museu do IB reabre com sala dedicada a explicar o controle biológico
- • Secretaria de Agricultura, APTA e Fundepag assinam acordo para implantar Programa Cidadania no Campo
- • IAC bate novo recorde de levantamento de intenção de plantio de cana no Brasil
- • Censo nacional de variedades de cana realizado pelo IAC reforça redução da concentração varietal
- • Instituto de Pesca cria projeto “Capturas não Reportadas” de pescado
- • Aprovação de R$ 13,134 mi do PDIP e recertificação pela ISO 9001 marcam ano comemorativo dos 55 anos do ITAL
- • Pesquisadora do IAC recebe reconhecimento em congresso internacional
- • Instituto Biológico abre suas portas no dia 9 para música, dança e oficinas de sustentabilidade
- • Pesquisador do Instituto Biológico é homenageado por sua dedicação ao setor agropecuário
- • IZ disponibiliza 139 bovinos para venda
- • IP publica nova lista de espécies aquáticas alóctones, exóticas e de híbridos cultiváveis em São Paulo
- • Agricultores de Mogi das Cruzes serão treinados para utilizar controle biológico em sua produção
- • Pesquisador do IB colabora em livro sobre resistência de plantas a causadores de doenças
- • IEA divulga o resultado preliminar do VPA do Estado de São Paulo
- • Iniciação Científica revela talentos do agro em institutos ligados à APTA
- • 31ª Raib: Como o Brasil está se preparando para a erradicação da aftosa?
- ► Novembro (26)
- • Mercado Atacadista: arroz e feijão seguem direções opostas, aponta IEA
- • IAC realiza curso prático sobre extração de óleos essenciais
- • Adubação verde diminui o uso de defensivos agrícolas na cultura do milho
- • Cafezais paulistas aumentam sua produção em 29,6%, em 2018
- • ITAL ministra palestra no MAPA durante evento de capacitação sobre Requisitos para exportação de produtos cárneos
- • IAC transfere informações no Seminário sobre cultivo e processamento de pupunheira para palmito no Vale do Ribeira
- • Reunião capacita representantes dos Núcleos de Inovação Tecnológica da APTA na valoração das tecnologias produzidas a partir da pesquisa
- • IEA divulga a estimativa final das culturas de inverno e intenção de plantio para 2018/19
- • Regulamentação da produção de mudas de maracujá em São Paulo objetiva recuperar o cultivo da fruta no estado
- • Agronegócio: Saldo da Balança Comercial fecha em US$ 9,84 bilhões
- • Palestras no Instituto Biológico reforçam a importância das abelhas para a agricultura
- • Sistema do Boi 7.7.7 gera lucro para pecuária, segundo produtores rurais
- • Ital realiza 1º curso teórico e prático de qualidade e cortes cárneos bovinos para o varejo e churrasco
- • 14º Workshop em Bioeconomia estimula o empreendedorismo em economia sustentável no ITAL
- • IEA divulga os resultados preliminares do LUPA 2016/17
- • Instituto Biológico reúne representantes da indústria de defensivos para reforçar adesão ao Gedave
- • Preço do tomate dispara e pressiona o orçamento das famílias
- • Pesquisador do IAC é homenageado pela principal instituição do setor de heveicultura
- • IEA completa 76 anos equilibrando memória e inovação
- • IB comemora 91 anos com aumento da produtividade em pesquisa
- • APTA apresenta ingredientes paulistas para a alta gastronomia durante Mesa São Paulo
- • IP e Yatch Club de Ilhabela promovem marcação científica de peixes-de-bico
- • Pesquisador do IP recebe homenagem da Câmara de Vereadores de Bragança Paulista
- • ITAL prorroga até 9 de novembro as inscrições para o curso de mestrado em Ciência e Tecnologia de Alimentos
- • Fabricação de chocolates é tema de curso teórico e prático do ITAL
- • IB comemora seus 91 anos e lança relatório com dados sobre atividades no período de 2016 e 2017
- ► Outubro (41)
- • ITAL sedia workshop colaborativo gratuito sobre novas oportunidades de negócio em bioeconomia
- • Passo a passo para obter o Boi 7.7.7. será tema de painel da InterCorte SP
- • Vinho: APTA organiza congresso para discutir questões-chaves na produção
- • Uso de controle biológico cresce e IB auxilia empresas a produzir organismos usados no combate de pragas e doenças
- • Planeta Inseto chega à marca de 200 mil visitantes com nova atração
- • Pesquisadores do IB ministram palestras durante o XXVII Congresso Brasileiro de Entomologia, em Gramado
- • Pesquisa do IZ em bem-estar animal é certificado entre os melhores trabalhos no Workshop Temple Grandin no Brasil
- • Lançamento da Unidade de Referência Tecnológica do IZ reuniu empreendedores para promover tecnologias em um sistema sustentável de produção agropecuária
- • IZ realizará leilão de reprodutores, matrizes e embriões bovinos
- • IZ inícia a avaliação de 265 animais na 68ª Prova de Ganho de Peso de 2018
- • Simpósio da APTA aborda propagação de plantas e ressalta importância da pesquisa agrícola
- • Instituto de Pesca abre processo seletivo para bolsa de pós-doutorado
- • ITAL coordena Plenária de Abertura do Fórum Fispal Tecnologia 2018
- • Pesquisador do IAC recebe o Prêmio MasterCana Centro-Sul 2018
- • II Beverage Innovation Summit discute sobre desmistificações e tendências
- • IB desenvolve banco de dados online sobre mosca-das-frutas em São Paulo
- • Aproveitamento do resíduo de pescado será tema de minicurso no VIII SIMCOPE
- • Curso inédito capacita profissionais a adequarem produtos para exportação dentro da nova lei americana
- • IB realizará 50ª edição de curso de habilitação para emissão de certificados de sanidade vegetal
- • IEA divulga análise da variação de preços no Mercado Atacadista da Região Metropolitana de São Paulo
- • Congresso Interinstitucional de Iniciação Científica vai premiar inovação na área agrícola
- • IB bate novo recorde na produção de imunobiológicos, usados no diagnóstico de tuberculose em animais
- • IB realiza dois minicursos para reconhecimento de famílias de himenópteros parasitoides
- • IAC abre inscrições até 27 de agosto para o II Concurso Cachaça com Ciência
- • Agronegócio: saldo da Balança Comercial fecha em US$ 7,02 bi
- • APTA realiza encontro sobre tecnologia de cultivo de panga e lambari
- • Embalagem a vácuo e armazenamento sob refrigeração garantem o dobro da vida útil da jabuticaba Sabará
- • Centro de Citricultura do IAC é tema de exposição em Cordeirópolis
- • Estão abertas inscrições de resumos de trabalhos científicos para apresentação na 31ª Reunião Anual do Instituto Biológico
- • 8º Simpósio de Controle de Qualidade do Pescado tem início na próxima terça-feira, 9 de outubro
- • APTA apresenta conceito do Boi 7.7.7 durante BeefDay
- • IEA divulga o ranking do VPA Regional de 2017
- • Manejo integrado de pragas será tema abordado pelo IB durante EsalqShow
- • APTA realizará evento para debater aquicultura da criação à mesa
- • APTA realizará III Dia de Campo de Fruticultura em Sandovalina
- • Pesquisa da APTA que avalia o cultivo em conjunto de camarão e lambari é premiada em congresso
- • 12ºCongresso Interinstitucional de Iniciação Científica conta com 41 trabalhos do ITAL
- • Cenário eleitoral e safra recorde impactam o Mercado Futuro do Café
- • APTA apresenta soluções tecnológicas para o agro paulista e brasileiro durante InovaCampinas
- • Instituto Biológico assinará acordo de cooperação técnica com prefeitura de Salto para controle do carrapato-estrela
- • Micotoxinas prejudicam o rendimento do gado de corte e são um inimigo oculto do produtor, segundo pesquisa da APTA
- ► Julho (10)
- • Institutos ligados à APTA oferecem bolsas de pesquisa
- • APTA e suas unidades de pesquisa arrecadam 862 peças na Campanha do Agasalho 2018
- • IEA avalia o Plano Agrícola e Pecuário 2018/19
- • Preços agropecuários fecham o mês de junho com alta de 1,54%
- • Revista científica editada pelo IAC alcança nível de citação máximo pela Journal Citation Reports
- • Milho também estará no centro dos debates na quarta do Global Agribusiness Forum
- • IEA divulga as Previsões e Estimativas das Safras Agrícolas do Estado
- • Publicação da CODEAGRO ajudará a ilustrar importância da alimentação saudável em ações do Museu do Instituto Biológico
- • Agricultores conseguem reduzir em até 90% aplicação de defensivos na produção de hortaliças
- • Agronegócio: Saldo da Balança Comercial Paulista fecha em R$ 4,91 bi
- ► Junho (30)
- • GAF 2018 vai discutir futuro da pecuária e avanços em genética com participação da ABCZ
- • V Treinamento Prático sobre Cachaça Artesanal será realizado no Centro de Cana do IAC
- • APTA treina 50 professores do Centro Paula Souza para processamento de frutas e produção de geleias
- • APTA publica sua política de inovação
- • IAC completa 131 anos com três novas patentes
- • APTA organizará Congresso Internacional de Vitivinicultura
- • Estudos desenvolvidos no IAC são premiados durante Conferência Europeia
- • Guia de visitação dos Museus da Baixada Santista é lançado no Museu de Pesca
- • IP é eleito organizador da XI Reunião da Sociedade Brasileira para Estudos de Elasmobrânquios
- • Ingredientes produzidos pela APTA são servidos em evento considerado o Oscar da gastronomia brasileira
- • Acontece no próximo mês a quarta edição do Global Agribusiness Forum
- • Instituto Biológico recebe tese de pesquisa que marcou a criação do instituto
- • APTA apoia PIPE-FAPESP para desenvolvimento de sistema inovador de criação de tilápias
- • APTA apresenta tecnologias e palestras durante VII Fórum Internacional de Plasticultura e Tecnologia Agrícola
- • Pesquisadores do IP apresentam resultados de pesquisa durante evento em Taiwan
- • Museu de Pesca recebe 657 visitantes durante a primeira semana da exposição “Oceanos Livres de Plásticos”
- • IB tem 292.350 doses de imunobiológico liberadas pelo MAPA
- • IAC recebe a primeira reunião entre produtores para criação de selo de origem da uva Niagara
- • IAC participa do 13º Dia de Campo da Tangerina
- • Governo do Estado nomeia 156 novos servidores para atuar na Secretaria de Agricultura
- • Estabelecimento e manutenção de linhas de seleção do IZ são fundamentais para trabalhos científicos com a raça Nelore
- • Copa do Mundo: APTA lista seus produtos campeões para consumir em dia de jogo
- • Presidente Prudente sedia evento para fomentar a cultura da batata-doce
- • Empregos formais no setor agropecuário paulista devem crescer no próximo trimestre, avalia IEA
- • Maior evento do agronegócio mundial será realizado em São Paulo no mês de julho
- • Pesquisa aponta 90 espécies de cogumelos nativas comestíveis em São Paulo
- • Como cultivar plantas aromáticas e extrair óleos essenciais
- • Dia Mundial do Meio Ambiente: APTA reforça seu compromisso com agricultura e agropecuária sustentável
- • IB é parceiro de empresa americana no teste de repelente natural para ocorrência de brocas em palmeiras
- • IAC dá início à 40º Semana da Citricultura nesta segunda, 4
- ► Maio (24)
- • Incêndio no bairro Alemoa, em Santos, em 2015: Instituto de Pesca emite relatório técnico a pedido do Ministério Público Federal
- • Colheita de café no Instituto Biológico abre a safra paulista
- • Pragas urbanas podem contaminar alimentos industrializados
- • APTA lança livro sobre Boi 7.7.7 durante a Confinar 2018
- • ITAL participa da Apas Show 2018
- • Pecuaristas do Acre e de Rondônia participam de treinamento da APTA no sistema do Boi 7.7.7
- • No Dia Nacional do Café, paulistanos poderão colher café no pé em um dos maiores cafezais urbano do País
- • Secretário Francisco Jardim destaca importância do setor de pescado na abertura da Aquishow 2018
- • Pesquisadora do IAC foi uma das finalistas da maior competição de divulgação científica mundial, o FameLab
- • APTA é uma das finalistas em evento internacional de inovação em saúde animal
- • Curso do IB habilita 50 engenheiros agrônomos na emissão de documento que permite exportação de limão tahiti
- • Instituto de Pesca levará informações técnicas para aquicultores durante a Aquishow Brasil
- • Pesquisador do IAC é eleito vice-presidente da Comissão de Meteorologia Agrícola da Organização Meteorológica Mundial
- • Pesquisadores desenvolvem método para diagnosticar nematoides em sementes de forrageiras em tempo real
- • Preços agropecuários sobem 0,5% em março
- • IEA divulga a estimativa final da Produção Animal de São Paulo em 2017
- • IZ disponibiliza 34 ovinos para venda
- • Global Agribusiness Forum 2018 apresenta “A Ciência do Campo a Serviço do Planeta: A Ação é Agora”
- • IZ realiza workshop para discutir a sustentabilidade da produção de leite em São Paulo
- • Canal Terraviva e APTA assinam acordo de colaboração técnica
- • IAC lança publicação voltada para o uso da cana além do açúcar e do etanol
- • Coordenador da APTA é homenageado durante cerimônia na Agrishow
- • IZ lança na Agrishow 2018 espaço Caminhos do Leite e inaugura Laboratório Móvel em Qualidade do Leite
- • Canal Terraviva e APTA assinam acordo de colaboração técnica
- ► Abril (21)
- • IAC lança cultivares de feijão e arroz na Agrishow, além de nova versão do Aplique Bem
- • Coordenador da APTA é escolhido como o “Homenageado Agrishow 2018”
- • Macroalga e probiótico para produção de tilápia são destaques do IP na Agrishow
- • APTA seleciona clones de café robusta para cultivo em São Paulo
- • IB treina agricultores na produção semi-intensiva de aves
- • Agrishow: Equipamento inédito permite produção de plantas aromáticas e medicinais dentro de casa
- • Pesquisadores do Instituto de Zootecnia e professora da FCAV/Unesp foram premiados no Congresso APA
- • 27ª edição do Prêmio Ernesto Illy faz homenagem ao diretor do IEA
- • ITAL sedia o curso "Summer School - Food Safety"
- • IAC realiza seminário sobre Conservação do Solo e Proteção de Recursos Naturais
- • APTA contribui com a formação profissional de alunos da Etec em Curso de Cozinha e Nutrição
- • Secretário Francisco Jardim visita o Centro Avançado de Pesquisa Tecnológica do Agronegócio Avícola, em Descalvado
- • IAC lança duas cultivares de arroz agulhinha e uma do tipo arbório
- • IZ disponibiliza novo número do Boletim de Indústria Animal
- • IZ disponibiliza 151 bovinos para venda
- • 1º Simpósio sobre os Avanços na Nutrição de Citros e Café será realizado pelo IAC
- • Empresas podem negociar licenciamento de tecnologias da APTA para indústria de alimentos e pecuária de corte
- • Cultivar Obatã Vermelho do IAC será usada em campeonato mundial de baristas
- • 150 produtores participam de treinamento do Prosaf em nematoides parasitos do café
- • Chamada da FAPESP contempla quatro Institutos da APTA com investimento total de R$ 49,765 milhões
- • IAC entregará quatro modernas variedades de cana na forma de Mudas Pré-Brotadas para canavicultores na região de Jaú
- ► Março (13)
- • Candidatos aprovados no concurso da Secretaria de Agricultura, atenção para as datas de escolha de vagas
- • IB integra pesquisa que identificou pela primeira vez no Brasil nematoide que ataca gramado de campo de golfe
- • Nasce em Campinas, no IAC, parte das sementes que vão às lavouras no Brasil
- • A cada real investido, APTA gerou R$ 12,20 para a sociedade
- • Corredor verde para polinizadores do IB é o local escolhido por São Paulo para a realização do 2º Plantio Global
- • Evento no IAC busca discutir formas de financiamento para as pesquisas com cana-de-açúcar no Brasil
- • IZ inaugura dois laboratórios em Sertãozinho, interior paulista
- • IZ realiza Workshop Pecuária de Sucesso, em Sertãozinho
- • 74 engenheiros agrônomos se sete Estados participam de cursos de habilitação para emissão de certificados de sanidade vegetal no IB
- • Pesquisadora do IEA discute a exportações de amendoim
- • Mulheres ocupam 52% do quadro de pesquisadores da APTA
- • Ferramenta para rastreamento de embalagens de defensivos agrícolas vence hackathon promovido no AgriFutura
- • IAC apresenta pesquisa sobre padrões de classificação automatizados na fruticultura durante o AgriFutura
- ► Fevereiro (16)
- • Instituto de Pesca recebe visita de comitiva colombiana
- • ITAL e IAC desenvolvem tecnologia inédita para obtenção de ingrediente fonte de cafeína, sem o uso de solventes
- • IZ disponibiliza novo número do Boletim de Indústria Animal
- • IZ realiza 6º Curso sobre Carcaça de Ovinos com foco em avaliação, cortes e defumados
- • Instituto de Zootecnia recebe artigos científicos para publicar no BIA
- • Produtores rurais recebem orientações sobre mastite, brucelose e tuberculose na primeira edição do Prosaf em 2018
- • Variedade de cana não tem influência direta na produção de cachaça, explica a pesquisadora da APTA
- • Instituto de Pesca inaugura laboratório em Ubatuba para intensificar pesquisa sobre peixes marinhos nativos
- • Livro da APTA orienta sobre cálculo do custo de produção de peixes em tanques-rede
- • Museu de Pesca e Aquário do IP receberam mais de 93 mil visitantes em 2017
- • Planeta Inseto inaugura nova atração em São Paulo: laboratório de ciências
- • Pesquisadores da APTA lançam manual para produção orgânica de goiaba
- • Pesquisadora do IB irá compor comitê para eleger melhores trabalhos para erradicação da BVD na Europa
- • Alunos da Esalq/USP visitam áreas de experimentos do IZ em pastagens e ovinocultura
- • Planeta Inseto recebe 27.645 visitantes em 2017
- • APTA realiza treinamentos para produção de açúcar mascavo, melado, rapadura e cachaça
- ► Janeiro (14)
- • IEA aponta queda dos empregos formais no Campo em 2016
- • ITAL participa do Prêmio EMBANEWS
- • Mercado Futuro de Café inicia 2018 em clima de expectativa
- • Publicações do IP e da Codeagro ensinam a escolher, armazenar e preparar adequadamente o pescado
- • Arnaldo Jardim visita a APTA em Tietê para conhecer trabalho de Integração Lavoura Pecuária
- • IAC amplia infraestrutura de armazenamento de dados de pesquisa e cria data center próprio
- • ITAL auxilia Tribunal de Contas do Município de São Paulo na avaliação de compras de alimentos para merenda escolar
- • Instituto Biológico lança 2ª edição do livro mais completo sobre doenças e pragas de plantas ornamentais do Brasil
- • APTA busca fomentar o plantio da palmeira macaúba no Vale do Paraíba
- • APTA aumenta em R$ 4,9 milhões captação de recursos externos em 2017
- • IB organiza treinamento para validação de métodos de acordo com norma internacional para análises laboratoriais
- • IB encerra comemorações dos 90 anos com evento para a população
- • APTA e CATI realizam 12º Seminário de Agregação de Valor em Horticultura
- • IEA 2018: foco na concretização dos novos projetos e modernização dos tradicionais produtos e serviços
- ► Dezembro (32)
- ► 2017 (272)
- ► Dezembro (17)
- • IB aumenta em 25% produção de antígeno para diagnóstico de tuberculose em bovinos
- • Prosaf treina mais de 800 agricultores familiares para aumentar a produtividade e garantir a sanidade na produção
- • Pesquisador do IP é agraciado com prêmio de destaque em inovação científica e tecnológica
- • O consumidor está preocupado com a saudabilidade dos alimentos, aponta ITAL durante evento em São Paulo
- • Pesquisador da APTA fomenta realização de campanha sobre cogumelos pela Rede Globo
- • Secretário e ex-diretor do Centro de Pesquisa de Descalvado são homenageados pela contribuição à Avicultura brasileira
- • Laboratório do IB passa por processo para se tornar referência para a virose Língua Azul pela OIE
- • Mercado Futuro do Café: diretor do IEA aponta clima de expectativa
- • Déficit da Balança Comercial Paulista cai 19,4% graças ao Agro
- • IB doará 214 quilos de café ao Fundo Social de Solidariedade do Estado de São Paulo
- • Pesquisadora do IEA analisa o Custo de Produção e a Rentabilidade da Cultura da Seringueira
- • Laboratórios do IB de sanidade avícola passam por melhorias
- • O planejamento do plantio é necessário para iniciar o cultivo de maracujá, recomenda APTA
- • IAC divulga dados do segundo censo nacional de variedades de cana-de-açúcar
- • IAC 2019Maria é a primeira tangerina totalmente desenvolvida no Brasil
- • IZ realiza venda de 89 bovinos Nelore, Caracu, Guzerá e mestiços, em Sertãozinho (SP)
- • Preços agrícolas sobem 1,30% IqPR em outubro, informa IEA
- ► Novembro (21)
- • Metodologias para o diagnóstico de mormo em equinos serão testadas pelo Instituto Biológico
- • Pesquisa da APTA mostra potencial de cultivo da PANC major gomes
- • Agregação de valor em horticultura é tema de seminário em Ribeirão Preto
- • IEA divulga preliminar do encerramento da safra 2016/17 e intenção de plantio para o próximo ano
- • Dois pesquisadores da Secretaria de Agricultura estão na lista das 100 personalidades mais influentes do agronegócio
- • Sistema de Gestão da Qualidade ISO 9001 do IB é recertificado
- • IEA aponta expectativa limitada de ganho no Mercado Futuro do Café
- • Alta de 1,21% no preço dos alimentos no varejo, informa IEA
- • IP participa de fórum sobre alimentação escolar na Argentina
- • Na InterCorte 2017, Instituto de Zootecnia destaca a produção pecuária sustentável aliada ao melhoramento genético
- • IZ integra o Caminhos da Genética na Intercorte em São Paulo
- • APTA realiza primeiro diagnóstico sobre produção de mudas de seringueira em bancada suspensa
- • IAC investe R$ 4,5 milhões na modernização da infraestrutura para otimização das pesquisas
- • Museu de Pesca de Santos implanta QR Codes para ampliar acesso à informações sobre seu acervo
- • Ao completar 75 anos, IEA anuncia levantamento do Índice de Preços Diários do Boi Gordo
- • Institutos de Pesquisas da Secretaria de Agricultura realizam 9º Workshop Bioeconomia em Pecuária de Baixo Carbono
- • APTA abre concurso para 33 pesquisadores científicos
- • Consepa apresenta propostas para Política de Pesquisa Agropecuária, em discussão no Senado
- • IB possui o único laboratório brasileiro para produção de imunobiológicos para diagnóstico de brucelose e tuberculose
- • Pesquisador do IAC recebe prêmio internacional por pesquisas com sustentabilidade
- • Defeso da piracema tem início em 1º de novembro em SP; estoque de pescado deve ser informado
- ► Outubro (30)
- • Instituto Biológico comemora 90 anos
- • Unidade da APTA em Assis comemora 30 anos de atuação
- • Obra editada pelo IB, Unesp e Universidade Mogi das Cruzes reúne informações sobre formigas em ambientes urbanos
- • Manual Técnico de Ranicultura está disponível para download
- • Artigo de pesquisadoras do IP é premiado pela Sociedade Brasileira de Herpetologia
- • APTA apresentou 17 tecnologias para os agronegócios no InovaCampinas
- • IB e agência de fomento discutem decreto que regulamenta as parcerias público-privadas
- • Cursos para preparo de feijão, cogumelos e aproveitamento integral dos alimentos são ministrados na Semana Mesa São Paulo
- • IAC transfere conhecimento sobre café a alunos do Curso de Classificação e Degustação de Café de Santos
- • Instituto Biológico discutirá os desafios do agronegócio durante Reunião Anual
- • Agronegócio: saldo da Balança Comercial Paulista sobe 2,8%
- • Seminário analisará a economia da pecuária de corte
- • APTA identifica materiais de goiaba que podem ser usados no cultivo orgânico
- • IB aumenta em 65% a produção de doses de tuberculina bovina e bate recorde de produção
- • Esalq homenageia Secretaria de Agricultura e suas unidades de pesquisa e extensão durante 60ª Semana Luiz de Queiroz
- • IZ desenvolve produto natural capaz de combater carrapatos em bovinos
- • ITAL debate o futuro da pesquisa e inovação no contexto da bioeconomia
- • Importância do investimento em ciência agropecuária é apresentada por coordenador da APTA em Campinas
- • Dia das Crianças terá programação especial sobre importância da preservação da vida aquática e dos insetos
- • IB debate pesquisas em controle biológico na EsalqShow, em Piracicaba
- • Três novas cultivares de café IAC têm ganhos de produtividade que variam de 35% a 70%
- • ITAL recebe visita do Ministro da Bósnia e Herzegovina
- • Professores das Etecs recebem treinamento da APTA em produção de cachaça
- • IB treina produtores familiares em saúde suína e qualidade da carne
- • 1º Workshop de Aquicultura Continental e Marinha reúne o público durante a feira Asian & SeaFood Show
- • Instituto Biológico lança boletim sobre sanidade na ovinocultura
- • ITAL promove primeiro curso sobre as etapas do processamento na área cárnea
- • CNPq premia pesquisa desenvolvida por bolsista do IAC
- • Pesquisadora do IP é eleita para diretoria do Capítulo Latino-americano e Caribenho da WAS
- • Mestrado IZ está com inscrições para processo Seletivo para 1º semestre 2018
- ► Setembro (24)
- • IB cria comissão interna para disseminar boas práticas científicas e avaliar denuncias de má conduta
- • Instituto de Pesca recebe certificação do MAPA e inaugurará quarentenário de organismos aquáticos
- • IAC lança três variedades de cana para o Cerrado e reúne 600 representantes do setor sucroenergético
- • Workshop reuniu 110 participantes para discutir toxicologia, resíduos e alternativas para controle de carrapato do boi
- • IEA analisa a variação de preços da cesta de alimentos do paulistano em julho e agosto
- • IB lança boletim técnico online sobre os aspectos fitossanitários da cultura da alface
- • Museu de Pesca sedia debate sobre desafios da pesca esportiva no Brasil
- • IAC lança três variedades de cana selecionadas em Goiás
- • IZ disponibiliza para venda 47 bovinos machos e fêmeas das raças nelore, caracu, Jersey,Girolando, Holandesa PB e mestiços
- • APTA premia cachaças de São Paulo nas categorias branca/descansada, envelhecida, premium e extra premium
- • APTA orienta piscicultores a reduzir perda de água por infiltração em viveiros escavados destinados à piscicultura
- • IAC assina projeto de validação tecnológica com Associcana para levar MPBs para 110 canavicultores da região de Jaú
- • Gestão da Pesca e Aquicultura é tema de debate no Instituto de Pesca
- • APTA realiza em Jaú evento com foco em empreendedorismo e inovação
- • UPD de Jaú da APTA comemora 80 anos de contribuição em pesquisa agropecuária na região
- • 58 rótulos de cachaça artesanal participam de concurso realizado pela APTA
- • Avaliações do ITAL reduzem impacto ambiental na cadeia produtiva de alimentos
- • Genética de reprodutores, matrizes e embriões bovinos estarão em leilão do Instituto de Zootecnia
- • Geraldo Alckmin regulamenta lei para garantir segurança jurídica e incentivar parcerias na pesquisa paulista
- • Pescado sustentável é o foco da primeira ação do IP na Semana do Peixe
- • Centro do IB em Campinas completa 80 anos e lança livro sobre sua história
- • IB e CDA capacitam 58 engenheiros agrônomos para evitar a entrada de pragas quarentenárias no país
- • ITAL comemora 54 anos
- • IZ disponibiliza 12 ovinos machos para venda
- ► Agosto (23)
- • Bioinseticida do IB garante controle do bicudo e pode gerar ganhos de 20 toneladas por hectare na cana-de-açúcar
- • Pesquisa do IB busca identificação e diagnóstico dos vírus causadores do mosaico na cana e no milho
- • Câmara Setorial do Pescado discute medidas para aumentar a produtividade do setor
- • Geraldo Alckmin e Arnaldo Jardim destacam bom trabalho do IZ em visita à 10ª Expogenética
- • Centro de pesquisa do IB em Campinas completa 80 anos
- • Coordenador da APTA é novo presidente do Consepa
- • Projetos de pesquisa em nutrição e sanidade animal são apresentados pela Apta a multinacional Trouw Nutrition
- • Pesquisa do IB reduz em 70% aplicação de defensivos na produção de tomate
- • Bolsistas do Instituto de Pesca apresentam seus trabalhos no XII SICIP
- • Equipes da Rede NIT-APTA são capacitadas em busca em bases de patentes
- • Para melhorar estrutura de pesquisa, institutos da APTA entregam Planos de Desenvolvimento Institucional para a Fapesp
- • Semana do Peixe acontece entre 1º e 15 de setembro com apoio da Secretaria de Agricultura
- • APTA arrecada 1.113 itens na Campanha do Agasalho 2017
- • Pesquisa do Instituto de Pesca garante isca viva mais barata e com menor impacto ambiental
- • Pesquisadora do IP é indicada para concorrer à Sociedade Mundial de Aquicultura
- • IB presta serviço de excelência para diagnóstico de morte súbita de bovinos por clostridioses
- • 16 bolsistas da APTA são premiados em congresso de iniciação científica
- • Secretaria apresenta resultados do primeiro ano de programa de fomento à bioeconomia
- • IAC recebe homenagem da Câmara Municipal de Mogi Mirim
- • ITAL propõe regulamentação técnica para mel das abelhas sem ferrão
- • APTA Regional organiza 11º Congresso Interinstitucional de Iniciação Científica, em Campinas
- • Agropolo Campinas-Brasil apresenta resultados parciais do projeto que identifica áreas estratégicas de pesquisa na bioeconomia
- • Professores de Cozinha e Nutrição da Etec recebem treinamento da APTA em plantas medicinais e aromáticas e em óleos essenciais
- ► Julho (29)
- • Laboratório do IB analisa 17 mil bovinos que serão exportados para o Egito
- • Mudas de café IAC são plantadas durante o 1º Festival da Cultura Cafeeira de Campinas
- • APTA realizará concurso para premiar as melhores cachaças paulistas
- • Nome de pesquisadora do IB é usado para descrever novo gênero de ácaro associado a granjas de postura
- • Empresa de ex-aluno da Pós-Graduação do IAC terá apoio do PIPE Fapesp
- • Programa de Sanidade em Agricultura Familiar do IB será apresentado em evento para comemorar o Dia do Agricultor
- • Projeto em Ribeirão Preto e Piracicaba beneficia qualidade da produção de leite na agricultura familiar
- • ITAL promove pesquisa para controlar a contaminação da castanha-do-pará
- • IAC participa do 1º Festival da Cultura Cafeeira de Campinas
- • APTA desenvolve software inédito para gestão de eventos agropecuários
- • Instituto de Pesca promove curso sobre Licenciamento Ambiental e Qualidade de Água em Piscicultura
- • ITAL promove curso de Cálculo de Processos Térmicos
- • Curso em Campinas orienta agrônomos sobre procedimentos fitossanitários
- • Apostila orienta sobre manejo para evitar prejuízos com as formigas-cortadeiras. Baixe grátis
- • Governador Geraldo Alckmin libera R$ 2,25 mi do FID para IB monitorar impactos ambientais da aplicação de agrotóxico
- • ITAL lança 2ª edição do livro Embalagens plásticas flexíveis: principais polímeros e avaliação de propriedades
- • IAC realiza Reunião Técnica e apresenta projeto para transmissão de informações agrometeorológicas pelo celular
- • Alta no preço do feijão e da carne encarece 1,83% a cesta de alimentos do paulistano em maio, aponta IEA
- • Planeta Inseto, do IB, possui certificado de excelência em site de recomendações turísticas
- • Gargalo da produção de azeite em São Paulo está no campo, segundo pesquisadora da APTA
- • Apostila orienta agricultores familiares sobre controle de parasitas na alface. Baixe grátis
- • ITAL lança estudo sobre tendências do setor laticínios
- • APTA realiza curso com técnicas básicas para produção de peixes no Vale do Paraíba
- • Restruturação da SPVinho marca início de encontro de vitivinicultores em São Paulo
- • Probio do IB assessorará implantação de nova biofábrica de agentes de controle biológico em Foz do Iguaçu
- • APTA fomenta produção de azeite de alta qualidade em São Paulo
- • Cadeia de óleos essenciais, plantas aromáticas e medicinais é debatida durante a comemoração dos 130 anos do IAC
- • IEA lança livro com histórias do setor agroflorestal no Estado de São Paulo
- • III Treinamento Prático sobre Produção de Cachaça será realizado pela APTA de Jaú
- ► Junho (27)
- • Protozoário que pode ser letal ao gado foi tema do Prosaf, que reuniu 86 produtores
- • APTA integra projeto temático da Fapesp para estudar mastite ambiental
- • APTA realizará um dos mais importantes fóruns sobre matérias-primas para bioenergia e energias renováveis do Brasil
- • Representantes do IP e da USP se reúnem para discutir parcerias para fomentar a aquicultura no Vale do Ribeira
- • ITAL apoia inclusão no mercado de trabalho
- • Instituto Agronômico completa 130 anos e lança duas variedades de cana com alto desempenho
- • Ingredientes da APTA são usados para preparação de cardápio servido no Prêmio Melhores do Ano Prazeres da Mesa/Rede
- • Reunião Anual do Instituto Biológico recebe trabalhos até 1 de agosto
- • Protozoário que pode ser letal ao gado será tema do Prosaf, em Nova Granada
- • Número de produtores orgânicos no Estado cresce 16,9%, aponta Secretaria
- • Pesquisador da Austrália conhece pesquisas do IB em sanidade vegetal
- • APTA desenvolve pesquisas com os principais produtos juninos
- • Unidade da APTA em Jaú instalará fossas sépticas biodigestoras para modernizar saneamento
- • Cardápio do evento Melhores do Ano Prazeres da Mesa/Rede será preparado com ingredientes desenvolvidos pela APTA
- • IB treina agricultores familiares no manejo para controle da broca da bananeira, uma das principais pragas da cultura
- • APTA arrecada R$ 22.300 em leilão de búfalos Puros de Origem no Vale do Ribeira
- • VI Workshop do IZ sobre Controle do Carrapato do Boi abordará a toxicologia, resíduos e alternativas
- • Prazo para inscrição de trabalhos no XI Workshop Agroenergia é prorrogado
- • Pesquisador do IAC fala sobre transgênicos X HLB
- • Artigo: O que nós somos para o meio ambiente?
- • Secretaria de Agricultura lança Programa de Inovação e Transferência de Tecnologia em Controle Biológico
- • No Dia Mundial do Meio Ambiente, Ubatuba recebe exposição Planeta Inseto, do IB
- • Reunião do IZ com a Aspaco traça futuras parcerias para ovinocultura
- • Pesquisadores e estudantes estrangeiros visitam sede do ITAL para conhecer o trabalho de tecnologia em alimentos
- • IP promove discussão sobre as perspectivas e desafios da pesca marinha em São Paulo
- • Pesquisadoras ligadas ao IAC ficam entre os finalistas em competição de comunicação científica
- • APTA lança plataforma online de acesso aos seus projetos de pesquisa em desenvolvimento
- ► Maio (19)
- • Búfalos Puros de Origem de alto valor genético serão vendidos em leilão da APTA no Vale do Ribeira
- • Plantio de árvores e arbustos em São Paulo reúne poder público e população em torno da educação ambiental
- • Pesquisador da APTA apresentará potencial econômico do lambari para petisco na Aquishow 2017
- • Nome de pesquisador do IB é utilizado para batizar inseto
- • Edital da Fapesp permitirá a abertura de novos projetos de pesquisa, melhoria da infraestrutura e contratação de bolsistas pelos Institutos
- • IZ realizará XII Simpósio Brasileiro de Melhoramento Animal
- • IP homenageia publicitário responsável por campanha em prol da revitalização do Museu de Pesca
- • IB transfere conhecimento na produção de fungos e insetos usados no controle biológico de pragas e doenças
- • APTA transfere conhecimentos a professores das Escolas Técnicas Estaduais (Etecs)
- • São Paulo terá um corredor verde para atrair insetos polinizadores
- • PIT Alimentos realiza encontro para ajudar produtores rurais e empresas da região de Campinas
- • População terá a oportunidade de colher café no pé em São Paulo durante evento do Instituto Biológico
- • Mortalidade de bezerros e mastite serão temas de treinamento realizado pelo Instituto Biológico em Dracena e Votuporanga
- • Aprenda a escolher e conservar a carne para não ter dissabores na hora da refeição
- • Levantamento do IEA identifica potencial para aumentar a produtividade da maçã no Estado de São Paulo
- • IZ realiza reunião do Agropolo Brasil-Campinas
- • Está no ar segunda temporada de programa de TV sobre aquicultura apresentado por pesquisador da APTA
- • População poderá auxiliar a construir condomínio de polinizadores no coração de São Paulo
- • Diretor do IB será homenageado pela Associação de Engenheiros Agrônomos do Estado de São Paulo, durante a Agrishow 2017
- ► Abril (25)
- • IAC-APTA lança cultivares de feijão, amendoim e sorgo vassoura na Agrishow 2017
- • IAC entrega primeiro pacote de pré-brotado IAC de cultivares de cana na Agrishow 2017
- • IB apresentará na Agrishow 2017 tecnologias para controle biológico em cana, soja, morango e plantas ornamentais
- • Vitrine Tecnológica para Pequenas Propriedades reúne tecnologias da APTA para pequenos produtores
- • Programa Aplique Bem completa dez anos com 55 mil trabalhadores treinados
- • Tecnologia sustentável e melhoramento genético de bovinos e ovinos serão foco do IZ na Agrishow 2017
- • IP levará informações sobre o licenciamento ambiental da aquicultura para a Agrishow 2017
- • Pesquisa do IAC no desenvolvimento de novos porta-enxertos busca controlar o HLB
- • IEA divulga o resultado final do VPA-SP de 2016
- • ITAL promove capacitação das vigilâncias sanitárias no Sul do Brasil
- • Resíduo do processamento de macroalgas marinha pode ser utilizado na produção de biocombustíveis e biofármacos
- • IB monitora a sensibilidade da ferrugem asiática aos fungicidas na soja
- • Sistema que alia produção de café e macadâmia com alta produtividade é apresentado pela APTA em evento em Jaú
- • Pesquisadora do ITAL participa de reunião sobre Projeto de Macaúba na Alemanha
- • Ministério da Economia da Holanda tem interesse em parceria com o IAC
- • Aprenda como escolher e armazenar peixes na Semana Santa
- • Amendoim: exportações do grão estão em alta, mas do óleo registram queda em 2016, afirma IEA
- • Cesta de mercado do paulistano ficou 2,25% mais barata em fevereiro, aponta IEA
- • Abertura de reunião científica do IP reúne autoridades, estudantes e pesquisadores em São Paulo
- • Centro do Pescado Continental do IP inaugura nova estrutura de pesquisa para desenvolver aquicultura paulista
- • IAC realiza palestra sobre melhoramento genético e aspectos nutricionais dos citros
- • IZ disponibiliza novo número do Boletim de Indústria Animal
- • IB integra projeto internacional para analisar se percevejos de cama podem transmitir doenças ao homem
- • Projeto Pecuária do Conhecimento completa cinco anos de atividade treinando 1.600 pessoas no sistema do Boi 7.7.7
- • IAC realiza o 18º Dia do Limão Tahiti em Pindorama
- ► Março (19)
- • APTA reúne 60 empresas do setor agrícola para apresentar suas linhas de pesquisa
- • Temperos, defumação e cortes diferenciados agregam valor à carne de cordeiros
- • Representantes de laboratórios de análises de solos do Brasil e do exterior participam de reunião no IAC
- • IB possui um dos únicos laboratórios de microscopia eletrônica do Estado de São Paulo
- • APTA realiza treinamento para capacitar gestores dos Núcleos de Inovação Tecnológica
- • No Dia Mundial da Água, Instituto de Pesca apresenta projeto inédito que busca determinar pegada hídrica na aquicultura
- • APTA reunirá empresários para apresentar oportunidades de novos negócios para as cadeias agrícolas paulista
- • Cultivo de macaúba é tema de pesquisa entre institutos da Secretaria de Agricultura e instituição alemã
- • Uso de capins da rodovia na dieta animal não é recomendado, alerta APTA
- • IZ abordará o bem-estar animal na produção de ovos no Congresso da APA
- • Pesquisas sobre emissões de gases do efeito estufa atraem delegação francesa ao IAC
- • IZ realiza 5º Curso sobre Carcaça de Ovinos com foco em avaliação, cortes e defumados
- • IZ analisa óleos funcionais como aditivo alimentar em dietas de bovinos
- • APTA realiza eventos para promover cultura de inovação dentro de seus institutos
- • Instituto Biológico abre suas portas para um domingo de diversão, ciência e cultura
- • IB realiza curso sobre abelhas sem ferrão, fundamentais para a polinização e conservação ambiental
- • Pragas urbanas aumentam no verão e causam transtornos e doenças na população, alerta IB
- • Pesquisa do IZ orienta a melhor forma de controle dos parasitas para que não haja resistência a tratamentos
- • Trabalho da APTA alavanca movimento agroflorestal no Vale do Paraíba
- ► Fevereiro (11)
- • Pesquisadores do IB dão dicas para o manejo de doenças fúngicas nas oliveiras
- • Pesquisa da APTA indica tipo de embalagem correta para vagem minimamente processada
- • IB realiza evento para dar start no desenvolvimento de uma nova vacina para febre aftosa
- • Manejo do pasto aumenta a produtividade da pecuária de leite, diz pesquisador da APTA
- • APTA realizará workshop sobre a cultura da soja
- • 40° Congresso Paulista de Fitopatologia será realizado no IAC, em Campinas, SP
- • Instituto de Pesca recebe investimento de R$ 4,7 milhões do Governo do Estado para alavancar pesquisas
- • IZ realiza venda de 138 bovinos, em Sertãozinho (SP)
- • IB e CDA coordenam curso de habilitação de engenheiros agrônomos para evitar entrada de pragas quarentenárias
- • Pesquisadora do IB lista métodos de manejo para controle do curuquerê-da-couve
- • APTA desenvolve dois equipamentos para limpar lambari
- ► Janeiro (27)
- • Concentração da chuva causa impacto na produção de milho, cana, hortaliças, frutas e flores, de acordo com IAC
- • Matrizes suínas criadas em baias coletivas e com alta fibra na ração apresentam melhor desempenho durante gestação
- • Resistência de linhagens de pepino à mosca-branca é avaliada em pesquisa na PG-IAC
- • Instituto Biológico transferirá tecnologia de controle biológico à biofábrica mineira
- • Ensaios de café consorciado com macadâmia da APTA atraem pesquisadores estrangeiros
- • Preços recebidos pelos produtores paulistas têm alta de 20,97% em 2016, informa IEA
- • Tecnologias paulistas serão apresentadas pela APTA na Coopershow, em Cândido Mota
- • Exportações no agronegócio paulista cresceram 12,8% em 2016, aponta IEA
- • Pesquisa na pós-graduação IAC avalia manejo do solo na cultura da cana
- • No Verão, cuidados para conservar os alimentos devem ser redobrados
- • Encontro da APTA discute tecnologia e controle de qualidade do pescado
- • Livro do IB sobre pragas e doenças na cultura da batata auxilia produtor no campo
- • IZ abre inscrições para o 14º Minicurso de ELISA
- • MBA-IAC em Fitossanidade tem inscrições abertas até 15 de janeiro de 2017
- • Prosaf treina 468 agricultores familiares em 10 cidades
- • Setor agropecuário foi o único a registrar aumento na geração de empregos formais em 2015, conclui IEA
- • Pesquisas do IZ mostram que a gordura da carne de cordeiros das raças deslanadas brasileiras beneficia a saúde humana
- • IAC propõe manejo com crotalária para controle de nematoides em quiabo
- • APTA identifica melhor cultivar de macadâmia para consorciar com café
- • Fortalecer o conceito de lavoura-pecuária para promover o agronegócio sustentável e produtivo é meta do IZ para 2017
- • IP consolidará Programa de Monitoramento da Pesca e aquicultura Continentais e formará parcerias para inovação tecnológica
- • IAC intensificará atividades de pesquisa e transferência de tecnologia em 2017
- • Fomentar o setor de inovação e difundir tecnologias em alimentos processados é meta do ITAL
- • IEA terá banco de dados da produção de orgânicos e agricultura familiar em 2017
- • Consolidar parcerias com o setor privado para fomentar novas tecnologias para o setor é meta da APTA em 2017
- • APTA Regional destaca para 2017 projetos focados no desenvolvimento regional
- • IB focará na inovação, prestação de serviços e transferência de tecnologia
- ► Dezembro (17)
- ► 2016 (276)
- ► Dezembro (25)
- • IEA acompanha produção para criar ferramentas para o desenvolvimento econômico
- • ITAL promove ações para garantia da qualidade de alimentos processados em 51 eventos
- • APTA faz balanço positivo de 2016
- • Desburocratização da aquicultura beneficia diretamente produtores paulistas
- • IB triplica captação de recursos junto a Fapesp e CNPq em 2016
- • Transferência de tecnologias e difusão de culturas marcam o ano para o IAC
- • Vitrine Tecnológica e melhoria genética do IZ fortalecem o conceito de ILPF
- • Planejamento estratégico para alinhamento dos projetos de pesquisa marcam o ano da APTA Regional
- • Geraldo Alckmin recebe exemplar de livro sobre educação ambiental produzido pela APTA
- • IB doa 82 quilos de café ao Fundo Social de Solidariedade do Estado de São Paulo
- • Instituto Biológico realiza, em média, 585 diagnósticos de pragas e doenças por dia
- • Treinamento Prático sobre Produção de Cachaça é realizado pela Apta
- • Cafés colhidos no IB serão doados para entidades assistenciais do Estado de São Paulo
- • Sem risco de contaminação, Vigilância Sanitária libera comércio e consumo de moluscos bivalves no Estado de São Paulo
- • APTA desenvolve produto para substituir antibióticos na produção de bovinos de corte
- • Para comemorar seis anos de atividade, Planeta Inseto, do Instituto Biológico, ganha espaços revitalizados
- • Dirigentes da maior empresa de controle biológico do mundo visitam laboratórios do IB
- • APTA lança livro sobre observação de pássaros para incentivar a educação ambiental
- • APTA realizará dia de campo sobre a cultura da pitaya
- • IZ disponibiliza 46 ovinos para venda
- • Lançamento do Programa de Inclusão Tecnológica de Alimentos é realizado no ITAL
- • Censo realizado pelo IAC identifica variedades de cana predominantes na região Centro-Sul do Brasil
- • IP divulga lista de espécies aquícolas alóctones, exóticas e híbridos cultiváveis no Estado de São Paulo
- • Instituto Biológico é consultado para atender protocolos sanitários para exportação de bovinos vivos à Malásia
- • Produtores rurais de Presidente Prudente são orientados sobre compostagem em olericultura
- ► Novembro (25)
- • Vitrine de Tecnologia Sustentável fará parte do Integrar para Crescer
- • IEA e Cati divulgam a intenção de plantio de 2016/17 e o levantamento final da safra 2015/16
- • IB transferirá conhecimento e informações a pequenos pecuaristas sobre mastite e carrapato
- • Coplana ganha o Prêmio SOMOSCOOP com projeto realizado em parceria com o IAC
- • IZ e HYG assinam a primeira parceria no novo modelo NIT da Secretaria de Agricultura
- • Instituto Biológico presta contas à sociedade com apresentação dos resultados de 2014 e 2015
- • I Encontro dos Núcleos de Inovação Tecnológica da SAA gera debate sobre segurança jurídica e oportunidades
- • Instituto Agronômico divulga maior censo varietal de cana já realizado no Brasil
- • APTA realizará evento para discutir nova legislação de incentivo à inovação tecnológica
- • IZ recebe prêmio com pesquisa inovadora ao bem-estar de codornas
- • 3º Workshop Bioeconomia do Agropolo Campinas-Brasil reúne indústrias e instituições públicas com o objetivo de produzir biocombustíveis avançados
- • Pesquisador do IAC recebe Prêmio IPNI Brasil em Nutrição de Plantas 2016
- • Pesquisador do IAC, Marcos Landell, e secretário de Agricultura, Arnaldo Jardim, recebem Prêmio Master Cana Brasil 2016
- • IEA completa 74 anos
- • ITAL lança plataforma de informações científicas sobre alimentos processados
- • Pesquisadora do IB é homenageada em maior congresso de controle de vetores e pragas da América Latina
- • IB comemora 89 anos com servidores, representantes do setor e empresas parceiras
- • Período de defeso em São Paulo tem início e pesca será liberada em 1º de março de 2017
- • APTA realiza curso sobre criação de camarão de água doce, em Pirassununga, interior paulista
- • IZ, Ital e Codeagro destacam a produção de leite paulista durante lançamento do Mercado São Paulo
- • Instituto Biológico realizará 29ª Reunião Anual com foco em sustentabilidade e meio ambiente
- • Instituto Biológico comemora 89º aniversário em São Paulo, Capital
- • IP promove curso sobre criação e reprodução de peixes ornamentais de água doce
- • Instituto Biológico recebe exposição de alta tecnologia sobre a importância da alimentação
- • Instituto Biológico desenvolverá projeto inédito para estudo do zika vírus em animais
- ► Outubro (29)
- • Levantamento do IEA indica queda na produção e impacto no preço da mandioca para indústria em 2016
- • Curso de fabricação de achocolatado é promovido pelo ITAL
- • Instituto de Pesca e Butantan planejam parceria para criação e manejo de zebrafish
- • IB treinará agricultores familiares no diagnóstico de doenças em produtos cítricos para exportação
- • Diretor do IB, Antonio Batista Filho é homenageado durante a 59ª Semana Luiz de Queiroz
- • Pesquisador da APTA ministrou palestra sobre as apostas da agricultura paulista no evento Semana Mesa SP
- • Antúrios desenvolvidos pelo IAC e pela APTA Regional são cultivados de Norte a Sul do Brasil
- • Animais em exposição no IZ divulgam a ciência e inovação em agropecuária na Semana Nacional de Ciência e Tecnologia 2016
- • Governo de SP investe R$ 7,7 mi em 15 obras para modernizar fazenda de pesquisas do IAC
- • Cafés IAC são degustados no maior evento do setor no Brasil
- • Primavera: Instituto Biológico ensina como ter flores bonitas e saudáveis
- • Curso de análise sensorial de Carnes é realizado no ITAL
- • IAC sedia Inova Campinas 2016
- • APTA abre as portas para parcerias com iniciativa privada durante workshop que discutiu novos negócios para a cadeia produtiva de proteína animal
- • Video mapping e projeções fulldome são destaques do projeto Arte Palavra Alimento
- • IB inicia curso de habilitação para ferramenta que evita a entrada de pragas sem ocorrência em determinada região
- • Agricultura não deteriora qualidade da água na microbacia do Córrego da Olaria, aponta APTA
- • APTA tem programação especial para aproximar pesquisa e público durante a Semana Nacional de Ciência e Tecnologia
- • APTA realizará encontro com empresários da cadeia produtiva de proteína animal para incentivar parcerias
- • Mestrado IZ está com inscrições para processo seletivo para 1º semestre 2017
- • VII Simcope discute estratégias para o setor da pesca e aquicultura
- • Três pesquisas desenvolvidas pela APTA receberão o Prêmio Josué de Castro
- • Luiz Tejon fala sobre os desafios do agronegócio em palestra no Ciclo de Seminários IEA
- • Autoridades se reúnem no IP para discutir ações de segurança no mar
- • Governo Alckmin cria núcleos de inovação tecnológica para impulsionar pesquisas sobre o agronegócio
- • Pesquisadores do IAC palestram sobre tecnologias e cenários da canavicultura
- • Levantamento de preços da Secretaria de Agricultura orienta população a consumir leite de qualidade com economia
- • Pesquisador do IB apresenta palestras sobre controle biológico em cana na Guatemala
- • Pesquisadores da APTA dão dicas ao agricultor de como iniciar o cultivo de maracujá
- ► Setembro (33)
- • Referência no Brasil, Boletim do Instituto de Pesca completa 45 anos
- • Brasil precisará adequar a produção de figo para atender normas de exportação ao mercado europeu
- • Projeto de recuperação de nascentes do IAC traz ações inéditas para região de Campinas
- • Exportações paulistas aumentam impulsionadas pelo agronegócio, aponta IEA
- • Instituto Biológico transferirá informações sobre manejo de pragas e doenças da roseira em Guararema
- • IAC quer unir esforços para alavancar a fruticultura paulista
- • Venda de fertilizantes agrícolas no País cresceu 10,4% em 2016, indica Instituto de Economia Agrícola
- • Governo de SP e Prefeitura de Campinas transformarão resíduos urbanos em adubo orgânico
- • Curso sobre projeto sanitário para a indústria de alimentos é ministrado pelo ITAL
- • Estudantes testam produtos desenvolvidos pela APTA em aulas de gastronomia
- • APTA realiza evento para integrar cadeia produtiva da piscicultura no Vale do Ribeira
- • Pesquisadores do IAC e APTA Regional palestram sobre tecnologias e cenários da canavicultura
- • IB e ROYAL CANIN® renovam convênio para análises microbiológicas de alimentos para pets
- • Pesquisa da APTA mostra transferência de 30% do nitrogênio no cultivo de tomate consorciado com leguminosas
- • IB realiza congresso para discutir produção orgânica e tecnologias e inovações na agropecuária
- • IEA e Esalq oferecem MBA à distância em Agronegócios
- • Agrônomo, profissional fundamental para fomentar a agricultura que abastece o mundo
- • Instituto Biológico é credenciado pelo MAPA para realizar diagnóstico de mormo
- • NESCAFÉ Dolce Gusto lança cápsulas Catuaí do Cerrado produzidas com cultivar do IAC
- • Programa de Sanidade em Agricultura Familiar aborda manejo de pragas e doenças em roseiras
- • Pesquisas da APTA com búfalos auxiliam no desenvolvimento do Vale do Ribeira
- • IZ sedia debate sobre os desafios respiratórios de suínos
- • Instituto Biológico realiza análises fitossanitárias para evitar introdução de pragas quarentenárias no Brasil
- • ITAL desenvolve requeijão enriquecido com farinha da casca do maracujá
- • Instituto Biológico lança manual e vídeo sobre Controle estratégico do carrapato bovino
- • Laboratório do IB testa kit de extração de proteína animal na alimentação de ruminante
- • Curso sobre avaliação de processos de esterilização e pasteurização na produção de alimentos é realizado pelo ITAL
- • IZ apresenta estudo que identifica animais mais resistentes ao calor
- • Pesquisadora do IAC recebe Prêmio Marcílio Dias por pesquisas em olericultura
- • IZ disponibiliza 59 ovinos para venda
- • IP cria projeto para auxiliar na preservação da espécie cação-viola
- • Pesquisa e indústria debatem o uso de resíduos em Workshop no IAC
- • Secretaria de Agricultura quer estimular parcerias entre seus institutos de pesquisa e a iniciativa privada
- ► Agosto (35)
- • IB transfere conhecimento e tecnologia para melhorar qualidade do leite de pequenos e médios produtores
- • Pesquisa do IB para monitorar impactos ambientais da aplicação de agrotóxico recebe investimento de R$ 2,25 milhões
- • IZ disponibiliza a melhor genética de Reprodutores e Matrizes em Leilão
- • Curso de controle da salmonela em alimentos é realizado na sede do ITAL, em Campinas
- • Safra paulista de grãos cresce 7% e atinge 8,4 milhões de toneladas, informa Secretaria
- • IAC desenvolve régua que reúne informações para orientar o plantio de cana-de-açúcar
- • Pesquisa da APTA aumenta em 60% produtividade de tomate orgânico com o uso do fungo Trichoderma
- • VII Aquishow transforma Santa Fé do Sul na capital da pesca e aquicultura
- • Pesquisador da APTA orienta pecuaristas a diagnosticar a mastite no rebanho bovino
- • IZ lança o Sumário de Touros e Matrizes Nelore na Expogenética 2016
- • Instituto de Pesca prepara programação especial para a XIII Semana do Peixe
- • IB presta assessoria técnica para implantação de biofábrica para controle biológico em flores
- • Arnaldo Jardim destaca importância de transferir conhecimentos ao produtor durante o I Beefday, em Colina
- • Uberaba (MG) Reprodutores da Linhagem IZ participarão da ExpoGenética 2016
- • APTA realizará evento para difundir conceito do Boi 7.7.7 em Colina, interior paulista
- • Dia dos Pais: IZ foi palco de piquenique e brincadeiras entre pais e filhos
- • Instituto Biológico receberá certificação do Inmetro para unidade laboratorial de sanidade animal e vegetal
- • Projeto de Políticas Públicas em Bioeconomia do Agropolo Campinas-Brasil é aprovado pela FAPESP
- • Aumento do feijão e dos produtos de origem animal encarecem preços agropecuários em junho, conclui IEA
- • Empresa norueguesa busca Governo de São Paulo para instalar centro de melhoramento genético de tilápias
- • Fabricação de produtos de panificação mais saudáveis é tema de curso do ITAL
- • Tourinhos Nelore com melhor eficiência alimentar são classificados pelo IZ
- • Polo Regional da APTA apresenta técnicas de produção e manejo de banana e pupunha
- • APTA arrecada 1304 itens para Campanha do Agasalho 2016
- • Artigo: Os insetos, as Olimpíadas e o Instituto Biológico
- • Instituto Biológico analisará resíduos de defensivos agrícolas nos produtos da Ceasa Campinas
- • IEA analisa os desafios do produtor rural para atender à legislação de qualidade do leite no País
- • Projeto desenvolvido pelo Instituto de Pesca auxilia na alimentação de alunos da rede pública de Itanhaém
- • Fungo em castanheiras-do-brasil e castanha-do-pará produzem antibióticos para combater infecções
- • Fluxo de viajantes pode aumentar a ocorrência de percevejos de cama, alerta Instituto Biológico
- • Jornalistas chineses, que farão a cobertura dos Jogos Olímpicos, visitam IB
- • Instituto de Pesca, APTA e CDA monitoram qualidade de moluscos na costa paulista
- • IZ aborda novas alternativas para controle da verminose e resistência de vermes em ruminantes
- • ITAL orienta sobre produção de linguiça artesanal, embutido cárneo mais fabricado no Brasil
- • Cultura do milho é tema de reunião técnica no IAC
- ► Julho (24)
- • APTA disponibiliza a piscicultores DVD sobre técnicas de cultivo do lambari
- • Treinamento alternativo de cavalos para esportes olímpicos é avaliado pela APTA
- • Secretaria de Agricultura divulga valor da Terra Nua no Estado de São Paulo
- • Curso realizado no ITAL reúne pesquisadores, estudantes e profissionais da indústria de alimentos
- • IAC desenvolve pesquisa com uvas para a produção de vinhos
- • Projeto de ácaros predadores do IB será financiado pela FAPESP
- • Primeiro Censo Paulista de Cogumelos Comestíveis e Medicinais é realizado em São Paulo
- • Caminhos da Cana 2016/2017 será lançado no Centro do IAC
- • Instituto de Zootecnia completa 111 anos de pesquisas para a pecuária
- • Instituto de Zootecnia comemora 111 anos de tecnologia agropecuária com sustentabilidade
- • Aumento nas exportações do setor agro paulista ajuda a reduzir o déficit da Balança Comercial
- • Instituto Biológico promove curso pioneiro sobre sanidade das oliveiras em São Paulo
- • Programa do IAC de qualidade de vestimentas de proteção para riscos com agrotóxicos completa dez anos
- • APTA realiza evento para discutir o conceito de produção do Boi 7.7.7
- • Institutos da APTA transferem conhecimento de forma lúdica e interativa para crianças e adolescentes
- • IZ realiza dia de campo sobre Sistemas Integrados de Produção na Agropecuária
- • Delegação da República de Camarões visita sede do ITAL, em Campinas
- • Instituto de Pesca recebe visita de comitiva chilena
- • Grãos em alta e sinal de alerta para cana e laranja são os resultados das Previsões e Estimativas de Safras divulgadas pelo IEA
- • Instituto Agronômico desenvolve pesquisas com pupunha em duas regiões do Estado de São Paulo
- • Inscrições abertas para curso em Campinas sobre processamento de mortadela e salsicha
- • Governador Geraldo Alckmin é homenageado por incentivar pesquisa e agricultura sustentável
- • IEA explica o efeito do aumento e queda do preço de alguns produtos no orçamento das famílias
- • IP atua na regularização de empreendimentos aquícolas
- ► Junho (34)
- • Normas para funcionamento dos Núcleos de Inovação Tecnológica nos institutos são estabelecidas pela APTA
- • Museu de Pesca tem programação especial para a Semana do Pescador
- • Pesquisadores da APTA instalam unidade demonstrativa para plantio de batata em assentamento rural da região de Bauru
- • Rede Social do Café completa dez anos
- • Unidade de pesquisa do Instituto Biológico é acreditada na norma ISO/IEC 17025 pela Cgcre/Inmetro
- • Vitrine Tecnológica e Boi 7.7.7 são destaques da Secretaria da Agricultura durante Semana da Carne em SP
- • Agropolo Campinas-Brasil completa um ano e realiza 1º Workshop em Bieconomia
- • Quebra da safra eleva o preço do feijão em maio
- • IAC completa 129 anos com parceria na área de compostagem de resíduos urbanos vegetais
- • Instituto de Zootecnia comercializará 146 bovinos em Sertãozinho
- • APTA é instituição líder em normas e procedimentos acreditados pelo Inmetro
- • Secretário Arnaldo Jardim anuncia lançamento do censo agropecuário paulista 2016-2017
- • Pesquisa sobre reprodução de espécie marinha ameaçada de extinção é conduzida pelo IP
- • APTA realiza X Workshop Agroenergia: Matérias-primas
- • IEA avalia a evolução das campanhas nacional e paulista para o controle da febre aftosa
- • Governador Geraldo Alckmin conhece a Vitrine de Tecnologia Sustentável, desenvolvida pela Secretaria, na InterCorte 2016
- • Curso do Instituto Biológico ensina importância ecológica das abelhas
- • IAC integra projeto internacional para estudar eficiência do uso do nitrogênio na agricultura
- • Agricultores do Assentamento de Tremembé recebem laudo de diagnóstico de greening
- • Projetos de pesquisa sobre manejo e conservação do solo em cana poderão ser enviados à APTA até 30 de junho
- • Ganhos de produtividade com o Boi 7.7.7, desenvolvido pela APTA, são destaque na BeefExpo 2016
- • Secretaria treinará agricultores de Arujá sobre controle biológico com ácaro predador
- • Instituto de Pesca retoma Ciclo de Palestras sobre Ciências do Mar
- • 20ª Conferência Mundial de Embalagem é realizada pelo CETEA/Ital
- • Fundação de Apoio à Pesquisa Agrícola completa 25 anos de suporte aos projetos de pesquisa desenvolvidos pela APTA
- • CRV Lagoa e Instituto de Zootecnia de Sertãozinho celebram 45 anos de uma parceria campeã
- • Fungo em castanha-do-brasil e castanha-do-pará produzem a antibióticos para combater infecções
- • Estudo do IAC sobre irrigação por gotejamento em laranjeiras mostra ganho de produtividade de até 100%
- • APTA desenvolve parâmetros para a produção de rações para peixes e ovinos comercializadas por cooperativa paulista
- • Arnaldo Jardim destaca os avanços da Citricultura, em Cordeirópolis
- • Equipe do IP realiza coletas em quatro Estados para desenvolver probiótico para tilápia
- • Produção de pescado na costa paulista foi de 635 toneladas em janeiro de 2016
- • A interação entre a agricultura e a natureza
- • Cerca de 100 pessoas participam de workshop da APTA sobre pimentão
- ► Maio (20)
- • Instituto de Pesca sedia curso internacional sobre biomarcadores
- • Pesquisa do IAC indica a possibilidade de reuso da fibra de coco para produção de baby leaf
- • Ital obtém melhor avaliação em auditoria e renova certificado de gestão de qualidade
- • Instituto de Zootecnia finaliza teste de eficiência alimentar em animais da raça Senepol
- • Bom desempenho do agronegócio contribui para queda no déficit na Balança Comercial paulista, informa estudo do IEA
- • Instituto Biológico recebe visita de 24 estudantes de jornalismo
- • Produtores visitarão unidade da APTA em Tietê para conhecer sistemas de integração de lavoura, pecuária e floresta
- • Secretaria de Agricultura realiza I Curso de Sanidade Apícola de São Paulo
- • Instituto Biológico inaugura laboratório de nível de segurança 3
- • Paulistanos poderão colher café durante evento do Instituto Biológico
- • APTA realiza I Curso de Sanidade Apícola de São Paulo
- • APTA realiza o I Curso de Camarão de Água Doce em Pirassununga
- • Tecnologia da APTA reduz em 30% a ocorrência da podridão nas pupunheiras
- • Instituto Biológico realiza curso de habilitação para Certificação Fitossanitária de Origem
- • Apta Regional de Pindamonhangaba produz silagem com girassol para alimentação de gado leiteiro
- • Pesquisador do IAC é homenageado com a medalha Fernando Costa na Agrishow 2016
- • IAC promove evento sobre inovação e empreendedorismo no agronegócio durante Agrishow 2016
- • APTA apresenta projeto de longa duração para realização de pesquisa e difusão tecnológica na Agrishow
- • Secretaria de Agricultura firma parceria para transferir tecnologias do IAC a associados da Orplana
- • Secretaria da Agricultura assina Protocolo de Intenções com o Conglomerado do Peru
- ► Abril (12)
- • Alckmin recebe o balanço social das pesquisas realizadas pela APTA durante Agrishow 2016
- • APTA fará três lançamentos na Agrishow 2016
- • R$ 11,40 é o retorno da APTA para a sociedade, a cada R$ 1,00 investido na Agência
- • IAC apresenta novas variedades de feijão e milho na Agrishow 2016
- • IZ e IP expõem pesquisas para melhorar a produção de leite e reduzir desperdício de pescado
- • APTA Regional apresenta técnica de enxertia de maracujá e tecnologia que integra produção de peixes e hortaliças
- • Parceria entre APTA e universidade do Texas estudará saúde reprodutiva dos peixes
- • APTA busca integrar projetos de pesquisa realizados por pesquisadores de unidades regionais e Institutos
- • APTA realiza II Curso sobre Técnicas de Cultivo e Produção Integrada de Lambari
- • Instituto de Pesca completa 47 anos e planeja ampliar parcerias com setor produtivo
- • Pesquisa da APTA avalia cultivares de milho e sorgo para diminuir custos da alimentação animal
- • APTA realiza V Curso de Análise Sensorial e Qualidade de Azeites
- ► Março (9)
- • Produção de tilápias em tanques-redes pode aumentar 30%, aponta pesquisa da APTA
- • Projeto de reflorestamento da APTA é apresentado em conferência na Alemanha
- • Secretaria ensinará em Campinas como produzir fungos que substituem os agroquímicos
- • Secretaria promove curso de bovinocultura para demonstrar o conceito do boi 7.7.7.
- • Laboratório da APTA desenvolve pesquisa para fomentar produção e comercialização de camarões de água doce
- • Secretaria de Agricultura cria Núcleo de Inovação Tecnológica para gerir ações de seus institutos de pesquisas
- • Pesquisa do IB e UFSCar pode contribuir para uma nova geração de inseticidas biológicos no mercado
- • Uso de resíduo de esgoto reduz custos de aplicação de fertilizantes em canaviais
- • Uso de telas de sombreamento na produção de hortaliças no verão é analisado pela APTA
- ► Fevereiro (16)
- • Pesquisas do IAC mostram viabilidade do uso de resíduos urbanos na agricultura
- • 90% das Centrais de inseminação artificial de touros do país são monitorados pelo Instituto Biológico
- • Substâncias extraídas de sementes de urucum podem ser usadas como repelente natural
- • Pesquisa da APTA dobra a produção de mudas de morango, com o uso da homeopatia
- • Agronegócio: Com exportações e importações em queda, saldo da BC de janeiro atinge pouco mais de US$ 500 milhões
- • 32ª Reunião Anual do Ensaio Proficiência IAC será realizada nesta terça, 16
- • Preço das hortaliças dispara e pressiona o orçamento familiar, indica pesquisa
- • Pesquisa usa rãs para medir nível seguro de agroquímicos
- • APTA realiza pesquisas para viabilizar a produção de oliveiras no Estado de São Paulo
- • Ital elabora documento para harmonizar os conceitos ambientais para o desenvolvimento de embalagens
- • Secretaria de Agricultura paulista apresenta exposição de arte e oficina infantil no Museu de Pesca
- • Instituto Biológico emite laudos sobre pragas urbanas em patrimônios históricos
- • Profissionais da agricultura podem colaborar com grupo de trabalho sobre Planejamento da Conservação do Solo
- • Método para pecuarista aferir peso de novilhas sem uso de balança é desenvolvido pela APTA
- • Geraldo Alckmin conhece conceito de Boi 7.7.7 e elogia: É impressionante o ganho de renda para a pecuária
- • Previsão de safra: boas perspectivas para grãos e resultados positivos para cana e laranja
- ► Janeiro (14)
- • Pesquisador da APTA apresenta primeiro programa de TV sobre aquicultura do País
- • Segurança alimentar será o foco do ITAL em 2016
- • Instituto de Pesca intensifica a transferência de tecnologia dos pequenos produtores
- • Instituto de Zootecnia investe no melhoramento genético e na pecuária sustentável
- • Aumentar o Sistema de Gestão de Qualidade e fomentar o Prosaf serão prioridades do Instituto Biológico
- • Desenvolver pesquisas alinhadas às necessidades do setor agrícola é a meta do IAC
- • APTA apresenta tecnologias paulistas na Coopershow
- • APTA busca reorganizar estrutura e firmar mais parcerias para desenvolver tecnologias em 2016
- • O sistema de Gestão da Qualidade no Instituto Biológico
- • Pesquisa sobre sustentabilidade ambiental na aquicultura é desenvolvida pelo Instituto de Pesca
- • IAC tem laboratórios credenciados pelo MAPA e acreditados pelo INMETRO
- • Manejo cultural na produção de brássicas previne a hérnia das crucíferas
- • MBA-IAC em Fitossanidade tem inscrições abertas até 23 de janeiro de 2016
- • Pesquisa inédita da APTA é agraciada em congresso de medicina veterinária
- ► Dezembro (25)
- ► 2015 (208)
- ► Dezembro (13)
- • Fundo Social distribuirá mais de 200 quilos de café doados pela Secretaria
- • Nova edição da publicação O Agronômico traz informações sobre solos
- • 1º Dia de Campo IZ reforça os ganhos ambientais e econômicos da Integração Lavoura-Pecuária-Floresta
- • Governador libera R$ 3,7 milhões para conclusão de obras em centro de pesquisa do pescado
- • Instituto Biológico se reúne com Ministério da Agricultura para discutir sanidade em São Paulo
- • APTA compila dados e disponibiliza informações sobre quebra de dormência de 145 espécies nativas
- • Instituto Biológico realiza treinamento sobre abelhas sem ferrão
- • ITAL recebe Prêmio Plásticos em Revista 2015
- • Workshop sobre clima mundial é realizado pelo Instituto de Zootecnia
- • Adaptação de tilápia a diferentes salinidades é tema de estudo no Instituto de Pesca
- • IEA divulga a estimativa preliminar do Valor da Produção Agropecuária por Região
- • Quarentenário do Instituto Agronômico integra sistema de defesa vegetal do Brasil
- • Aquaponia integra produção de lambari e hortaliças
- ► Novembro (23)
- • Feno é opção de alimento em períodos de escassez de forragens
- • Secretaria consegue autorização para captura de caranguejo-uçá no litoral paulista
- • IEA comemora aniversário com palestra sobre Tecnologia e Inovação, suas marcas registradas
- • Secretaria atende pedido de agricultores familiares e ensina controle biológico em Mogi das Cruzes
- • Ensaio sobre composição de bisfenol A em alimentos é realizado pelo ITAL
- • Curso que capacita empresas alimentícias a exportarem seus produtos aos EUA é ministrado pelo ITAL
- • Sistema de plantio desenvolvido pelo IAC aumenta a produtividade e reduz a ocorrência de pragas e doenças em videiras
- • Agropolo Campinas-Brasil faz 1ª oficina para debater temas ligados à bioeconomia
- • Revista O Biológico completa 80 anos de divulgação da inovação em defesa do agronegócio paulista
- • Avicultura ganha ainda mais força em Campinas com retomada de pesquisas no Instituto de Zootecnia
- • Tecnologia reduz idade ao primeiro parto de novilhas leiteiras mestiças
- • APTA realiza I Workshop de Aquaponia
- • Instituto Biológico treinará horticultores na região de Mogi das Cruzes
- • APTA tem dois pesquisadores na lista dos mais produtivos na área de agroecologia
- • APTA realiza pesquisa para avaliar variedades de cana para produção de açúcar mascavo
- • Site da APTA tem cerca de 358 mil acessos em 2015
- • Instituto Biológico realiza reunião anual focando produção de alimentos e sustentabilidade ambiental
- • 28ª Reunião Anual do Instituto Biológico discute água e sustentabilidade da agricultura
- • Pesquisador do Instituto Biológico orienta técnicos e fiscais sobre o ácaro vermelho no Ceará
- • Novo diretor do Instituto de Pesca quer aproximar pesquisa e aplicação prática na produção
- • Alho processado de cultivares nacionais escurece menos que o chinês
- • Especialistas discutem propostas para o clima, água e sustentabilidade durante 28ª Reunião Anual do Instituto Biológico
- • Tendências e inovações na área de processamento de alimentos são temas de palestras do Ital
- ► Outubro (17)
- • Diálogo entre Secretaria e Fapesp pode intensificar financiamento de pesquisas de institutos
- • Pesquisadora do Instituto Biológico recebe Prêmio ENDESA 2015
- • Agronegócio: complexo sucroalcooleiro, sucos e alimentos garantem superávit da Balança Comercial
- • Laboratório da Secretaria garante a São Paulo R$ 1,5 bilhão por ano em exportação de carne de frango
- • Pesquisadora da APTA apresenta trabalho em evento para estimular parcerias científicas entre Brasil e Reino Unido
- • Tecnologias em cogumelos e cafés finos serão expostas pela APTA em evento de gastronomia
- • APTA expõe tecnologias em feira de negócios e inovação para agricultura familiar
- • IAC abre inscrições para mestrado em Agricultura Tropical e Subtropical
- • Tecnologia de indução na reprodução do lambari desenvolvida pela APTA pode aumentar a produção
- • Pesquisador do IAC recebe prêmio Josué de Castro
- • Médicos veterinários do Acre são capacitados pelo Instituto Biológico
- • APTA trabalha para resgatar e difundir conhecimento em Plantas Alimentícias Não Convencionais
- • Secretaria de Agricultura apresenta o diagnóstico do Setor Sucroenergético em 2014
- • Síndrome do Colapso das Colônias das abelhas é pesquisada pela APTA
- • Dia Internacional do Café tem tudo a ver com o IAC
- • No Planeta Inseto, público pode conhecer abelhas sem ferrão e visualizar o interior de uma colmeia ao vivo
- • Tecnologia para reprodução de búfalos teve participação da APTA
- ► Setembro (17)
- • Pesquisa da APTA adéqua cultivo de melancia em áreas de renovação de canavial
- • Tecnologia do Instituto Biológico pode eliminar a aplicação de acaricidas em flores e plantas ornamentais
- • É preciso focar na produtividade, levar inovações para o campo, pede Arnaldo Jardim em Polo da APTA
- • Instituto Biológico reduz consumo de água em 32,1%
- • Ital apresenta estudo Brasil Processed Food 2020 no Metro Alimentos 2015
- • Parceria une APTA de Campos do Jordão e universidade argentina
- • IZ realiza leilão em Sertãozinho e comercializa animais de seu programa de melhoramento genético
- • Preços Agropecuários apresentam alta de 0,92% em agosto de 2015
- • Melhoraria da produção de amoreira para alimentação do bicho-da-seda é orientada pela APTA
- • Agricultores do Vale do Ribeira terão curso para evitar a Sigatoka Negra na cultura da banana
- • Secretaria de Agricultura e Abastecimento realizará o 13º Cicam, no Instituto Biológico
- • Pesquisadores analisam mecanização na colheita da cana em Piracicaba
- • Aplicadores de agrotóxicos são capacitados pelo Programa Aplique Bem do IAC
- • Tecnologia do Pescado é tema de palestra do Instituto de Pesca na TecnoCarne
- • População paulista conta com laboratório para garantir alimentos seguros na mesa da família
- • Mudas Pré-Brotadas de cana terão linha de crédito de até R$ 200 mil do Feap
- • Sistemas agroflorestais são desenvolvidos por pesquisadores da APTA
- ► Agosto (32)
- • IZ realizará venda de Reprodutores e Matrizes bovinos em Sertãozinho
- • Pesquisador da Secretaria é uma das 100 pessoas mais influentes da Avicultura Brasileira
- • Tecnologia para descarte de peixes através de compostagem é transferida pela APTA
- • Gerar sustentabilidade, energia e renda usando dejetos suínos é projeto desenvolvido pela Secretaria
- • Secretaria de Agricultura firma convênio para desenvolver o projeto Brasil Processsed Food 2020"
- • Previsão de Safra: Secretaria divulga levantamento de junho Grãos devem ter produção 19,1% maior em 2015
- • Uso do sistema MPB em manejo conservacionista é tema de pesquisa da APTA
- • Angolanos buscam cooperação da Secretaria de Agricultura Paulista
- • IEA abre inscrições para MBA em Agronegócio à distância
- • Segurança alimentar do pescado é tema de palestra da Secretaria de Agricultura durante feira internacional de comida asiática
- • Secretaria de Agricultura incentiva jovens estudantes no caminho da ciência
- • XII Encontro sobre a cultura do Amendoim tem palestras do IEA e das Câmaras Setoriais
- • IZ lança Sumário 2015 e expõe touros e matrizes Nelore na Expogenética
- • Pesquisador do IAC ministrará palestra sobre a importância da saúde do solo para a produção de banana
- • Novas tecnologias para o desenvolvimento do agronegócio sustentável são apresentadas pelo diretor do IAC, em São Pedro
- • Pesquisador do IAC palestra sobre cultivares de amendoim e diversidade de ambientes
- • Preferência dos consumidores de carne de ovinos é apontada em estudo da APTA
- • ITAL conduz estudo inédito tudo para avaliação da segurança microbiológica de mortadelas comercializadas no País sob temperatura ambiente
- • Secretaria de Agricultura Paulista estuda cultivo de garoupa em sistema de recirculação de água
- • Rede Social do Café atinge 15 milhões de acessos
- • Pesquisas com a cultura da pitaya são desenvolvidos pela APTA
- • Cana forrageira com 58% de digestibilidade é destaque do IAC na Agrifam
- • Nova variedade de sorgo-vassoura é apresentada pelo IAC na Agrifam
- • Cultivares de feijão carioca IAC são destaques na Agrifam
- • Algodão de fibra colorida é exposto pelo IAC na Agrifam
- • Híbridos de milho são expostos pelo IAC na Agrifam
- • Pesquisas com controle biológico são apresentadas na Agrifam
- • Instituto Biológico apresenta Prosaf na Agrifam
- • Pesquisador da APTA ministra palestra sobre orgânicos na Agrifam
- • Batatas do IAC-APTA, expostas na Agrifam, possuem elevada qualidade culinária
- • Tecnologia de produção de cogumelos frescos é apresentada pela APTA na Agrifam
- • APTA apresenta na Agrifam tecnologia para produção integrada de peixes e hortaliças
- ► Julho (20)
- • Caviar de truta é resultado de pesquisa da APTA
- • Secretaria de Agricultura analisa Mercado do Segmento de Máquinas Agrícolas Automotrizes
- • PIBIC IZ 2015 abre inscrições para apresentação de propostas
- • 9º Curso IZ sobre Controle da Verminose abordará uso de vacinas contra o verme
- • Secretaria de Agricultura é a única instituição pública do País a produzir rainhas para apicultores de todo o Brasil
- • Pesquisa com larvas de peixes-de-bico da Secretaria tem participação de pescadores esportivos e pesquisadores de universidades
- • Preços Agropecuários apresentam nova alta em junho de 2015
- • Citros de mesa: programa incentivará pequenos e médios produtores a obter melhores resultados
- • Agronegócios: Saldo da Balança Comercial Paulista supera US$ 5 bilhões
- • Vacina no controle de carrapato em bovino é tema do Workshop IZ
- • Secretaria de Agricultura divulga a primeira estimativa de oferta e demanda de milho em 2015
- • Secretaria de Agricultura lança programa Citricultura Nota 10, para incentivar produção de citros de mesa
- • Instituto de Zootecnia completa 110 anos de tecnologia científica agropecuária
- • Secretaria de Agricultura realiza treinamento para manejo da Sigatoka Negra na cultura da banana
- • Pesquisas com cana-de-açúcar visam produtividade de três dígitos
- • Pesquisador da Secretaria de Agricultura dá dicas que diminuem em até 75% a predação de peixes por outros animais
- • Pesquisa inédita da Secretaria de Agricultura alia plantio de café em conjunto com macadâmia
- • Secretaria de Agricultura instala 17 estações meteorológicas automáticas no interior paulista em junho de 2015
- • Secretaria de Agricultura divulga o VPA regional de 2014
- • Secretaria de Agricultura participa do Japan Asian Food
- ► Junho (21)
- • Secretário Arnaldo Jardim transfere o gabinete da Secretaria de Agricultura para o IAC
- • Aproximação da safra brasileira pressiona as cotações da curva futura do café
- • Secretaria de Agricultura (IEA/CATI) apresenta o Valor da Produção Agropecuária Paulista
- • Com esqueleto gigante de baleia, Museu de Pesca une história, educação ambiental e diversão em Santos
- • Secretaria apresenta na Fispal estudo para quebrar preconceitos contra alimentos processados
- • Secretaria de Agricultura divulga 2º levantamento com as previsões e estimativas de safras
- • Em seu 128º aniversário, IAC homenageia comunidade interna e externa
- • Nos 128 anos do IAC, Secretaria de Agricultura assina acordo de cooperação com instituições de Campinas e da França
- • Palavra do Secretário
- • Pesquisador do IZ ministra palestra sobre micotoxinas na suinocultura
- • Secretaria de Agricultura desenvolve software inédito para orientar pulverização
- • Balança comercial dos agronegócios tem saldo de US$ 4,09 bilhões
- • Pesquisas do IAC geram ingredientes para os principais pratos juninos
- • Preços agropecuários: alta de 0,52% em maio
- • Pesquisadores da Secretaria de Agricultura participam de simpósio de cogumelos
- • Secretaria realiza em Campos do Jordão cursos para aumentar produtividade da truta
- • Pesquisa aponta queda no rebanho e na produção de leite na última década
- • Secretaria abre inscrições para curso de produção de peixes em viveiros escavados
- • Palestra da Secretaria de Agricultura discute uso da água na agropecuária
- • Agricultura e (é) sustentabilidade
- • Agronegócios: saldo da balança comercial é de US$ 2,98 bilhões
- ► Maio (18)
- • APTA realiza IX Workshop Agroenergia: Matérias-primas
- • Pesquisa inédita do IAC quantifica impacto do HLB na qualidade de sementes de porta-enxertos de citros
- • Institutos de Pesquisa da SAA-SP recebem grupo de técnicos da República dos Camarões
- • IEA prevê recorde de produção na safra paulista de amendoim
- • IEA analisa o faturamento do setor de defensivos agrícolas em 2014
- • Instituto de Pesca desenvolve técnica para seleção de bactéria probiótica para peixes de água doce
- • Instituto de Pesca realiza IV Workshop de Piscicultura do Noroeste Paulista
- • Secretaria de Agricultura inaugura sala com tecnologia para ver ao vivo dentro de colmeia no Museu do Instituto Biológico
- • Reiteradas vendas pressionam as cotações do café, segundo IEA
- • Último dia para inscrições no curso mestrado do Instituto de Zootecnia
- • APTA realiza treinamento para manejo da Sigatoka Negra na cultura da banana
- • Tecnologia paulista reduz em 30% tempo para criar gado com 21 arrobas
- • Projeto Bioma IZ: uma proposta ambiental" receberá R$ 3 milhões do recurso financeiro do FID
- • Ciclo de seminários IEA discute o uso da água na agropecuária
- • Preços agropecuários apresentam pequena alta no fechamento do mês
- • Governo de São Paulo e ABCZ assinam parceria para difusão de tecnologias da pecuária do IZ
- • Agronegócio: saldo da balança comercial paulista é de US$ 2,47 bilhões
- • IEA discute as perspectivas para o plantio de trigo na safra 2015
- ► Abril (18)
- • APTA Regional tem novo diretor-geral
- • Público poderá participar de oficina práticas do sistema de Mudas Pré-Brotadas de cana
- • Pela primeira vez na Agrishow, APTA apresenta tecnologia que aumenta em 40% o lucro dos produtores de cogumelo
- • Batatas do IAC-APTA, expostas na Agrishow, possuem elevada qualidade culinária
- • Tecnologia da APTA pode reduzir em 95% a quantidade de água usada na produção de peixes e hortaliças
- • IAC lança três novas cultivares de algodão
- • Instituto Agronômico (IAC) lança híbridos de milho e cultivares de algodão na Agrishow 2015
- • Programa Leite Mais será lançado pelo IZ-APTA na Agrishow 2015
- • IZ-APTA lança na Agrishow programa de pesquisa em sistemas de integração
- • Instituto Agronômico realiza evento sobre conservação dos solos
- • Secretário de Agricultura de São Paulo assina protocolo de intenções com a Agência das Bacias PCJ voltado à preservação dos recursos hídricos
- • Delegação de Iowa e Kansas visita o Centro de Bovinos de Corte do IZ
- • Sistema de Integração de lavoura, pecuária e floresta é desenvolvido por pesquisadores da APTA
- • Preços agropecuários sobre 2,06% no fechamento do mês de março
- • IEA promove cursos sobre sistemas agroflorestais
- • Parceria entre Instituto Agronômico e Centro francês já beneficia pesquisas com seringueira
- • Ciclo de seminários IEA aborda a formação socioespacial dos circuitos agropecuários
- • Crise nos empregos do setor sucroalcooleiro se acentua, afirma IEA
- ► Março (15)
- • Ciclo de seminários IEA discute o financiamento do agronegócio
- • IEA discute o uso da água pela agropecuária
- • Pesquisadora do Instituto de Pesca dá dicas de como comprar peixes salgados, frescos, congelados e em conserva
- • IEA é o mais novo polo de ensino PECEGE-Esalq
- • APTA realiza curso teórico e prático de inseminação artificial em búfalas
- • Chuvas melhoram situação para agricultura
- • IEA analisa o Plano Agrícola e Pecuário 2015/16
- • IEA divulga estudo sobre os impactos da variação climática para a produção de cana-de-açúcar
- • Contribuições da pesquisa agropecuária paulista são comentadas por Secretário-adjunto da SAA
- • Agronegócio: saldo da balança comercial paulista é de US$ 1,37 bilhão
- • Preços agropecuários sobem 0,91% em fevereiro, informa IEA
- • Pesquisador do IEA aponta otimismo do mercado futuro do café
- • Programa Cana do Instituto Agronômico tem ação inédita com pequeno produtor
- • IEA discute o mercado de lácteos e as perspectivas para 2015
- • Colheita mecanizada da cana atinge 85% das áreas de produção paulistas
- ► Fevereiro (10)
- • IEA divulga estudo sobre custo de manutenção e rentabilidade dos seringais paulistas
- • Transferência de tecnologia IAC muda perfil de laboratórios privados de análises de solos
- • Pesquisador do IEA aponta mudança de patamar na curva futura do café
- • Relatório Agroambiental do Setor Sucroenergético aponta ganhos ambientais na produção e em processos industriais
- • Instituto de Pesca lança site inédito com informações pesqueiras
- • Agronegócio: exportações paulistas atingem US$ 1,31 bi em janeiro
- • IZ realiza 4º Curso sobre carcaça de ovinos
- • Elas vão invadir sua casa
- • IZ abre inscrição para cursos de prática continuada
- • Agricultura não é a vilã da crise hídrica, afirma pesquisador do IEA
- ► Janeiro (4)
- ► Dezembro (13)
- ► 2014 (142)
- ► Dezembro (17)
- • IEA comenta a cultura da tangerina no Estado de São Paulo
- • Pesquisadores da APTA alinham pesquisas na área de bovinocultura leiteira
- • Café: previsão de safra iea/conab indica crescimento, apesar da estiagem
- • As instituições de pesquisa agropecuária e o novo modelo jurídico
- • Brasil Ingredients Trends 2020 tem versão online gratuita
- • Instituto Biológico bate recorde e aumenta em 34% a produção de imunobiológicos para análise do rebanho nacional
- • Queda de preço do petróleo afeta cotações futuras do café
- • Terceira florada dos cafezais brasileiros eleva as expectativas de colheita
- • Instituto Agronômico faz levantamento sobre a seca em São Paulo
- • IEA divulga estimativa preliminar do VPA por região
- • Preços agropecuários fecham novembro em alta de 1,32%
- • MBA IAC informa sobre coleta de embalagens vazias de defensivos agrícolas
- • VPA: A Geografia da Agricultura Brasileira em 2012
- • IAC lança site sobre solos paulistas no Dia Mundial dos Solos
- • Abelhas sem ferrão são nova atração do Planeta Inseto, no Instituto Biológico
- • Ciclo de seminários IEA discute o futuro da produção familiar de leite no Brasil
- • Destinação de embalagens vazias de defensivos agrícolas é tema de aula inaugural do MBA em Fitossanidade no IAC
- ► Novembro (16)
- • IEA divulga prévia do valor da produção agropecuária
- • Pesquisadora do IEA discute a agricultura urbana e a aprovação do novo plano diretor do município de São Paulo
- • Pesquisador da APTA será homenageado como Agrônomo do Ano em Ribeirão Preto
- • Alunos e docentes do IZ participam de workshop para capacitação em artigos científicos
- • Agricultura familiar é tema de workshop nos 72 anos do IEA
- • Incremento dos embarques e retorno das precipitações esfriam as cotações futuras, avalia IEA
- • Evento sobre agricultura familiar marca os 72 anos do IEA
- • Projeto da APTA será apresentado em congresso de gestão pública
- • Instituto de Pesca desenvolve banco de dados sobre pesca amadora
- • Pesquisador do ITAL é homenageado pela Associação Brasileira de Automação
- • Ciclo de seminários IEA discute o trabalho e a renda na cultura do limão
- • Preços agropecuários sobem 1,94% em outubro
- • Biotecnologia em pesquisas com truta tem apoio da FAPESP
- • Previsão de safra agrícola: estiagem deixa suas marcas, alerta IEA
- • Instituto Agronômico (IAC) vence Prêmio Finep no Sudeste brasileiro
- • APTA promove curso de capacitação em arborização e pastagem
- ► Outubro (20)
- • Pesquisadoras avaliam o banco CEAGESP de alimentos
- • Estudantes visitam Unidade de Pesquisa da APTA de Jaú
- • Instituto Biológico realiza 27ª reunião anual
- • APTA apresenta sistema de cultivo que integra produção de lambari com hortaliças
- • Instituto Agronômico estuda feijão resistente ao estresse hídrico
- • Indicação geográfica: pesquisadora do IEA apresenta panorama da legislação e registro no Brasil
- • Ciclo de seminários IEA discute a análise em sistemas agrários
- • Bem-estar de animais de Produção é tema do 5º ECPAS do IZ
- • Preços agropecuários fecham setembro em alta de 0,88%
- • ITAL inicia novo estudo da Série Trends 2020 no Dia Mundial da Alimentação
- • Agronegócios: saldo da balança comercial paulista é de US$ 9,13 bilhões
- • AGRONEGÓCIOS: saldo da balança comercial atinge us$ 8,03 bilhões
- • IAC participa da Semana Nacional e Municipal de Ciência e tecnologia
- • Mestrado IZ abre inscrições para processo Seletivo para 1º semestre 2015
- • IEA aponta padrão volátil na curva futura das cotações do café
- • Setor agropecuário reduz a emissão de gases de efeito estufa
- • Agronegócios: saldo da balança comercial atinge US$ 11,09 bilhões
- • Pesquisadores do IEA avaliam o emprego formal agropecuário em SP
- • Estiagem antecipa em dois meses suplementação alimentar para animais
- • Pesquisadora da APTA será agraciada como agrônoma do ano em Bauru
- ► Setembro (8)
- • A organização dos agricultores para defender as feiras orgânicas de São Paulo
- • ITAL promove 4ª Semana Tecnológica
- • Preços agropecuários fecham agosto em alta de 0,99%
- • Pesquisador do IEA analisa a curva futura das cotações do café
- • APTA realiza II Seminário sobre Manejo Estratégico de Pragas Exóticas
- • IEA divulga a segunda estimativa de oferta e demanda de milho no estado de São Paulo
- • APTA participa de tecnologia inovadora na reprodução de búfalos
- • Produção e vendas de máquinas agrícolas em queda, afirma IEA
- ► Agosto (7)
- • Pesquisadores do IEA preveem novo recorde de vendas de fertilizantes em 2014
- • Pesquisa da APTA aumenta em 50% a produtividade das lavouras de batata-doce de Presidente Prudente
- • ITAL abre inscrições para Pós-Graduação em Ciência e Tecnologia de Alimentos
- • Preços agropecuários sofrem queda de 2,72% em julho
- • Setor sucroalcooleiro diminui as contratações formais
- • Previsões e estimativas de safras agrícolas: IEA divulga o terceiro levantamento
- • Atlas Socioambiental da Bacia do Ribeirão das Anhumas é lançado nesta quinta, 7, no Instituto Agronômico
- ► Julho (6)
- • Preços agropecuários fecham o mês de junho em queda de 3,47%
- • TRIGO: São Paulo pode ter a maior produção dos últimos 10 anos
- • Curva futura das cotações do café: arábica estável e robusta em alta
- • Agronegócio: Balança comercial paulista fecha o semestre com superávit de us$ 5,87 bilhões
- • Centro de Engenharia e Automação do IAC comemora 45 anos com Palestras Técnicas
- • Governador Alckmin entrega obras de restauro do Museu de Pesca de Santos
- ► Junho (15)
- • Panorama da suinocultura no Estado de São Paulo
- • Instituto Agronômico comemora 127 anos com resultados inovadores
- • Energia e pujança marcam geração e transferência de tecnologias canavieiras pelo Programa Cana IAC
- • IEA aponta reversão nas expectativa na curva futura das cotações do café
- • Técnico de Moçambique visita o IAC para conhecer tecnologia de propagação de batatas
- • Trabalho do IAC em micronutrientes em cana é premiado com o TOP Etanol, na categoria inovação tecnológica
- • Instituto de Pesca inaugura Centro de Pesquisa do Pescado Continental, em São José do Rio Preto
- • Capim Piatã é foco de painéis do IZ na Zootec 2014
- • Agronegócio: saldo da balança comercial paulista supera US$ 4,7 bilhões
- • Trabalhos científicos do IAC têm impacto positivo na área agrícola e em todas as modalidades científicas
- • Pesquisadores chegam ao sequenciamento do genoma citros
- • Turismo rural é mais uma opção para o visitante durante a Copa
- • Secretaria de Agricultura lança a primeira semente orgânica de milho do Brasil
- • Centro de Citricultura do IAC realiza o maior evento citrícola do Brasil
- • Mercado mundial terá mais soja, segundo IEA
- ► Maio (16)
- • Pesquisadora do Instituto Agronômico irá receber Prêmio Miklos Faust para Jovens Pomologistas
- • Cotações futuras do café tendem a estabilidade, informa IEA
- • Instituto Agronômico monitora condições de seca no Estado de São Paulo
- • IEA passa a oferecer a usuários banco de legislação online
- • IZ realiza II Workshop sobre Prova de Ganho de Peso
- • Pesquisador do IEA ministra palestra sobre como o clima está afetando o mercado e a produção de café
- • Evento da APTA sobre limão Tahiti reúne 125 pessoas em Pindorama, interior paulista
- • Pesquisadores da APTA ministram palestra sobre criação de peixes em represas
- • SP: saldo da balança comercial do agronegócio é de US$ 3,74 bilhões
- • Controle do carrapato-do-boi é tema de Workshop no IZ
- • IEA divulga a segunda estimativa de safra cafeeira
- • APTA participa da 47ª Expo Fernandópolis
- • Preços agropecuários fecham o mês de abril em alta
- • Evento no cafezal urbano do Instituto Biológico marca início da colheita do café em São Paulo
- • Transferência de tecnologia marca inauguração do Centro de Seringueira e Sistemas Agroflorestais do IAC
- • IEA divulga o valor da produção agropecuária por região
- ► Abril (13)
- • Governador de São Paulo visita estande com tecnologias paulistas na Agrishow
- • APTA gera R$ 11,80 para a sociedade a cada R$ 1,00 que recebe para pesquisa
- • APTA apresenta sistema inédito de cultivo hidropônico com produção intensiva de peixes na Agrishow
- • Instituto de Zootecnia expõe na Agrishow sistema de produção de ovinos que pode aumentar em seis vezes a renda do produtor
- • Instituto Agronômico expõe pacotes tecnológicos na Agrishow
- • APTA apresenta na Agrishow batata orgânica com alta produtividade e qualidade culinária
- • Valor da produção agropecuária paulista supera R$ 57,7 bilhões
- • Milho é tema do painel apresentado pelo IEA
- • Agronegócios: saldo da balança comercial paulista atinge US$2,7 bilhões
- • Integração lavoura-pecuária-floresta é tema de palestra no VI Seminário de Conservação do Solo e Proteção de Recursos Naturais
- • Preços agropecuários sobem 5,74% no fechamento do mês de março
- • APTA recebe suplementação orçamentária do Governo do Estado de São Paulo
- • IAC inaugura biofábrica de cana-de-açúcar capaz de produzir 4 milhões de mudas por ano
- ► Março (2)
- ► Fevereiro (11)
- • Pesquisadores do IEA avaliam os efeitos da falta de chuva sobre as lavouras paulistas
- • Projeto Ambicana gera ganhos de 20,4 milhões de toneladas de cana na região Centro-Sul
- • IZ divulga nova linha de pesquisa
- • IAC contribui para qualificar análises de solos no setor privado
- • Preços agropecuários fecham janeiro em alta de 0,23%
- • Pesquisador do IAC da área de climatologia é agraciado com Medalha Defesa Civil
- • Safra 2013/14: área plantada com grãos cresce 1,71% em São Paulo
- • Pesquisadora do IAC é agraciada no 1º Concurso Frederico de Menezes Veiga, realizado pela Embrapa
- • ITAL divulga calendário de eventos de 2014
- • IZ comercializa bovinos machos e fêmeas
- • Cogumelo Shiitake é tema de eventos realizados pela APTA
- ► Janeiro (11)
- • APTA recebe trabalhos técnico-científicos para o IX Workshop Agroenergia: Matérias-primas
- • Expedição técnico-científica é criada para fazer levantamento da Helicoverpa armigera
- • Calendário 2014 da Pós graduação do IZ
- • Alunos do Curso de Prática Continuada em Zootecnia e do Mestrado do IZ participam de visita técnica na CRVLagoa
- • Instituto Biológico realiza pesquisa sobre os impactos do uso de herbicidas nos peixes
- • Agronegócios: saldo da balança comercial paulista supera US$ 20 bilhões
- • Preços agropecuários em São Paulo: alta de 0,47% em dezembro e de 12,34% em 2014
- • Pesquisadoras do IZ participaram de curso sobre ecofisiologia de pastagens
- • IZ sedia a reunião da diretoria da ABRAVES SP
- • Pesquisadora do IP é uma das autoras de livro sobre qualidade e processamento de pescado
- • Santa Catarina quintuplica área de produção de maracujá com tecnologias IAC
- ► Dezembro (17)
- ► 2013 (191)
- ► Dezembro (8)
- • Instituto de Pesca tem resultados inéditos em cultivo de peixes marinhos
- • Laranja: safra paulista atinge 286,4 milhões de caixas
- • Agronegócios: cresce o saldo da balança comercial paulista
- • IAC realiza evento sobre fitossanidade em Agudos
- • Encontro promovido pela APTA reúne cadeia produtiva da noz macadâmia
- • Centro de Seringueira e Sistemas Agroflorestais é a nova unidade do Instituto Agronômico
- • Instituto de Pesca inova na taxidermia
- • IZ difunde tecnologia científica em dois grandes eventos brasileiros
- ► Novembro (12)
- • APTA estuda método de cultivo de amoreira que pode revolucionar a produção do bicho-da-seda no Brasil
- • SP: Valor da produção agropecuária deve superar R$ 57,1 bilhões
- • Instituto Biológico está credenciado pelo MAPA para fazer diagnósticos da Helicoverpa armigera
- • IZ vende bovinos nelores e mestiços
- • Agronegócios: saldo da balança comercial paulista ultrapassa US$ 12 bi
- • Novas cultivares de cana IAC têm alto teor de sacarose e mantêm alta produtividade durante toda a safra
- • IZ expõe tecnologias em bovinocultura de leite e ovinocultura na Interlactea
- • APTA transfere informações sobre agregação de valores em horticultura
- • Abertas as inscrições para o I Seminário de Manejo Estratégico de Pragas Exóticas, realizado pela APTA
- • Pesquisadores do IEA avaliam o potencial de geração de bioeletricidade através do bagaço da cana-de-açúcar
- • 26ª Reunião Anual do Instituto Biológico debate a sanidade no agronegócio
- • IZ participa do Simpósio Internacional em Coturnicultura
- ► Outubro (20)
- • Pesquisadores cubanos visitam unidade de pesquisa da APTA
- • ITAL reúne nutricionistas de todo o País em Seminário de Alimentação Escolar
- • IAC tem mais dois Centros de pesquisa credenciados junto à ANP
- • Pesquisadora do Instituto de Zootecnia participa do 2º encontro do CREA-SP
- • Pesquisa da APTA e USP com leite funcional aumenta em 160% os níveis de selênio e 33% de vitamina E nas crianças
- • Instituto de Zootecnia tem nova diretoria
- • APTA realiza curso de análise sensorial do azeite e harmonização de pratos
- • IAC faz descoberta inédita em citros
- • Unidades de pesquisas da APTA vencem Prêmio Josué de Castro
- • Agronegócios: balança comercial paulista tem superávit de US$ 11,36 BILHÕES
- • IAC abre inscrições para a Pós-Graduação em Agricultura Tropical e Subtropical
- • Secretaria de Agricultura apresenta novos projetos do Instituto de Pesca
- • Preços agropecuários encerram mês de setembro em alta
- • APTA leva pesquisa inédita no Estado de São de Paulo para simpósio internacional
- • Referência em orgânicos, Unidade de pesquisa da APTA muda de nome para atender pedido de produtores
- • Encontro discute perspectivas do mercado fungicultor
- • IZ realiza 4º Encontro Científico de Produção Animal Sustentável
- • Novidades no site do IEA: pesquisa por cadeias
- • Professor da Universidade de Havana visita o IZ e dá palestra na PG
- • APTA apresenta tecnologia inédita de indução na reprodução do lambari que pode aumentar a produção em 80%
- ► Setembro (21)
- • Projeto do Instituto de Pesca, em Cananéia, ganha laboratório multifuncional com apoio da FAPESP
- • IZ abre inscrições para o mestrado
- • ITR: proprietários de terra podem consultar valores no site do IEA
- • Centenário de nascimento do maior pesquisador de café do mundo
- • Início da primavera é celebrado com plantio de árvores em Unidade de Pesquisa da APTA
- • Animal do Instituto de Zootecnia é pai do touro Backup recordista mundial de venda de sêmen
- • Inscrições para processo seletivo de mestrado do IZ começa em 1º de outubro
- • ITAL será homenageado na ALESP
- • Saldo da balança comercial dos agronegócios paulista sobe 19% e supera US$ 10 bilhões
- • Ciclo de seminários IEA analisa o custo de produção de cana-de-açúcar no Estado de São Paulo
- • Levantamento de safra do café em São Paulo registra queda de 10,1% na produção
- • APTA discute os principais problemas e as novas técnicas de cultivo do maracujá
- • Preços Agropecuários fecham o mês de agosto em alta
- • APTA realiza minicurso para o cultivo de mandioca destinada à indústria
- • Pesquisador da APTA participa do V Congresso Internacional sobre Anonáceas
- • Pesquisador do IAC alerta para período de semeadura do trigo
- • Pesquisadores do IEA discutem a evolução na agropecuária paulista e a implantação da legislação ambiental
- • Viticultura artesanal: pesquisadores do IEA apresentam estudo de caso
- • São Paulo é o Estado brasileiro com mais informações climáticas graças ao banco de dados do IAC
- • Pesquisadores do IEA analisam o VPA do Brasil por UF
- • ITAL completa 50 anos de apoio ao setor de alimentos, ao agronegócio e para a sociedade
- ► Agosto (14)
- • Proposta do Instituto de Pesca sobre destino de resíduos sólidos da atividade pesqueira é a mais votada na IV Conferência Regional do Meio Ambiente da Baixada Santista
- • Ciclo de seminários IEA avalia o projeto de subvenção ao prêmio do seguro rural
- • 15 bolsistas de instituições de pesquisa da APTA são premiados em Campinas
- • Pesquisa inédita da APTA mostra novos cultivares para a produção de pasta de alho
- • Preços agropecuários sobem 0,35% no fechamento de julho
- • Balança comercial dos agronegócios sobe 20,4% e saldo supera US$ 8 bilhões
- • Instituições de pesquisa da região apresentam projetos de ciência e inovação desenvolvidos por alunos bolsistas, em evento
- • IEA/CONAB divulgam a segunda estimativa da safra da laranja
- • APTA desenvolve produto tipo caviar de truta
- • Manejo de nutrientes na citricultura pode prolongar produção e reduzir severidade de doenças
- • Três universidades assinam convênio de estágio com IZ
- • IZ participará da Expogenética 2013 em Uberaba - 17 a 25/8/2013
- • Pesquisadora do IEA apresenta palestra na Agrifam
- • APTA apresenta tecnologias paulistas na Agrifam 2013
- ► Julho (12)
- • Ciclo de seminários IEA discute a evolução da agropecuária paulista e a nova
- • Dia do Agricultor: IEA participa das comemorações no parque da Água Branca
- • Produtores de Cogumelos podem aumentar renda em até 40%
- • Entressafra pressiona os peço do leite em São Paulo
- • Laboratório de Bromatologia de Bastos recebe nova ala
- • Balança comercial dos agronegócios paulista fecha o semestre com saldo superior a US$ 7 bilhões
- • IZ comemora 108 anos com integração e transparência na geração de tecnologia científica agropecuária
- • ITAL: 50 anos de apoio ao setor de alimentos em benefício da sociedade
- • Palmito pupunha é uma alternativa de cultivo para produtores do Vale do Ribeira
- • Clones de seringueira do IAC começam a produzir látex em cinco anos quando o comum são sete
- • Algodão IAC 26 RMD foi apresentado na Agrishow 2013
- • IZ participou da Feicorte 2013
- ► Junho (16)
- • Instituto Agronômico (IAC) chega a cultivar de número mil
- • Mercado atacadista: IEA inclui novos produtos no boletim diário de preços e no levantamento mensal
- • IEA informa: salários rurais de abril já estão disponíveis no site
- • Projeto São Paulo Orgânico promove quinto curso de capacitação
- • Ciclo de seminários IEA discute a evolução na agricultura orgânica em São Paulo
- • APTA realiza o XXV Seminário Nacional de Cebola
- • Termina no dia 30 de junho de 2013 o prazo para as pré-inscrições no MBA em Fitossanidade IAC-ANDEF
- • IZ participa da Tecnotour com o tema ILPF
- • IZ participa da Feicorte 2013
- • Pesquisadores do IZ participaram da Zootec 2013
- • Preços agropecuários fecham o mês de maio em queda de 3,62%
- • Tecnologia inédita da APTA reduz em 30% a ocorrência da podridão nas pupunheiras
- • Secretaria de Agricultura promove encontro temático de Indicação Geográfica
- • IZ avalia o capim paraíso para a produção de feno
- • IZ terá Programa Institucional de Bolsas de Iniciação Científica
- • APTA mostra experimento inédito com cana-de-açúcar durante evento de agroenergia, em Ribeirão Preto
- ► Maio (26)
- • Pesquisador do IEA participa de evento internacional sobre café
- • Inscrições com desconto para o VII Workshop Agroenergia: Matérias-Primas vão até 30 de maio
- • São Paulo exporta laboratórios móveis para promover o diagnóstico sanitário animal
- • Pesquisadora do IAC ministra palestra sobre Certificações do Café no 2º Seminário Técnico do Serra Café
- • Café: pesquisador do IEA participa de eventos relacionados ao produto
- • Sabor da Colheita dá início à safra dos cafezais paulistas
- • Pesquisador da APTA ministra minicurso para ensinar produtores rurais e técnicos da área a classificar o grão e a bebida do café
- • IEA pesquisa a evolução do pagamento de empreita nas colheitas das principais culturas do Estado de São Paulo
- • Delegação de dinamarqueses visita o Brasil para conhecer pesquisas da APTA em aquicultura
- • IAC divulga resultados das pesquisas de milho na região paulista do Médio Paranapanema
- • Ciclo de seminários IEA foca o pagamento de empreita nas colheitas das principais culturas do Estado de São Paulo
- • APTA conquista 724 inserções na imprensa em 2012 os espaços custariam quase 2,6 milhões, caso fossem pagos
- • APTA investe mais de R$ 8,3 milhões em 2012 em serviços de engenharia em Unidades de Pesquisa
- • Percevejo na cama é uma praga reemergente
- • APTA apresenta pesquisa inédita sobre o comportamento parasitológico em bovinos criados no sistema de integração lavoura-pecuária-floresta
- • Quebra-vento é destaque do VIII Dia de Campo de Tangerina
- • Delegação do Sudão visita IZ em Nova Odessa e Sertãozinho
- • IEA divulga o valor da produção agropecuária por região
- • Porta-enxertos respondem por segurança fitossanitária e período de colheita de citros
- • IAC realiza o VII Dia de Porta-enxerto
- • Valor da produção agropecuária e florestal do Estado de São Paulo supera R$ 60 bilhões em 2012
- • Diretoria mundial da John Deere visita experimentos de cana do IAC
- • Livro sobre os 75 anos da Unidade de Pesquisa e Desenvolvimento da APTA de Jaú é lançado na cidade
- • IEA-APTA discutiu sistema e custos de produção de cana durante a Agrishow
- • 5ª Semana de Citricultura destaca as adversidades da cultura
- • IEA prevê uma boa safra para a cana-de-açúcar, café e grãos
- ► Abril (19)
- • Coordenador da APTA participa da Agrishow há 20 anos
- • IAC desenvolve sistema inédito que muda o conceito de plantar cana
- • ITAL apresentou exemplos de inovação tecnológica para o setor de alimentos
- • IAC expôs pela primeira vez na Agrishow material de triticale 6% mais produtivo e com redução de 60% na aplicação de defensivos agrícolas
- • Nova variedade de amendoim IAC com alto teor de ácido oleico foi apresentada na Agrishow 2013
- • Antúrios mais cultivados no Brasil foram expostos na Agrishow
- • PREÇOS AGROPECUÁRIOS FECHAM A SEGUNDA QUADRISSEMANA DE ABRIL EM ALTA
- • Pesquisadores do Instituto de Pesca contribuem para o crescimento do agronegócio do pescado
- • Reunião Científica do Instituto de Pesca discute pesca amadora e esportiva
- • BALANÇA COMERCIAL DOS AGRONEGÓCIOS TEM SALDO DE US$ 3,30 BILHÕES
- • Prorrogadas as inscrições de trabalhos técnicos para o VII Workshop Agroenergia realizado pela APTA
- • PRESENÇA JAPONESA EM SOLO PAULISTA
- • SP: saldo da balança comercial dos agronegócios sobre 67,9% e atinge US$ 4,5 bilhões
- • São Paulo Orgânico promove curso de capacitação
- • Instituto de Pesca completa 44 anos e realiza XI Reunião Científica
- • Prorrogadas as inscrições para o VIII Workshop Agroenergia: Matérias-primas, realizado pela APTA
- • PREÇOS AGROPECUÁRIOS MANTÊM TENDÊNCIA DE ALTA NO FECHAMENTO DO MÊS DE MARÇO
- • MBA em Fitossanidade IAC-ANDEF abre pré-inscrições
- • IZ vende bovinos leiteiros
- ► Março (11)
- • Pesquisadora da APTA dá dicas de como comprar peixes salgados, frescos, congelados e em conserva
- • IAC tem novo Diretor-geral
- • Única unidade do Brasil com pesquisas em truticultura tem infraestrutura melhorada
- • PESQUISADORES DO IEA PARTICIPAM DE EVENTO NA ALESP EM DEFESA DA AGROECOLOGIA
- • PREÇOS AGROPECUÁRIOS SOBEM 2,01% NA SEGUNDA QUADRISSEMANA DE MARÇO
- • Saldo da balança comercial dos agronegócios é de US$ 2,10 bilhões no primeiro bimestre de 2013
- • IZ realiza II Curso prático sobre Carcaça de Ovinos
- • IZ realizará projetos com análise computadorizada do sêmen
- • Pesquisa do IAC comprova que quanto mais tempo a planta de citros permanece infectada com o HLB, maior será eficiência na aquisição da bactéria pelo inseto vetor, o psilídeo
- • PREÇOS AGROPECUÁRIOS FECHAM O MÊS DE FEVEREIRO EM ALTA
- • Pesquisa da APTA com aplicação do lodo de esgoto e composto orgânico diminui em até 60% dos custos com fertilizantes na cana e aumenta produtividade e a vida útil do canavial
- ► Fevereiro (14)
- • CICLO DE SEMINÁRIOS ESTUDOS IEA DISCUTE O CÓDIGO FLORESTAL
- • PREÇOS AO PRODUTOR: ALTA DE 0,85% NA TERCEIRA QUADRISSEMANA DE FEVEREIRO
- • IV Simpósio Brasileiro de Pós-Colheita abre inscrição para trabalhos a serem apresentados
- • Curso de Mestrado do Instituto de Pesca abrirá inscrições em 4 de março
- • 4º Encontro de Produtores e Dia de Campo de Amendoim reuniu cerca de 200 pessoas no Polo Centro Norte/APTA Regional
- • PREÇOS AGROPECUÁRIOS FECHAM A SEGUNDA QUADRISSEMANA DE FEVEREIRO EM QUEDA
- • Instituto de Pesca participa de campanha internacional para retirada de petrechos do mar, em Itanhaém
- • SP: SALDO DA BALANÇA COMERCIAL DOS AGRONEGÓCIOS SUPERA US$ 1 BI EM JANEIRO DE 2013
- • Estão abertas as inscrições de trabalhos técnicos e científicos para o VII Workshop Agroenergia realizado pela APTA
- • Unidade Sede do Polo Sudoeste Paulista/APTA Regional completa 70 anos de pesquisas
- • PREÇOS AGROPECUÁRIOS ENCERRAM JANEIRO EM QUEDA DE 0,24
- • IEA DIVULGA PREVISÃO DA ATUAL SAFRA AGRÍCOLA E O LEVANTAMENTO FINAL 2011/12
- • IAC realiza workshop com o Ministério do Trabalho sobre as novas normas de Equipamentos de Proteção Individual (EPI
- • Preços agropecuários mantêm tendência de alta
- ► Janeiro (18)
- • Alunos de mestrado do IZ defendem dissertações nas áreas de ovinos, leite e forragicultura
- • IAC e APTA Regional apresentam cinco inovações na 7.ª Coopershow
- • Mais de 300 equídeos já receberam marcação a frio na APTA Alta Mogiana
- • Preços agrícolas sobem 0,87% na segunda quadrissemana de janeiro
- • ITAL vai oferecer 52 eventos ao público em 2013
- • Óleo de linhaça fornecido a bovino pode ajudar na prevenção de doenças além de reduzir colesterol na carne
- • Alunos do Pós-Graduação do IZ começam a defender dissertações de mestrado
- • Produtores capacitados já instalam hortas orgânicas rurais e periurbanas
- • CANA SEGURA ALTA NOS PREÇOS AGROPECUÁRIOS PAULISTAS EM 2012
- • Mais de 60 mil pessoas visitaram o Planeta Inseto do Instituto Biológico em 2012
- • Pesquisador do IAC ministra curso no Rio de Janeiro sobre preservação de nascentes
- • ITAL lança versão digital de livro sobre 50 anos da história do Instituto e da indústria de alimentos no País
- • SP: Saldo da balança comercial dos agronegócios supera US$ 12 bilhões
- • Café: São Paulo deverá colher entre 4 e 4,7 milhões de sacas na safra 2013
- • Preços agrícolas sobem 2,19% em dezembro de 2012
- • Fundação Educacional de Ituverava assina convênio de estágio com IZ
- • Sardinha-verdadeira lidera pescado descarregado na costa paulista
- • IZ assina convênios de estágios com universidades brasileiras
- ► Dezembro (8)
- ► 2012 (237)
- ► Dezembro (16)
- • Preços agrícolas sobem 2,23% na terceira quadrissemana de dezembro
- • APTA recebe mais de R$ 7,2 milhões de suplementação orçamentária para serviços de engenharia
- • Preços agrícolas fecham segunda quadrissemana de dezembro em alta
- • São Paulo revela os melhores cafés gourmet produzidos no Estado
- • SP: SALDO DA BALANÇA COMERCIAL DOS AGRONEGÓCIOS SUPERA US$ 11 BILHÕES
- • PREÇOS AGROPECUÁRIOS SOBEM 0,31% NA PRIMEIRA QUADRISSEMANA DE DEZEMBRO
- • Pesquisador do IZ no "2º Simpósio Internacional em Sistemas de Integração Lavoura Pecuária 2012
- • Tecnologia IAC para produção de material de propagação de batata conquista norma de certificação oficial
- • Valor da produção agropecuária e florestal: IEA divulga dados regionais da estimativa preliminar 2012
- • Ovinos: IZ faz parceria com Universidade do RJ e Instituto Federal do ES
- • Tecnologia de cultivo orgânico da APTA pode aumentar em até seis vezes a produtividade do tomate
- • PREÇOS AGROPECUÁRIOS FECHAM NOVEMBRO EM QUEDA DE 1,58%
- • APTA inaugura Sala para Processamento Mínimo de Vegetais e moderniza cinco Laboratórios em Bauru, em 7 de dezembro
- • Novo livro aborda etapas do diagnóstico dos principais patógenos de plantas
- • Secretaria de Agricultura comemora 75 anos de unidade de pesquisa de Jaú
- • Leilões de gado da APTA em Ribeirão Preto e Sertãozinho
- ► Novembro (23)
- • Preços agrícolas fecham em queda pela quarta quadrissemana consecutiva
- • Eventos discutem extensão pesqueira na costa Sul-Sudeste e rede solidária da pesca
- • Cana-de-açúcar: dois projetos do IAC são aprovados pela FAPESP e ETH Bioenergia
- • Aos 85 anos, Biológico realiza cerca de 450 exames diários com mais sensibilidade e segurança nos resultados
- • Preços agropecuários fecham a segunda quadrissemana de novembro em baixa
- • Intenção de plantio da safra agrícola paulista 2012/13: aumento de 5,2% na área de grãos
- • Fertirrigação do cafeeiro: desafio é obter doses ideais de nutrientes e melhores formas de aplicação
- • Laboratório de Nutrição Animal, uma das novas instalações do IZ inauguradas em Sertãozinho
- • Pesquisas em desenvolvimento na APTA reforçam selênio e vitamina E na alimentação de vacas lactantes e dobram nutrientes no leite
- • APTA Regional e IAC promovem oficina sobre qualidade e uso do solo, no Médio Paranapanema
- • PREÇOS AGROPECUÁRIOS: QUEDA DE 2,84% NA PRIMEIRA QUADRISSEMANA DE NOVEMBRO
- • Laboratório de Nutrição Animal será uma das três novas instalações do IZ inauguradas em Sertãozinho
- • Governo do Estado de São Paulo lança Via Rápida Ambiental da Aquicultura
- • BALANÇA COMERCIAL DO AGRONEGÓCIO PAULISTA: SALDO ULTRAPASSA 10 BILHÕES DE DÓLARES
- • Secretaria entrega dois novos laboratórios e um modernizado do Instituto Biológico, em Campinas
- • HOMENAGENS E PALESTRA MARCAM O 70º ANIVERSÁRIO DO INSTITUTO DE ECONOMIA AGRÍCOLA
- • PREÇOS AGROPECUÁRIOS REGISTRAM QUEDA DE 1,90% NO MÊS DE OUTUBRO
- • Laboratório de referência internacional em citros recebe nome da pesquisadora Victoria Rossetti
- • IEA: 70 ANOS AJUDANDO A CONSTRUIR E COMPREENDER A AGRICULTURA PAULISTA
- • Reunião técnica anual sobre milho safrinha acontece no município de Assis
- • Polo Centro-Norte/APTA Regional realiza encontro para discutir ações do projeto Bacia Hidrográfica: um instrumento de educação
- • AGROECOLOGIA: IEA PARTICIPA DO FÓRUM PAULISTA E DO ENCONTRO DA APA EM SOROCABA
- • Instituto Biológico comemora 85 anos, em solenidade de abertura da 25ª RAIB
- ► Outubro (30)
- • PREÇOS AGROPECUÁRIOS SOFREM QUEDA DE 0,83%, INFORMA IEA
- • PESQUISADOR DO IEA PARTICIPA DE EVENTO NA CÂMARA BRASIL-ISRAEL
- • Reunião Anual do Instituto Biológico (RAIB) comemora 25 anos, com 16,8 mil trabalhos de 5.090 autores
- • Valor da produção agropecuária e florestal deve atingir R$ 58,7 bilhões, informa IEA
- • Livro com contribuição de pesquisadoras da APTA Regional e do IP fica em segundo lugar no Prêmio Jabuti 2012
- • PREÇOS AGROPECUÁRIOS SOBEM 0,87% NA SEGUNDA PRÉVIA DE OUTUBRO
- • IAC e APTA Regional colaboram em pesquisa de sustentabilidade da cana-de-açúcar
- • PESQUISADORAS DO IEA APRESENTAM TRABALHOS NO XXII CONGRESSO BRASILEIRO DE FRUTICULTURA
- • SECRETARIA EXPÕE SUAS AÇÕES EM EVENTO DA FAO, NESTA SEXTA
- • Campo Limpo Paulista ganha prêmio de campeão em preservação e gerenciamento de recursos hídricos, com apoio do IAC
- • Agricultura orgânica é tema de Workshop no IEA
- • Projeto com colaboração da APTA será agraciado com o Prêmio Josué de Castro, hoje, 16 de outubro
- • Com biscoito à base de pescado, Instituto de Pesca ganha Prêmio Josué de Castro
- • Preços agropecuários sobem 1,43% na primeira quadrissemana de Outubro
- • SP: Saldo da Balança Comercial dos Agronegócios é de US$ 8,75 bilhões
- • Pesquisadora da APTA contribui com livro finalista ao Prêmio Jabuti 2012
- • Custo de produção de morango orgânico é de R$ 18.967,04, inferior ao do cultivo convencional
- • Secretaria de Agricultura participa da 55ª Semana Luiz de Queiroz, em Piracicaba
- • IEA recebe homenagem durante as comemorações da Semana Luiz de Queiroz, em Piracicaba (SP)
- • Concentrado protéico de soja pode substituir farinha de peixe em rações para tilápia
- • Palestras sobre sanidade em agricultura familiar reuniram em setembro cerca de 100 pessoas entre produtores e técnicos
- • Preços agropecuários fecham Setembro com alta de 1,44%
- • Cafezal em flor no coração da cidade de São Paulo
- • Ministra alemã em visita ao ITAL da Secretaria de Agricultura e Abastecimento do Estado
- • IZ realiza o 3º Encontro Científico de Produção Animal Sustentável
- • IEA expõe suas atividades no Parque da Água Branca, capital paulista
- • Curso em DVD sobre reprodução artificial de lambari é lançado por APTA Regional e ABRACOA
- • Preços agropecuários continuam em alta, de acordo com IEA
- • Bem estar animal: pesquisador inglês ministra palestra na sede do IZ, em Nova Odessa
- • Preços agropecuários: alta de 2,19% na segunda quadrissemana de setembro
- ► Setembro (14)
- • IAC realiza exposição no parque da Água Branca, em São Paulo, e apresenta ao público 16 tipos de sementes desenvolvidas pelo Instituto
- • CONCURSO DE QUALIDADE DE CAFÉ LEVA O NOME DE PESQUISADOR DO IEA
- • Projeto de educação ambiental desenvolvido pela APTA é agraciado pela quarta vez no Diálogo de Interbacias
- • PREÇOS AGROPECUÁRIOS: ALTA DE 2,46% NA PRIMEIRA QUADRISSEMANA DE SETEMBRO
- • IZ realiza venda de bovinos provenientes do melhoramento genético de Sertãozinho
- • Semana tecnológica vai apresentar cursos e seminário na área de Bakery & Confectionery
- • Mais de 900 toneladas de pescado foram descarregadas em maio, em SP
- • Exportações do agronegócio paulista atingem US$ 13,38 bilhões no período janeiro-agosto
- • IB tem, pela primeira vez, representante em entidade internacional de buiatria, que cuida de tratamento bovino
- • Evento busca conscientizar os consumidores sobre a qualidade dos azeites e discute o cultivo da oliveira em SP
- • Leste paulista realiza 5º Concurso do Café de Amparo e Região do Circuito das Águas
- • Preços agrícolas sobem 2,66% em agosto e 5,56% no acumulado de 12 meses
- • Seminário no ITAL discute tendências e desafios da tecnologia de pós-colheita em frutas
- • Produtores poderão adotar no médio prazo policultivo de tilápias em tanque-rede e camarões livres
- ► Agosto (18)
- • Preços agropecuários: alta de 2,38% na terceira quadrissemana de agosto
- • Nova variedade IAC de triticale será lançada em Reunião Técnica de Cereais de Inverno
- • Café: safra paulista deverá crescer 33,8%, para 5,24 milhões de sacas beneficiadas, diz IEA
- • Instituições governamentais e particulares lançam projeto de educação sanitária em citros
- • Pesquisadora do IZ fala sobre pastagens consorciadas, durante evento no Recife (PE)
- • Preços agrícolas: alta de 1,32% na segunda quadrissemana de agosto
- • Biológico promove Congresso de Iniciação Científica em SP; 18 premiados em Congresso de Jaguariúna
- • ITAL no Parque da Água Branca: informações sobre alimentos e embalagens e degustações
- • 29º Congresso Nacional de Milho e Sorgo, em Água de Lindóia (SP)
- • Preços agrícolas sobem pela nona quadrissemana consecutiva
- • Novos multiplicadores em educação ambiental em bacia hidrográfica são formados no centro-norte paulista
- • Novo Manual Técnico apresenta alternativas de uso da amoreira
- • Exportações do agronegócio paulista, de US$ 11,24 bilhões no período janeiro-julho, representam 20,1% do total nacional
- • Ovinocultura, piscicultura e fruticultura: novas opções para agricultura familiar no Vale do Paranapanema
- • Preços agrícolas sobem 0,60% em julho e 4,64% no acumulado de 12 meses
- • Agrifam 2012: ITAL apresenta alternativas de agregação de valor na cadeia de frutas
- • Dia do agricultor foi comemorado na capital paulista
- • 1.º Simpósio Internacional sobre equipamentos de proteção na aplicação de agrotóxicos
- ► Julho (15)
- • Dia do Agricultor terá comemoração especial no Parque da Água Branca
- • Preços agrícolas sobem pela sétima vez seguida: 0,82% na 3ª quadrissemana de julho
- • 4º Encontro de Citricultura: espaço para discutir produção de frutas pela agricultura familiar
- • Preços agrícolas sobem 1,34% na 2ª quadrissemana de julho; tomate de mesa aumenta 68,24%
- • IEA, da Secretaria de Agricultura e Abastecimento, vai oferecer cursos de extensão e atualização
- • Pesquisador do IEA, José Sidnei Gonçalves, será homenageado em Congresso da SOBER
- • Macaúba: projeto busca consolidar cadeia do biodiesel com agricultura familiar no Pontal do Paranapanema
- • Preços agrícolas sobem 1,51% na primeira quadrissemana de julho
- • Faleceu Nelson Staudt, pesquisador do IEA e secretário geral das Câmaras Setoriais da Secretaria de Agricultura
- • Agronegócio paulista exporta US$ 9,05 bilhões no primeiro semestre
- • Pesquisadores paulistas participam de livro que reúne o de mais atual sobre milho
- • Preços agrícolas sobem 1,68% em junho e 0,06% no acumulado de 12 meses
- • Produtores e trabalhadores rurais podem fazer curso rápido de operação de tratores agrícolas
- • Técnico do Biológico fala do apoio aos programas sanitários brasileiros, em entrevista em Portugal
- • Agrifam 2012: Secretaria de Agricultura mostra ações durante a feira
- ► Junho (24)
- • APTA Regional divulga editais para bolsas de iniciação científica e em desenvolvimento tecnológico e inovação do CNPq
- • Preços agrícolas sobem 1,22% na terceira quadrissemana de junho
- • Produção paulista de laranja deve atingir 365,25 milhões de caixas na safra agrícola 2011/12
- • IAC completa 125 anos, com entrega de restauro de prédio imperial e anúncio de descoberta de isoflavona no feijão
- • APTA realiza workshop para discutir questões energéticas
- • IZ coloca à venda 300 animais do seu programa de melhoramento genético, em Sertãozinho
- • Workshop Agroenergia apresenta novas tecnologias para produção de energia limpa e sustentável
- • Preços agrícolas sobem 0,63% na segunda quadrissemana de junho
- • Inscrição de trabalhos para III Encontro da Cadeia Produtiva de Olivicultura, até 15 de julho
- • Produção paulista de café na safra 2012/13, estimada em 4,92 milhões de sacas
- • V Simpósio de Controle de Qualidade do Pescado aborda acesso e aproveitamento integral do produto
- • Secretaria de Agricultura assina protocolo de intenções com Instituto Italiano
- • Preços agrícolas sobem 1,26% (e 4,58%, sem a cana) na primeira quadrissemana de junho
- • Tubarão taxidermizado: atração do Instituto de Pesca no Parque da Água Branca
- • IEA tem nova diretora, a pesquisadora Marli Dias Mascarenhas Oliveira
- • Exportações do agronegócio paulista atingem US$ 7,29 bilhões no período janeiro-maio
- • Secretaria de Agricultura mostra suas ações na 18ª Feicorte
- • Já está disponível nova versão de grade de agrotóxicos para produtores de citros
- • Padrões de qualidade de laboratórios científicos serão discutidos em encontro no Biológico
- • Sem incluir a cotação da cana-de-açúcar, preços agrícolas sobem 0,70% em maio
- • Protocolo de cooperação para setor florestal, uma das medidas do pacote ambiental do governo paulista
- • Aquicultura: estudo mostra viabilidade econômica do uso de probiótico
- • Pesquisadora do Biológico lança Guia de Identificação de Doenças do Feijoeiro
- • APTA participa do InovaCampinas de inovação, sustentabilidade e tecnologia
- ► Maio (21)
- • Tubarões: alta demanda e captura crescente provocam impacto sobre populações desses peixes
- • Biológico promove colheita solidária de café no início da semana do meio ambiente
- • Preços agrícolas caem 0,41% na terceira quadrissemana de maio
- • Colheita no cafezal do IB lança início da safra em São Paulo
- • Mais de 40 palestras na 34ª Semana da Citricultura, em Cordeirópolis (SP)
- • II Seminário de Plantio Direto da Alta Paulista enfatiza culturas perenes
- • Pesquisador José Sidnei Gonçalves: uma carreira de muitas contribuições à agricultura
- • Preços agrícolas caem 0,50% na segunda quadrissemana de maio
- • São Paulo mantém liderança nacional nas exportações do agronegócio, no período janeiro-abril
- • Evento no cafezal urbano do Instituto Biológico abre colheita de café da safra 2012
- • Milho e sorgo: vence no final do mês prazo de apresentação de trabalhos para Congresso Nacional
- • IAC e ANDEF criam o primeiro MBA em Fitossanidade do País
- • Preços agrícolas sobem 0,20% na primeira quadrissemana de maio; destaque para batata e feijão
- • Pesquisadora do Instituto Biológico participa do livro Água na Avicultura Industrial
- • Integração lavoura-pecuária-floresta: sistema adaptável ao perfil de produtor e de região
- • Até quinta-feira (10), inscrições de trabalhos para o VI Workshop Agroenergia, de Ribeirão Preto
- • Preços agrícolas sobem 0,57% em abril e 7,69% no acumulado de 12 meses
- • Programa Aplique Bem: novo veículo vai aumentar em 50% quantidade de treinamentos
- • Aquicultura: São Paulo pode aumentar em mais de 10 vezes a produção de peixes
- • Valor da produção agropecuária e florestal paulista aumentou 6,5%, para R$ 59,6 bilhões, em 2011
- • ITAL participa do 23º Congresso Brasileiro de Ciência e Tecnologia de Alimentos, em Campinas
- ► Abril (22)
- • SECRETARIA DE AGRICULTURA MOSTRA SUAS AÇÕES NA FEIRA AGRISHOW 2012
- • Preços agrícolas sobem 0,83% na terceira quadrissemana de abril
- • Mais de 200 pessoas no evento de 3 anos de Programa de Sanidade em Agricultura Familiar
- • Banana: representantes do setor e pesquisadores alertam Brasília sobre riscos de importações do Equador
- • ITAL apresenta tendências na área de embalagens, durante a Expo Embala em SP
- • Preços agrícolas sobem 1,05% na segunda quadrissemana de abril
- • No IZ-Sertãozinho, sistema canadense GrowSafe vai medir consumo de alimento e comportamento dos animais
- • Baby leaf: hortaliças de pequeno porte ganham espaço na gastronomia e ajudam na alimentação saudável das crianças
- • Pesquisadores da APTA Regional avaliam criação de tilápias em tanque-rede no Sudão
- • Pesquisadora do IAC recebe Prêmio Péter Murányi 2012 Alimentação por mandioca de mesa
- • Exportações do agronegócio paulista somam US$ 4,15 bilhões no primeiro trimestre
- • Preços agrícolas sobem 1,04% na primeira quadrissemana de abril
- • ITAL e Instituto Fraunhofer assinam protocolo para inovação em alimentos e bioenergia
- • Dia de Campo, em Pindamonhangaba, trata de reforma e recuperação de pastagem
- • Grupo Fitotécnico de Cana-de-açúcar comemora 20 anos, no Centro de Cana do IAC em Ribeirão Preto
- • IAC promove seminário sobre conservação do solo e proteção de recursos naturais
- • Preços agrícolas sobem 0,73% em março e 6,44% no acumulado de 12 meses
- • Programa sanidade em agricultura familiar completa 3 anos com evento em Monte Alegre do Sul
- • Laboratório de Nutrição Animal do Polo Regional Alta Mogiana/APTA/SAA-SP, certificado pela EMBRAPA
- • Instituto de Pesca completa 43 anos de atuação na cadeia produtiva do pescado
- • Pesquisa avalia propriedades funcionais de alho industrializado
- • Nova espécie de ostra é identificada no estuário de Cananeia
- ► Março (23)
- • Primeiro cultivo experimental de camarão marinho em águas continentais
- • Preços agrícolas sobem 0,21% na terceira quadrissemana de março, puxados por frango e ovos
- • Estudos do IAC ajudam a verificar que vírus do tomate também ataca a batata
- • Conferência aborda cooperação entre Brasil, Itália e África pela produção sustentável de biocombustíveis
- • Exportações do agronegócio paulista atingem US$ 2,58 bilhões no primeiro bimestre
- • IZ debate o uso sustentável da água em simpósio de produção animal e recursos hídricos
- • Custo de produção de cenoura em sistema orgânico é de R$ 11.261,06 por hectare
- • Inovação contra desperdício na indústria de pescado
- • Workshop sobre produção sustentável de ovinos: um balanço das palestras na Feinco 2012
- • Preços agrícolas caem 0,53% na 2ª quadrissemana de março, mas produtos animais sobem
- • Dissertação no Instituto de Pesca apresenta biologia pesqueira do molusco Lula
- • Ministro Marcelo Crivella visita Instituto de Pesca
- • Uso de águas públicas para projetos de piscicultura em tanque-rede mobiliza setor
- • Pesquisador do Instituto de Pesca lança livro Peixes-de-bico do Atlântico
- • Pesquisa obtém nascimento de primeiro jumento gerado a partir de sêmen congelado
- • IAC, fonte histórica para projeto Memória do Café no Estado de São Paulo
- • Preços agrícolas caem pela quinta vez consecutiva, em São Paulo
- • APTA fornece cavalos para a Polícia Militar do Estado de São Paulo a índice zero de rejeição
- • Estão abertas as inscrições de trabalhos técnicos e científicos para o VI Workshop Agroenergia realizado pela APTA e IAC
- • Feinco: Secretaria de Agricultura apresenta ações voltadas ao setor
- • Pesquisador do IEA fala sobre cenários para o mercado de café, em evento na FEA-USP
- • Sanidade avícola: pesquisa do Instituto Biológico sobre novo ácaro é premiada pelo setor
- • APTA realiza 6.º Ciclo de Palestra de Fitossanidade e apresenta técnica de cultivo de maracujá que diminui em até 90% a aplicação de defensivos agrícolas
- ► Fevereiro (14)
- • Preços pagos ao produtor continuam em queda, aponta estudo
- • Integração lavoura-pecuária-silvicultura: primeiros produtores já utilizam o sistema no noroeste paulista
- • IZ participa da análise genética de bovino Crioulo
- • Secretaria de Agricultura de São Paulo estuda a criação de consórcio para pesquisa com seringueira
- • Preços agrícolas caem 0,47% na primeira quadrissemana de fevereiro
- • Exportações do agronegócio paulista somam US$ 1,20 bilhão em janeiro
- • IZ participa de simpósio sobre Uso sustentável da água nos sistemas de produção pecuária
- • Integração entre eucalipto e ovinos de corte, projeto inédito de pesquisa em São Paulo
- • Estado lança vacina para erradicação de doença aviária em Bastos
- • Pesquisadores do Instituto Biológico e da Unesp, em livro on-line sobre herbicidas
- • Nutrição de plantas: estudo avalia consorciação de lavouras com forrageiras
- • Preços agrícolas sobem 0,54% no encerramento de janeiro
- • II Mutirão Agroflorestal no Vale do Paraíba: tecnologias para conciliar agricultura e recuperação ambiental
- • Laranja: regiões e municípios líderes no Estado de São Paulo
- ► Janeiro (17)
- • Nova previsão da safra 2011/12: produção paulista de milho deve atingir 3,287 milhões de toneladas
- • Preços agrícolas sobem 0,45% na terceira quadrissemana de janeiro
- • Garrote do IZ venceu prova de ganho de peso de 2011 em Sertãozinho (SP)
- • Agricultores de Extrema (MG) produzem boa parte da água que abastece a Grande São Paulo
- • IAC desenvolve 15 novos clones de seringueira mais precoces
- • Preços agrícolas apresentam leve alta (0,26%) na segunda quadrissemana de janeiro
- • ITAL oferece curso de especialização em tecnologia de carnes
- • APTA é a única instituição pública do País a produzir abelhas rainhas para apicultores de todo Brasil
- • ITAL planeja realizar 45 eventos em 2012, entre workshops, cursos e seminários
- • Exportações do agronegócio paulista crescem 14,4%, para US$ 23,11 bilhões, em 2011
- • Preços agrícolas: estabilidade na primeira quadrissemana de janeiro
- • Café: primeira estimativa da safra paulista 2012/13 prevê 4,6 milhões de sacas
- • Laboratórios do Biológico e do IAC, credenciados em dezembro pelo Ministério da Agricultura
- • Preços agrícolas sobem 14,57% no acumulado de 2011 por causa do efeito cana
- • Preços agrícolas sobem 0,19% no último mês de 2011
- • Robalo: estudos sobre comportamento, biologia e manejo alimentar visam à criação em cativeiro
- • Acervo de 340 mil documentos do Biológico conta história da sanidade agropecuária paulista
- ► Dezembro (16)
- ► 2011 (221)
- ► Dezembro (10)
- • Estado lança 9ª Edição Especial dos Melhores Cafés de São Paulo Safra 2011
- • Projeto de educação ambiental em bacia hidrográfica recebe Prêmio COFEHIDRO 2011
- • Preços agrícolas sobem 1,70% na primeira quadrissemana de dezembro
- • Projeto de educação ambiental em bacia hidrográfica promove geração de conhecimento e de tecnologias
- • Instituto Biológico prepara programação de férias para Planeta Inseto
- • Exportações do agronegócio paulista crescem 14,9%, para US$ 21,47 bi, em janeiro-novembro
- • Instituto de Pesca participa do Programa Via Rápida, com cursos na área de aquicultura
- • Centro de Frutas IAC completa 75 anos, com novo boletim técnico
- • Preços agrícolas sobem 1,85% no fechamento do mês de novembro
- • Seringueira: irrigação por gotejamento antecipa em até 2 anos período de sangria da árvore
- ► Novembro (16)
- • Pesquisadores do IEA defendem adiamento da discussão do Código Florestal para aprofundar debate
- • Preços Agrícolas aumentam 1,44% na terceira quadrissemana de novembro
- • Sanidade Avícola: Laboratório do IB é credenciado para mais três doenças
- • Pesquisadores da Apta participam de workshop sobre mudanças climáticas
- • Produção de leite: antecipação da idade ao 1º parto, para 28 meses; mais produção e animais para venda
- • Preços agrícolas sobem 1,42% na segunda quadrissemana de novembro
- • IZ desenvolve projetos de Integração Lavoura-Pecuária, envolvendo capim e milho
- • Produção de carne: tempo de abate de bovinos cai para menos de dois anos; mais lucro e melhor qualidade
- • Equipamento do IAC ajuda na medição da seiva das plantas e colabora com meio ambiente
- • Polo de hortaliças no Nordeste Paulista, um dos principais do Estado de São Paulo
- • Preços agrícolas sobem 0,96% na primeira quadrissemana de novembro
- • Exportações do agronegócio paulista sobem 15,8% até outubro, para US$ 19,45 bilhões
- • Preços agrícolas sobem 0,51% em outubro e 17,12% no acumulado de 12 meses
- • UNESP e IAC-APTA promovem Encontro sobre Gestão de Impactos Ambientais
- • Encontro em Piracicaba define propostas para cadeias produtivas das regiões Centro Oeste e Centro Sul
- • Biológico é credenciado para análise de toxina botulínica em ração animal
- ► Outubro (25)
- • João Demarchi é o novo diretor geral do Instituto de Zootecnia
- • Biológico comemora 84 anos na abertura da 24ª Reunião Anual-RAIB
- • Preços agrícolas caem 0,19% na terceira quadrissemana de outubro
- • Vacas Girsey produzem mais leite e criador tem mais animais para venda
- • Encontro regional reúne extensionistas e pesquisadores em Piracicaba
- • Pesquisador do Polo Centro Sul/APTA Regional ganha prêmio da EMBRAPA
- • APTA colabora na reedição das Normas de Classificação de Citros de Mesa para padronizar mercado e fidelizar consumidor final
- • Dia de campo da laranja discute o uso de quebra-ventos na citricultura
- • VI Congresso Brasileiro de Ciência e Tecnologia de Carnes, na cidade de São Pedro
- • Preços agrícolas caem 1,19% na segunda quadrissemana de outubro
- • Governo do Estado libera R$ 1,5 milhão para Museu de Pesca e laboratórios do IP
- • Alckmin nomeia 289 servidores concursados para a Secretaria de Agricultura
- • Encontro de café do sudoeste paulista discute indicação geográfica, comercialização e mecanização
- • Alimentação escolar: ITAL reúne profissionais de nutrição para discutir tema
- • Laboratório da APTA é o único público de São Paulo credenciado para fazer análises de pinta preta em frutos cítricos exportados à Europa
- • Seminário debate gestão ambiental relacionada com economia agrária e recursos naturais
- • Preços agrícolas caem 1,49% na primeira quadrissemana de outubro
- • Workshop internacional sobre mudanças climáticas, no IAC em Campinas
- • Laboratório de resíduos de pesticidas do Biológico recebe novo certificado do INMETRO
- • Exportações do agronegócio paulista crescem 17,5%, para US$ 17,39 bi, no período janeiro-setembro
- • Plantio direto do tomateiro: sustentabilidade do agricultor na cadeia produtiva
- • Implantação da cultura de café em sistemas orgânicos é 11 a 15% mais barata
- • Preços agrícolas tem baixa de 1,82% no encerramento de setembro
- • Valor da produção agropecuária e florestal paulista, estimada em R$ 61,45 bilhões em 2011
- • Alta Mogiana: encontro de lideranças e técnicos define propostas para cadeias de produção
- ► Setembro (20)
- • Citricultura paulista: boa safra cria 264,6 mil postos de trabalho na safra 2011/12
- • Preços agrícolas caem 1,29% na terceira quadrissemana de setembro
- • Pontal do Paranapanema poderá tornar-se grande produtor paulista de maracujá
- • Pesquisa FAPESP/UNESP/APTA Regional, premiada em Congresso Latino-Americano de Avicultura
- • Projeto de educação ambiental do Polo Centro Norte/APTA Regional, premiado pela 3ª vez no Diálogo Interbacias
- • Dia de Campo realizado pelo IAC e APTA apresenta ao produtor rural o capim-ruziziensis usado nas lavouras do Sistema Plantio Direto na Palha
- • Preços agrícolas caem 0,32% na segunda quadrissemana de setembro
- • IZ vende reprodutores e matrizes melhorados, em Sertãozinho
- • Instituto de Pesca promove VI Seminário de Iniciação Científica e III Encontro de Pós-graduandos
- • Preços agrícolas sobem 0,75% na primeira quadrissemana de setembro
- • Evento discute demarcação de parques aquícolas nos reservatórios do Rio Paranapanema
- • Instituto Biológico tem o primeiro Jardim Zoológico de Insetos no Brasil
- • Exportações do agronegócio paulista: US$ 15,11 bilhões em janeiro-agosto
- • Projeto Oliva SP da APTA estuda o cultivo de oliveiras em condições paulistas
- • Café: nova previsão paulista é de 3,316 milhões de sacas na safra 2011/12
- • Combate a doenças animais: Instituto Biológico produziu 40 mil análises até julho
- • Preços agrícolas sobem 1,77% em agosto, com viés de alta
- • Pesquisadora do ITAL ganha prêmio ABRE da Embalagem Brasileira
- • AVES: CONFERÊNCIA DISCUTE A LARINGOTRAQUEÍTE INFECCIOSA
- • TRIGO: NOVA VARIEDADE TEM DOBRO DE PRODUTIVIDADE E REDUÇÃO DE 30% NA APLICAÇÃO DE DEFENSIVOS
- ► Agosto (17)
- • Ital comemora aniversário com ampliação e modernização de laboratórios
- • Laboratório modernizado: novas perspectivas de pesquisas no setor de sementes do Biológico
- • IZ lança em Uberaba Sumário 2011 de touros e matrizes Nelore e Guzerá
- • CATI e Polo Regional Centro Oeste (APTA) lançam Manual Técnico de Goiaba do plantio à comercialização
- • Preços agrícolas apresentam ligeira queda 0,58% na segunda quadrissemana de agosto
- • IZ na ExpoGenética 2011 em Uberaba: confira a programação e as ações nas redes sociais
- • Exportações do agronegócio paulista crescem 16,7%; saldo comercial do setor é de US$ 6,62 bi
- • Juventude rural será um dos temas de encontro regional no sudoeste paulista
- • Preços agrícolas caem 2,34% na primeira quadrissemana de agosto
- • I Seminário Paulista de Higiene e Tecnologia do Pescado, em Santos (SP)
- • Projeto de educação ambiental já capacitou 120 educadores e técnicos da Bacia Hidrográfica dos Rios Turvo e Grande
- • Livro Nascentes aborda produção e captação da água para consumo doméstico
- • Preços agrícolas caem 3,80 % no fechamento de julho
- • SECRETARIA APRESENTA AÇÕES DURANTE A 8ª AGRIFAM
- • Em Jundiaí, IAC promove dois eventos relacionados com o meio ambiente
- • Em Assis, o 1º Seminário sobre Gestão da Qualidade na Implantação de Lavouras em Plantio Direto
- • Pães e doces: ITAL, Governo Federal e Indústria discutem o setor de alimentação e nutrição
- ► Julho (21)
- • Bovinos: dois eventos numa única semana para combater o carrapato
- • Preços agrícolas caem 4,55% na terceira quadrissemana de julho
- • Tilápia: surgem complexos de produção em São Paulo e no Brasil
- • Instituto de pesca seleciona novos bolsistas de iniciação científica do CNPq
- • IZ promove I Curso de Tecnologia de Sêmen Ovino
- • Curso capacita técnicos para cultivo sustentável de pupunha para palmito
- • Estudo do IAC sobre cultivo protegido de uva aumenta produtividade em 100%
- • Preços agrícolas caem 4,72% na segunda quadrissemana de julho
- • 3º encontro de citricultura apresenta novas tecnologias na região sudoeste paulista
- • Evento discute em São Paulo avanços na área de controle biológico
- • IZ COMEMORA 106 ANOS DE PESQUISAS
- • Preços agrícolas caem 4,79% na primeira quadrissemana de julho
- • Em evento sobre citros de mesa, IAC homenageia 72 famílias pioneiras na produção
- • Pesquisadora da APTA Regional vai ser juíza de concurso de qualidade de ovos, em Bastos
- • Mais de 60% dos produtores de mandioca financiados pelo FEAP/BANAGRO tornaram-se inadimplentes
- • Exportações do agronegócio paulista atingem US$ 9,92 bilhões no primeiro semestre
- • Aprovada proposta de criação do sistema nacional de curadorias de bancos de germoplasma
- • Preços agrícolas caem 5,23% em junho, segundo IEA
- • Curadores de germoplasma do País iniciam discussões sobre conservação e manejo de recursos genéticos
- • Workshop discute criação de sistema nacional de coleções biológicas e bancos de germoplasma
- • ESTUDO ANALISA DISTRIBUIÇÃO E CAPTURA DE PEIXES DEMERSAIS NO SUDESTE BRASILEIRO
- ► Junho (21)
- • Robalo-peva tem boa adaptação à criação em água doce, no Vale do Ribeira
- • IEA avalia impactos ambientais, econômicos e sociais de futura hidrelétrica no Pará
- • Preços agrícolas caem 1,78% na terceira quadrissemana de junho
- • Produção paulista de grãos na safra 2010/11 deve atingir 6,7 milhões de toneladas
- • IAC completa 124 anos e lança Programa de Cafés Especiais
- • Encontros discutem biocombustíveis, agricultura irrigada e olerícolas em diferentes regiões
- • Alta de 1,51% nos preços agrícolas na segunda quadrissemana de junho
- • Estudo detecta concentração de mercúrio no Rio Grande e Represa Billings
- • Pesquisadores da APTA Regional escrevem capítulo do livro Sustainable water management
- • Pesquisador do IEA critica partidarismo de entidades científicas na discussão do Código Florestal
- • Curso ensina como lidar com insetos em alimentos industrializados, da matéria-prima ao consumidor
- • Feicorte 2011: participação da Secretaria é marcada pela interatividade
- • Exportações do agronegócio paulista atingem US$ 7,69 bilhões no período janeiro-maio
- • Preços agrícolas paulistas sobem 7,92% na primeira quadrissemana de junho
- • Instituições da APTA vão avaliar capacidade competitiva de laboratórios da APTA Regional
- • Exposição fotográfica para comemorar os 124 anos do IAC
- • Pesquisa da APTA Regional ajuda aumentar eficiência das aves poedeiras no consumo de rações
- • Efeito cana eleva preços agropecuários em 15,43% no encerramento do mês de maio
- • ITAL participa das feiras TecnoSorvetes e FISPAL, na capital paulista
- • ITAL participa da FISPAL Tecnologia, na capital paulista
- • Com R$ 22,87 bilhões, cana-de-açúcar representa 43,60% do valor da produção agropecuária paulista
- ► Maio (24)
- • Avicultura é tema do Blog da Secretaria de Agricultura
- • Semana da Citricultura terá mais de 40 palestras técnicas e exposição de 46 empresas
- • Preços agrícolas sobem 11,45% na terceira quadrissemana de maio, puxados pela cana
- • Canavicultura sustentável é tema de seminário do IAC em Ribeirão Preto
- • Inseminação artificial de tainha é tema de mestrado no Instituto de Pesca
- • Planeta Inseto do Instituto Biológico vai ao Parque Ecológico de Campinas
- • Preços agrícolas sobem 8,28% na segunda quadrissemana de maio
- • Exportações do agronegócio paulista crescem 15,6%, para US$ 6 bilhões, no primeiro quadrimestre
- • Instituto Biológico lança a publicação Doenças e Pragas em Seringueira
- • ITAL e Instituto Fraunhofer discutem importância da cooperação entre instituições
- • Instituto de Pesca abre perspectivas de parceria nas Filipinas
- • Pesquisadores do ITAL elaboram produtos cárneos embutidos com carne de ovelha
- • IAC lança publicação sobre cálculo de fórmulas comerciais de fertilizantes
- • Preços agrícolas sobem 3,64% na primeira quadrissemana de maio
- • Evento Sabor da colheita 2011 abre a colheita de café, no coração da cidade de São Paulo
- • Instituto Biológico lança novos boletins técnicos
- • Aquário do Instituto de Pesca: revitalização do espaço destinado a rãs-touro
- • Safra paulista 2011/12 de laranja é estimada em 355 milhões de caixas
- • Pesquisador do Instituto de Pesca introduz conceitos de Neuroendocrinologia em estudos com peixes
- • Preços agrícolas caem 0,61% em abril, após nove meses de alta
- • Polo Leste Paulista/Apta Regional completa 69 anos
- • Pesquisadora alerta sobre qualidade da água de fontes de abastecimento e de efluentes da piscicultura
- • São Paulo precisa investir em armazenagem no eixo sudoeste-médio Paranapanema
- • APTA na Agrishow: novas variedades e tecnologias do IAC; novo levantamento da safra de laranja IEA/CATI/CONAB; presença no Blog da SAA
- ► Abril (21)
- • Seminário discute produção de flores e plantas ornamentais no Vale do Ribeira (SP)
- • Preços agrícolas sobem 0,36% na terceira quadrissemana de abril
- • Milho: primeiro balanço de oferta e demanda de 2011 aponta aumento de 12,3% nas importações paulistas
- • Estudo compara sistemas de cultivo integral e de engorda da ostra-do-mangue
- • Preços agrícolas sobem 1,59% na segunda quadrissemana de abril
- • APTA Regional realiza I Simpósio de Ovinocultura do Sul Paulista
- • ESTIMATIVA DE SAFRA: ALGODÃO COM ÁREA 80% MAIOR; MILHO PASSA POR AJUSTE
- • Lago das Garças, no Parque Estadual das Fontes do Ipiranga, é tema de mestrado
- • No Dia da Conservação do Solo, informações úteis para uma boa prática agrícola
- • Preços agrícolas sobem 2,71% na primeira quadrissemana de abril
- • PROTOCOLO COM ORPLANA GARANTE ESTUDO DE CUSTOS DA CANA
- • Exportações do agronegócio paulista sobem 11,2%, para US$ 4,27 bilhões, no primeiro trimestre
- • Balança Comercial dos Agronegócios Paulista e Brasileiro no Primeiro Trimestre de 2011
- • Encontro entre CATI e APTA discute desenvolvimento rural sustentável, em Votuporanga
- • Blog da Secretaria da Agricultura: Pesca e Aqüicultura são temas da Semana
- • Seminário no IAC comemora o Dia Nacional da Conservação do Solo
- • Instituto de Pesca completa 42 anos de apoio à cadeia produtiva do pescado
- • Preços agrícolas fecham março com alta de 3,32%, em plena colheita da safra das águas
- • ITAL e Instituto Fraunhofer discutem inovação na cadeia produtiva de alimentos em Seminário Internacional
- • II Workshop de piscicultura do Noroeste Paulista
- • Pesquisador Hamilton Ramos é o novo diretor geral do IAC
- ► Março (13)
- • APTA divulga orientações para implantação da Produção Integrada de Citros, exigência do mercado
- • Coordenador da APTA integra nova diretoria do CONSEPA
- • Regiões da Capital, Baixada Santista e Araraquara, maiores exportadoras do agronegócio
- • APTA Regional ganha três prêmios no VI Congresso Brasileiro de Pregoeiros
- • Feijão puxa lista de aumentos nos preços agrícolas da terceira quadrissemana de março
- • Secretaria de Agricultura marca presença na Agrovia 2011
- • Técnicos venezuelanos discutem critérios de exportação de bovinos com Biológico
- • Balança comercial: exportações aumentam, mas saldo é menor
- • Seminário discute sustentabilidade, conhecimento e qualidade do café brasileiro
- • Preços agrícolas sobem 2,53% na primeira quadrissemana de março
- • Produção Sustentável de Ovinos é tema de workshop do IZ na Feinco 2011
- • Preços agrícolas sobem 2,19% em fevereiro
- • Uma proposta de remuneração econômica a agricultor que mantenha vegetação nativa
- ► Fevereiro (19)
- • Biológico homenageia pesquisadora Victória Rossetti pela contribuição na área citrícola
- • Agronegócio paulista exporta US$ 1,27 bilhão em janeiro
- • Preços agrícolas sobem 1,76% na terceira quadrissemana de fevereiro
- • Alimentos funcionais: pesquisadores do ITAL testam bactérias probióticas em néctar de frutas
- • Curso vai mostrar a importância do uso de internet na propriedade agrícola
- • IZ convida criadores e associações para a 61ª Prova de Ganho de Peso de Sertãozinho
- • Área de doenças suínas do Biológico é credenciada pelo Ministério de Agricultura
- • Preços agrícolas sobem 1,18% na segunda quadrissemana de fevereiro
- • IAC reúne 114 laboratórios de análises de solos para fins agrícolas
- • APTA Regional e CATI capacitam veterinários em manejo do rebanho leiteiro
- • Congresso paulista de fitopatologia discute sustentabilidade na agricultura moderna
- • Preços agrícolas sobem 1,05% na primeira quadrissemana de fevereiro
- • Polos Regionais/APTA vão ter rede integrada de laboratórios para defensivos agrícolas
- • Alckmin recebe ministra da Pesca e Aquicultura, Ideli Salvatti
- • Pesquisadora do IZ fala sobre enfermidades de ovinos na 6ª Expo Piracicaba Show
- • Avaliação e gestão da pesca do parati no litoral sul paulista
- • Preços agrícolas fecham janeiro em alta de 1,55%
- • Projeto do IZ vai elaborar índices econômicos de seleção para melhoramento de bovinos da raça Nelore
- • Pesquisadores da APTA em evento de desenvolvimento tecnológico da Coopermota
- ► Janeiro (14)
- • Vacas leiteiras mestiças podem ser criadas sem produtos químicos
- • Custo de produção de fornecedores de cana varia entre R$ 32,08 e 45,42 a tonelada
- • Preços agrícolas sobem 1,73% na terceira quadrissemana de janeiro
- • Safra paulista de laranja pode atingir 353 milhões de caixas em 2010/11
- • Pesquisadores da APTA participam do projeto Qualisolo
- • Exportações do agronegócio paulista crescem 27,02%, para US$ 20,20 bi, em 2010
- • Preços agrícolas sobem 2,44% na segunda quadrissemana de janeiro
- • Preços agrícolas sobem 1,71% neste início de 2011
- • Planeta Inseto vai à praia: Museu de Pesca de Santos recebe exposição do Museu do Instituto Biológico
- • FINEP aprova 13 PROJETOS para Organizações Estaduais de Pesquisa Agropecuária
- • ITAL divulga o calendário de eventos de 2011
- • Produção paulista de café deve cair 26,55%, para 3,4 milhões de sacas, em 2011/12
- • Preços agrícolas fecham 2010 com alta de 36,40%
- • Leite funcional: projeto integra pesquisas de zootecnia, nutrição e medicina humana aplicada
- ► Dezembro (10)
- ► 2010 (207)
- ► Dezembro (17)
- • Pesquisa perde Victória Rossetti, uma das maiores fitopatologistas do Brasil e do mundo
- • APTA disponibiliza 110 coleções biológicas e cria sistema de curadoria para gerir patrimônio genético
- • Pesquisa do IAC sobre espécies nativas da Mata Atlântica de SP, premiada pela Natura
- • Cientistas de 40 países discutem estoques de atuns e peixes afins
- • Preços agrícolas sobem 2,34% na primeira quadrissemana de dezembro
- • Exportações do agronegócio paulista atingem US$ 18,68 bilhões em novembro
- • São Paulo lança os melhores cafés da safra 2010
- • IAC ganha Laboratório de Microbiologia e Fitopatologia Pós-colheita
- • Carne bovina: câmara setorial discute ameaças de proposta do CONSEMA sobre espécies exóticas
- • Mundo dos Insetos é tema de exposição no Museu do Instituto Biológico
- • Petrechos de pesca perdidos no mar: projeto inédito no Brasil
- • Preços agrícolas encerram novembro em alta de 3,24%
- • Biológico inicia exportações de antígeno para diagnóstico da brucelose animal
- • Encontro discute tecnologia de aplicação de agrotóxicos na agricultura
- • Exportações do agronegócio paulista crescem 30,3%, para US$ 16,80 bilhões
- • Pesquisadores realizam a 2ª Reunião Nacional da Cadeia Produtiva do Urucum, em Campinas
- • Aquicultura ganha inédito laboratório interinstitucional de sanidade
- ► Novembro (29)
- • Instituto de Pesca transfere tecnologia de alga marinha para produtores de Ubatuba
- • Polo Regional Centro-Sul ganha novo laboratório de tecnologia da cana-de-açúcar
- • IAC inaugura Laboratório de Biotecnologia e Qualidade de Frutas em Jundiaí
- • Secretaria entrega laboratório modernizado do Instituto Biológico em Descalvado, importante região avícola
- • Preços agrícolas sobem 3,03% na terceira quadrissemana de novembro
- • Secretaria de Agricultura inaugura laboratório de tecnologia de cana-de-açúcar, no Polo Centro Sul/APTA
- • Instituto de Economia Agrícola comemora 68 anos
- • IAC tem três Laboratórios do Centro de Solos acreditados pelo Inmetro
- • Pesquisadores do IZ participam do I Simpósio de Manejo de Pastagens do Sul do Pará
- • Preços agrícolas sobem 2,34% na segunda quadrissemana de novembro
- • Governo do Estado lança projeto de ampliação do Áquario Água Branca, na capital paulista
- • Área plantada com grãos deve crescer 2,9%, para 1,28 milhão de hectares, em SP
- • Unidade de Pesquisa do Instituto de Pesca, em Ubatuba, ganha instalações modernizadas
- • Secretaria de Agricultura moderniza Laboratório de Sanidade Apícola, visando ao credenciamento no MAPA
- • Tecnologias de biodiesel e de última geração de etanol, em seminário do IAC em Jundiaí
- • Ciclo de palestras discute cadeia da borracha natural em São Paulo
- • 2º Simpósio de Certificação de Cafés Sustentáveis discute desafios da atividade, em Poços de Caldas (MG)
- • Preços agrícolas sobem 1,87% na primeira quadrissemana de novembro
- • I Seminário de OvinoCaprinocultura das Vertentes e Zona da Mata, em Barbacena
- • Feileite 2010: Secretaria terá programação especial nas redes sociais
- • Mais importante fórum de discussão sobre doenças de citros, em Campinas
- • Mudanças Climáticas e Sustentabilidade da Pecuária será tema de workshop no IZ
- • Produto tipo caviar de ovas de truta arco-íris salmonada
- • Preços agropecuários encerram o mês de outubro em alta de 2,37%
- • Ao completar 83 anos, Biológico recebe novo certificado de qualidade e abre 23ª Reunião Anual
- • Laranja: safra paulista de 2009/10 deve atingir 318,6 milhões de caixas
- • Gado de corte: criadores de MG e SP vencem provas de ganho de peso de Sertãozinho
- • Evento em Santos apresenta compradores dos melhores cafés de concurso estadual de qualidade
- • Encontro reúne pesquisa e extensão rural da Alta Paulista e Médio Paranapanema
- ► Outubro (22)
- • São Paulo: Ministério e Secretaria de Agricultura anunciam safra de laranja
- • Preços agrícolas sobem 3,65% na terceira quadrissemana de outubro
- • Resistência de parasitos de ovinos aos vermífugos é maior em São Paulo
- • Café cereja descascado de Bragança Paulista, entre cinco melhores em concurso estadual
- • Pesquisadoras da APTA participam de livro sobre micorrizas
- • Preços ao produtor: alta de 5,22% na segunda quadrissemana de outubro
- • Polo Centro Norte/APTA promove II encontro de educação ambiental focado em bacia hidrográfica
- • Feijão: VII seminário discute pragas, doenças e plantas daninhas da cultura
- • Uso do lodo de esgoto na agricultura, em simpósio interamericano no IAC
- • Preços agrícolas sobem 5,98% na primeira quadrissemana de outubro
- • Encontro técnico discute culturas de milho e sorgo no Estado de São Paulo
- • Exportações do agronegócio paulista crescem 29,8%, para US$ 14,8 bi, em janeiro-setembro
- • XII Seminário de Alimentação Escolar: ITAL reúne profissionais da área de nutrição
- • Café: custo médio de produção para produtor residente é de R$ 5.471,95 por hectare
- • Peixes: pesquisador japonês faz palestra sobre reprodução artificial pela técnica de barriga de aluguel
- • Parque citrícola paulista: adensamento sobe de 293 para 347 plantas por hectare
- • Controle de qualidade de produtos pesqueiros, discutido em encontro internacional
- • IEA promove curso "Agronegócio e economia do meio ambiente"
- • Alta Mogiana recebe 20 bolsas de iniciação científica do CNPq para alunos do ensino médio
- • Preços agrícolas fecham setembro com alta de 5,43%
- • Pesquisador do IAC fala em Goiás sobre estratégia de produção de cana no cerrado
- • Apta/IAC e Coopermota testam cereais alternativos de inverno, no Médio Paranapanema
- ► Julho (6)
- • Trabalho sobre nanotecnologias e cadeia da soja, em Encontro Nacional de Geógrafos
- • Agricultura de precisão ajuda na rastreabilidade de produtos agrícolas
- • Catavento recebe a exposição Planeta Inseto: Biodiversidade, do Instituto Biológico
- • Feijão: custo de produção em sistema de plantio direto é de R$ 2.852,41 o hectare
- • Seguro rural e cana: dois estudos inéditos na edição de junho de revista do IEA
- • Pindorama: investimentos de R$ 220 mil em centro de convenções
- ► Junho (25)
- • Workshop discute matérias-primas agroenergéticas e sustentabilidade, em Ribeirão Preto
- • Preços agrícolas sobem 1,95% na terceira quadrissemana de junho
- • Consultor da FAO faz palestra sobre perspectiva da aqüicultura mundial
- • Salários rurais mensais tem evolução positiva no Estado de São Paulo, de 2000 a 2009
- • IAC comemora 123 anos com nove prêmios só em 2010
- • APTA PERDE DIRETOR DOS POLOS REGIONAIS
- • Produção paulista de cana-de-açúcar deve cair 1,2%, para 418 milhões de toneladas
- • IZ será sede do XV Curso de Introdução a Docência em Bem-estar Animal
- • Código florestal: técnicos defendem modernização e tecnificação à luz da ciência
- • Produtores consideram satisfatórios recursos de R$ 1 bilhão para armazenagem em propriedades
- • INSTITUTO DE PESCA ANUNCIA DOIS EVENTOS LIGADOS AO CONTROLE DE QUALIDADE DO PESCADO
- • Preços agrícolas sobem 4,36% na segunda quadrissemana de junho
- • Técnica de medição do gás metano produzido pelos bovinos é apresentada na Feicorte 2010
- • Ações de seqüestro de carbono em pastagens promovem aumento de produtividade
- • Instituto de Zootecnia e CRV Lagoa, juntos no mercado de venda de embriões
- • Preços agrícolas sobem 7,14% na primeira quadrissemana de junho
- • São Paulo: exportações do agronegócio crescem 23% de janeiro a maio
- • Feicorte 2010: IZ apresenta workshop sobre pesquisas em gado de corte
- • Pecuária de corte: IZ comercializa 800 embriões de vacas nelore, a partir da Expo Zebu
- • Citricultura: Secretaria apresenta seguro para greening e cancro
- • Semana do Meio Ambiente: 1ª oficina sobre gestão ambiental comunitária
- • Preços agropecuários: maio encerra com alta de 8,66%
- • Evento abre a colheita de café 2010 no maior cafezal urbano do Estado de São Paulo
- • Descendentes de touros nelore do IZ no Tocantins e em Mato Grosso
- • Pesquisador do IZ fala em simpósio sobre impactos da pecuária nos gases do efeito-estufa
- ► Maio (23)
- • Valor da produção agropecuária e florestal paulista foi de R$ 43,3 bilhões em 2009
- • Citros e banana: dois eventos importantes na segunda semana de junho
- • Preços ao produtor aumentam 5,30% na 3ª quadrissemana de maio
- • Ovinos: reunião no IZ cria comissão para avaliar projetos de pesquisa da APTA
- • Cruzamento de gir com jersey pode potencializar produção de leite com qualidade
- • Variedade de feijão IAC é cultivada em Santa Catarina
- • Preços agrícolas sobem 2,57% na segunda quadrissemana de maio
- • MIRANTE DO PARANAPANEMA TERÁ UNIDADE EXPERIMENTAL DE PESQUISAS
- • Pesquisador do Polo Extremo Oeste/APTA será premiado na ZOOTEC 2010, principal evento de zootecnia
- • Encontro discute mosca dos estábulos, associada à vinhaça da cana, que traz prejuízos ao pecuarista
- • QUAIS ALIMENTOS ESTAREMOS CONSUMINDO NA PRÓXIMA DÉCADA?
- • DELEGAÇÃO DO USDA SE REÚNE COM TÉCNICOS DA SECRETARIA DE AGRICULTURA
- • Exportações do agronegócio paulista crescem 22,1% no primeiro quadrimestre, para US$ 5,19 bilhões
- • Preços agrícolas sobem 0,48% na primeira quadrissemana de maio
- • Pescado: estudo caracteriza mercado consumidor em SP e indica espécies mais procuradas
- • IZ apresenta trabalhos na ZOOTEC 2010, o primeiro na região amazônica
- • ITAL e o café: treinamento prepara provadores para analisar qualidade da bebida
- • Programa de sanidade em agricultura familiar chega à qualidade da água
- • Mercado da batata orgânica será discutido em encontro regional promovido pela APTA
- • Preços agrícolas caem 1,20% na quarta quadrissemana de abril
- • Adubação verde melhora o ambiente de produção para a cana-de-açúcar
- • Exposição do Biológico mostra o mundo dos insetos e sua influência sobre nossas vidas
- • Tilápia em tanques-rede: estudo estima custos de implantação e de produção no Médio Paranapanema
- ► Abril (21)
- • Pesquisador do IAC recebe prêmio da EMBRAPA, em Brasília
- • FEIJÃO: DIA DE CAMPO DISCUTE CUSTO DE PRODUÇÃO E APRESENTA NOVAS TECNOLOGIAS
- • Preços agrícolas caem 0,49% na terceira quadrissemana de abril
- • Coordenador fala da participação da APTA na Feira Agrishow, de Ribeirão Preto
- • Exportações do agronegócio paulista sobem 23,9% no primeiro trimestre, para US$ 3,84 bi
- • Preços agrícolas caem 0,07% na segunda quadrissemana de abril
- • Ostras: estudo avalia queda em estoque de Cananéia
- • Primeiros resultados do projeto integração lavoura-pecuária de São José do Rio Preto, em palestra no blog da SAA
- • Gado de corte: 60ª Prova de Ganho de Peso de Sertãozinho agrega nova tecnologia econômica e sustentável
- • Seminário no IAC comemora dia nacional da conservação do solo
- • APTA promove 6º Encontro Regional da Batata, em Itararé (SP)
- • Preços agrícolas sobem 2,17% na primeira quadrissemana de abril
- • Pesquisador do Biológico levanta situação zoo-sanitária da Guiné Equatorial, na África
- • Parceria entre IZ e CRV Lagoa promete revolucionar mercado de venda de embriões
- • Gado de leite: IZ promove reunião para discutir programa conjunto de pesquisa para SP
- • Aos 41 anos, Instituto de Pesca recebe modernização e ampliação
- • Influenza A H1N1: consumo de carne suína é seguro, mas cuidados são necessários em granjas e abatedouros
- • Integração lavoura-pecuária é assunto de dois eventos em abril
- • Pesquisador da APTA ganha prêmio em Congresso de Cana-de-Açúcar, no México
- • Preços agrícolas encerram março com alta de 4,45%
- • Agrotóxicos: Biológico avalia potencial de impacto no meio ambiente e nos alimentos
- ► Março (29)
- • Silagem biológica como aproveitamento racional do pescado
- • São Paulo ganha o primeiro índice de preços de madeira de eucalipto
- • PREÇOS AO PRODUTOR: ALTA DE 6,88% NA TERCEIRA QUADRISSEMANA DE MARÇO
- • Associação de pecuária sustentável anuncia eventos para 2010, em assembleia na sede do IZ
- • Mudanças climáticas: workshop do IZ discute integração lavoura-silvicultura e pecuária sustentável
- • PROGRAMA APLIQUE BEM GANHA PRÊMIO MARIO COVAS
- • Consórcio milho safrinha-planta forrageira pode viabilizar integração lavoura-pecuária em SP
- • GOVERNO DE SP CRIA A ESTAÇÃO EXPERIMENTAL DE AGROENERGIA EM JAÚ
- • Instituto Biológico treina empresas de controle biológico de natureza fúngica
- • Preços agrícolas sobem 8% na segunda quadrissemana de março
- • APTA ganha prêmio nacional na categoria maior número de pregões em um único dia
- • Pesquisa leva debate e plantio de espécies nativas para escola pública em Campinas
- • Rio Paranapanema vai ganhar Parques Aquícolas
- • Embalagem: ITAL participa de projeto de produtos com menor impacto ambiental
- • Comunidade Manejo da Lavoura Cafeeira: mais de um milhão de visitas
- • Reunião vai articular rede de técnicos e pesquisadores interessados em Sistemas Agroflorestais
- • USO DE IMAGEM DIGITAL PARA SELEÇÃO E CLASSIFICAÇÃO DE FRUTAS E HORTALIÇAS
- • Agrotóxicos: Biológico e Prefeitura de Brotas vão monitorar a qualidade dos recursos hídricos
- • VARIEDADES DE FRUTAS IAC ILUSTRAM SELOS DOS CORREIOS
- • AGRONEGÓCIO PAULISTA: PRIMEIRO BIMESTRE DE 2010 MOSTRA RECUPERAÇÃO
- • Biológico contribui para o manejo da mosca negra dos citros na Paraíba
- • PREÇOS AGROPECUÁRIOS: ALTA DE 9,87% NA PRIMEIRA QUADRISSEMANA DE MARÇO
- • Aquecimento global: pesquisador do IEA contesta papel de vilã da agropecuária na emissão de gases efeito-estufa
- • Sustentabilidade de pastagens: manejo adequado reduz emissão de gases de efeito estufa
- • Projeto visa capacitar pescadores do Litoral Sul Paulista
- • Preços agrícolas: fevereiro encerra com alta de 10,26%
- • FEINCO: Secretaria apresenta projetos e blog tem programação especial
- • Biológico inicia exames laboratoriais em grãos de soja exportados para Rússia de porto amazonense
- • Culturas que perderam área para cana, compensadas com adensamento e produtividade
- ► Fevereiro (16)
- • Preços agrícolas: alta de 7,14% na terceira quadrissemana de fevereiro
- • Exportações do agronegócio paulista crescem 10,7% em janeiro, para US$ 1,14 bilhão
- • APTA promove capacitação em educação ambiental com foco em bacia hidrográfica, em Pindorama (SP)
- • Ovinocultura ganha moderna unidade de pesquisa em Assis (SP)
- • Desafios da pesquisa paulista: coordenador da APTA fala com exclusividade ao Espaço Citrícola
- • Preços ao produtor: alta de 5,43% na segunda quadrissemana de Fevereiro
- • Preços agrícolas sobem 3,04% na primeira quadrissemana de fevereiro
- • Promissores os dados preliminares de cultivo de hortaliças em plantio direto, com adubação verde
- • Curso no CTC-ITAL alinha ensino de qualidade com sucesso profissional
- • Instituto de Pesca fará mapeamento da pesca artesanal
- • Carne bovina: sustentabilidade deve nortear projetos de pesquisa em pecuária de corte
- • Possíveis perdas na agropecuária paulista em decorrência das chuvas, segundo o IEA
- • Preços agrícolas encerram mês de janeiro com alta de 1,15%
- • Avicultura: evento oficializa credenciamento do Biológico no diagnóstico de doença infecciosa
- • Café: produtores cooperados exibem melhores indicadores agronômicos e sócio-econômicos
- • Pecuária de corte: pesquisadores da APTA discutem programa de pesquisa para o Estado, no IZ/Sertãozinho
- ► Janeiro (19)
- • Suinocultura: pesquisa e setor produtivo vão apresentar proposta técnica sobre tratamento de dejetos
- • Preços agrícolas sobem 0,92% na terceira quadrissemana de janeiro
- • Suinocultura: pesquisadores discutem no IZ ações conjuntas de pesquisa para São Paulo
- • Produtores já adotam medidas mitigadoras da emissão de metano pelos animais
- • Preços agrícolas sobem 0,08% na segunda quadrissemana de janeiro
- • Saldo comercial do agronegócio paulista vai a US$ 9,68 bilhões em 2009
- • Preços agrícolas tem ligeira queda de 0,07% na primeira quadrissemana de janeiro
- • Votuporanga realiza I Encontro de Integração Lavoura-Pecuária-Floresta do Noroeste Paulista
- • FERRUGEM ALARANJADA DA CANA: SECRETARIA DE AGRICULTURA APRESENTA RELATÓRIO
- • Metodologia otimiza determinação de substância precursora do Tamiflu® e reduz impacto ambiental
- • ITAL divulga calendário de eventos de 2010
- • IB investe no gerenciamento de resíduos químicos
- • IAC lança nova edição da publicação Hortaliças e plantas medicinais
- • São Paulo lança abacaxi IAC Fantástico para substituir cultivares em uso no Brasil
- • APTA faz treinamento em diagnóstico de brucelose, tuberculose e outras doenças, em Andradina
- • Preços agrícolas quadrissemanais encerram 2009 com crescimento de 12,04%
- • Citros: pesquisa quer utilizar agentes biológicos para manter árvores até 2,5 m de altura
- • Mozarela de búfala: produção do sudoeste paulista deve ser destinada à Grande São Paulo
- • Preços agrícolas sobem 1,21% na terceira quadrissemana de dezembro
- ► Dezembro (17)
- ► 2009 (367)
- ► Dezembro (25)
- • PREÇOS AGRÍCOLAS SOBEM 2,13% NA SEGUNDA QUADRISSEMANA DE DEZEMBRO
- • CAFÉ PAULISTA: OS MELHORES DA SAFRA 2009 À DISPOSIÇÃO DO CONSUMIDOR
- • Segurança Alimentar será tema da terceira edição da revista Tecnologia e Inovação Agropecuária, da APTA
- • Cestas de madeira e bambu devem ser substituídas na colheita do morango, diz pesquisa preliminar do IB
- • CAPES apóia práticas de manejo e processamento sustentáveis na cadeia produtiva do pescado
- • Café: floradas irregulares causam apreensão para técnicos e produtores em 2009
- • Balança comercial paulista: saldo do agronegócio atinge US$ 8,85 bilhões em janeiro-novembro
- • Preços agrícolas sobem 1,72% na primeira quadrissemana de dezembro
- • Biodigestores: tecnologia para o manejo de efluentes da pecuária
- • Estudo sobre manejo de pastagens da APTA recebe prêmio em Simpósio de Iniciação Científica
- • Pesquisador fala de aquecimento global e seus impactos sobre a pesca, no Blog da Agricultura
- • IAC dá início à 40º Semana da Citricultura nesta segunda, 4
- • Instituto de Pesca participa de Reunião Científica na Venezuela
- • Pesquisadores da APTA recebem prêmios e homenagem no X Seminário Nacional de Milho Safrinha
- • Pró-Vinho: resultados de projeto de revitalização da cadeia produtiva serão apresentados em São Roque
- • Blog da SAA: aquecimento global e outos fatores do gênero que interferem na agricultura
- • Rodrigo Lima, do ICONE, fala de agricultura e mudanças climáticas no Blog da Secretaria
- • Pesquisa do Instituto de Pesca em maricultura: capítulo de livro nos Estados Unidos
- • Preços agrícolas sobem 1,48% em novembro
- • Balança comercial do agronegócio paulista tem saldo de US$ 7,87 bilhões em dez meses
- • João Demarchi, do IZ, no blog: mudanças climáticas e sustentabilidade na pecuária
- • Castanho, do IEA, no blog: questões sobre mudanças climáticas e agricultura
- • MUDANÇAS CLIMÁTICAS: NO BLOG DA SECRETARIA, A PARTIR DESTA QUARTA
- • Surubim-do-Paraíba: tema de projeto do Instituto de Pesca, com o apoio do CNPq
- • IZ avalia Sistema de Identificação Eletrônica de Bovinos
- ► Novembro (36)
- • Ácaros na agricultura: benefícios econômicos e sociais do novo laboratório do IB
- • Biológico inaugura novo Laboratório de Acarologia, para atender setor agrícola brasileiro
- • Preços agrícolas sobem 1,04% na terceira quadrissemana de novembro
- • IAC é credenciado pela Agência Nacional de Petróleo, Gás Natural e Biocombustíveis
- • Flores comestíveis: cada vez mais presentes na mesa do brasileiro
- • Ovinos e Caprinos: tecnologia do IZ chega à Universidade Federal do Piauí
- • IEA discute o papel das informações estatísticas para o agronegócio
- • Carrapato bovino: pesquisa inédita mostra alta resistência a carrapaticidas
- • Jumentos: IZ faz intercâmbio internacional para pesquisas de caracterização genética
- • Preços agrícolas sobem 1,09% na segunda quadrissemana de novembro
- • Workshop discute projeto e construção de carretas de transbordos para cana-de-açúcar
- • Preservação e recuperação de nascentes serão abordadas em curso em Nova Odessa
- • Biológico inaugura novas instalações de laboratório e recebe primeira ISO ambiental
- • IEA promove palestra Desenvolvimento territorial: água e vinho
- • ITAL promove o I Seminário de Biodiesel e Coprodutos, em Campinas
- • Carcinicultura de água doce e recifes de ostras: pesquisadores do Pesca em livros internacionais
- • Trabalho do IZ ganha 1º lugar em Simpósio Internacional sobre Forrageiras
- • Leite: Pólo Nordeste Paulista/APTA e CODEAGRO promovem curso em Mococa
- • Azeite de oliva: pesquisador italiano visita SP e ministra curso no Pólo Centro Sul da APTA
- • Preços agrícolas sobem 1,66% na primeira quadrissemana de novembro
- • Vencedor do concurso estadual de café: apoio da APTA à região produtora de Amparo
- • APTA promove eventos nesta sexta-feira, 13, no Vale do Ribeira, Itapetininga e Pinhalzinho
- • Primeiro levantamento da safra paulista 2009/2010
- • Bioenergia: tema de palestra no IEA e debate no blog da Secretaria de Agricultura
- • Milho safrinha: manejo de doenças da cultura é tema de livro lançado recentemente
- • Workshop apresenta diagnóstico da irrigação por pivô central no Nordeste Paulista
- • Mais de 200 trabalhos científicos serão apresentados na XXII Reunião Anual do Instituto Biológico
- • Preços agrícolas encerram outubro com alta de 2,58%
- • Leite para adultos: pesquisadores lançam livro e submetem questão a tribunal científico
- • Etanol: mandioca tem potencial para seguir os passos da cana-de-açúcar nos anos 1970
- • Censos agropecuários paulista e brasileiro, em palestras no IEA
- • Milho: reunião técnica apresenta resultados de avaliação de 80 cultivares no Estado
- • Banana: curso apresenta tecnologias para combater a doença da sigatoka negra
- • Feijão: quinta geração do carioca incorpora novos benefícios a produtor e consumidor
- • Nanotecnologias e Agricultura abre ciclo de palestras sobre os 67 anos do IEA
- • Preços Agrícolas sobem 2,43% na terceira quadrissemana de outubro
- ► Outubro (34)
- • Produtores venezuelanos de citros vem conhecer pesquisa e tecnología paulistas
- • FEILEITE 2009: ITAL leva Prumo e palestra sobre aspectos nutricionais e de saúde do leite
- • Valor da produção agropecuária e florestal paulista cai 8,3%, para 40,6 bilhões em 2009
- • Mudanças climáticas e pecuária, tema de workshop do IZ em Nova Odessa
- • Pinhão manso: dia de campo e reunião técnica discutem resultados de pesquisa
- • Pesquisadores da APTA participam de criação da Rede de Pesquisa em Bananicultura
- • IAC inaugura sistema protegido para maior coleção de citros do mundo
- • Hortaliças: pesquisadores da APTA participam de simpósio sobre cultivo protegido
- • Lula: abundância de captura pela pesca artesanal vem caindo na Ilha de São Sebastião
- • Preços agrícolas sobem 1,49% na segunda quadrissemana de outubro
- • Adubação verde pode ajudar no seqüestro de carbono e redução do efeito estufa e do desmatamento
- • IZ realiza o 2º Workshop de Bioética e Bem-estar Animal
- • IX Dia da Laranja do IAC foca o greening que torna as plantas improdutivas
- • Trabalho de recomposição de mata ciliar do Pólo Centro Norte/APTA vai a congresso mundial, em Buenos Aires
- • Agroenergia: workshop discute produção de biocombustíveis e culturas agroenergéticas em Ribeirão Preto
- • Açúcar puxa exportações paulistas do agronegócio nos primeiros nove meses do ano
- • Livro inédito de nanotecnologia na cadeia da soja será lançado em seminário em Manaus (AM)
- • ITAL reúne profissionais para o XI Seminário de Alimentação Escolar
- • Preços agrícolas sobem 0,82% na primeira quadrissemana de outubro
- • Pólo Alta Sorocabana/APTA monitora mosca da fruta na região de Presidente Prudente
- • Borracha natural: produção paulista cresce mas está longe das metas de autossuficiência
- • IP pesquisa pesca artesanal no Alto, Médio e Baixo Tietê
- • Instituto Biológico apresenta o mundo dos insetos em semana nacional de ciência e tecnologia
- • Pesquisadores da APTA participam de simpósio sobre liderança em momentos de crise
- • IAC e CATI participam do Simpósio de Cafeicultura Familiar, em Poços de Caldas (MG)
- • Projeto Pró-Vinho: entrevistados 950 produtores de uva na segunda fase
- • Agricultura familiar e tecnologias sociais nas regiões metropolitanas: seminário em Campinas
- • Biocombustíveis: pesquisadores do IAC e IEA participam de evento em Minas Gerais
- • Novo censo agropecuário do IBGE será discutido em palestra no IEA
- • PISCICULTURA É TEMA DE DISCUSSÃO NO NOROESTE PAULISTA
- • Estudo aponta custos de produção de café nas principais regiões produtoras do Brasil
- • Preços agrícolas quadrissemanais fecham setembro com alta de 0,22%
- • Ovinos: projeto busca viabilizar sistemas de produção sustentáveis para criador familiar
- • Macadâmia: primeiro encontro nacional da cadeia de produção
- ► Setembro (33)
- • Cogumelos: curso para aprimorar processos, desenvolver produtos e estimular consumo
- • Técnicos discutem demandas e carências da banana no Vale do Ribeira, maior produtor do Estado
- • Curso aborda produção de água e recuperação de nascentes no setor sucroalcooleiro
- • Preços agrícolas sobem 0,49% na terceira quadrissemana de setembro
- • Pesquisadores da APTA na conferência nacional de aqüicultura e pesca
- • Comunidade Manejo da Lavoura Cafeeira do Peabirus: mais de mil membros e presença em 84 países
- • Secretaria de Agricultura lança Blog
- • Seminário discute sanidade agropecuária em São Paulo
- • IZ promove workshop sobre alimentação e bem-estar dos eqüinos
- • Oficina sobre qualidade na operação de semeadoras, em Jundiaí (SP)
- • Carne de caprino: Unidade da APTA em Itapetininga desenvolve projeto de produção
- • Antúrio: APTA promove curso prático de cultivo no Vale do Ribeira
- • Tilápia: aproveitamento integral de resíduos é tema de mestrado
- • Preços agrícolas sobem 1,17% na segunda quadrissemana de setembro
- • Tilápia: dia de campo discute criação em tanque-rede de empresa rural
- • Encontro discute controle de carrapatos e outros parasitos de animais de importância econômica
- • Encontro incentiva criação familiar sustentável de suínos
- • Videira vinícola pode alcançar melhores índices de maturação na média altitude paulista
- • Saldo comercial do agronegócio paulista atinge US$ 6,19 bilhões até agosto
- • Eucalipto: encontro vai capacitar produtores e técnicos em manejo e comercialização
- • Qualidade do Café: região de Amparo prepara-se para 8º concurso estadual
- • Pesquisadora do IEA fala na CEAGESP sobre Seguro rural como gerenciamento do risco
- • Preços agrícolas sobem 1,98% na primeira quadrissemana de setembro
- • Programa IZ de Olho no Campo discute o potencial da cana-de-açúcar
- • FINEP aprova reforma de laboratórios multiuso do Instituto Biológico
- • Doenças de plantas medicinais são temas de palestras do Biológico em Socorro (SP)
- • Institutos da APTA apontam desafios da cadeia produtiva da carne frente à crise econômica
- • Peixes e camarões: ciclo de palestras apresenta novas tecnologias sobre policultivo
- • Macarrão de pupunha: desenvolvido pelo ITAL em parceria com a Palmito Pupunha São Cassiano
- • Pólo Leste Paulista da APTA participa de Festa do Cogumelo em Pinhalzinho
- • Começam na capital paulista as revoadas de cupins que atacam residências e árvores
- • Preços agrícolas sobem 2,67% em agosto
- • Elevado esforço de pesca e mortalidade de fêmeas imaturas: queda da abundância da lagosta-sapateira
- ► Agosto (35)
- • Pesquisadores do IEA analisam exportações do agronegócio por Estado brasileiro
- • Feira Agrotec 2009 discute tecnologia e mercado para os municípios do Circuito das Frutas
- • Câmaras Setoriais: várias reuniões agendadas para os próximos dias
- • Metade do cafezal paulista apresenta adensamento de mais de 3 mil plantas por hectare
- • Preços agropecuários: alta de 1,74% na terceira quadrissemana de agosto
- • Cana-de-açúcar: parceria de IAC, FAPESP e setor privado para aumentar produtividade, de olho no etanol sustentável
- • Pesquisador do IEA apresenta estudo em simpósio na Bahia que mostra dianteira de cultivares IAC de amendoim
- • IZ realiza 2º Workshop Nutrição de Suínos, em Nova Odessa (SP)
- • ITAL comemora 46 anos de pesquisa e difusão tecnológica na área de alimentos
- • IAC-APTA promove IX Curso de Atualização em Café
- • Simpósio brasileiro de produção de pescado, junto com a Feira Tecnocarne em SP
- • ITAL promove Congresso Brasileiro de Ciência e Tecnologia de Carnes, em SP
- • Criação e manejo de ovinos, tema do 4º Programa IZ de Olho no Campo
- • Preços agrícolas caem 0,24% na segunda quadrissemana de agosto
- • Instituto de Pesca promove oficina em Feira de Turismo Rural, na capital paulista
- • Reunião técnica apresenta novas tecnologias de trigo e outros cereais de inverno em Capão Bonito
- • Reunião técnica apresenta novos resultados de pesquisa sobre milho e sorgo para silagem
- • Pólo Centro Leste/APTA promove I Workshop da Macadâmia em Ribeirão Preto
- • Instituto de Zootecnia participa da Expogenética, em Uberaba
- • Congresso de iniciação científica do Biológico reúne bolsistas de várias instituições de pesquisa e ensino
- • Reunião técnica discute tecnologia, evolução e oportunidades do sistema de plantio direto
- • Saldo comercial do agronegócio paulista atinge US$ 5,31 bilhões no período janeiro-julho
- • Biológico estuda viroses emergentes em batata-semente importada
- • Preços agrícolas caem 1,88% na primeira quadrissemana de agosto
- • Encontro discute mudanças climáticas e seus efeitos sobre o café
- • Dia do Viveirista discute ações para combater o Greening, maior desafio da citricultura
- • Citros: delegação de São Paulo visita Estados Unidos
- • Instituto de Pesca inaugura Laboratório de Análise de Qualidade da Água
- • Mofo-branco na soja e outras culturas: atenção, principalmente no outono-inverno
- • IAC e ITAL apresentam projetos de Iniciação Científica no 3° CIIC 2009
- • Estudo aponta avanços no Projeto Vivaleite e defende sinergias com área de saúde
- • Preços agrícolas encerram julho com queda de 4,12%
- • Últimos dias para submissão de propostas para o Edital Universal - MCT/CNPq 14/2009 ( Data limite 05/Ago/2009 )
- • Controle biológico do IB identifica 20.900 insetos de várias partes do Brasil
- • Seminário vai explorar vantagens do Vale do Ribeira na piscicultura
- ► Julho (29)
- • China recebe em agosto tecnologia IAC de produção de batata-semente com variedades paulistas
- • Agrifam: alternativas do ITAL para agregar valor a produtos agropecuários
- • Pesquisadores defendem unificação de estatísticas sobre florestas e vegetação natural
- • Uso da água na horticultura é tema do Congresso Brasileiro de Olericultura
- • Preços agrícolas: queda de 3,34% na terceira quadrissemana de julho
- • Pesquisadores da APTA, eleitos para III Conferência Nacional de Aqüicultura e Pesca
- • Pesquisadoras do ITAL são premiadas em congresso de laticínios em Juiz de Fora
- • Maracujá: cultivar IAC 275, para sucos, vai além das fronteiras paulistas
- • I Fórum de piscicultura em tanque-rede do Sudoeste Paulista
- • Saldo comercial do agronegócio paulista aumenta 2,8%, para US$4,34 bi no primeiro semestre
- • Programa IZ de Olho no Campo: Conservação de pastagem é tema de palestra
- • Pesquisa do Biológico identifica presença de fungos em chás e condimentos
- • Preços agrícolas caem 1,98% na segunda quadrissemana de julho
- • Seminário discute direitos sociais e ambientais no setor sucroalcooleiro brasileiro
- • Reserva Legal: pagamento por serviços ecossistêmicos com base no custo de oportunidade das terras
- • Workshop do CEA-IAC trata de desempenho de pneus agrícolas e de carga (novos e reformados)
- • Projeto monitoramento embarcado da pesca industrial gera primeiro curso de capacitação
- • Preços agrícolas caem 0,94% na primeira quadrissemana de julho
- • Projeto agroflorestal com reeducandos de Instituto Penal Agrícola é premiado e vai ao Quênia
- • CEA-IAC pesquisa alternativas de energia para substituir o óleo diesel
- • Aos 40 anos, Centro de Engenharia e Automação do IAC inaugura laboratório de pós-colheita
- • Pesquisa avalia gorduras alternativas em chocolate
- • Novas instalações de unidade do IB em Bastos serão entregues na Festa do Ovo
- • Alta Paulista concentra maior área de produção de urucum, principal fonte de corante natural
- • IB estuda novos ácaros predadores para o controle biológico de pragas das culturas
- • Preços agrícolas fecham junho com ligeiro aumento de 0,56%
- • Estudo analisa mudanças e novos alinhamentos político-institucionais na citricultura paulista
- • Recomendações do Biológico para cuidar de frutíferas no inverno
- • Produção de agroenergia: pesquisa seleciona herbicidas para pinhão-manso
- ► Junho (37)
- • São Paulo: previsão de safra para café, cana e laranja
- • Secretaria apresenta quarta estimativa da safra paulista
- • Sementes de mexilhão (e seus benefícios) é tema de dissertação de mestrado no Instituto de Pesca
- • APTA INICIA PROCESSO SELETIVO PARA BOLSAS DE INICIAÇÃO CIENTÍFICA DO CNPq
- • Biológico e Prefeitura de Bauru desenvolvem pesquisa inédita sobre a mosca da abóbora
- • Preços agrícolas sobem 1,82% na terceira quadrissemana de junho
- • Valor da produção florestal paulista inclui valor potencial de áreas de conservação
- • Instituto de Pesca promove a II Semana do Pescador, em Santos
- • Aos 122 anos, IAC apresenta novo Laboratório de Análise Química de Fertilizantes e de Resíduos
- • Dia internacional do leite: pesquisadora do ITAL fala sobre opções disponíveis no mercado
- • IB inaugura novas instalações de Laboratório de Controle Biológico e recebe certificado ISO
- • Cana é o destaque do seguro rural subvencionado em São Paulo
- • Cana: pesquisa paulista tem dia de campo no cerrado goiano
- • Preços agrícolas sobem 2,65% na segunda quadrissemana de junho
- • Câmara Setorial de Milho paulista discute mercado e transgênico
- • Produção de cana-de-açúcar continua mais eficiente nas regiões tradicionais do Estado
- • Manejo em suinocultura: novo encontro do Programa IZ de Olho no Campo
- • Empresa holandesa doa equipamento ao Cereal Chocotec-ITAL
- • Saldo comercial do agronegócio paulista atinge US$ 3,38 bilhões no período janeiro-maio
- • APTA promove 1º encontro de citricultura da região sudoeste paulista
- • Abertura da colheita de café 2009 em cafezal urbano do Biológico
- • ITAL participa de dois eventos da área de alimentos
- • Preços agrícolas sobem 2,91% na primeira quadrissemana de junho
- • Instituto Biológico e Universidade da Geórgia (EUA) firmam termo de cooperação para erradicar doença de aves
- • IAC e ANVISA estudam reformulação de rótulos e bulas de agrotóxicos
- • Agricultura e meio ambiente: seminário discute temas como reserva legal e outorga da água
- • O selo de qualidade Padrão paulista da pecuária de corte está a caminho
- • Simpósio vai tratar de bebidas não-alcoólicas na Fispal Tecnologia 2009
- • Encontro apresenta novas pesquisas e tecnologias de milho e sorgo, em Votuporanga
- • IAC seleciona novos híbridos de copas e porta-enxertos resistentes a doenças dos citros
- • Preços agrícolas encerram mês de maio em alta de 3,38%
- • Pesquisadoras do Biológico apontam resistência a antibióticos em aves silvestres
- • Dia Mundial do Meio Ambiente: encontro Água e Meio Ambiente no IZ
- • Unidade de pesquisa de Tietê comemora 85 anos com seminário sobre produção e preservação
- • Biológico discute gerenciamento de resíduos químicos e industriais, em Semana do Meio Ambiente
- • 60 anos de truticultura: peixe ganha a mesa e o paladar do brasileiro
- • APTA desenvolve projeto de rede agroecológica para caiçara e comunidades tradicionais em Ubatuba
- ► Maio (28)
- • Preços agrícolas sobem 2,69% na terceira quadrissemana de maio
- • IAC realiza seminário sobre segurança e saúde no meio rural
- • IEA apresenta trabalho sobre estrutura produtiva da cafeicultura, em simpósio de pesquisas de café
- • Biológico cria 50 novos exames para diagnósticos de doenças animais
- • Mais de 40 palestras de especialistas nacionais e internacionais na 31ª Semana da Citricultura
- • Qualificação do impacto do lançamento de efluentes de aqüicultura em corpos hídricos naturais
- • Cadeia de produção de orégano é tema de livro do IAC
- • Pesquisadores da APTA no Simpósio de Pesquisa dos Cafés do Brasil, no Espírito Santo
- • Tilápias: Instituto de Pesca avalia criação e seus efeitos no meio ambiente, em busca do manejo sustentável
- • São Paulo divulga 1ª estimativa da safra de laranja e outras ações para o setor
- • Preços agrícolas sobem 2,41% na segunda quadrissemana de maio
- • Laboratório móvel Prumo Alimentos ITAL é atração na Feira APAS 2009
- • Seminário de hortaliças apresenta novas tecnologias, no Vale do Ribeira
- • Pesquisadores da APTA no Zootec 2009, congresso brasileiro e internacional de zootecnistas
- • Preços agrícolas sobem 2,22% na primeira quadrissemana de maio
- • Uso agrícola do lodo de esgoto: pesquisadores de EUA e Austrália em workshop do IAC
- • Primeiros números da cana-de-açúcar indicam aumento de 2,2% na produção paulista
- • Varíola bovina tem casos confirmados em vários estados brasileiros, diz Biológico
- • IAC recebe presidente da Confederação Nacional da Agricultura e agricultores
- • Saldo comercial do agronegócio paulista: US$ 2,45 bilhões no primeiro quadrimestre
- • Paulo Rabello de Castro fala sobre a crise global em palestra no IEA
- • Programa de Olho no Campo: palestras começam no dia 15
- • Em Monte Alegre do Sul, Seminário e Dia de Campo em Piscicultura
- • Instituto de Pesca tem pacote tecnológico para produzir robalo o ano inteiro
- • Preços agrícolas encerram abril com alta de 1,49%
- • Demanda por biodiesel pode chegar a 1,57 milhão de metros cúbicos em 2009
- • Em Paraguaçu Paulista, encontro discute manejo na produção agrícola sustentável
- • Dia de campo apresenta tecnologias de integração lavoura-pecuária
- ► Abril (37)
- • Preços agrícolas sobem 1,25% na terceira quadrissemana de abril
- • Com produtos florestais, valor da produção agropecuária vai a R$ 42,5 bilhões em SP
- • Pesquisador do IEA fala de café e crise em seminário da BM&FBovespa
- • Seminário aborda perspectivas e oportunidades no setor de lácteos
- • IAC apresenta novas variedades de amendoim na Agrishow
- • Preços ao produtor: alta de 0,80% na segunda quadrissemana
- • Novo serviço leva suporte tecnológico do ITAL até micro e pequenas empresas
- • Novas tecnologias e capacitação em encontro sobre pupunha no Vale do Ribeira
- • Workshop do IZ debate mudanças climáticas e sustentabilidade da pecuária
- • Agrishow: Secretaria transfere gabinete para Ribeirão Preto
- • IAC promove o IV Dia do Porta-Enxerto em Cordeirópolis (SP)
- • Pesquisadora do ITAL recebe prêmio da área de embalagem
- • ITAL treina profissionais da Vigilância Sanitária da região de Campinas
- • Pesquisadora do Instituto Biológico, homenageada em evento de suinocultura
- • Instituto Biológico desenvolve controle biológico do ácaro-rajado em morangueiro
- • Agrishow: Secretaria de Agricultura renova cessão de área para eventos ligados ao agronegócio
- • Governo paulista lança novo censo agropecuário
- • IAC recebe Consórcio Brasileiro de Pesquisa do Café
- • Encontro na Alta Paulista discute a expansão do plantio direto na palha
- • Reserva Legal em São Paulo: IEA defende revisão do Código Florestal
- • Erosão do solo faz parte da vida rural e urbana
- • O perigo das biotoxinas marinhas
- • Preços agrícolas caem 0,91% na primeira quadrissemana de abril
- • Exportações do agronegócio paulista atingem US$ 3,10 bilhões no primeiro trimestre
- • ITAL busca segurança na indústria de carnes com apoio de sistema internacional
- • IAC promove 1º Seminário sobre Conservação do Solo e Proteção de Recursos Ambientais
- • Robalo: APTA desenvolve projeto de crescimento e engorda em água doce no Vale do Ribeira
- • O chocolate no centro das atenções
- • Região de Marília é a principal empregadora em atividades não-agrícolas no meio rural
- • Diretor do IZ faz palestra sobre leguminosas forrageiras na Venezuela
- • Programa de sanidade em agricultura familiar será lançado em Monte Alegre do Sul
- • Búfalos e bovinos: seminário discute tecnologias de reprodução, no Vale do Ribeira
- • Preços agrícolas apresentam leve alta de 0,03% em março
- • BRUCELOSE E TUBERCULOSE: PÓLO REGIONAL DO EXTREMO OESTE/APTA TREINARÁ NOVOS TÉCNICOS DA DEFESA
- • Pesquisadores do ITAL orientam sobre compra, preparo e armazenamento de pescado
- • Pinhão manso: pesquisadores do Mali e da EPAMIG conhecem experiências da APTA no Vale do Paraíba
- • Instituto de Pesca: 40 anos de contribuições para a pesca e a aquicultura
- ► Março (30)
- • Estudo inédito mostra resistência do carrapato bovino a carrapaticidas
- • Seminário de piscicultura: produção de tilápia em tanques-rede em represa rural
- • IZ eConselho Nacional de Pecuária de Corte discutem parceria para projeto de sustentabilidade
- • IEA divulga estudo sobre impactos da crise mundial no agronegócio em 2009
- • Preços agrícolas: queda de 0,16% na terceira quadrissemana de março
- • Representantes de Honduras visitam ITAL para conhecer tecnologia de biodiesel
- • Ovinos: projeto de viabilidade de frigorífico será apresentado em Paraguaçu Paulista
- • LIMÃO TAHITI: DIA DE CAMPO MOSTRA IMPORTÂNCIA ECONÔMICA EM SP
- • SERINGUEIRA É TEMA DE PALESTRAS EM BARRETOS
- • Empresários peruanos do setor agroindustrial visitam o Instituto Biológico
- • Preços agrícolas: estabilidade na segunda quadrissemana de março
- • Câmara Setorial paulista discute mercado de milho e futuro do agronegócio
- • Pinhão manso: dia de campo apresenta tecnologia de produção e extração de óleo
- • Representantes de instituto alemão conhecem o ITAL e discutem parceria
- • Cereal Chocotec-ITAL oferece dois cursos em março
- • Agronegócio paulista: saldo comercial de US$ 1,08 bilhão no primeiro bimestre
- • IAC participa de reunião em Paris junto à OCDE
- • Venezuela já é o quinto destino das exportações do agronegócio
- • Dia de Campo de Feijão apresenta novas tecnologias em Capão Bonito
- • "Monoculturas regionais" em São Paulo exigem políticas públicas adequadas
- • Preços agrícolas sobem 1,02% na primeira quadrissemana de março
- • Curso teórico-prático trata de leites fermentados prebióticos e probióticos
- • Pesquisas em manejo integrado de pragas da goiaba são intensificadas
- • IEA promove palestra sobre globalização e o capitalismo contemporâneo
- • Centro APTA Citros do IAC realiza II Dia do Greening
- • Instituto Biológico lança livro sobre plantas ornamentais, doenças e pragas
- • I Workshop de Piscicultura do Noroeste Paulista
- • Curso do ITAL aborda gestão de projetos
- • PREÇOS AGROPECUÁRIOS ENCERRAM MÊS DE FEVEREIRO EM ALTA DE 1,70%
- • IEA promove curso de aperfeiçoamento em comercialização agrícola
- ► Fevereiro (28)
- • PREÇOS AGROPECUÁRIOS: ALTA DE 1,79% NA TERCEIRA QUADRISSEMANA DE FEVEREIRO
- • Oficina tecnológica aborda diagnóstico ambiental em áreas ciliares
- • Crise e valorização do dólar podem beneficiar a próxima safra de cana
- • Em Andradina, projeto de integração grãos-carne bovina em pastagens degradadas
- • Preços agrícolas sobem 2,38% na segunda quadrissemana de fevereiro
- • Sistema vai agilizar comunicação no setor agropecuário
- • Infestação predial de roedores em SP é tema de dissertação de mestrado no Biológico
- • Soja responde por 78,4% da produção de mais de um milhão de m3 de biodiesel
- • Pesquisa estuda variedades de cacau resistentes à vassoura-de-bruxa
- • IAC estuda viabilidade do café robusta em São Paulo
- • Reunião técnica discute plantio direto e integração lavoura-pecuária
- • Integração lavoura-pecuária: investimentos em equipamentos nos Pólos Regionais da APTA
- • Uso da água em laboratórios de pesquisa, tema de palestra no Biológico
- • Câmara Setorial de Café discute implantação do robusta em São Paulo
- • Preços agrícolas sobem 2,29% na primeira quadrissemana de fevereiro
- • Comitiva britânica conhece o ITAL
- • Saldo comercial do agronegócio: São Paulo teve aumento em janeiro de 2009
- • Oficina discute planejamento para proteção de áreas ciliares
- • Café: como inserir o produtor familiar no mercado de produtos diferenciados
- • Treinamento na Áustria para implementar boas práticas agrícolas em frutas e vegetais
- • Dia de campo de arroz: variedades de tipo especial e tecnologias para o produtor
- • Institutos de Pesquisa aprovam projetos em edital do CNPq no valor de R$ 4 milhões
- • Inflação no campo: preços agrícolas sobem 1,27% em janeiro
- • No Vale do Ribeira, curso vai capacitar produtores no manejo intensivo de leite a pasto
- • Dissertação de mestrado IEA analisa mudanças geradas por ciclo da cana em Araçatuba
- • ITAL moderniza estrutura para apoiar exportação e segurança alimentar
- • IZ participa do programa Prosa Rural da Embrapa
- • Diminuição global de rãs é estudada pelos Institutos de Pesca e Biológico
- ► Janeiro (15)
- • Uva Niagara: pico da oferta poderá mudar para o mês de agosto em SP
- • Encontro em Tatuí discute tecnologias de plantio direto e tendências do agronegócio
- • Preços agrícolas sobem 0,27% na terceira quadrissemana de janeiro
- • Dia de Campo de amendoim: novas cultivares e pesquisas para melhoria do grão
- • Primeira dissertação apresentada ao Programa de Pós-graduação do Biológico
- • Preços agrícolas caem 1,41% na segunda quadrissemana de janeiro
- • Workshop do IAC traz novas tecnologias de purificação de água para o reuso
- • Diagnóstico do perfil dos profissionais da pesca artesanal em Itanhaém (SP)
- • Setor de suínos e aves lidera crescimento nas exportações do agronegócio paulista
- • Calendário de eventos do ITAL: previsão de 70 treinamentos em 2009
- • Parques e museus da Secretaria de Agricultura são opções nas férias
- • Biológico atinge 100% de antígenos e tuberculinas aprovados pelo Ministério da Agricultura
- • Preços agrícolas subiram 4,12% no acumulado de 2008
- • Aumento de lodo de esgoto na agricultura gera maior demanda por pesquisas e tratamento
- • Preços agrícolas: queda de 1,65% no último mês de 2008
- ► Dezembro (25)
- ► 2008 (307)
- ► Dezembro (35)
- • PREÇOS: QUEDA DE 0,56% NA TERCEIRA QUADRISSEMANA DE DEZEMBRO
- • Preços Agrocpecuários: Alta de 0,67% na segunda quadrissemana de Dezembro
- • Balança comercial do agronegócio: confira o desempenho de janeiro a novembro
- • O papel do Instituto de Pesca no desenvolvimento pesqueiro paulista
- • Especialização em Tecnologia de Carnes inscrições abertas no Ital
- • SP: Safra de laranja para indústria aponta 306 milhões de caixas
- • Instituto de Pesca avalia gestão da pesca de siri-azul no Litoral Sul Paulista
- • Pesquisador sueco visita IB e colabora em projetos sobre a Mata Atlantica
- • Pesquisadora do ITAL é eleita presidente da Sociedade Brasileira de Ciência e Tecnologia de Alimentos
- • Leite: Câmara Setorial quer melhorar as relações comerciais na cadeia produtiva
- • Nova praga em citros: pesquisador do IB viaja a Roraima a convite do MAPA
- • Secretaria de Agricultura discute criação de selo de qualidade para pecuária de corte
- • Ostra-de-Mangue: Instituto de Pesca avalia captura e gestão no estuário de Cananéia (SP)
- • Hortaliças: Câmara Setorial lança projeto para obtenção de alimento seguro
- • Pesquisa avalia uso de xarope de glicose feito de mandioca em sistemas açucarados
- • Instituto de Pesca participa de Rede Latino-Americana de Conservação de Moluscos Bivalves
- • Preços Agrícolas: alta de 0,55% na primeira quadrissemana de dezembro
- • Curso de Especialização em Tecnologia de Carnes do ITAL tem inscrições abertas
- • Workshop sobre produção sustentável de oleaginosas e inclusão social
- • Agricultura Familiar: vitrine de produtos de propriedades referência da região de Monte Alegre do Sul
- • IZ realiza curso de controle alternativo de verminose em pequenos ruminantes
- • Dia de campo apresenta feijão preto IAC-Diplomata a produtores do Vale do Paraíba
- • Ácaros: IB oferece curso em Campinas
- • Fruticultura: dia de campo sobre novas tecnologias em sistemas de cultivo protegido
- • IAC reúne 800 produtores de hortaliças da região de Campinas para transferir tecnologia
- • Propriedade da terra e política agrícola no Brasil e nos Estados Unidos, em palestra no IEA
- • Agricultura orgânica: encontro discute tecnologias, legislação e gestão da qualidade
- • Floricultura: exportações crescem 6%, para US$ 30,7 milhões
- • Preços agrícolas encerram novembro com queda de 0,40%
- • Centro de Convenções da Cana: programação de eventos para 2009
- • Criadores de organismos aquáticos precisam desenvolver "mentalidade sanitária"
- • Ovinos: encontro discute manejos sanitário e de pastagens na Noroeste Paulista
- • Perspectivas da atividade de pesqueiros no Alto Tietê (SP)
- • Importação paulista de milho é de 3,34 milhões de toneladas em 2008
- • Piscicultura: seminário discute tecnologias e comercialização
- ► Novembro (35)
- • IAC lança a mais completa obra atualizada sobre cana-de-açúcar
- • Ribeirão Preto ganha Centro de Convenções da Cana-de-açúcar
- • Vitivinicultura: III Simpósio em Campinas
- • Preços agrícolas: queda de 0,98% na terceira quadrissemana de novembro
- • Encontro do Biológico discute perspectivas e desafios da avicultura, em Descalvado
- • Evento internacional aborda ingredientes utilizados pela indústria de alimentos
- • Secretário João Sampaio analisa o mercado de borracha natural
- • Tecnologia IAC deve reduzir viroses nos 4,5 milhões de hectares da bataticultura chinesa
- • Exportações do agronegócio paulista atingem US$ 14,47 bilhões no período janeiro-outubro
- • Instituições de pesquisa da APTA têm 327 novos servidores
- • Plantas medicinais e aromáticas serão discutidas em evento no Vale do Paraíba
- • Integração lavoura-pecuária: encontro discute tecnologia no Vale do Paranapanema
- • Preços agrícolas: queda de 1,44% na segunda quadrissemana de novembro
- • Valor da produção agropecuária paulista atinge R$ 37,7 bilhões em 2008
- • Pesquisadora do ITAL recebe prêmio na área de vigilância sanitária
- • Câmara Setorial de Milho: palestra sobre integração lavoura-pecuária, em SP
- • Pesquisa do IAC identifica vírus que reduz o tamanho das flores de hortênsias azuis
- • Pré-processamento da semente de urucum traz vantagens a produtores e empresas
- • Preços ao produtor caem 1,11% na primeira quadrissemana de novembro
- • Pesquisa busca aprimorar o aproveitamento de pele de tilápia
- • São Paulo estabelece cooperação com a China na área de biocombustíveis
- • ITAL trabalha no desenvolvimento de bebidas saudáveis
- • Workshop vai discutir pesquisas em horticultura dos institutos da APTA
- • Percepção de consumidores sobre riscos em cadeias de alimentos e bebidas
- • Unidade da APTA completa 50 anos de pesquisas de ovinos e caprinos em Itapetininga
- • Novo coordenador da APTA fala de seus planos para a pesquisa
- • Melhor café da safra é de São Sebastião da Grama
- • Projeto internacional com participação do ITAL gera dois seminários
- • Reunião técnica discute custos e novas tecnologias do milho safrinha e do sorgo
- • Os 100 anos da imigração japonesa e da edificação do Museu de Pesca
- • Preços agrícolas encerram mês de outubro com queda de 0,78%
- • Armazenagem de grãos e agricultura orgânica, em eventos no Biológico
- • Encontro discute bubalinocultura brasileira, no Vale do Ribeira
- • Cana: chineses fazem acordo com o Estado de São Paulo
- • Tilápia é o peixe mais produzido em viveiros escavados, no Médio Paranapanema
- ► Outubro (36)
- • Secretário João Sampaio participa de eventos no 81º aniversário do Instituto Biológico
- • Textura no desenvolvimento de alimentos é tema de curso no ITAL
- • Participação da Secretaria de Agricultura na Feileite
- • Zullo é o novo diretor-geral do Instituto Agronômico
- • Preços agrícolas: queda de 0,96% na terceira quadrissemana de outubro
- • ITAL discute biotecnologia aplicada à área de alimentos
- • IZ realiza I workshop sobre ambiência na produção de leite
- • Seminário aborda novas tecnologias voltadas para a produção do tomate
- • Área cultivada em SP pode atingir 1,4 milhão de hectares na safra das águas 2008/09
- • Workshop discute avanços técnicos e econômicos na cadeia produtiva do camarão de água doce
- • Secretário João Sampaio instala Câmara Setorial de Uva e Vinho, em São Roque
- • Reprodutores e matrizes de linhagens IZ serão leiloados em Ribeirão Preto
- • Estudo realiza levantamento e enfoca ecologia dos peixes da Serra do Japi (SP)
- • Secretário João Sampaio inaugura prédio da Pós-graduação do IZ
- • Horticultura: seminário em Ribeirão Preto discute agregação de valor
- • Tecnologia em máquinas para plantio direto, tema de Oficina em Capão Bonito
- • São Paulo impulsiona produção de uva e de vinho de qualidade
- • Pesquisadora do ITAL fala sobre propriedades do leite de cabra na Feileite
- • Preços agrícolas: queda de 1,33% na segunda quadrissemana de outubro
- • Pesquisadores da APTA tomam posse no CONSEA-SP
- • Novas Pesquisas e tecnologias do feijão, em congresso nacional realizado pelo IAC
- • Insetos e pragas urbanas em palestras no IB, na Semana Nacional de Ciência e Tecnologia
- • Exportações do agronegócio paulista atingem US$ 12,79 bilhões nos primeiros nove meses do ano
- • Montagem de aquário e reprodução de peixes ornamentais, em curso no Instituto de Pesca
- • IV Sintag Segurança em Tecnologia de Aplicação de Agrotóxicos, em Ribeirão Preto (SP)
- • Amendoim: inovações tecnológicas contribuem para aumentar e estabilizar oferta antes do plantio e da colheita
- • Preços agrícolas: queda de 1,71% na primeira quadrissemana de outubro
- • Workshop aborda futuro energético sustentável e produção de biocombustíveis
- • Dia da laranja aborda mercado de fertilizantes, inovação e qualidade
- • Workshop sobre prova de ganho de peso em bovinos de Corte, em Sertãozinho
- • Revista científica do ITAL completa dez anos
- • Preços agrícolas encerram mês de setembro com queda de 2,41%
- • Ciência para vida: APTA apresenta tecnologias dos Institutos e Pólos em Brasília
- • Pesquisadores do IAC-APTA no XX Congresso Brasileiro de Fruticultura
- • Dia de campo em Colina: resultados de pesquisa em recria e terminação de bovinos de corte
- • Inovação social e sustentabilidade, em palestra no IEA-APTA
- ► Setembro (24)
- • Pesquisadora do IEA-APTA fala sobre seguro rural em evento de corretores
- • Bem -estar de aves e suínos é tema de evento do ITAL
- • Preços agrícolas: queda de 3,87% na terceira quadrissemana de setembro
- • Programa IAC de capacitação para aplicadores de agrotóxicos, em Jundiaí e Campinas
- • Cachaça do Circuito das Águas Paulista pode ter indicação geográfica
- • Convocados os aprovados no concurso de apoio e assistente de pesquisa da APTA
- • Preços Agrícolas: queda de 4,51% na segunda quadrissemana de setembro
- • Seminário apresenta inovações tecnológicas na cultura da goiaba de mesa
- • ITAL-APTA participa da organização do Metroalimentos 2008
- • Evento mostra como plantio direto pode ajudar na produção de biodiesel
- • Alimentação animal: 1º dia de campo sobre melhoramento genético em Piracicaba
- • Exportações do agronegócio paulista atingem US$ 11,14 bilhões até agosto
- • Inscrições para curso de mestrado do IZ-APTA, IB-APTA e IAC-APTA
- • Palestra apresenta recomendações ao manejo da ferrugem asiática da soja
- • Variedades de cevada são destaques em dia de campo de cereais de inverno
- • Mais importante conferência científica internacional do café começa em Campinas
- • Pólo APTA Alta Sorocabana faz evento para homenagear japoneses
- • Bionergia: Governo do Estado disponibiliza banco de dados
- • Preços Agrícolas: queda de 4,40% na primeira quadrissemana de setembro
- • Projeto da APTA, premiado no VI Diálogo Interbacias de Educação Ambiental
- • IAC-APTA e Fundag patrocinam Prêmio Alcides Carvalho
- • Preços agropecuários encerram agosto com queda de 3,40%
- • ITAL-APTA inaugura planta-piloto de extração de óleos para biodiesel e alimentação
- • Café robusta, uma alternativa para os produtores rurais paulistas
- ► Agosto (31)
- • Variedades de cana IAC-APTA: potencial do cerrado para a produção de etanol
- • Aumentam as produções de cana-de-açúcar, café e milho, em São Paulo
- • ITAL completa 45 anos de pioneirismo em tecnologia de alimentos
- • Preços agrícolas caem 2,04% na terceira quadrissemana de agosto
- • II Workshop da Cachaça Paulista discute agregação de valor e mercado
- • Dia de Campo busca produtividade e qualidade nos pomares de tangerina
- • Lactobacilo melhora a qualidade do queijo prato
- • Bioética e bem-estar dos animais de produção, tema de workshop no IZ-APTA
- • Preços agrícolas: queda de 0,44% após três meses seguidos de alta
- • Reunião Técnica de Cereais de Inverno apresenta resultados de trigo e triticale
- • Doenças do milho, em palestra no ciclo de fitossanidade do IAC-APTA
- • Produtos lácteos: Simpósio internacional sobre prebióticos e probióticos
- • Exportações do agronegócio paulista crescem no período janeiro-julho, mas saldo comercial cai
- • Aberta a adesão de produtores de cana ao protocolo agroambiental paulista
- • Preços Agrícolas sobem 0,88% na primeira quadrissemana de agosto
- • Subprodutos da indústria bioenergética para produção animal, em workshop no IZ-APTA
- • APTA e Embrapa promovem curso de produção integrada de citros, em Novo Horizonte (SP)
- • Resíduo do processamento do leite de soja vira ingrediente para alimentos
- • Índice pluviométrico, cotação do dólar e o preço do boi gordo
- • A cadeia da tilápia se organiza
- • Ingrediente pode diminuir custos de produtos cárneos
- • Institutos da APTA são aprovados pela CAPES e oferecerão cursos de mestrado e doutorado
- • Etanol norte-americano feito do milho reduz oferta e aumenta preços dos alimentos
- • Encontro mostra resultados de pesquisa com irrigação em seringueira
- • Estudo pioneiro de criação do robalo em água doce, no Vale do Ribeira
- • Trabalho do Pólo APTA Alta Mogiana recebe prêmio do setor de suplementação mineral
- • Preços agrícolas encerram julho com alta de 2,87%
- • Queda da produção paulista de leite reduz emprego formal na cadeia produtiva
- • IB-APTA realiza congresso de iniciação científica para estudantes de graduação
- • Economia de água é tema de evento sobre lavagem a seco da cana, em Jundiaí
- • Treinamento para setores de chocolates, balas, confeitos, cereais, farinhas e panificação
- ► Julho (32)
- • APTA reúne ações de pesquisa em agricultura familiar
- • 2º Congresso Interinstitucional de Iniciação Científica apresenta 99 trabalhos
- • Seminário sobre gestão ambiental em áreas ciliares, em Jundiaí (SP)
- • Pólo APTA Alta Mogiana (Colina) tem maior valor da produção agropecuária do Estado
- • Preços agrícolas sobem 3,55% na terceira quadrissemana de julho
- • Plantio direto de tomateiro envarado, em projeto da APTA e UNESP-Jaboticabal
- • Congresso interinstitucional reúne trabalhos de jovens cientistas
- • Oferta de milho deve atingir 8,5 milhões de toneladas em SP, maior que a demanda
- • Inflação no campo: preços agrícolas sobem 3,81% na segunda quadrissemana de julho
- • IEA-APTA apresenta 15 trabalhos no Congresso da SOBER, em Rio Branco (AC)
- • Grupo da cadeia da cachaça promove workshop para produtores em Jaú
- • Tecnologia do plantio direto poupa insumos em época de petróleo caro
- • Bastos ganha novas instalações de laboratório avícola do IB-APTA
- • Pesquisadores do ITAL-APTA analisam presença de resíduos de agrotóxicos no caldo de cana
- • IZ-APTA promove curso de Western Blot, exigido na confirmação da aftosa
- • Agronegócio paulista tem saldo comercial de US$ 4,22 bilhões no primeiro semestre
- • Curso de aplicação de agrotóxicos alerta para a correta manipulação do produto
- • Pinhão manso: APTA desenvolve pesquisa com produção integrada de biodiesel no Vale do Paraíba
- • Instituto de Zootecnia (IZ-APTA) comemora 103 anos de pesquisa agropecuária
- • Ameaça da vespa-da-madeira ao Pinus será tema de palestra no IAC-APTA
- • Pesquisa estuda mercado de alimentos com apelo de conveniência e saúde
- • Inflação no campo: preços agrícolas sobem 3,37% na primeira quadrissemana de julho
- • Safra paulista de milho deve atingir 4,65 milhões de toneladas
- • Apesar dos preços, consumo de fertilizantes deve ser recorde na safra 2008/09
- • Sopa desidratada e biscoito de pescado, desenvolvidos pelo IP-APTA
- • Dia de campo vai reunir pesquisa e produtores para discutir qualidade do leite
- • Coordenador da APTA faz palestra em reunião de Comitê Assessor da Embrapa Meio Ambiente
- • Inflação no campo: alta de 2,42% nos preços agrícolas em junho
- • Integração cana-pecuária, tema de encontro do IZ-APTA em Sertãozinho
- • Exportações do agronegócio paulista atingem US$ 6,19 bilhões, de janeiro a maio
- • III Seminário AMBICANA avalia potencialidades regionais e debate manejo da cana
- • Perspectiva da pesquisa do agronegócio com a lei paulista de inovação tecnológica
- ► Junho (29)
- • Aniversário do IAC: apresentação do zoneamento da cana no Estado de São Paulo
- • Inflação no campo: preços agrícolas sobem 2,60% na terceira quadrissemana de junho
- • Degradação das várzeas da sub-bacia do Piracicaba: prejuízos para meio ambiente e agricultura
- • Importância da alimentação de peixes em tanques-rede
- • Pesquisa do ITAL-APTA vence o Prêmio Henri Nestlé na categoria graduação
- • Manual técnico sobre proteção de cultivares é lançado pela APTA
- • Prevenção, manejo e controle de pragas urbanas, em Encontro no Biológico
- • Estudo do IEA-APTA aponta contribuições dos imigrantes japoneses para a agricultura paulista
- • IZ-APTA, em ensaios nacionais para obtenção de cultivar-exemplo de milheto
- • ITAL-APTA na Fispal Food Service 2008
- • Inflação no campo: preços agrícolas sobem 3,53% na segunda quadrissemana de junho
- • Seminário Agricultura e Soberania Alimentar abre semana de aniversário do IAC-APTA
- • Pesquisa do ITAL-APTA é finalista do Prêmio Henri Nestlé
- • Governo paulista investe R$ 896,87 mil em pesquisa agropecuária no Vale do Ribeira
- • Ocupação de mão-de-obra infantil na agropecuária paulista cai para 21,1 mil menores em 2006
- • Água é o tema da primeira edição da revista da APTA, já disponível on-line
- • Reunião técnica apresenta resultados de avaliação regional de cultivares de milho
- • Projeto de criação de peixes em Comunidades de Quilombo no Vale do Ribeira, aprovado no CNPq
- • Aqüicultura: importância do gerenciamento da qualidade da água
- • Preços agrícolas sobem 4,59% na primeira quadrissemana de junho
- • IZ-APTA vende ovinos de várias raças
- • Parceria vai estimular pesquisas com plantio direto de hortaliças em S. José do Rio Pardo
- • Preços dos defensivos agrícolas caem em São Paulo no período de um ano, até abril
- • Roberto Rodrigues será um dos palestrantes de seminário da APTA
- • A busca pela qualidade do pescado
- • Colheita de café da safra 2008, no cafezal do IB-APTA na cidade de São Paulo
- • Dia internacional do meio ambiente e o consumo sustentável
- • Mosca-do-figo, desafio da pesquisa, será discutida em palestra no IAC-APTA
- • Inflação no campo: preços agrícolas encerram maio com alta de 5,49%
- ► Maio (25)
- • Pesquisadores da APTA participam do maior evento da citricultura
- • Simpósio de pescado discute segurança alimentar, inovação tecnológica e mercado
- • Na Fispal 2008, ITAL-APTA coordena simpósio sobre tendências em alimentos e bebidas
- • Inflação no campo: alta de 3,91% na terceira quadrissemana de maio
- • IAC-APTA reúne pesquisadores e produtores para falar de fruticultura em Jundiaí
- • Saldo comercial do agronegócio paulista encolhe 18%, para US$ 2,59 bilhões
- • Aqüicultura e piscicultura em tanques-rede, em discussão no Médio Paranapanema
- • Inflação no campo: preços agrícolas têm alta de 2,29% na segunda quadrissemana de maio
- • Exportações de carne bovina e a questão européia, em palestra no IEA
- • APTA tem primeira fazenda de bovinos de Corte certificada do Estado de São Paulo
- • Estado vai investir R$ 830 mil em ovinos e caprinos no Sudoeste Paulista
- • Curso orienta sobre controle da Sigatoka Negra, no Vale do Ribeira
- • Projeto Ambiental do Pólo APTA Centro Norte, em eventos em S. J. do Rio Preto
- • No Museu de Pesca de Santos, Agricultura inicia homenagem ao centenário da imigração japonesa
- • Inflação no campo: preços agrícolas sobem 0,89% na primeira quadrissemana de maio
- • Seminário ITAL-APTA discute setor de biscoitos
- • IAC-APTA organiza simpósio de certificação de cafés sustentáveis
- • Lançado livro da cadeia de produção do leite, em São Paulo
- • ITAL-APTA treina provadores de café para avaliar a qualidade
- • Laranja: produção paulista deverá atingir 368,2 milhões de caixas
- • Inflação no campo: tomate, trigo, carnes e leite sofrem aumentos
- • Dia de campo discute mercado futuro e novas tecnologias de milho
- • O 1º Workshop sobre Nutrição de Suínos, em Nova Odessa (SP)
- • Segurança Alimentar será tema de Seminário da APTA, em Campinas (SP)
- • Expansão da cana em SP: incorporados 673 mil hectares de pastagem cultivada
- ► Abril (27)
- • IZ-APTA apresenta amostras de leguminosas forrageiras e capim na Agrishow
- • Valor da produção agropecuária paulista atingiu R$ 31,8 bilhões em 2007
- • Inflação no campo: preços agrícolas caem 0,50% na terceira quadrissemana de abril
- • Produtos do ITAL-APTA poderão ser degustados na Agrishow Ribeirão Preto
- • IAC-APTA apresenta na Agrishow programa pioneiro em treinamento de aplicadores de agroquímicos
- • A APTA na Agrishow Ribeirão Preto
- • Exportações do agronegócio paulista caem para US$ 3,45 bi no primeiro trimestre
- • Aumentam as produções de cana-de-açúcar, milho e soja, em São Paulo
- • ITAL-APTA lança livro sobre embalagens rígidas
- • Nova edição da Revista Tecnologia e Inovação Agropecuária recebe artigos
- • Inflação no campo: preços agrícolas sobem 0,74% na segunda quadrissemana de abril
- • Nomeados 18 pesquisadores para ocupar cargos vagos na APTA-Pólos
- • Alerta aos citricultores para ataques de praga que derruba ramos de frutos da planta
- • ITAL-APTA realiza treinamento sobre produtos diet e light
- • Nomeados 17 pesquisadores para ocupar cargos vagos na APTA
- • IZ-APTA realiza II Encontro Técnico sobre Leguminosas Forrageiras
- • Inflação no campo: preços agrícolas sobem 2,95% na primeira quadrissemana de abril
- • Instituto de pesca (IP-APTA) comemora 39 anos
- • Pesquisadores da APTA-Pólos recebem prêmio em Congresso de Avicultura
- • Lançado novo livro sobre a história do café
- • Diagnósticos de doenças em organismos aquáticos e de qualidade da água
- • Trabalho do ITAL-APTA desenvolve hambúrguer magro e funcional
- • Inflação no campo: preços agrícolas sobem 3,75% em março
- • ITAL-APTA oferece suporte ao setor de barrinhas
- • Projeto APTA/FAPESP vai beneficiar agricultores familiares nas cabeceiras do Alto e Médio Tietê
- • Pesquisa paulista inicia ações de controle da mosca negra dos citros
- • IEA-APTA cria índice de mecanização na colheita da cana em São Paulo
- ► Março (15)
- • APTA promove curso de brucelose, tuberculose e EET em Presidente Prudente
- • Inflação no campo: preços agrícolas sobem 3,50% na terceira quadrissemana de março
- • ITAL completa dez anos de certificação ISO 9001
- • Balança comercial de pescado: Brasil exportou US$ 316,79 milhões em 2007
- • IZ venderá 268 bovinos, em Sertãozinho
- • Algodão orgânico na América Latina será discutido no Ceará e em São Paulo
- • Conferência internacional de embalagens flexíveis, no ITAL
- • Os 45 anos de política de crédito agrícola, em palestra no IEA
- • Controle biológico é opção para combate ao ácaro rajado do morangueiro
- • APTA convoca pesquisadores concursados para preencher vagas nos Pólos Regionais
- • Inflação no campo: preços agrícolas sobem 1,87% na segunda quadrissemana de março
- • APTA convoca pesquisadores concursados para preencher vagas nos Institutos
- • Pesquisadora dá dicas para a escolha do peixe da Sexta-feira da Paixão
- • Importações do agronegócio paulista crescem 68,9%, para US$ 1,25 bilhão
- • Ótima engorda com uso de feno da rama de mandioca na alimentação de ovinos
- ► Fevereiro (9)
- • Um perfil detalhado do consumidor paulistano de café fora do lar
- • Cafeicultores paulistas utilizam mais títulos financeiros na comercialização
- • Pesquisa da APTA faz diagnóstico inédito da piscicultura no Médio Paranapanema
- • Instituto de Pesca observa peixes para avaliar a degradação ambiental
- • INSTITUTO DE PESCA TRABALHA PELA BOA QUALIDADE DO PESCADO
- • Agência aposta em pesquisa com pinhão-manso
- • A DATA LIMITE PARA INSCRIÇÕES DOS ARTIGOS PARA A PRIMEIRA EDIÇÃO DA REVISTA TECNOLOGIA E INOVAÇÃO AGROPECUÁRIA FOI PRORROGADA ATÉ 22 DE FEVEREIRO.
- • INSTITUTO DE PESCA E APTA PÓLOS DESENVOLVEM TÉCNICA PIONEIRA DE PLANTIO DE ARROZ COM PRODUÇÃO DE CAMARÃO
- • Grupo Jalles Machado e IAC realizam dia de campo de cana-de-açúcar voltado ao cultivo no Centro Oeste brasileiro
- ► Janeiro (9)
- • Estão abertas as inscrições para a sexta edição do curso a distância Tópicos da cultura da cana-de-açúcar
- • Pesquisadores testam técnicas que reduzem as perdas da uva cv. Niagara
- • Pólo APTA Centro Oeste: Sistema de irrigação promete aumentar produção de cana em SP
- • Estão abertas as inscrições de artigos técnicos para a primeira edição da Revista Tecnologia e Inovação Agropecuária da Série Técnica APTA
- • CONDIÇOES AGROMETEOROLÓGICAS E A SECA NO ESTADO DE SÃO PAULO
- • IZ intensificará pesquisas para ovinocultura em 2008
- • IZ abre inscrições para o 4º Minicurso de ELISA para diagnóstico e aplicações no agronegócio
- • ITAL faz diagnóstico de barreiras ambientais para exportação de frango
- • Um cafezal no meio da cidade
- ► Dezembro (35)
- ► 2007 (796)
- ► Dezembro (9)
- • Informações sobre Genoma dos citros estarão disponíveis em janeiro
- • Preços dos principais defensivos agrícolas caem em São Paulo
- • I Encontro de Educação Ambiental acontece amanhã, 14, no Pólo APTA Centro Norte
- • Pesquisa APTA identifica variedades resistentes e manejo adequado para produção orgânica de batata
- • IB INAUGURA LABORATÓRIO DE REFERÊNCIA EM PRAGAS URBANAS
- • Em Campinas, pesquisadores realizam a 1ª Reunião Nacional da Cadeia Produtiva do Urucum
- • Pesquisadora do IEA indicada para avaliar curso de faculdade gaúcha
- • Carne bovina: Comunidade Européia aperta o cerco sobre rastreabilidade
- • Programa Cana IAC lança quatro variedades de cana-de-açúcar
- ► Novembro (12)
- • Variedades de feijão IAC trazem tipo colorido inédito no Brasil e carioca com melhor grão do mercado
- • IZ realiza 1º Workshop sobre Alternativas de controle da verminose em pequenos ruminantes
- • Demanda paulista de milho cresce 3,1%, para 7,7 milhões de toneladas
- • Ciclo Debates IEA 65 anos: seminário Gerenciamento de risco no agronegócio, em novembro
- • Milho: perspectiva de abastecimento interno tranqüilo em 2008
- • Qualidade do leite é tema do Workshop promovido pelo IZ
- • No Aniversário Do IEA, Mais De 200 Pessoas E Propostas Para O Estado E O País
- • A bioenergia em debate na APTA
- • Câmara Setorial do Café e ABIC vão harmonizar programas de qualidade
- • ITAL cria Grupo de Desenvolvimento Regional, com instituições externas
- • Reprodutores e novilhas de linhagens IZ serão leiloados esta semana
- • Exportações e adulteração do leite, em debate na reunião da Câmara Setorial
- ► Outubro (16)
- • Câmara Setorial de Leite reúne-se na FEILEITE
- • Valor da produção agropecuária paulista atinge R$ 30,6 bilhões em 2007
- • Câmara Setorial de Caprinos e Ovinos quer selo paulista de qualidade
- • APTA e Fapesp reúnem-se para tratar da pesquisa agropecuária no Estado
- • APTA cria grupo de nanotecnologia para Agronégocio
- • Pesquisa da APTA com plantas medicinais apóia serviço municipal de saúde
- • ENCONTRO CELEBRA OS 20 ANOS DA ASSOCIAÇÃO BRASILEIRA DE TRUTICULTORES
- • Oficina discute técnicas para otimizar uso de semeadoras
- • Aprovados em concurso para pesquisadores da APTA têm até 26 de outubro para tomar posse
- • MONTAGEM DE AQUÁRIOS É TEMA DE CURSO NO INSTITUTO DE PESCA
- • Semana da Alimentação - Pesquisas vão do campo à industrialização
- • Nova edição do Manual sobre Hortaliças e Plantas Medicinais
- • Produção familiar de suínos com controle de qualidade
- • Orçamento para a área de agricultura em SP é de R$ 610 milhões e há propostas de aumento para 2008, diz secretário
- • ALIMENTOS FUNCIONAIS
- • Programa Laranja Nota 10 tem sua primeira variedade selecionada
- ► Setembro (10)
- • Bovino e suinocultura serão temas do 6º Seminário Inovações Tecnológicas do IZ
- • Cana-de-açúcar é tema da 12ª Reunião Técnica sobre Produção Intensiva de Ovinos do IZ
- • Integrar e Inovar: Foco DGE/APTA
- • Nova ruralidade será tema de palestra no Seminário Organização e desenvolvimento territorial
- • IZ realiza 1º Minicurso de Citogenética de Animais de Interesse Zootécnico (13 e 14/09/2007)
- • Comissão de Bioenergia estuda produção de energia a partir de florestas
- • Segurança alimentar responde por 42% dos projetos de pesquisa da APTA
- • Pesquisa pioneira no IAC visa acelerar desenvolvimento de variedade de feijão
- • Sobre os parasitóides de Planococcus minor (Maskell) (Hemiptera, Pseudococcidae), praga potencial do algodoeiro no Brasil
- • Preços Agropecuários Encerram Mês De Agosto Com Alta De 3,84%
- ► Agosto (77)
- • IZ é parceiro no 1º Circuito Cidadão de NO
- • Iº Minicurso de Citogenética de Animais de Interesse Zootécnico
- • Câmara Setorial da Carne Bovina quer fundo indenizatório, em apoio a Risco Zero
- • INSTITUTO DE PESCA INTEGRARÁ O CONJUNTO DE SEMINÁRIOS DA SEAFOOD EXPO LATIN AMERICA
- • ITAL recebe trabalhos para Simpósio de aproveitamento de subprodutos e resíduos
- • Câmara Setorial de Produtos Florestais quer mudança na reserva legal em SP
- • CENTRO DE TECNOLOGIA PARA CEREAIS E CHOCOLATES COMPLETA 10 ANOS
- • A Força De Volta Ao Campo
- • Importação paulista de milho aumenta 6,7%, para 3,298 milhões de toneladas
- • Área de milho com sementes melhoradas deve aumentar 5% na safra 2007/08
- • Recursos do FEAP/BANAGRO para ovinos e caprinos e exigências sanitárias
- • Projeto prevê planta-piloto para a cadeia de ovinos, com apoio da FAPESP
- • II Dia de Campo de Tangerina traz tecnologias para Socorro
- • IZ abre inscrições para o 5º Seminário Inovações Tecnológicas (31/08/07)
- • Brasil produz cerca de 1,2 milhões de sacas de café especial
- • Previsões da Conab contrariam expectativas para a safra atual
- • Preços Agropecuários: Alta De 4,92% Na Segunda Quadrissemana De Agosto
- • PARA ONDE VAI A TILÁPIA
- • Diesel determina lucratividade dos produtores de soja
- • Moinhos brasileiros antecipam importação de trigo
- • Australianos apostam em algodão transgênico no Brasil
- • SP continuará com redução da queima de cana
- • Brasil ainda não conseguiu abrir o mercado chinês às carnes brasileiras
- • Agroindústria cresce menos que a agropecuária
- • IAC realiza VII curso de atualização em cafeicultura
- • Pode sobrar 11 bilhões de litros de etanol em 2012
- • Mercado de boi gordo, soja e milho são destaques na BM&F
- • Exportações de café solúvel devem chegar a 2,79 milhoes de sacas no ano
- • Balança Comercial Dos Agronegócios Paulista E Brasileiro, Janeiro A Julho De 2007
- • Renda agrícola deve crescer 12%
- • Novo prazo para mudança da Guia de Trânsito Animal
- • AGRONEGÓCIO: Cenário é positivo, apesar de problemas no País
- • Índia está de olho no etanol produzido no Brasil
- • Brasil volta a comprar trigo da Argentina
- • Mercado De Álcool: Desajustes E Excesso De Expectativas
- • Café fechou em alta na sexta-feira
- • Classificação de soja terá cartilha explicativa
- • MAPA PROMOVE 6º AGROINT EM PETROLINA
- • Utilização dos derivados de boi será tema de exposição na TecnoCarne 2007
- • PREÇOS AGROPECUÁRIOS INDICAM RECUPERAÇÃO PARA PRODUTORES
- • Aquecimento global baterá recorde após 2009
- • Brasil pode colher mais de 60 milhões de toneladas de soja em 2008
- • Produção de trigo crescerá mais de 66% este ano
- • ESTRADAS RURAIS, CANA E EXPOJAÚ NA AGENDA DESTE SÁBADO
- • Produção de cana cai 1,5% de abril a junho
- • Café - leilão negocia 98,32% da oferta
- • PINHÃO MANSO PARA PRODUÇÃO DE BIODIESEL: UM PROMISSOR NEGÓCIO OU UM GRANDE DESASTRE
- • Arroba do boi gordo segue com recordes diários
- • CNPq selecionará propostas para apoiar eventos
- • Brasil perde divisas de US$ 70 milhões anuais na exportação da soja
- • Quilo da carne está até 32% mais caro
- • Sementes ilegais prejudicam agronegócio
- • MAPA PROMOVE INCLUSÃO DIGITAL DO HOMEM PANTANEIRO
- • Pesquisadores estudam produtos obtidos de cacau danificado por vassoura-de-bruxa
- • Café: Uma Lavoura Ensandecida
- • Demanda de citros garante novas altas em SP
- • Conab eleva estimativa da safra 2006/07 de grãos
- • EXPORTAÇÃO DE CACHAÇA CRESCE 15%
- • CÂMARA DA CARNE BOVINA AVALIA AUDITORIAS DA UNIÃO EUROPÉIA E MUDANÇAS NO SISBOV
- • CONAB DIVULGA NOVO LEVANTAMENTO DA SAFRA
- • Cotação do arroz supera R$ 22 no RS
- • Febre aftosa na Europa pode ajudar o Brasil
- • Seminário Discute Política Econômica, Crescimento E Renda Na Agricultura, Nos 65 Anos Do IEA
- • CAFÉ TERÁ PADRÕES MÍNIMOS DE QUALIDADE
- • SP muda regras para licença ambiental
- • Exportação americana provoca alta dos grãos
- • Preços Agropecuários Encerram Julho Com Queda De 0,80%
- • ALTA DOS PRODUTOS DE ORIGEM ANIMAL PODE PUXAR INFLAÇÃO PARA CIMA
- • Safra do algodão não recupera prejuízos em SP
- • Funcafé promove dez leilões
- • DEFESA AGROPECUÁRIA É PRIORIDADE DO GOVERNO, DIZ STEPHANES
- • SECRETARIA ANUNCIA MUDANÇA NO CRÉDITO PARA AGRICULTURA FAMILIAR
- • Alimentos pressionam e IGP-M registra alta de 0,28% em julho
- • Preço do leite ao produtor reage 9,23% em julho
- • SISBOV: 47 MIL ANIMAIS MIGRAM PARA NOVO SISTEMA DIARIAMENTE
- • FUNCAFÉ PROMOVE 10 LEILÕES ATÉ O FINAL DESTE ANO
- • APTA MÉDIO PARANAPANEMA: 20 ANOS DE INOVAÇÕES EM GRÃOS
- ► Julho (96)
- • Milho: Produção recorde pode não acontecer
- • Produtor de laranja e indústrias começam negociação para a safra
- • Avicultura hindu, como a brasileira, quer regionalização da atividade
- • Greve de fiscais provoca filas e lotação em armazéns
- • CAFÉ: CONSUMO INTERNO PASSA DE 17 MILHÕES DE SACAS
- • Agroindústria brasileira cresce 1,29% entre janeiro e abril
- • Ministério propõe tarifa menor para adubos
- • Safra de café vale 22,7% menos este ano
- • Mercado continua favorável para o milho
- • Pesquisadores do IZ na 44ª Reunião da SBZ
- • Preço pago ao produtor de leite sobe pelo quinto mês consecutivo no país
- • SECRETÁRIO DE DEFESA AGROPECUÁRIA APRESENTA RESULTADOS DA VIAGEM À RÚSSIA
- • Tarifa de importação de fertilizantes será reduzida
- • Biocombustíveis E Insegurança Alimentar
- • Projeto regula importação de genética de aves
- • Melhora qualidade do trigo brasileiro
- • Feijão perde espaço no prato do brasileiro
- • Preços Agropecuários: Queda De 2,88% Na Terceira Quadrissemana De Julho
- • Com preço em alta plantio da soja beira recorde
- • Cotação do trigo deve permanecer elevada
- • Vácuo de legislação no setor de turismo rural será um dos temas da 4a FEIRATUR
- • APTA Regional já responde por 46% dos novos projetos de pesquisa do agronegócio
- • Menor preço do algodão para os produtores brasileiros
- • Ovo em alta
- • Brasil deve comandar controle à aftosa na América do Sul
- • REUNIÃO DA CÂMARA DO LEITE SERÁ NA SEDE DA CNA
- • Área de soja deve aumentar 7% na safra 2007/08
- • Começa amanhã seminário sobre trigo no Brasil
- • Soja a US$ 9 por bushel ajuda, mas não salva
- • Renda com cana-de-açúcar será menor
- • TÉCNICOS DA CONAB ESTÃO EM CAMPO PARA O PENÚLTIMO LEVANTAMENTO DA SAFRA 2006/2007
- • Reserva florestal produtiva: carro chefe da Câmara Setorial de Produtos Florestais
- • ZONEAMENTO DE CULTURAS BIOENERGÉTICAS NO ESTADO DE SÃO PAULO
- • Preços do trigo voltaram após forte queda nos dois últimos pregões
- • Mapa e Abic promovem exposições sobre café
- • Ataque irlandês à carne bovina brasileira é inconsistente
- • PREÇOS AGROPECUÁRIOS RECUAM 4,84% NA SEGUNDA QUADRISSEMANA DE JULHO
- • Não existe risco de embargo da exportação de carne bovina
- • Mapas de zoneamento restringirão o plantio de cana-de-açúcar
- • Consultoria estima aumento de 30% no consumo de álcool
- • Pesquisadores Do IEA E APTA Regional, No Congresso Anual De Engenharia Agrícola
- • PESQUISADORES DO IEA PARTICIPAM DE CONGRESSO DA SOBER
- • Mapa vai exigir certificação de armazenagem
- • Câmara Setorial de Agricultura Ecológica na 4a Feira de Turismo Rural
- • Muito além do Milho: o potencial do etanol
- • Preço da arroba do boi sobe 15%
- • MAPA DIVULGA ZONEAMENTO PARA CULTURA DE MAMONA EM CINCO ESTADOS E NO DF
- • Cotação do arroz sobe mesmo com importação 25% maior
- • Sobe preço de derivados do trigo
- • Volume das exportações de frutas cresce 14% no 1º semestre
- • Avança colheita de milho safrinha no país
- • Comercialização de café já atinge 22% do total
- • Argentina esmaga menos soja e dá espaço para o Brasil
- • Produtor de trigo poderá ser melhor remunerado em 2007/08
- • SAI EDITAL PARA NOVAS PROVAS
- • Instituto de Zootecnia comemora 102 anos de pesquisa agropecuária
- • Seminário Política econômica e renda na agricultura, nos 65 anos do IEA
- • Brasil e EUA afirmam que etanol é o "combustível do futuro"
- • Preços futuros do trigo fecharam com forte alta
- • Segundo leilão Pepro / café vende 100% da oferta
- • Exportação de carne bovina tem receita recorde no semestre
- • Câmaras Setoriais de arroz e feijão querem os produtos na merenda escolar.
- • Apta Regional: Pólo Sudoeste Paulista estuda desenvolvimento de tecnologia de congelamento de massa para produção de mussarela de Búfala
- • Está em falta farinha de trigo no Brasil
- • Pecuária e cana, o que é mais lucrativo
- • Preços do algodão sofrem quedas menos intensas
- • Brasil poderá exportar dez vezes mais algodão
- • Sojicultor paulista que não cumprir vazio será multado
- • Governo planeja carência de até cinco anos a agricultores
- • São Paulo limita queima da palha da cana ao período noturno
- • Carne Cultivada: Uma Possibilidade?
- • Plantio de cana pode sofrer restrições
- • Produtor retém café em plena colheita
- • Começa processo para mercado de biocombustível
- • BALANÇA COMERCIAL: EXPORTAÇÕES DE CARNES ATINGEM us$ 10 BILHÕES NOS ÚLTIMOS DOZE MESES
- • JUNHO TEVE QUEDA DE 3,80% NOS PREÇOS AGROPECUÁRIOS
- • BACIA HIDROGRÁFICA DO ALTO TIETÊ: PESQUISAS DO INSTITUTO DE PESCA ANALISAM COMPLEXIDADE DO SISTEMA
- • Produção mundial de café deve cair 9,2% na próxima safra
- • Safra de milho fica nos 50 milhões de toneladas em 2007
- • Governo reconhece que a cana toma espaço de grãos
- • O Poder De Compra Sob As Luzes Da Ribalta
- • Frango vivo tem primeira alta do mês; em São Paulo e em Minas
- • Poder de compra de produtor de leite supera o de carne
- • Produção brasileira de soja pode passar a dos EUA em 2009
- • BM&F apresenta modelo de hedge em reunião da Câmara Setorial de Soja
- • Uma proposta de subvenção ao prêmio em operações de mercado contra riscos
- • Exportações de frango e suínos cresceram em maio; bovinos caíram
- • Preço do leite continua em franca ascensão em São Paulo
- • Demanda aquecida sustenta cotação da laranja em SP
- • Conab mantém estimativa de safra recorde de grãos
- • Exportação de milho cresce 20% em volume em junho
- • Mel vira sistema de alarme contra poluição
- • Fenômeno La Niña influencia no volume de chuvas
- • Cafeicultores estão à espera de preços melhores
- • O Que A Agricultura Importa?
- • SP adota vazio sanitário contra ferrugem da soja
- ► Junho (80)
- • Pólo Regional da Alta Mogiana promove leilão de eqüídeos na 30 ª Festa do Cavalo
- • Café sofre revés no plano institucional
- • Conab divulga nova estimativa da safra na terça-feira
- • Mudança Do Nome Para Revista De Economia Agrícola
- • Assista às comemorações do aniversário do IAC no www.noticiasagricolas.com.br
- • CONAB DIVULGA NOVO LEVANTAMENTO DA SAFRA 2006/2007
- • Maior Produção De Cana-de-açúcar E De Laranja E Safra Menor De Café Em SP
- • STEPHANES LANÇA AGENDA DE TRABALHO PARA AMPLIAR A COMPETITIVADE DO AGRONEGÓCIO BRASILEIRO
- • Abate de frangos cresce 2,1% no primeiro trimestre
- • MAIS RECURSOS E QUEDA DE JUROS NO PLANO AGRÍCOLA E PECUÁRIO 2007/2008
- • IAC comemora 120 anos com mais um produto diferenciado no mercado
- • Preços da soja subiram na bolsa de Chicago
- • Brasil usará mais álcool e gás
- • Café, Cafés E Cafeterias
- • Leilão de Pepro para o café acontece hoje
- • Brasil pode enfrentar crise na oferta de fertilizantes
- • Produção brasileira de algodão supera 1,5 milhão de toneladas
- • Seminário de Bioenergia abre comemorações dos 65 anos do IEA
- • Agronegócio garante superávit para comércio de São Paulo
- • Arroba do boi caminha para R$ 60 no mercado paulista
- • Mercado de frango vivo abre a R$ 1,45
- • Agroindústria registra aumento das exportações no trimestre
- • Belgas visitam cultivos de café no Brasil
- • São Paulo reduz em 4% área de queima de cana
- • MAPA DEFINE MÉTODOS PARA ANÁLISE DE METAIS PESADOS EM INSUMOS
- • São Paulo: feira em Holambra propicia negócios a floricultores gaúchos
- • Setor de café pede revisão de incentivo
- • Exportação de milho deve atingir 4 milhões de ton no semestre
- • Sojicultor do RS tem lucro 27% maior com transgênicos
- • Exportações do agronegócio em SP subiram 29,8% entre janeiro e maio
- • Pesquisador Mexicano realizará palestra no IZ sobre gramíneas forrageiras
- • CURSO ABORDA MONTAGEM E MANUTENÇÃO DE AQUÁRIOS DE PEIXES ORNAMENTAIS
- • Fórum debate mercado do leite
- • Fundecitrus ressalva o perigo do greening na 29ª Semana da Citricultura
- • Feicorte - leilões com animais de elevado padrão genético e variedade de raças
- • As Mudanças No Câmbio E Nos Juros, Brasil, 1994-2006
- • IB comemora 80 anos com investimentos em laboratórios
- • Os 10 principais compradores de cortes de frango do Brasil
- • Simpósio Sobre Biotecnologia Em Etanol E Biodiesel, Em Piracicaba (SP)
- • Brasil aumenta a exportação de arroz em maio
- • SILAS BRASILEIRO ANUNCIA LANÇAMENTO DO PEPRO PARA O CAFÉ
- • PREÇOS AGROPECUÁRIOS CAEM 2,41% NA PRIMEIRA QUADRISSEMANA
- • Leilão de arroz comercializa 7,5 mil toneladas
- • Maior importador de trigo, Brasil assiste a escalada de preços
- • Preço do açúcar em SP é o menor dos últimos dois anos
- • Brasil aumenta receita com a exportação de carne suína
- • Aftosa - vigilância é fundamental
- • Brasil deve liderar exportação
- • IBGE revisa para cima safras de soja e de milho do Brasil
- • PROGRAMA DO MAPA APÓIA AGROINDÚSTRIA COOPERATIVA
- • Brasil vacina 137 milhões de bovinos
- • TRÊS CÂMARAS SETORIAIS DA SECRETARIA DE AGRICULTURA SE REÚNEM NA HORTITEC 2007
- • Agrishow 2007 estimula a agricultura familiar no semi-árido
- • Clima seco e Usda causam alta do trigo
- • Feicorte 2007 ocorre de 19 a 23 de junho em São Paulo (SP)
- • Brasil deve liderar exportação mundial de soja
- • SIGATOKA NEGRA DOS BANANAIS: SÃO PAULO É REFERÊNCIA NO CONTROLE
- • IZ e CPFL fazem parceria para estudo de aguapé na alimentação de ruminantes
- • Abertas inscrições para 4º Seminário Inovações Tecnológicas do IZ
- • Câmara Setorial de Biocombustíveis quer fazer mapeamento de biodiesel em SP
- • Encontro debate certificação fitossanitária
- • Safra global de café será menor
- • Ribeirão Preto: cana cai e esfria o mercado de terras
- • Semana da Citricultura começa hoje em Cordeirópolis
- • AFTOSA: PECUARISTA TEM ATÉ HOJE PARA COMPROVAR A VACINAÇÃO
- • Economia na aplicação de fungicidas
- • Produção de arroz no Brasil vai cair com recuo de área
- • SP: receita com exportação de café tem alta de 18,1%
- • Leite e derivados elevam IPC a 0,36% na cidade de São Paulo
- • Distribuição E Representatividade Das Exportações Regionais Do Agronegócio No Estado De São Paulo Em 2006¹
- • COMEÇA DIA 11 DE JUNHO A 29ª SEMANA DA CITRICULTURA EM CORDEIRÓPOLIS
- • UE pode liberar frigoríficos de SP antes do fim do embargo
- • Declaração de russos revolta setor de carne brasileiro
- • Canaviais de SP devem eliminar queimada até 2014
- • Qualidade Do Leite: Padrões Normativos Para Implantação Do Selo Produto De São Paulo
- • Frango foi destaque nas vendas externas de carnes in natura de maio
- • São Paulo: trigo caro já faz moinho brasileiro importar do Canadá
- • Benefícios da cana compensam queimadas
- • Verminose é doença severa em ovinos e caprinos
- • Mercado dita as regras para a indústria de adubos
- ► Maio (107)
- • Mercado brasileiro de carnes exibe dinamismo
- • Brasil apresenta menor custo de produção de bovinos
- • Cana: Conab estima safra recorde de 528 mi/t em 2007/08
- • Exportação de soja em grão registra alta
- • PROJETOS DE TANQUES-REDE EM ÁGUAS PÚBLICAS: COMO REGULARIZAR
- • ESTUDO MOSTRA VALORIZAÇÃO DAS TERRAS PAULISTAS DE 1995-2006
- • Indicador do algodão recua mais de 15% em maio
- • Conceito de zona de contenção para aftosa vai beneficiar o país
- • Certificação fitossanitária de origem é tema de workshop
- • Para não perder renda, avicultor busca alternativa
- • Grau De Investimento: E O Café Com Isso?
- • Brasil precisa intensificar combate ao greening
- • Frango vivo abre a última semana do mês em alta
- • Brasil muda certificado de embarque de carnes
- • CERTIFICAÇÃO FITOSSANITÁRIA DE ORIGEM É TEMA DE WORKSHOP EM CAMPINAS
- • Estudo realizado por pesquisadores do Pólo Centro Leste propõe nova forma de avaliação dos cafezais para controle do bicho-mineiro
- • Câmara Setorial quer diagnóstico completo da produção orgânica em SP
- • Carne bovina: maior lucro com exportações
- • Cafezais ficaram livres do risco de geadas
- • Preços Agropecuários: Queda De 3,40% Na Terceira Quadrissemana De Maio
- • Chuva eleva cotação de grãos
- • Preço externo das commodities garante rentabilidade
- • Mapa atualiza regras para cultivares de algodão no Brasil
- • Produção Sustentável, Palavra De Ordem Para Rações E Alimentos
- • ÚLTIMA SEMANA DA CAMPANHA DE VACINAÇÃO CONTRA AFTOSA
- • Câmara Setorial de Caprinos e Ovinos solicita estudo ao Sebrae-SP
- • IZ promove 3º Seminário Inovações Tecnológicas
- • Produtor quer renegociar dívida do campo com juros menores
- • Diagnóstico de cancro por DNA
- • Propriedade de Sinop produz 60 toneladas de banana por ano
- • CAFÉ DO SABOR AO VALOR
- • Suinocultor diz que o governo oferece pouco
- • São Paulo terá fábrica de vacina contra aftosa
- • Falta de chuva não compromete safrinha de milho e sorgo em SP
- • SP: quase metade do café tem negócios pela corretagem, diz o IEA
- • Produtor quer rever preço mínimo da soja
- • Plantio de cana pode até elevar produção de grãos
- • Brasil incrementa exportação de frutas
- • Governo anuncia queda na pauta fiscal do leite, milho e soja
- • Cafeicultor reclama da política de câmbio
- • Mecanização eleva nível de exigências na lavoura de cana
- • Processo reduz microbiota do leite sem tratamento térmico
- • Brasil deve fechar parceira com Paraguai na área de biodiesel
- • Dólar baixo muda o mapa do agronegócio
- • Perspectivas de clima e mercado para trigo
- • Massa de ar fria vai derrubar temperaturas
- • Preços Agropecuários: Queda De 3,48% Na Segunda Quadrissemana De Maio De 2007
- • Criadores de avestruz preocupados com prazo para medidas sanitárias
- • Apesar da cana, área de soja se mantém nas 10 principais regiões produtoras
- • Plantio de trigo deve ser no prazo para evitar perdas com clima
- • Suinocultor investe para aumentar o consumo interno
- • IMA fiscalizará combate à ferrugem no cultivo de soja
- • Produção brasileira de café está superestimada
- • Custo E Rentabilidade Da Produção De Milho Safrinha Em Dois Níveis Tecnológicos
- • Mapa quer estudo da proibição de exportação de trigo argentino
- • Preço do algodão em pluma acumula baixa de 5,6% no mês
- • Ministério da Agricultura divulga novo padrão da soja
- • Cadeia do café terá mais recursos a partir de hoje
- • Preço do milho é atrativo para o produtor
- • Clima global eleva preços do trigo
- • Combate à aftosa terá ações conjuntas entre Brasil e Paraguai
- • Frango, ovo, milho e inflação em abril de 2007
- • SECRETARIA DE AGRICULTURA E FUNDECITRUS INICIAM SEMANA DE COMBATE AO GREENING
- • Balança Comercial Dos Agronegócios Paulista E Brasileiro De 2007 - Primeiro Quadrimestre
- • Pecuarista deve ter cuidados ao vacinar contra aftosa
- • São Paulo quer controlar queima de cana
- • Semente certificada de arroz é garantia de qualidade
- • Necessidades e interações em micronutrientes são temas de seminário
- • Agricultura, Água E Florestas Serão Temas De Evento Na Assembléia Legislativa
- • PECUARISTA PRECISA TOMAR CUIDADO AO VACINAR ANIMAIS CONTRA FEBRE AFTOSA
- • DEFESA AGROPECUÁRIA TREINA TÉCNICOS DO GEASE
- • Preço alto da soja corrói lucro da Brasil Ecodiesel
- • Cuidados com o preparo do solo aumentam produtividade do trigo
- • Cotação do arroz estável e perspectiva favorável
- • FGV: preço agrícola acumula recuo de 1,96% no âmbito do IGP-M
- • Produção de cana-de-açúcar vai aumentar em 4,4%
- • Preço do café pode frustrar receita das torrefadoras
- • Exportações de produtos lácteos aumentam
- • Juros do agronegócio podem cair no mês de junho
- • Pecuaristas chamam atenção para diferenças de qualidade da carne
- • Preço do café em SP teve recuo de 0,15% na semana
- • Milho: Demanda Por Etanol Eleva Cotações
- • Rótulo em transgênicos pode ser obrigatório
- • IBGE estima safra de grãos em 132,3 milhões de toneladas
- • Frango vivo obtém alta de dez centavos
- • Aumento das exportações estabiliza preço do milho em SP
- • Governo mudará lei para reduzir gasto dos Estados com aftosa
- • Mecanização traz nova praga à cana
- • A Relevância Da Economia Da Qualidade Agroalimentar No Contexto Atual
- • Especulação sustenta preços do algodão
- • Colheita da soja se aproxima do final
- • Carne brasileira vale 9% mais no exterior
- • Intempéries reduzem estimativa de safra recorde de grãos
- • CONTRIBUIÇÃO DA SECRETARIA À CAFEICULTURA PAULISTA
- • Commodities agrícolas valorizam-se nas bolsas
- • Estimativa Da Produção Animal No Estado De São Paulo Para 2006
- • Governo projeta leilões para atender a cafeicultura
- • METADE DAS USINAS DO CENTRO-SUL JÁ INICIOU A MOAGEM DE CANA DA SAFRA 2007/08
- • Importações de farinha de trigo crescem 50%
- • Exportações de carne tiveram bom desempenho
- • Brasileiras disputam mercado de colheitadeiras
- • Governo deve definir opção privada do café
- • Produção mundial de algodão deverá cair
- • Cana avança e criador se adapta
- • SECRETÁRIOS DE ESTADO DE AGRICULTURA SE REÚNEM NA AGRISHOW
- • Curso traz conhecimentos sobre desidratação de frutas e hortaliças
- • Pesquisadores publicam boletim que orienta os procedimentos para regularização de projetos de aqüicultura em águas públicas
- ► Abril (95)
- • Produção de carne pode aumentar sem ampliar rebanho
- • Começa em maio nova etapa da camanha contra aftosa
- • Funcafé libera recurso para a colheita de café
- • Produtor deve ter cautela com oscilação do preço do algodão
- • ITAL e Abis participam da 4ª TecnoLáctea & Sorvetes
- • Clima poderá prejudicar produção milho safrinha no Brasil
- • São Paulo: lei sobre frete onera o exportador de soja
- • Brasil voltará a importar carnes da Argentina
- • Principais Mercadorias Exportadas Pelo Agronegócio, Estado De São Paulo, Janeiro A Março De 2007
- • Estudo Inédito Do IEA Em Seminário Sobre Pesquisas De Café
- • Europa ameaça impor embargo à carne do Brasil
- • Frio à noite beneficia morango
- • Primeira fase da campanha contra a aftosa começa dia 1º
- • Agrishow 2007: indústria aposta na retomada
- • Clima poderá prejudicar produção de milho safrinha
- • Ecassez de boi gordo eleva preço da arroba
- • Prêmio Cafeicultor Brasileiro Destaque 2007
- • COOPERATIVAS PEDEM REDUÇÃO DE TAXA DE JUROS
- • Avanço de álcool e grãos reanima Agrishow
- • Programa VivaLeite: Um Pouco De Sua História
- • Safra de café será de 32 milhões de sacas
- • Produtos orgânicos ganham mercado
- • Commodities fecharam a semana em queda
- • Queda do preço do milho reduz despesa com a ração
- • Orçamento não inclui combate à aftosa
- • Expectativa de aumento da safra pressiona preços do café
- • Missão européia avalia controle de aflatoxina em amendoim brasileiro
- • O milho firma-se como commodity
- • Brasil segue na liderança das exportações mundiais de carne de frango
- • Itália quer gado, porcos e frangos brasileiros
- • Conab divulga na sexta-feira nova estimativa de café
- • Começou a colheita do limão em São Paulo
- • MT reforça fiscalização na fronteira para evitar febre aftosa
- • PREÇOS AGROPECUÁRIOS CAEM 4,97% NA SEGUNDA QUADRISSEMANA DE ABRIL DE 2007
- • Projeto estuda combinações de cálcio para melhorar a qualidade de produção de ovos
- • Cafeicultor atrasa colheita para reduzir o custo da lavoura
- • Produtor nacional de milho aguarda definições de mercado
- • 2ª etapa de vacinação contra aftosa começa no dia 1º
- • SP: preço do frango vivo sofre primeiro retrocesso do mês
- • Área de cana será 8% maior
- • Febre do etanol mantém grãos competitivos
- • Área de trigo será maior nesta safra no Paraná
- • Agroenergia não afeta produção de alimentos
- • Brasil avisa a europeus que não aceita certificado ambiental
- • Estatísticas Agrícolas Municipais De 2006 Já Estão Disponíveis Para Consulta
- • Agronegócio bate novo recorde de exportações
- • Colheita do milho
- • Café Brasileiro está entre os melhores do país
- • Cana invade áreas ocupadas pelo boi
- • Sobra de farelo emperra indústria de soja
- • Receita no campo deve crescer 8,6%
- • Aftosa: Adeal espera criadores para declaração do rebanho
- • Avicultura brasileira cresce entre 8% e 10%
- • Maior demanda por milho e soja encarece ração animal
- • MAPA ANUNCIA PRIMEIRO LEILÃO DE ALGODÃO DO ANO
- • PESQUISADORES DA SECRETARIA OFERECEM CURSO NA ÁREA DE CANA
- • PIB do agronegócio registra aumento em janeiro
- • Produtor deverá plantar menos feijão nesta safra
- • Trigo: Produção Paulista Deverá Aumentar Em 2007
- • Brasil debate-se contra aftosa para manter liderança em carne
- • USDA projeta estoque maior de milho nos EUA
- • Estoques de soja surpreendem o mercado
- • Análise De Resíduos: Atendimento Das Exigências Européias Ou Embargo Nas Exportações De Produtos Brasileiros De Origem Animal
- • Piscicultura Orgânica
- • Agricultura debaterá regras para acondicionamento de leite
- • Embargo argentino faz cotações do trigo subirem
- • Secretário da Agricultura garante continuidade dos leilões de arroz pela Conab
- • Preços Agropecuários Caem 1,48% No Mês De Março De 2007
- • LANÇAMENTO DA AGRIFAM 2007: SECRETARIA PARTICIPA DA FEIRA
- • Leilão de arroz no RS oferta 90 mil toneladas nesta terça-feira
- • Cartilha sobre manejo da ordenha e qualidade do leite, em fase de elaboração
- • FUNDO TERÁ R$ 123 MILHÕES PARA PEQUENO PRODUTOR PAULISTA
- • Escolas agrícolas terão acesso à internet gratuita a partir de julho
- • Apta Regional: Curso de formação de técnicos em produção de cana-de-açúcar tem a participação de pesquisadores da Secretaria de Agricultura do Estado
- • Leilão de café dos estoques do governo negocia 99% da oferta
- • Preços do suco de laranja voltaram a subir na quarta-feira
- • Lucro do campo deverá ser maior que o esperado
- • Produtividade garante recorde de grãos em 2006/07
- • Produção de arroz será 16% menor que o consumo, diz Conab
- • Pesquisadores estudam pastejo com ovinos na região Oeste do Estado de São Paulo
- • Dourados vê avanço da cana com ressalva
- • Produção de grãos deve atingir marca histórica de 131 milhões/t
- • Plantas transgênicas podem resistir ao aquecimento global
- • Ministro da Agricultura diz que combate à aftosa precisa ser reestruturado
- • Governo de SP prioriza programa de sanidade animal
- • Leilão negocia saca de arroz a R$ 24,78 para setembro
- • Preço do milho mantém queda em Chicago
- • Exportações de carnes cresceram em março
- • Ministros e secretários discutem aftosa
- • Frango vivo encerrou o mês de março em leve alta
- • Governo garante apoio para próxima safra de trigo
- • Grãos encerram setembro com queda de preços médios
- • Mamona "social" vira óleo para químicas
- • Brasil mapeia áreas para cana
- • Avicultura brasileira relaxa com indicações no Ministério da Agricultu
- ► Março (104)
- • Brasília: novas projeções elevam produção de milho no País
- • Agricultura executou 1,5% do orçamento até início de março
- • Amendoim Descascado: O Destaque Nas Exportações Da Cadeia De Produção
- • PRIORIDADES DE PESQUISA PARA A BATATICULTURA
- • Colheita Manual Representa 75,6% Da Área Total De Café Em SP
- • Hora da verdade para os preços do milho
- • Soja e derivados sobem com previsões de área menor
- • Cafés especiais recebem verba do Funcafé para promoção internacional
- • Preços Agropecuários Sobem 0,83% Na Terceira Quadrissemana De Março
- • Pólo Regional do Centro Oeste tem projeto de pesquisa aprovado pelo CNPq no valor de R$ 120 mil
- • Exportação de arroz vai cair pela metade com produção menor
- • Agrishow Comigo 2007 começa em grande estilo
- • Produtores esperam aumento no consumo de carne de ovinos no País
- • Para uma páscoa tranqüila, peixe fresco na Sexta-feira Santa
- • Cana-de-açúcar Na Região De Ribeirão Preto
- • Produtores se reúnem hoje em Brasília
- • Milho mantém preço interno firme e mercado internacional em alta
- • Boi Gordo: semana registra queda nas cotações
- • Agrônomos serão capacitados para certificação de banana
- • Safra de soja nem terminou e produtor faz planos com o milho safrinha
- • Proibição de queima de palha de cana contraria lei e pode causar desemprego
- • IZ promove 1º Simpósio Inovações tecnológicas
- • O Emprego Na Cafeicultura Paulista: Situação Atual
- • Prorrogado o prazo para solicitação de bolsas de mestrado via FUNDAG
- • Autuadas 19 marcas de feijão
- • São Paulo: indústria da soja pede menos impostos
- • TÉCNICOS INICIAM TREINAMENTO PARA IDENTIFICAÇÃO DE PRAGAS POR MEIO DE TECNOLOGIA DIGITAL
- • PPHO e HACCP pela segurança do alimento
- • Aditivos e Oléos Vegetais para melhorar o desempenho e as características das carcaças de bovinos de corte
- • Venda de milho e soja está mais adiantada este ano
- • Citricultor antecipa colheita
- • Exportações de frango crescem 6,95%
- • Café: Crescente Exportação De Origem Pressiona As Cotações
- • Agregação de valor e articulação da cadeia de produção consolidam o mercado de acerola na Alta Paulista
- • SECRETARIA CERTIFICA 2ª GRANJA COM O SELO SUÍNO PAULISTA
- • Cientistas unem-se a produtores agrícolas em apoio à votação do milho transgênico
- • Soja transgênica rendeu economia de US$ 14 bi
- • Ministério quer manter preço mínimo na próxima safra de trigo
- • Aspectos reprodutivos das ovelhas
- • Carnes puxam as exportações do campo no ano
- • Exportações do agronegócio brasileiro cresceram 25,5%
- • População desconhece benefícios dos transgênicos
- • MAPA ANUNCIA NOVO LEILÃO DE ARROZ
- • Preços Agropecuários Sobem 2,51% Na Segunda Quadrissemana De Março
- • Usinas de biodiesel buscam grãos no mercado paulista
- • Carne de frango do Brasil perde liderança mundial em 2007, diz FAPRI
- • Leite ferve no bolso
- • TURMA DO SÍTIO DO PICAPAU AMARELO DIVULGA TRABALHO DE INSPEÇÃO EM SUCOS DE FRUTAS
- • Carne brasileira tira mercado do Paraguai
- • Álcool Brasileiro: Exportações Versus Mercado Interno
- • Instituto Biológico de Portas Abertas Homenagem à Vila Mariana
- • Brasil vai dobrar exportações de milho
- • ARROZ COM CAMARÃO: PROJETO DE PESQUISA OFERECE ALTERNATIVA PARA A RIZICULTURA
- • Pecuaristas buscam certificação para rebanhos
- • Arroz a R$ 22,30 já em março
- • WORKSHOP APRESENTA POTENCIAL DA PRODUÇÃO DE CACHAÇA NO CIRCUITO DAS ÁGUAS
- • Produção de álcool e açúcar vai crescer 15%
- • Projeto de Aqüicultura do Pólo do Nordeste Paulista, Instituto de Pesca e Unesp é aprovado pela Fapesp
- • SIMPÓSIO DE OVINOCULTURA E CURSO DE ULTRA-SOM SERÃO DESTAQUES NA FEINCO
- • CÂMARA DE CAPRINOS DISCUTE CRÉDITO PARA LÃ E PRIORIDADES EM PESQUISA
- • Produtor não aproveitará alta no preço da soja
- • Fruta brasileira faz sucesso na Alemanha
- • Pecuaristas buscam certificação para rebanhos
- • Brasil é o 8º maior criador de caprinos e ovinos do mundo
- • Falta de semente limita área de trigo no País
- • AGROPAUTA - CÂMARA DISCUTE CENÁRIOS E POLÍTICAS PARA O MILHO
- • Preços Agropecuários Sobem 3,59% Na Primeira Quadrissemana De Março
- • Pecuária paulista perde US$ 1 bi com febre aftosa em MS e PR
- • SECRETÁRIO PARTICIPA DE AULA INAUGURAL DA PÓS-GRADUAÇÃO DO INSTITUTO BIOLÓGICO
- • Safra vai superar 129 milhões de toneladas
- • Queda no preço da soja
- • Indústria repassa alta da cotação do leite
- • Sabor e qualidade garantem preço melhor do café brasileiro
- • Argentina barra exportação de trigo; brasileiros reclamam
- • Apta Regional: Pesquisador do Pólo Regional do Leste Paulista receberá prêmio em congresso da APA
- • Aumento de custos afeta a competitividade da carne brasileira no mercado internacional
- • Avicultura espera crescer 12% este ano
- • Cana foi a cultura com maior renda em 2006
- • IBGE: Brasil terá safra recorde de 129,4 mi de toneladas de grãos
- • Agricultura: 2007, ano de recuperação
- • Receita com as exportações de café bate recorde em 12 meses
- • Novas fronteiras podem dobrar produção de cana
- • Via Campesina invade área de destilaria em SP
- • Apta Regional: Pesquisadores apresentam alternativas para controle de pragas e doenças do amendoim
- • Lentidão na implantação do novo Sisbov
- • País pode ter nova expansão de fronteira agrícola
- • Preços Agropecuários Sobem 4,74% Em Fevereiro De 2007
- • Brasil vai construir uma usina de álcool e açúcar por mês até 2012
- • USO INDISCRIMINADO DE SUBSTÂNCIAS QUÍMICAS COMPROMETE AQÜICULTURA
- • Grãos encerram semana de turbulência em baixa
- • GUEDES REFORÇA NECESSIDADE DE AMPLIAR OFERTA DO SEGURO AGRÍCOLA
- • Exportações brasileiras de soja em ritmo forte
- • IAC contesta inviabilidade do café em SP com aquecimento global
- • PRODUÇÃO DE ALEVINOS DE BIJUPIRÁ: INSTITUTO DE PESCA TEM ESTUDO PIONEIRO
- • Brasil desponta como promissor na produção de orgânicos
- • Exportações de grão e farelo de soja cresceram 7,5% em fevereiro
- • Embarques de carne bovina e de frango cresceram em fevereiro
- • Brasil não importará café
- • Demanda aquecida para o algodão
- • Especulação tumultua mercado de grãos
- • Cinco Estados começam hoje campanha de vacinação contra aftosa
- • Pesquisadora Do IEA Participa De Livro Sobre O Nordeste Brasileiro
- • MINISTÉRIO DA AGRICULTURA ENVIA MISSÃO AO REINO UNIDO
- • Expansão da cana pode agravar conflitos fundiários em SP
- ► Fevereiro (91)
- • Sorgo pega carona no milho
- • PESQUISADORES REALIZAM DIA DE CAMPO DE SOJA NA ALTA MOGIANA
- • Preços agropecuários sobem 5,02% na terceira quadrissemana
- • Colheita de soja da safra 2006/2006 chega a 14%
- • Floricultura: Desempenho Do Comércio Exterior Em 2006
- • Produtor rural fecha 2006 no vermelho
- • Exportações de frango caíram em janeiro
- • De olho nos EUA, Brasil assina acordo com a Jamaica
- • Soja alcança sua maior cotação desde 2006
- • Missão chilena visita frigoríficos no Brasil
- • Agricultores familiares buscam no exterior novos mercados para orgânicos.
- • SC perto de ser reconhecida área livre de aftosa
- • Avicultura no foco das atenções
- • Brasil pode restringir farinha da Argentina
- • Real valorizado faz cair cotação do café no Brasil
- • Lamy: agricultura está entre principais itens da rodada de Doha
- • VOLUME DE EMBALAGENS VAZIAS DE DEFENSIVOS AGRÍCOLAS PROCESSADAS CRESCE 40% NO BRASIL EM JANEIRO
- • SUSTENTABILIDADE DE ÁREAS AQÜÍCOLAS: ATUAÇÃO DO INSTITUTO DE PESCA EM SÃO JOSÉ DO RIO PRETO
- • Preços Agropecuários Sobem 4,52% Na Primeira Quadrissemana De Fevereiro De 2007
- • HORTALIÇAS E PLANTAS MEDICINAIS: MANUAL PRÁTICO
- • Porto de Paranaguá culpa operadores e cooperativas por fila
- • Câmara Setorial inicia campanha para reabrir mercado europeu para a carne bovina de São Paulo
- • Vale (quase) tudo no 'flexível' mercado de biodiesel do país
- • Exportação de café solúvel registrou em janeiro receita 7% maior
- • Programa de Microbacias completa 20 anos em SP e busca enfoque sócio-ambiental
- • Brasil exporta tecnologia para produção da cana-de-açúcar
- • Brasil recupera registro da marca 'açaí' de japoneses
- • Sigatoka negra na banana
- • Cana já limita cultivo de grão
- • Convênio entre Sebrae e Ibraf estimula a fruticultura em SP
- • SP faz avaliação de risco para aftosa de olho na UE
- • MAPA E UnB DISCUTEM CRIAÇÃO DO CURSO DE ESPECIALZIAÇÃO EM VIGILÂNCIA AGROPECUÁRIA INTERNACIONAL
- • Grupo alcooleiro quer investir US$ 8,4 bi no Brasil
- • Recurso para próxima safra de café serão liberados a partir abril
- • Produção de álcool nos EUA beneficia soja brasileira
- • Brasil e Jamaica renovam acordo sobre produção de etanol
- • Brasil planta pinhão-manso mesmo sem pesquisa
- • Brasil irá doar três milhões de doses de vacina contra aftosa à Bolívia
- • Criador pede que governo compre estoques de suínos
- • DIA DE CAMPO MOSTRA BENEFÍCIOS DA INTEGRAÇÃO LAVOURA PECUÁRIA
- • Soja e milho injetam R$ 37 bi na economia
- • Cinco estados fazem do Brasil segundo exportador mundial de carne de peru
- • Produção de álcool nos EUA beneficia exportação de soja brasileira
- • TRIGO: CÂMARA SETORIAL DISCUTE HOJE CONCORRÊNCIA COM PRODUTO ARGENTINO
- • Produção brasileira de açúcar pode crescer 17% na safra
- • Cientistas transformam biotecnologia em negócios promissores
- • Maça terá projeto-piloto sobre sanidade e qualidade
- • IAC lança nova variedade de arroz em Dia de Campo e tem aprovação de quem entende
- • CÂMARA DE INSUMOS DISCUTE RENEGOCIAÇÃO DAS DÍVIDAS DOS PRODUTORES
- • LEILÕES VÃO OFERTAR 70 MIL TONELADAS DE FEIJÃO
- • Um plano para fazer do sertão um mar de cana
- • Aftosa: restrição em municípios deve terminar em 6 meses
- • Bagaço pode virar álcool a partir de 2009
- • Revista americana destaca etanol brasileiro
- • Agronegócio sai do vermelho e cresce 1,6%
- • BRASIL INVESTIRÁ R$ 1 BILHÃO EM BIOTECNOLOGIA ESTE ANO
- • Mercado de barrinhas: permanente busca por novidades
- • Pesquisadores Do IEA No Livro Comercialização E Agroindústria Familiar
- • Pecuaristas se aliam para conter avanço da cana
- • Supermercados apostam em orgânicos
- • Lula lança Política de Desenvolvimento da Bioindústria
- • Usinas querem que Brasil negocie fim de taxa sobre etanol nos EUA
- • Agora é a hora de saber como será a próxima safra de bezerros
- • Brasil vai colher safra recorde de 126,5 milhões de toneladas
- • SP mantém incentivos fiscais a produtos da cesta básica
- • CONAB DEBATE ARMAZENAGEM
- • Soja apresenta safra maior
- • Produção de maçã será 25% maior do que em 2006
- • Exportações de cooperativas brasileiras cresceram 25,7% em 2006
- • Pecuaristas e agricultores de SP fecham parcerias contra a crise
- • Novo caso positivo de aftosa na Bolívia
- • Europeus importarão mais cortes bovinos; Brasil pode avançar
- • Cafeicultor pede mais crédito para colheita
- • Ministério passará a utilizar tecnologia na identificação de pragas
- • Embarque de carnes suínas e de frango cai em janeiro
- • País quer agregar valor às vendas de sisal
- • Prevenção da ferrugem asiática da soja
- • MAPA utilizará tecnologia digital para identificação de pragas
- • Aftosa: Estados vão reforçar as barreiras
- • Excesso de chuvas não eleva produção brasileira de café
- • Altas da soja e do milho beneficiam produtores
- • MAPA UTILIZARÁ TECNOLOGIA DIGITAL PARA IDENTIFICAÇÃO DE PRAGAS
- • Uso de transgênico reduz gastos de agricultores
- • Alemanha é alvo para as frutas brasileiras
- • Produção de laranja cresce 1,6% em SP
- • Maior feira de lacteos do Brasil deve movimentar US$ 60 milhões
- • Brasil reforça fronteira e oferece apoio técnico ao país vizinho
- • Plano de R$ 20 milhões contra a febre aftosa
- • MAPA DIVULGA DATA, HORÁRIOS E LOCAIS DAS PROVAS DO CONCURSO DE FISCAL FEDERAL
- • São Paulo registra queda na produção de grãos
- • Governo de SP retira crédito de ICMS sobre o abate de aves
- ► Janeiro (99)
- • Brasil doará um milhão de doses anti-aftosa à Bolívia
- • Brasil quer consolidar mercado da carne em Dubai
- • Aftosa: Brasil suspende importações da Bolivia
- • Brasil poderá exportar etanol para a União Européia
- • UE estima que Brasil terá o maior crescimento agrícola no mundo
- • Pólo Regional do Vale do Paraíba tem dois projetos de políticas públicas financiados pela FAPESP em 2007
- • A SAFRA BRASILEIRA DE CAFÉ SOB A VISÃO DOS PRODUTORES
- • Frigoríficos de SP cancelam compras de gado do Mato Grosso do Sul
- • Bolívia notifica Brasil sobre foco de febre aftosa no país
- • Agroenergia do Brasil atrai mais capital externo
- • Cresceu o abate de aves em 2006; apesar da crise
- • Estoques de café seguem em nível histórico baixo,alerta OIC
- • Fruticultura brasileira em crescimento
- • O Brasil vai exportar em 2007 o maior volume de milho de sua história.
- • Ferrugem asiática no Brasil alerta produtor e indústria
- • Projeto de combate à febre aftosa avança
- • Moinho quer restringir entrada de pré-mistura
- • Reunião da Sociedade Brasileira de Zootecnia reúne especialistas
- • Brasil deve participar de consulta aos EUA
- • Chuva irregular em 2006 deve reduzir safra paulista de café
- • PROJETO-PILOTO DE COMBATE À AFTOSA NO MERCOSUL DEVE COMEÇAR NESTE ANO
- • PRODUTORES DE SOJA LIDERAM OPERAÇÕES DE SEGURO RURAL
- • Exportação de lácteos deve crescer
- • Brasil é o segundo fornecedor de frango do mercado russo
- • Apoio à comercialização sustenta preço do arroz
- • Quase a metade da safra de soja 2006/07 foi negociada
- • ADAB TRAÇA ESTRATÉGIAS PARA A 1ª ETAPA DA CAMPANHA ANTI-AFTOSA
- • Agricultura fica em segundo plano no PAC
- • SP processa 2.905 toneladas de embalagens de defensivos em 2006
- • Brasil mantém liderança mundial na exportação de carne de frango
- • Técnica de fertirrigação pode melhorar produtividade do canavial
- • BrasilAgro e Maeda fazem parceria em terras
- • Brasil pode cultivar até 1 mi ha de algodão transgênico até 2015
- • Arroz: Governo disponibiliza R$ 700 milhões para apoio à comercialização
- • Chile enviará três missões ao Brasil
- • Preços agrícolas sobem 0,35% na 2ª prévia do IGP-M de janeiro
- • Governo já fiscaliza área de produção de algodão
- • Debate de lideranças reúne especialistas para discussões sobre o futuro do leite no Brasil
- • Exportação de cooperativas de SP cresce mais de 46%
- • Ovinocaprinocultura já tem Câmara Setorial em São Paulo
- • Área de transgênicos deve triplicar no Brasil até 2015
- • Produção brasileira de cafés especiais em plena expansão
- • Couro brasileiro movimenta US$ 21 bilhões
- • Cana pode dominar lavouras
- • Preços agrícolas sobem 0,03% em janeiro no âmbito do IGP-10
- • Projeto de pesquisadores científicos da Secretaria de Agricultura sobre pólen apícola in natura é aprovado pela Fapesp
- • Processamento de soja em ritmo lento
- • Guedes defende mudanças no modelo agrícola brasileiro
- • Consumidores alemães na mira do sabor das frutas brasileiras
- • Produtores brasileiros querem importar café do Vietnã
- • Produtores mantêm o "pé no freio" na venda de café
- • Brasil voltará a exportar carnes a mais dois países
- • Exportações brasileiras de milho atingem terceiro maior nível
- • Abertura do mercado de resseguros impusionará segro rural no Brasil
- • Após subir 5%, preço do álcool recua 1,5% nas usinas de SP
- • ANGOLA SUSPENDE RESTRIÇÕES COMERCIAIS À CARNE BRASILEIRA
- • Preços do álcool voltam a cair no mercado de SP
- • Consumidores alemães na mira do sabor das frutas brasileiras
- • OIC prevê queda na produção global de café em 2007/08
- • Brasil faz novas críticas aos EUA na disputa do algodão
- • EXPORTAÇÕES DO AGRONEGÓCIO BRASILEIRO AUMENTARAM 99% EM CINCO ANOS
- • Café do Brasil tem a maior exportação de todos os tempos
- • Butantã terá nova cepa do vírus da gripe aviária para testes
- • Apta Regional: Produtores da região do Extremo Oeste serão beneficiados com projeto de pesquisa sobre população de insetos nas pastagens
- • Cana atinge 45,5% da produção de SP
- • Fruticultores são os maiores beneficiários do seguro rural paulista
- • Missões vão avaliar sistema de defesa agropecuária do Brasil
- • Exportações do agronegócio brasileiro aumentaram 99% em 5 anos
- • Preços agrícolas sobem 0,05% na 1ª prévia do IGP-M de janeiro
- • Lesões desconhecidas atacam lavouras de soja
- • Brasil tem o maior banco de genes de frutas cítricas
- • Preços agrícolas recuam 0,66% em dezembro no âmbito do IGP-DI
- • LABORATÓRIO DE CARCINOCULTURA BENEFICIA PESCADORES DE CANANÉIA
- • Revitalização Da Cadeia Vitivinícola Paulista
- • Importadores vêm ao Brasil avaliar sanidade
- • SP: chuva ameaça lavouras brasileiras de café, feijão e hortaliças
- • Produção no Brasil deve ser a maior desde 2002/03
- • Retomada do agronegócio chega ao setor de máquinas agrícolas
- • Salvação da lavoura
- • PESCA: INSTITUTO DESENVOLVE TECNOLOGIA PARA REPRODUÇÃO DE GAROUPAS EM CATIVEIRO
- • Álcool pode sofrer nova intervenção
- • Produtores de algodão dependem cada vez mais do mercado externo
- • FGV: preço do álcool sobe no varejo após quatro meses em queda
- • Resolução de ano novo: nada de gordura trans
- • Sucesso da goiaba neutraliza valorização cambial em 2006
- • SP dará incentivo fiscal a produtor de orgânico
- • Agronegócio é responsável por cerca de 20% das exportações do país
- • Lei que incentiva produção de orgânicos é promulgada em SP
- • UE prepara estímulos para o etanol e Brasil pode lucrar
- • Disparam preços de milho na exportação
- • Brasil exportará 8,5 bi de litros de etanol em 2010
- • Projeto identifica 775 plantas para uso comercial
- • Nova Edição De Florestar Estatístico E Sistema De Informações Florestais Em SP
- • Produtor abandona o Manejo Integrado de Pragas da Soja
- • Empresário paulista investe para resgatar frutas da Mata Atlântica
- • SAMPAIO ASSUME A AGRICULTURA E TRABALHARÁ PELA QUALIDADE DOS PRODUTOS PAULISTAS
- • Umidade favorece canaviais no Estado de São Paulo
- • Álcool encerra 2006 e começa 2007 com aumentos em usinas e postos
- • AGRONEGÓCIO GARANTE SALDO DA BALANÇA COMERCIAL BRASILEIRA
- ► Dezembro (9)
- ► 2006 (542)
- ► Dezembro (81)
- • Futuro promissor para o campo
- • GOVERNO AUTORIZA LINHA DE CRÉDITO PARA MAÇÃ, PÊSSEGO, MEL, LÃ E FÉCULA DE MANDIOCA
- • Pós-Graduação do IAC irá abrir inscrições em janeiro
- • Novo livro trata de análise química de resíduos sólidos
- • Instituto Biológico agora oferece curso de pós - graduação
- • Produção de milho cresce 16,5%
- • Brasil negocia regras para vender biodiesel à UE
- • Carne bovina busca mercados mais nobres
- • Planta considerada praga pode se tornar biocombustível em 2007
- • Fim da safra da cana no Centro-Sul agita o mercado de álcool
- • Cresce a demanda por sebo bovino para a produção de biocombustível
- • Preço melhor compensará volume menor de café exportado em 2007
- • MAPA realiza quatro leilões de soja em janeiro
- • Plano de safra deve incluir todos os bancos
- • Na fazenda, valor pago pelo leite recua em 2006
- • Comissão aprova regras para aplicação aérea de agrotóxicos
- • Procura por biocombustível deve fazer Brasil dobrar produção de álcool
- • Preços agrícolas sobem no atacado de São Paulo
- • Açúcar e álcool sob os holofotes em 2007
- • Renda dos produtores deve aumentar em até 70% em 2007, diz estudo
- • Biocombustivel revolução na vida rural da América Latina
- • Governo gasta R$ 4 bilhões com socorro ao agronegócio em 2006
- • GOVERNO FEDERAL ASSUME COMPROMISSO COM SETOR PESQUEIRO
- • Manejo de fungos fitopatogênicos habitantes do solo
- • GUEDES DIVULGA ESTUDO SOBRE TENDÊNCIAS DO AGRONEGÓCIO PARA OS PRÓXIMOS DEZ ANOS
- • Câmara ameniza regras sobre produtos transgênicos
- • MINISTRO APRESENTA HOJE PROPOSTA DE NOVO MODELO DE POLÍTICA AGRÍCOLA
- • Vacinação contra aftosa atinge 99,40% do rebanho paulista
- • Brasil produziu 143 milhões de sacas nos últimos quatro anos
- • Brasil quer ser exportador de biocombustíveis
- • Chuva atrasa plantio de soja no sudeste e no nordeste
- • Indústria de alimentação animal em expansão apesar de cenário desfavorável
- • Custo alto faz produtor desovar aves
- • Demanda por álcool eleva preços agrícolas
- • Agricultura Paulista E Aparelho Estatal: Falta De Recursos Ou De Conteúdo?
- • Centro de Inteligência do Café participa de assembléia em São Paulo
- • MAPA ADQUIRE SISTEMA PARA MONITORAR SALMONELLA EM CARCAÇAS DE FRANGOS E PERUS
- • MAPA DIVULGA HOJE ESTIMATIVA DA PRÓXIMA SAFRA DE CAFÉ
- • Transgênicos: Guedes espera que liminar seja cassada
- • Governo promete ajudar pequeno exportador agrícola
- • Agronegócio vai responder por 36% das exportações brasileiras
- • Diminui A Produção Paulista De Goiaba Para Indústria Em 2006
- • Tangerina: Tendências No Cultivo No Estado De São Paulo
- • Pesquisadores do Sudoeste Paulista farão diagnóstico sobre a piscicultura na região
- • APROVADO ZONEAMENTO AGRÍCOLA PARA MILHO 2ª SAFRA EM MG, PR e RJ
- • Exportações: Brasil assume 1º lugar em receita cambial
- • Cana-de-açúcar tem investimentos em áreas de expansão
- • Livro traz informações de mercados para exportação de chocolates, balas e confeitos
- • Manejo integrado de plantas daninhas em hortaliças
- • Japão pode usar álcool brasileiro após 2010
- • CAFÉ DE CARMO DE MINAS VENCE O CONCURSO DE QUALIDADE CAFÉS DO BRASIL
- • RÚSSIA SUSPENDE RESTRIÇÃO ÀS IMPORTAÇÕES DE PRODUTOS CÁRNEOS E LÁCTEOS DO BRASIL
- • Brasil lidera na exportação de carne
- • Centro de Fruticultura IAC completa 70 anos
- • O Cavalo Crioulo é Campeão Brasileiro de Equitação de Trabalho
- • Ministério promove café do Brasil no Japão
- • Brasil e Venezuela terão encontro bilateral para tratar de temas agrícolas
- • Brasil Certificação conquista ISO 65
- • Preços agrícolas sobem 0,45% na 1ª prévia de dezembro do IGP-M
- • ESTUDO REGISTRA QUEDA, EM 2005, NA PRODUÇÃO DE PESCADO MARINHO, EM RELAÇÃO A 2004
- • Exportação brasileira de carne suína registra forte desempenho
- • Leilão Sela Brasil será dia 16
- • EM CANANÉIA, INSTITUTO CAPACITA PESCADORES PARA CULTIVAR CAMARÃO
- • Agricultura Na Região Metropolitana De Campinas
- • O Futuro Do Controle Biológico
- • Delegação do Mapa promove cafés do Brasil no Japão
- • Produtores rurais tem até o dia 31 para fazer recadastramento
- • Surtos de aftosa reduzem a venda de sêmen de gado no País
- • Governo gasta cada vez menos com agricultura, aponta estudo
- • Pesquisadores científicos iniciam pesquisas com palmeiras para produção de palmito na região do Sudoeste Paulista
- • GOVERNO ANUNCIA MEDIDAS PARA FACILITAR REGISTRO DE AGROTÓXICOS
- • Pesquisadores científicos desenvolvem projeto para recuperar açudes na região de Andradina
- • Cresce consumo de arroz e feijão no país
- • SP: proposta quer limitar avanço da cana em pequenos municípios
- • Brasil produz 53 milhões de toneladas de soja
- • Valor Da Produção Agropecuária Paulista Atinge R$ 33 Bilhões Em 2006
- • Apta Regional: Pesquisadores científicos desenvolvem projeto para recuperar açudes na região de Andradina
- • SAFRA DE CANA-DE-AÇÚCAR BATE MAIS UM RECORDE
- • Nova regulamentação da OIE pode ajudar o Brasil
- • AMERICANOS VOLTAM À CONAB
- • MAPA AVALIA PLANO DE SANIDADE AVÍCOLA DURANTE ENCONTRO NO RN
- ► Novembro (83)
- • Pecuaristas de SP e do RS vencem ranking 2006
- • Bayer CropScience participa do Agroshow 2006
- • Brasil e Europa negociam regionalização para Suinocultura
- • SP: combate a pragas e a doenças onera a produção cítrica em 36%
- • LABORATÓRIO INGLÊS CAPACITARÁ TÉCNICOS BRASILEIROS EM ANÁLISE DE RESÍDUOS
- • Preços de produtos agrícolas no atacado sobem 3,31% em novembro
- • Expande 2006 começará na sexta-feira em São Paulo
- • Pesquisa busca aumentar vida útil de palmito in natura
- • Brasil e Europa negociam regionalização para suíno
- • GUEDES ENCERRA ENERBIO 2006 NO BLUE TREE PARK
- • INSTITUTO DE PESCA SERÁ REPRESENTADO EM REUNIÃO DA FAO, NO URUGUAI
- • Mel Brasileiro Troca Europa Por Estados Unidos
- • CONAB DIVULGA 3ª ESTIMATIVA PARA SAFRA DE CANA-DE-AÇÚCAR
- • CONAB DIVULGA 3ª ESTIMATIVA PARA SAFRA DE CANA-DE-AÇÚCAR
- • Cotações devem manter-se firmes em 2007
- • Tecnologia: Equipamento prevê doenças em lavouras
- • Preços agrícolas seguem em alta
- • Meio Ambiente: Estado lançará mapa de áreas prioritárias
- • IZ realiza Reunião Técnica sobre Pesquisas com Reprodução Animal
- • Agronegócio brasileiro não destrói meio ambiente
- • Carne de frango perde posições na pauta
- • Plantio de algodão transgênico no Brasil ocupará 50% da área
- • Exportações Do Agronegócio Paulista Aumentam 22,3%, Para US$ 12,12 Bi, Até Outubro
- • Locais de Prova
- • 1º SIMPÓSIO DA QUALIDADE DA CARNE SUÍNA PARA NUTRICIONISTAS
- • UK Experience discute experiência britânica
- • Câmara Setorial De Biocombustíveis Reúne-se Na Assembléia Legislativa
- • A piscicultura no Sudoeste Paulista é tema de encontro de produtores em Capão Bonito
- • SISTEMA DE PRODUÇÃO DE GRANDES CULTURAS É TEMA DE PALESTRA EM PRUDENTE
- • 5º CICLO DE PALESTRAS SOBRE HEVEICULTURA PAULISTA
- • Botulismo no Brasil
- • INCENTIVO AO CONSUMO DE PEIXE
- • SOJA: Bom momento para vender
- • Brasileiro já consome mais frangos
- • Levantamento da safra das águas de SP indica área 13,1% menor
- • SP é o Estado mais afetado pela nova onda de invasões do MST
- • Exportações Dos Agronegócios Brasileiros Para A Argentina, Janeiro-setembro De 2006
- • Aumenta uso de herbicida com soja adoção de trangênicos
- • Brasil exporta mais arroz em outubro
- • Safra 2006/07: A Menor Da Década?
- • Livro De Pesquisador Do IEA Utilizado Em Mestrado Da Universidade De Brasília
- • Venda de tratores de pequeno porte impulsiona o setor
- • CAFÉ: EXPORTAÇÕES DEVEM SOMAR US$ 3,2 BILHÕES
- • Exportações brasileiras de frango caem
- • Produção de orgânicos cresce 30% no Brasil
- • Biodegradação = benefício ao meio ambiente. Será?
- • Exportações Dos Agronegócios Brasileiros, Janeiro-setembro De 2006: Vendas Para A China
- • Exportações Dos Agronegócios Brasileiros Para A União Européia, Janeiro-setembro De 2006
- • Exportações Dos Agronegócios Brasileiros Para A Rússia, Janeiro-setembro De 2006
- • Amendoim: qualidade é o grande desafio
- • IZ realizará leilão de reprodutores IZ, em Sertãozinho
- • Agronegócio exportou US$ 48 bilhões nos últimos 12 meses
- • Milho transgênico pode colocar saúde dos brasileiros em risco
- • Cerealistas brasileiros avaliam uso da biotecnologia na agricultura americana
- • Duas usinas paulistas negociam fusão
- • Banana: Flexibilização Tarifária Da União Européia Estimula Exportações E Expansão Da Produção
- • Máquinas para cana, café e laranja impulsionam vendas
- • Ministério da Agricultura discute vigilância agropecuária
- • Embrapa Caprinos mostra produção científica dos últimos dois anos
- • Governo quer apoiar comercialização de até 20 milhões de t de soja
- • Principais Destinos Das Exportações Dos Agronegócios Brasileiros, Janeiro-setembro De 2006
- • Argentina muda tributos e poderá comprar mais soja do Brasil
- • São Paulo: frigoríficos avançam nos mercados sofisticados
- • Avanço da vacina contra febre aftosa
- • IBGE: safra de grãos de 2007 deverá crescer 5,34% ante 2006
- • SP é responsável por 27,2% do consumo nacional de leite
- • Brasil detém a melhor tecnologia da produção de vacinas contra febre aftosa
- • Clube da Cana FMC reúne produtores em SP
- • Preços agrícolas sobem 5,18% em outubro no âmbito do IGP-DI
- • CONTAMINAÇÃO AMBIENTAL POR MERCÚRIO REQUER ATENÇÃO
- • Importar soja também fica mais barato no país vizinho
- • Aprovado programa de ação para Mercosul livre de aftosa
- • São Paulo estabelece critérios de entrada de aves e produtos do MT
- • Simpósio internacional discute rumos da fruticultura
- • 19ª REUNIÃO ANUAL DO INSTITUTO BIOLÓGICO
- • Anzol Seletivo
- • Produtores do Sudoeste Paulista participam de evento sobre a cultura do palmito
- • Complexo teniose-cisticercose
- • Moinhos brasileiros adiam compras de trigo da Argentina
- • Sara Lee inaugura fábrica de R$ 90 milhões em Jundiaí
- • Palmital, no interior de SP, poderá ter usina de etanol
- • Guedes anuncia R$ 1 bilhão para soja
- • Campanha contra aftosa
- ► Outubro (95)
- • Embutidos cárneos fermentados e cozidos: proteína para a hora do lanche
- • Exportação agrícolas do Brasil para China podem triplicar
- • Pork Expo 2006 bate recorde de público
- • Descoberta uma nova variedade do vírus da gripe aviária
- • Flores: Desempenho Do Comércio Exterior No Período Janeiro-setembro De 2006
- • Campanha contra Febre Aftosa começa na quarta-feira
- • Exportação de frutas para UE tem novas normas
- • Preços agrícolas sobem 3,56% em outubro no âmbito do IGP-M
- • Dívida rural: termina amanhã prazo de parcela da securitização
- • Biotecnologia é assunto de seminário em São Paulo
- • Banco do Brasil disponibiliza R$ 500 mi para cooperativas agrícolas de SP
- • Agricultura vai lucrar com biocombustíveis
- • Área de cana cresce 24,6% em MG até setembro
- • Brasil e UE fecham acordo para carne de frango
- • Saldo do agronegócio paulista já atingiu US$ 7,2 bilhões em 2006
- • Regras para orgânicos deverão sair do papel
- • Brasil e UE perto de pacto para o frango
- • Mais de 50% da soja poderá ser transgénica na próxima campanha
- • Famato: exportação agrícola do Brasil para China pode triplicar
- • SP inicia a 2ª etapa de vacinação contra aftosa em novembro
- • Aposta em oliveiras ganha força no Sul
- • Cooperativa vai produzir sementes de feijão
- • Governo leiloará milho de estoques de seis Estados para baixar preço
- • CNA confirma que haverá alta no preço dos alimentos
- • MAPA INSTALA NO PRÓXIMO DIA 31 A CÂMARA SETORIAL DA CADEIA PRODUTIVA DO FEIJÃO
- • ÓRGÃOS DE DEFESA AGROPECUÁRIA DISCUTEM SIGATOKA NEGRA EM GOIÁS
- • Número de vítimas da gripe aviária tem aumentado, adverte a ONU
- • Produção e preços na agricultura são o que mais preocupa o setor, diz CNA
- • Sul vai plantar 40% da área com transgênica
- • Exportações de café torrado e moído devem aumentar 76%
- • Defensivos em queda no mercado de São Paulo
- • Soja transgência deve ocupara 50% das lavouras de Sinop
- • Algodão transgênico ocupará cerca 67,4 mil/ha
- • Brasil pode dominar 50% do mercado de açúcar, prevê a Sugar On Line
- • CRESCE ARMAZENAGEM DE GRÃOS NO CAMPO
- • Preço agrícola sobe 2,24% na segunda prévia de outubro do IGP-M
- • Conscientização reduz problemas ambientais na lavoura de arroz
- • Nova ofensiva para reabrir mercados à carne brasileira
- • Idec pede que hormônio do leite seja proibido no Brasil
- • Pesquisas monitoram qualidade do caqui
- • Demanda retraída restringe embarque de frango do país
- • Setor pressiona por liberação dos agroquímicos genéricos
- • Safra verão - chegou a hora do milho
- • Milho transgênico, novo 'reino' das múltis
- • País poderá perder preferências na lista de produtos vendidos aos EUA
- • BM&F quer atrair pequenos produtores com contratos mínis de café e boi
- • Agricultura familiar terá seguro de preço
- • Ministério da Agricultura fecha cerco à semente pirata
- • FUNDO SOCIAL DE SOLIDARIEDADE RECEBE DOAÇÃO DE CAFÉ PRODUZIDO NA CAPITAL
- • Nanotecnologia Será Tema De Dois Seminários Internacionais Em Novembro Na Capital Paulista
- • LINHA DE CRÉDITO PARA SERICICULTURA TEM MUDANÇAS
- • Mal-do-panamá ameaça produção de banana
- • É baixa a procura por troca de sementes certificadas de soja
- • Socorro à soja não deve mudar intenção de plantio
- • Brasil estudará rota Antártica de aves
- • Brasil deve colher 55,2 milhões de toneladas de soja na temporada 2006/07
- • Menor oferta mundial sustenta preço do café
- • ALIMENTAÇÃO:1,5 BILHÃO DE LITROS DE LEITE DISTRIBUÍDOS E 30 MILHÕES DE REFEIÇÕES
- • Cafeicultor se ajusta às regras do Japão para resíduos químicos
- • Agricultura Paulista E Mudanças Na Estrutura De Representação
- • BRASILEIROS E EQUATORIANOS REALIZAM EVENTO SOBRE A CULTURA DA BANANA
- • POSIÇÃO DA EMBRAPA NO MERCADO DE SEMENTES SERÁ DISCUTIDA HOJE
- • Produtor de São Paulo investe no milho
- • Resultado da Expomilk 2006 supera expectativas
- • Pesquisadora do Pólo Regional do Leste Paulista iniciará pesquisas na nova granja experimental
- • CRIAÇÃO DE TILÁPIA É TEMA DE PALESTRA
- • Exportações agrícolas voltam a crescer
- • NAVIO DE PESQUISAS DO INSTITUTO DE PESCA TERÁ NOVO NOME
- • Perdas para a ciência brasileira
- • Exportações brasileiras de café verde sobem 6,5% até setembro de 2006
- • Indústrias de suco deverão elevar produção de laranja
- • Cresce procura por algodão transgênico
- • Mais cana por hectare
- • Embrapa vai fiscalizar sementes piratas por meio de satélite
- • Projeção para a soja está dentro das expectativas
- • Rodrigues assumirá Conselho do Agronegócio da Fiesp
- • PAÍSES REUNEM-SE EM BRASÍLIA PARA ANALISAR PROGRAMA DE CONTROLE DA RAIVA NAS AMÉRICAS
- • Métodos de preservação para fungos fitopatogênicos habitantes do solo
- • Preços de produtos agrícolas sobem 1,2% em setembro
- • Pesquisadores desenvolvem máquina para descascamento de babaçu
- • Agropecuárias Paulista E Brasileira: Crescimento Do Produto E Investimento Em P&D
- • Pitangueiras: como controlar pragas
- • Pesquisadores brasileiros e equatorianos realizam evento sobre a cultura da banana
- • Marfrig negocia frigorífico no Uruguai
- • Rio Grande do Sul dobrará a produção de leite nos próximos dois anos
- • Brasil será o maior consumidor mundial de café em 10 anos, prevê CNC
- • Pesquisadora do IAC é uma das vítimas do vôo 1907
- • CRIAÇÃO DE TRUTAS EXIGE MONITORAMENTO SANITÁRIO
- • SISTEMA PERMITE OBTER TOMATE SEM RESÍDUO DE AGROTÓXICO
- • Aumenta o contrabando de agrotóxico vindo do Paraguai
- • Expomilk começa nesta terça-feira em São Paulo
- • Banco do Brasil libera R$ 7 bilhões para agricultura
- • Ministério da Agricultura inicia nova etapa da Campanha de Vacinação contra Aftosa
- • Demanda fraca corrói cotações do açúcar
- • Soja: produtores poderão trocar sementes a partir de hoje
- ► Setembro (74)
- • Abate de frango registra queda no 2º trimestre
- • Abecitrus: Índia incomoda Brasil no mercado do suco de laranja
- • Controle do carrapato dos bovinos
- • Curso do CTC contempla teoria e prática relacionadas a cortes cárneos de bovinos e suínos
- • Manejo e controle biológico são temas no Fórum Permanente de Agronegócios da Unicamp
- • Brasil ensina a elevar consumo de café
- • Cresce a disputa por soja não-transgênica
- • Queda na projeção do PIB 2006 concentra-se na agropecuária e indústria
- • Produtores de soja adotam novas medidas contra a ferrugem
- • Expomilk 2006 começa dia 3 e deve reunir mil bovinos em SP
- • INSTITUTO DE PESCA PARTICIPA DA GESTÃO DA SARDINHA-VERDADEIRA
- • Apta Regional: Pólo Centro Sul inaugura seu programa de Educação Ambiental
- • Balança: importações somam US$ 6,042 bi em setembro
- • Usinas no interior de São Paulo viram atração turística
- • Produção Animal: Previsão No Estado De São Paulo Para 2006
- • Palestra em Bauru alerta sobre os riscos da leptospirose
- • PROJETO MAPEOU ESPÉCIES SILVESTRES DE ALGODÃO EM 17 ESTADOS BRASILEIROS
- • UE volta a ameaçar alimentos do Brasil
- • Biocombustíveis vão valorizar os grãos
- • Centro de Frutas do IAC faz concurso para criação de logomarca
- • Começa o plantio de soja em Mato Grosso
- • Projeto de pesquisa vai resgatar raça de Gir Leiteiro no Pólo Regional do Nordeste Paulista
- • Piscicultura em tanque-rede terá dia especial
- • Pesquisa treina equipe para apontar defeitos de sabor em leites
- • Exportação faz frango subir; entressafra puxa bovino
- • União Européia envia missão para investigar aftosa em São Paulo
- • Programas Sociais, O Arroz Com Feijão E O Pão Nosso De Cada Dia
- • Recuperação e Intensificação da produção de pasto de ´´Urochloa Brizantha´´ Stapf Webster Cv. Marandu
- • Unica: Centro-Sul deve processar 370,6 milhões de t de cana em 2006/07
- • AÇÕES DO INSTITUTO DE PESCA NO FOMENTO À PRODUÇÃO PESQUEIRA MARINHA NO ESTADO DE SÃO PAULO
- • Bife reestruturado aproveita cortes de baixo valor mercadológico
- • Reserva Legal E Leis Agrícolas Ultrapassadas
- • COMEÇA A FEIRA INTERNACIONAL DA INDÚSTRIA SUCROALCOOLEIRA
- • SECRETARIA DE AGRICULTURA ABRE INSCRIÇÕES PARA CONCURSO PÚBLICO
- • OIC eleva previsão da safra 2006/07 de café para 122 milhões de sacas
- • China espera produzir 6,2 bilhões de litros de etanol por ano até 2010
- • IEA Lança Serviço De Custo Rodoviário Nas Rotas Barretos/Assis -Porto De Santos
- • MERGULHADOR E CINEASTA LANÇA LIVRO SOBRE TUBARÕES, NO MUSEU DE PESCA DE SANTOS
- • Fertilizantes Refletem Situação Desfavorável No Mercado De Grãos
- • Agronegócio: Exportações Paulistas Crescem Mais Do Que As Brasileiras
- • Agente biológico combate praga da cana
- • Novo laboratório para o setor de piscicultura do Pólo Regional do Noroeste Paulista vai auxiliar novas pesquisas sobre o tema
- • Secretaria amplia proibição de queima de cana no norte de SP
- • Pólo Regional do Extremo Oeste promove mais um curso de inseminação artificial em Andradina
- • Preços Recebidos Pela Cana-de-açúcar E Perspectivas Para A Safra 2006/07
- • IAC reúne pesquisadores e mostra como o ambiente está bem perto da gente no campo ou na cidade
- • Caracterização da Pecuária no Vale do Paraíba Paulista Utilizando a Análise Multivariada
- • Usinas freiam investimento em açúcar destinado a varejo
- • SÃO PAULO: 10 ANOS SEM AFTOSA
- • PISCICULTORES REÚNEM-SE NO VALE DO ITAJAÍ
- • São Paulo Agroindustrial-exportador Num Brasil Primário-exportador
- • Pesquisadores apresentam estudos sobre pupunha e couve-flor em Congresso Brasileiro de Olericultura
- • Área de soja deve cair 7% no país em 2006/07
- • Frio e geadas prejudicam pomares de frutas do Sul
- • UE mantém embargo à importação de carnes de SP, MS e PR
- • EXPORTAÇÕES E SUPERÁVIT DO AGRONEGÓCIO BATEM RECORDES HISTÓRICOS
- • EMPRESAS COMEÇAM A COMERCIALIZAR SEGURO RURAL COM SUBVENÇÃO DO GOVERNO
- • Avanço da cana eleva os investimentos das indústrias de base
- • Agronegócio: Mapa divulga balança do setor até agosto
- • CONVÊNIO POSSIBILITA MONITORAMENTO PARA DOENÇAS DAS AVES
- • Instituto de Pesca ganha novos laboratórios
- • Balança Comercial Dos Agronegócios Encontra Os Seus Destinos
- • Soja "responsável" terá controle internacional
- • Exportação de álcool via porto de Santos cresce 46% de janeiro a julho
- • A região da Alta Paulista e suas potencialidades na produção de corantes naturais
- • São Paulo: pesquisa busca melhor sistema para exploração da seringueira
- • Gerenciamento De Riscos Na Produção E Comercialização, Tema De Evento E Ituverava
- • O aroma que sai da floresta e gera negócios
- • SEMINÁRIO DE INICIAÇÃO CIENTÍFICA ESTIMULA BOLSISTAS E ESTAGIÁRIOS DO INSTITUTO DE PESCA
- • Reserva Legal: Argumentos Da Secretaria Estadual Do Meio Ambiente
- • Emprego Na Agricultura Paulista: Desempenho Melhor Que O Divulgado No CAGED
- • Campo dá sinais de recuperação após três anos de crise
- • Alternativa ao mercado
- • Importância do pulgão na transmissão do vírus do mosaico das nervuras do algodoeiro
- ► Agosto (50)
- • Governo investirá R$ 355 mi em pesquisa de biocombustível
- • Agregação de valor ao setor de horticultura é tema de seminário em Ribeirão Preto
- • Pesquisas científicas e tecnológicas em agronegócios na região do Vale do Paraíba serão baseadas nas demandas regionais
- • GOVERNADOR CLÁUDIO LEMBO INAUGURARÁ, EM SANTOS, OBRAS DE MODERNIZAÇÃO DE CENTRO DE PESQUISA MARINHA
- • Livros são lançados na cerimônia de aniversário do ITAL
- • Mancha de Phoma: controle preventivo na época de florada
- • Doenças que atacam plantações de pupunha aumentam no último ano e deixam produtores preocupados na região
- • Brasil realiza Conferência Internacional de Agroenergia
- • Aquecimento já afeta o país, afirma Greenpeace
- • Semana comemora 43 anos de ITAL
- • Reservas: Incentivo A Matas Nativas Em Propriedades Rurais
- • Instituto faz análise de plantas
- • Pólo Regional do Extremo Oeste desenvolve projeto para capacitar estudantes de Medicina Veterinária
- • Convocação em Quinta Anuência à Nomeação PARA PROVIMENTO DE CARGOS DE PESQUISADOR CIENTÍFICO
- • Álcool cai, mas preço deve voltar a subir
- • Bactérias podem ajudar a prever mudanças no oceano
- • Pesquisas buscam agregar valor à carne de tilápia
- • Inquérito sanitário da caprinocultura familiar no município de Itapetininga SP
- • Processo Seletivo 2007/2009 - Agricultura Tropical e Subtropical Instituto Agronômico - IAC
- • V Encontro Nacional Educação Ambiental na Agricultura "Recuperando o Meio Ambiente" 13 a 15 de Setembro de 2006
- • Uruguai deve superar argentinas em exportações de carne
- • Ministro da Agricultura culpa pecuaristas por febre aftosa
- • MAIS DE 70 MUNICÍPIOS COMEMORAM DIA NACIONAL DO CAMPO LIMPO EM 18 ESTADOS
- • Cafeicultura se arma para boa fase de preços
- • Exportações do agronegócio de SP atingem US$ 7,5 bilhões até julho
- • EUA vão comprar mais carne bovina do Brasil
- • IZ tem 23 novos projetos de pesquisa aprovados pela Fapesp
- • Pesquisa verifica contaminação em pescado
- • Produção De Grãos Cai Em SP; Café E Cana Aumentam E Laranja Mantém Estabilidade
- • Agronegócio Paulista: Crescem Exportações E Saldo Comercial Em Janeiro-julho
- • Depois do RS, Newcastle é confirmada no Amazonas
- • Pesquisadores do Vale do Paraíba realizam evento para identificar demandas científicas e tecnológicas na região
- • Pesquisador de Ribeirão Preto estuda possibilidades de alimentação bovina em época de seca
- • Agropecuária Brasileira: Anos Gloriosos Que Não Voltam Mais
- • Alternarioses em hortaliças: sintomas, etiologia e manejo integrado
- • IZ recebe a visita de alunos das EMEF
- • Representante do IAC vem ao Tocantins
- • IZ promove 10ª Reunião Técnica sobre produção intensiva de ovinos
- • Câmbio Ou Petróleo: Qual Preço Afeta Mais A Agropecuária Brasileira?
- • Pimenta, Castanha E Mel: Primeiras Vítimas Da Ausência De Rastreabilidade
- • Seminário Discute Em São Paulo Futuro Do Biodiesel E Do H-Bio
- • Crianças do Programa Caravanas do Conhecimento visitam o Pólo Regional do Noroeste Paulista
- • Apta Regional: Técnicas para inseminação artificial são ensinadas aos produtores rurais em Andradina
- • Análise ambiental: base para o desenvolvimento sustentável
- • Citricultor receberá pelo menos US$ 4 por caixa de laranja na safra 2006/07
- • Seminário aborda enriquecimento de alimentos
- • Pastagem bem formada - base da alimentação econômica dos bovinos
- • Mudança em rótulos é viável para empresas
- • MÁQUINA AGRÍCOLAS AUTOMOTRIZES: UM 2006 SEM ESPERANÇAS
- • ASPECTOS SANITÁRIO DA CAPRINOCULTURA FAMILIAR NA REGIÃO SUDOESTE PAULISTA
- ► Julho (14)
- • AVES MARINHAS AMEAÇADAS DE EXTINÇÃO É TEMA DE CURSO NO MUSEU DE PESCA DE SANTOS
- • ITAL PARTICIPA DAS ANÁLISES DA TACO.
- • GERENCIAMENTO DE RISCOS NA PRODUÇÃO E COMERCIALIZAÇÃO, TEMA DE EVENTO EM ITUVERAVA.
- • Concurso gourmet escolhe a melhor receita preparada com o arroz preto.
- • CADEIA PRODUTIVA DA ACEROLA É TEMA DE REUNIÃO TÉCNICA EM JUQUEIRÓPOLIS.
- • TERCEIRA CHAMADA CONCURSO PESQUISADOR CIENTÍFICO IV
- • Agronegócio Paulista Sustenta Desempenho Da Balança Comercial Brasileira
- • Biológico lança livro sobre pragas de grãos
- • Pesquisadores estudam variedades de mangueira para cultivo orgânico na região centro norte do Estado de São Paulo
- • No Centro de Cana, IAC inaugura Laboratório de Biologia Molecular
- • Pesquisadores da Apta Regional são homenageados pela Câmara de Vereadores de Monte Castelo
- • São Paulo Inicia Estudos De Dutos Para Exportação De Alcool E Açúcar
- • São Paulo Estabelece Critérios De Entrada Para Aves E Produtos Do RS
- • Pesquisadores avaliam valor nutritivo da cana-de-açúcar tratada com cal microprocessada para alimentação de animais
- ► Junho (15)
- • R$ 5 milhões para inovação em empresas
- • Quedas Nos Saldos Comerciais Paulista E Brasileiro Atenuadas Pelo Agronegócio
- • Pandemia de gripe aviária custaria US$ 300 bi à Ásia
- • Novas regras do Sisbov devem sair em 30 de junho
- • Projeto promete minimizar os riscos de contaminação da aftosa
- • Comissão debate avanço científico e tecnológico do agronegócio no Estado
- • Brasil e Rússia definem medidas para restabelecer venda de carne
- • Produção brasileira de café cresce 23%
- • Algodão Em Pluma: Cincos Anos De Saldo Positivo Na Balança Comercial
- • Fundo Social de Solidariedade recebe 1ª colheita de café do Instituto Biológico
- • A vez dos desidratados Velhos conhecidos, frutas e hortaliças desidratadas são tendência no mercado atual
- • Café: Mercado Em Queda, Nova Safra Brasileira E Baixo Risco De Geada
- • Pesquisa identifica pólen como possível fonte de vitamina C e betacaroteno
- • 5º CONGRESSO BRASILEIRO DE AGRIBUSINESS
- • Pesquisadores Científicos da região de Jaú divulgam técnicas adequadas para a produção de mudas de cana-de-açúcar
- ► Maio (15)
- • Projeto ambiental visa recuperar represas da região de Votuporanga
- • Pragas e doenças na cultura do café é tema de encontro no Pólo Regional do Centro Leste
- • Piscicultores do Vale do Ribeira participam de evento para incrementar a produção
- • Instituto De Zootecnia Desenvolve Híbridos Para Alimentação Animal
- • IX Reunião Técnica - Produção Intensiva de Ovinos
- • Agroenergia nas pesquisas IAC
- • Espécies de leguminosas utilizadas como adubos verdes
- • Apta Regional: Pesquisadores do Pólo Regional do Nordeste Paulista ensinam técnicas de educação ambiental a estudantes de Mococa
- • Nomeação de Pesquisadores Científicos I
- • Lista de espécies ameaçadas no Brasil tem 25 novos integrantes
- • Soja: Óleo E Trigo Sustentam
- • MISSÃO DO MAPA NEGOCIARÁ EXPORTAÇÃO DE ETANOL, FRUTAS E CARNES NO JAPÃO
- • Safra de cana deve crescer 11,32%, estima a Unica
- • Exportação de carne suína cai pelo 3º mês consecutivo
- • Discurso de Abertura do Congresso ABIPTI 2006
- ► Abril (8)
- • Estudantes aprendem técnicas de manejo para o rebanho bovino em Presidente Prudente
- • PESCADO: Segurança Alimentar é Tema de Simpósio
- • Pesquisador do IAC receberá Prêmio FCW de Ciência Aplicada ao Campo
- • Pesquisadores científicos debatem sobre as vantagens da produção da mamona para a extração de biodiesel em palestra
- • Alta no preço do álcool reduz venda do combustível
- • Soja para todos os gostos
- • Máquinas Agrícolas: Crise Impede Retomada Das Vendas No Mercado Interno
- • Governo Enxuga MP Do Bem Para A Agricultura
- ► Março (35)
- • Leite: preços sobem mas renda do produtor continua apertada
- • APTA PARTICIPA, EM BRASÍLIA, DE CONFERÊNCIA SOBRE AQÜICULTURA E PESCA
- • IEA Publica Primeira Pesquisa Com Área De Agricultura Orgânica Em SP
- • Identificação de parasitóides
- • Doenças em Mamona (Ricinus communis L.)
- • Cabanhas Samara e Lomas Negras apóiam programa de pesquisa do Instituto de Zootecnia
- • Preço do álcool deve cair até maio, prevê Unica
- • Bens De Capital E Insumos Da Agricultura: Déficit Nas Transações Externas Brasileiras
- • Alternativa de controle: Bicudo da cana-de-açúcar
- • Comercialização da banana no Médio Paranapanema: o caso da COOPABAN
- • IZ realiza IX REUNIÃO TÉCNICA PRODUÇÃO INTENSIVA DE OVINOS
- • Ministério Prepara MP do Bem da Agricultura Para Apoiar Agronegócio
- • São Paulo é o maior produtor de ovos do país
- • Biodiesel: oferta no Brasil será 40% maior que a demanda em 2008
- • Estágios no exterior
- • Saldo Comercial Do Agronegócio Paulista Atinge US$ 1 Bi No Primeiro Bimestre
- • IAC realiza curso sobre uso de resíduos urbanos e industriais no solo agrícola
- • Ministro da Agricultura se reunirá com o setor sucroalcooleiro e do biodiesel
- • Desoneração pode deixar carne mais barata
- • Agricultura e Fazenda começam a negociar Plano de Safra 2006/07
- • Cana agora expulsa gado do interior de São Paulo
- • Boi: aftosa frustrou expectativa de crescimento da Lagoa da Serra
- • PESQUISA ALERTA: NÃO HÁ COMO PREVER A CHEGADA DA GRIPE AVIÁRIA AO BRASIL
- • Commodities: Cotação Do Açúcar Dobra Em Doze Meses
- • Café: Especulação Faz Desabar As Cotações
- • MORANGO: Controle Adequado
- • Receita com exportações de café cresce 22,7% em fevereiro
- • Mercosul tomará posição conjunta contra a aftosa
- • Pequeno agricultor pode ajudar meio ambinete
- • Exportações de suco de laranja crescem em 2006
- • Máquinas agrícolas: vendas em fev/06 sobem 11,7% sobre jan/06
- • Agricultura pode ter sua MP do Bem contra crise
- • AQUECIMENTO GLOBAL, MUDANÇAS CLIMÁTICAS E A CAFEICULTURA PAULISTA
- • IEA: Estudo Aponta Crescimento Para Bovino, Leite, Aves, Ovos E Suínos
- • Plantas ornamentais: a pesquisa de antigos e novos vírus
- ► Fevereiro (54)
- • Impactos Da Aftosa Nas Vendas Externas De Carne Bovina Não-processada
- • Principais Viroses Da Cana-De-Açúcar
- • Formação adequada da pastagem: o alicerce da produtividade
- • R$ 200 milhões para programa de integração lavoura-pecuária
- • Brasil não está imune ao vírus da gripe aviária, afirma Ministro
- • Confirmados mais seis focos de aftosa no Paraná
- • Agricultura é destaque no 50º Congresso Estadual dos Municípios
- • Álcool: Mapa confirma que mistura à gasolina passa de 25% para 20%
- • Instituto Biológico: Laboratório Paulista Realiza Avaliação de Produtos Agrícolas Exportados Para o Japão
- • Evento debate condições para política de biocombustíveis no Brasil
- • Execução Extrajudicial De Títulos Fundiários No Financiamento Agrícola
- • Análise de solo significa investimento para reforçar a capacidade produtiva
- • IAC reúne 93 laboratórios para avaliar qualidade de análises de solo
- • R$ 787 milhões para Pesquisa
- • Seminário Destaca Liderança Brasileira Em Recolhimento De Embalagens De Agrotóxicos
- • Soja/EUA: com biodiesel, produção de derivados pode ser afetada
- • PÓS-GRADUAÇÃO DO INSTITUTO DE PESCA REALIZA PRIMEIRO EXAME DE QUALIFICAÇÃO
- • Mapa avalia ação contra aftosa
- • Produtos orgânicos conquistam espaço no mercado brasileiro
- • Safra de cana deve atingir 360 milhões toneladas
- • Produção de soja, girassol e amendoim pode ser alternativa para produtores de cana-de-açúcar na região de Ribeirão Preto
- • Breve perfil dos municípios rurais do Estado de São Paulo
- • Exportação de carne deve crescer 20% em 2006
- • Instituto Abre Inscrições Para Reunião Sobre Pprodução Intensiva De Ovinos
- • Preço Do Álcool Ultrapassa Nível Combinado Com Governo
- • EUA Podem investir em Álcool Brasileiro
- • Exportações Brasileiras De Bovinos Crescem 630%
- • Commodities: O Destaque De Janeiro Foi O Café, Com Forte Alta
- • Formigas Indicam A Qualidade Do Meio Ambiente
- • Brasil supera EUA na exportação de soja
- • Café: OIC prevê que Brasil terá em estoque de 9 mi/sacas em abril
- • Leite: ministério esclarece rumores que circulam na internet
- • Produtores participam de palestra sobre controle de pragas
- • Senado apresenta projeto de Reforma Cambial da Fiesp
- • Argentina: foco de aftosa deixa produtor em estado de choque
- • Venda de máquinas agrícolas cai 1,3%
- • Brasil poderá embargar carne argentina
- • UE lança plano de desenvolvimento de biocombustíveis
- • Estudo dos consumidores valoriza cafés certificados do Brasil
- • TANQUES-REDE: REUNIÃO DISCUTE IMPORTÂNCIA DE AGILIZAR REGULARIZAÇÃO AMBIENTAL
- • Floricultura: Desempenho Do Comércio Exterior Em 2005
- • Expansão da agroindústria sucroalcooleira: nova configuração para São Paulo
- • Brasil deve produzir 1,12 bilhão de litros de biodiesel
- • BB libera R$ 2,56 bi para produtor rural
- • Inovação paulista
- • Açúcar tem maior alta em 25 anos; Brasil domina cenário global
- • Carne Bovina: Queda De Preços Não Chega Ao Varejo Em 2005
- • Lei de Inovação será assinada na FAPESP
- • Preço do boi é o menor em 50 anos, mas consumidor paga mais
- • MAPA monta estratégia para acompanhar evolução do agronegócio
- • Relatório de instituto norte-americano defende regulação ambiental para produtos que incorporem nanotecnologia
- • Brasil, Índia e África do Sul firmarão acordo de cooperação
- • Cana valoriza terras em até 49% em Ribeirão Preto (SP)
- • Safra global de soja 2005/06 será maior que consumo
- ► Janeiro (18)
- • Apta Regional: Laboratório realiza exame inédito em Bauru para identificar leptospirose
- • Aftosa: já são 56 os países que pararam de comprar carne do Brasil
- • Produção de banana pode ser alternativa para a região do Médio Paranapanema
- • Mosca e percevejo atacam maracujás
- • Pragas de Verão
- • IBGE: Safra de Grãos em 2006 Pode Crescer 13,2%, Para 127,6 mi/t
- • Brasil Produz 436,8 Milhões De Toneladas De Cana, Recorde Histórico
- • Prevenção E Doenças De Rãs
- • Governo Libera R$ 200 Milhões Para Combate Á Ferrugem Asiática Da Soja No Centro-Oeste
- • Brasil exportou 2,762 milhões de toneladas de carne de frango em 2005
- • Cana, laranja e café elevaram a renda do agricultor em 2005
- • Importação Cresce, Mas Não Alcança Nível Do Plano Real
- • Algodão: Icac estima aumento de 3% no plantio mundial em 2006/07
- • Criação de búfalos é bom negócio
- • Preço do Leite pago ao produtor cai 4,4% em dezembro, informa Cepea
- • Defesa Civil previne MG, RJ e SP sobre temporais
- • Mais R$ 2 Bilhões Para O Crédito Agrícola
- • MAPA define padrão de qualidade para diversos produtos
- ► Dezembro (81)
- ► 2005 (75)
- ► Dezembro (52)
- • Instituto De Pesca Sistematiza Estatística Da Pesca Paulista
- • Instituto Biológico garante qualidade sanitária ao sêmen, embriões e ovócitos de bovídeos comercializados no Brasil e no exterior
- • Exportações Do Agronegócio Paulista Atingem US$ 10,8 Bilhões Em 11 Meses
- • Tilápia Toma Espaço do Couro de Boi
- • Instituto aprova peixe comercializado
- • Recuperação: Preços Agrícolas Sobem 0,92% Na 3ª Quadrissemana De Dezembro
- • Analistas prevêem escassez mundial de café daqui a 2 anos
- • Prognóstico Agrícola 2005/06
- • Tecnologia de ponta na cana-de-açúcar
- • Governo admite que UE pode ampliar trava à carne do país.
- • Brasil Vai Bater Recorde Na Exportação De Carne Bovina
- • Reação de Genótipos de Soja ao Oídio (Erysiphe diffusa) em Plantio Safrinha e Convencional na Região de Jaboticabal- SP
- • Os Preços Agrícolas Desaceleram E Caem 0,47% Na 2ª Quadrissemana De Dezembro
- • Controle microbiano de pragas
- • MAPA vai reformular regras para certificação sanitária
- • A Utilização das Boas Práticas Agropecuárias
- • Laboratório do IZ recebe certificado de controle de qualidade
- • Estudo de gramíneas em sistema de produção de ovinos
- • Parceria entre IZ e Matsuda na obtenção de híbridos
- • IZ realiza validação de cultivar para Itograss
- • Pesquisa no IZ - Silagem de cana-de-açúcar para alimentar ovinos
- • Pesquisadora do IZ recebe homenagem da ABC
- • Alimentação Institucional: Dispêndios Do Governo Do Estado De São Paulo
- • OMC: UE Não Quer Fixar Data Para Fim Dos Subsídios Às Exportações E Coloca Questão Política Na Mesa
- • Frangos: Embarques Caíram 20,4% Em Nov Ante Out, Para 206.589 T
- • Apertem os cintos: vai faltar café!
- • São Paulo bate recorde no índice de vacinação contra aftosa
- • Artrite-Encefalite dos Caprinos (CAE)
- • Febre Maculosa Brasileira
- • Pele De Peixe: Após Curtimento, Tem Aspecto Peculiar, Inimitável!
- • Ganhos Em Escala Nas Agropecuárias Norte-americana E Brasileira
- • As Oportunidades Para A Agricultura Familiar Na Lei Brasileira De Orgânicos
- • Pesquisadora do IAC é Homenageada em Evento Sobre Maracujá
- • Ministério Confirma Aftosa E Abre ''Guerra'' Com Paraná
- • Superávit Comercial Do Agronegócio Alcança US$ 35,284 Bi No Ano
- • Produtores argentinos participam de intercâmbio tecnológico sobre caprino e ovinocultura no Estado de São Paulo
- • CONAB Confirma Aumento Da Produção Em 2005/06
- • Vendas De Máquinas Devem Retomar Crescimento Em 2006
- • Rebanho Bovino Brasileiro Continua Sendo O Maior Do Mundo
- • Fórum aproxima produção de C&T dos setores produtivos
- • Gripe Aviária: Empresa Japonesa Pode Ter Fraudado Testes
- • Ovinos E Caprinos Avançam Em São Paulo
- • Goiaba Para Indústria: Estabilidade De Preços Requer Controle Severo De Custos
- • Apta Regional: Produtores argentinos participam de intercâmbio tecnológico sobre caprino e ovinocultura no Estado de São Paulo
- • São Paulo Amplia Entrada De Animais E Produtos De Regiões Do MS E PR
- • Tarifas (barreiras) de 150 por cento à carne bovina
- • Aftosa: Exames Confirmam Aftosa No Paraná, Diz Ministério
- • 3º Edição dos melhores cafés de São Paulo
- • Preços Agrícolas Crescem 3,38% Em Novembro
- • Rodrigues Sobre o PIB: Tecnicamente Isso Era Esperado
- • Veterinário Alerta Para Vacinação Mal Feita Contra Aftosa
- • Fórum Regional de Inovação Tecnológica, Inclusão Social e Redes de Cooperação
- ► Novembro (22)
- • Edição Especial Apresenta os Melhores Cafés de São Paulo
- • Confirmados Mais Três Focos da Febre em MS
- • IEA: preços agrícolas sobem 4,34% na 3ª quadrissemana do mês
- • ITAL Abre Suas Portas Para Receber Alunos
- • Febre Maculosa
- • Sai a regulamentação da Lei de Biossegurança
- • Plantio De Sementes Ilegais Impulsiona A Soja Transgênica
- • Tecnologia IAC chega aos EUA para ser produzida e comercializada
- • Governo Libera Mais R$ 2 Bilhões Com Juros Favorecidos Para Agricultura
- • Atividade Pecuária No Pólo Noroeste Paulista
- • Começa a semana do 38º aniversário da CATI
- • Criando rãs é tema de curso
- • São Paulo Permite Entrada de Animais e Libera Realização de Eventos
- • A importância da Febre Aftosa em Saúde Pública
- • Influenza Aviária
- • Preços Agrícolas Crescem 3,30%
- • ITAL se prepara para a implantação do Prumo
- • Plantio Direto Caminho para a Agricultura Sustentável
- • O uso de maturadores químicos na cana-de-açúcar
- • Educação: O Melhor Caminho Para O Pequeno Produtor De Leite
- • III Simpósio Brasileiro debate setor de óleos essenciais no IAC
- • Uma Truta com jeito de salmão
- ► Janeiro (1)
- ► Dezembro (52)








